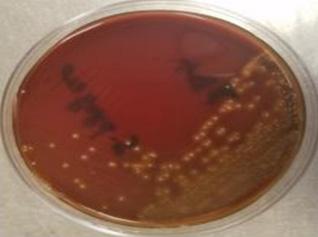
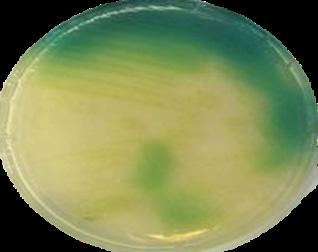
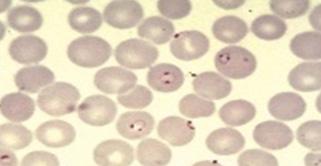

Jhon Ortiz

Jaime Torres
![]()
Jhon Ortiz

Jaime Torres
CARDIOLOGÍA - GASTROENTEROLOGÍA
INFECTOLOGÍA SYNAPSIS

FUNDAMENTOS TEÓRICOS EN MEDICINA - VOLUMEN I
Jhon Ortiz Peceros
© Jhon Ortiz Peceros, 2023
© Jaime Torres Arias, 2023
Diseño y diagramación: Jaime Torres Arias
Jefe de arte: Torres Tizón, Beatriz María Diseño de cubierta: Torres Tizón, Beatriz María Ilustraciones: Condori Chavez, Gina Melissa
Editado por:
Editorial SYNAPSIS S.A.C
Av. César Vallejo 544 - Lince - Lima - Perú R.U.C: 20608680331
Primera Edición: Mayo 2024 Tiraje: 1050 ejemplares
Impreso por:
Multiservicios “El Tigre” Jr. Azángaro 1041 Int. A1 - Lima



Estimado (a) estudiante / Doctor (a): Quisiera enviarle un cordial saludo en nombre del Grupo Qx Medic, una institución educativa formada por médicos destacados. Nuestra misión es proporcionarle una preparación académica de la más alta calidad y nivel.
En esta oportunidad, queremos manifestar nuestro agradecimiento por elegirnos en su preparación académica.
En ese sentido, el manual de FUNDAMENTOS TEÓRICOS EN MEDICINAVOLUMEN I, refleja la esencia de nuestra institución, innovación continua y el compromiso para ofrecerle el mejor servicio educativo.
Este manual comprende los siguientes capítulos: cardiología, gastroenterología y infectología. Está organizado por temas que suelen ser preguntados en los diferentes exámenes como ESSALUD, ENAM y ENARM. Además, incluye ilustraciones a color y referencias a datos que han sido preguntas de examen, con el fin de garantizar un aprendizaje significativo.
Al inicio de cada capítulo, se podrá escanear un código QR que proporcionará estadísticas relevantes y detalles sobre los temas más importantes, según el examen oficial que va a rendir. Esto brinda al postulante una guía de estudio que le permite optimizar su tiempo y maximizar su aprendizaje.
En caso tenga alguna sugerencia u observación del manual, pueden escribirnos a jaime.torres@innovaqx.com, colocando en asunto el título de la obra.
Finalmente, esperamos que los estudiantes encuentren en este manual un medio que los inspire en el aprendizaje y los motive a lograr sus metas.
Jaime Torres Director académico












































































El capítulo de CARDIOLOGÍA es considerado un CAPÍTULO INTERMEDIO debido al porcentaje moderado de preguntas que generalmente se incluyen en exámenes oficiales como ESSALUD, ENAM y ENARM. Por lo tanto, es recomendable revisar los temas más relevantes y consolidar los conceptos esenciales. Asigna repasos espaciados y realiza evaluaciones junto con capítulos menores para maximizar la eficiencia de tu tiempo de estudio.







La cardiopatía isquémica o enfermedad coronaria, se debe al desequilibrio existente entre el aporte y la demanda de oxígeno del miocardio y representa la causa principal de disfunción de la contracción miocárdica ( sístole)


1 (ENARM 2000)


1 (ENAM 2013)


La ateroesclerosis (ATE) es la causa más frecuente, afecta los vasos coronarios proximales (epicárdicos). La arteria más afectada es la arteria descendente anterior (ADA) . Otras causas son:
Vasoespasmo coronario (angina Prinzmetal) jóvenes que consumen cocaína
Alteración de la microcirculación coronaria (síndrome X) mutación del receptor de adenosina.
Embolismo coronario endocarditis infecciosa, fibrilación auricular
Vasculitis coronaria Kawasaki y sífilis
Disección de aorta ascendente
La ateroesclerosis:
Enfermedad inflamatoria multifactorial de la capa íntima de las arterias.

Caracterizado por una acumulación de placas de colesterol en la íntima.
Afecta las arterias elásticas (aorta) y las arterias musculares grandes / medianas (coronarias).


1 (ENAM 2013)



2 (ENAM EXTRA 2013)


La enfermedade aterosclerótica es la principal causa de muerte en los pacientes diabéticos (representan el 80% de las muertes).


Mayores
Edad: hombres ≥ 45 años, mujeres ≥ 55 años (posmenopausia)
Sexo masculino
1 2
Diabetes no controlada, dislipidemia, hipertensión, tabaquismo , estos fueron determinados por el estudio de Framingham.

Menores
Obesidad
Sedentarismo
Postmenopausia
Hiperhomocistemia



1 2 (ENAM EXTRA 2020) (ENAM 2012) (ENARM 2014)


La isquemia produce metabolismo anaeróbico (acidosis) y reducción en la producción de ATP. Esta lesión metabólica produce primero disminución de la función diastólica y posteriormente se afecta la función sistólica, lo cual empieza a manifestarse en la clínica (angina) y en el electrocardiograma (alteración de la onda T y segmento ST).
La reducción coronaria produce:
Miocardio viable (reversible) Miocardio no viable (irreversible)
Aturdido: isquemia aguda y severa
Hibernado: isquemia crónica

Necrosis (infarto): isquemia persistente y completa.

El infarto de miocardio es un tipo de necrosis coagulativa.
Disfunción diastólica

Breve y severa
Reducció de flujo coronario
Hipoperfusión crónica
Completa y persistente

Disfunción sistólica


Disfunción electrocardiográficos

Miocardio aturdido
Miocardio hibernado

Necrosis miocárdica

La cardiopatía isquémica puede manifestarse de diferentes formas:
Síndrome coronario crónico (angina estable)
Síndromes isquémicos coronarios agudos (SICA)
Angina inestable.
Infarto agudo de miocardio sin onda Q
Infarto agudo de miocardio con onda Q
Muerte súbita
Angina


Miocardio viable
Miocardio no viable


Disfunción ventricular izquierda



Se refiere al malestar en el pecho que ocurre de manera predecible y reproducible a un cierto nivel de esfuerzo. Se alivia con reposo o nitroglicerina (duración < 20 minutos).


La placa de ateroma es estable cuando tiene un centro lipídico pequeño que está rodeado de una gruesa capa fibrosa de colágeno, que evita su ruptura y va creciendo de forma crónica, con lo cual la oclusión es progresiva y genera un desbalance entre la oferta ( ) y la demanda ( ) de oxígeno . Además, pone en funcionamiento la circulación colateral del corazón. Se considera que cuando una placa de ateroma ocluye el 70 % de la luz arterial aparece angina con el esfuerzo; cuando supera el 90 %, puede aparecer ya en reposo.



(ENARM 2000)

El grado de estenosis y la isquemia asociada determinan la intensidad, frecuencia y duración de los síntomas de la angina.


El diagnóstico es eminentemente clínico, un dolor torácico es considerado una angina cuando presenta las siguientes características:
Dolor opresivo en la región retroesternal o precordial, irradiado a la cara interna del brazo izquierdo, mandíbula, epigastrio o zona interescapular
Se considera una angina estable cuando:
Los síntomas son reproducibles o predecibles. Se desencadena por el esfuerzo físico / mental o exposición al frío. Se atenúa con el reposo o los nitratos (duración < 20 minutos)









Clase Esfuerzo que desencadena la Angina

Limitación de la actividad cotidiana
I Ejercicio prolongado No
II Caminar más de dos cuadras Ligera
III Caminar menos de dos cuadras Moderada
IV Mínimo o en reposo Grave


En pacientes diabéticos el equivalente de angina es disnea (ENAM EXTRA 2021).

Pruebas funcionales: sirven para el diagnóstico en casos sospechosos, pero, principalmente, para la evaluación de la gravedad de la enfermedad coronaria estable, así como para clasificar al paciente en bajo o alto riesgo (evaluación del pronóstico). Contraindicado en cuadros agudos (SICA), en presencia de arritmias graves o falla cardiaca. detecta cambios isquémicos con el esfuerzo.
Ergometría (test de esfuerzo):
Computadora de registro para ECG


Ecocardiograma de esfuerzo. Gammagrafía de perfusión
Tiene mayor especificidad y sensibilidad que las pruebas anteriores.



Coronariografía (angiografía coronaria)
Es una prueba invasiva y definitiva para valorar la gravedad de la enfermedad coronaria (gold estándar).
Se indica en casos de angina severa (grado III – IV), falta de respuesta al manejo médico, alto riesgo en pruebas funcionales o previo a la revascularización.

Medidas generales

Los resultados del ECG en reposo suelen ser normales en pacientes con angina estable.

La reducción de los factores de riesgos debe ser un componente central y primario del manejo de estos pacientes, el abandono del tabaquismo, la reducción de peso y, sobre todo, el control glucémico en los diabéticos, dado que estos últimos presentan un riesgo absoluto muy alto (equivalente al de aquellos que ya han sufrido un evento coronario previo).
Tratamiento farmacológico
Antianginoso
Los betabloqueadores:
Son los antianginosos de primera línea porque mejoran el pronóstico (selectivos: metoprolol, bisoprolol, atenolol).
Disminuyen el consumo de oxígeno al disminuir la frecuencia cardiaca (prolongando la diástole) y la contractilidad. Contraindicado en casos de asma severa, EPOC, enfermedad del nodo sinusal, bloqueos A-V de 2.º y 3.º grado o vasculopatía periférica (especialmente, los no selectivos como propranolol).
Los calcioantagonistas:
Terapia alternativa en la que actúan como vasodilatadores coronarios y periféricos, y disminuyen la frecuencia cardiaca (verapamilo y diltiazem).
Son de elección en casos de angina de Prinzmetal (vasoespasmo).
Contraindicados en pacientes con disfunción ventricular izquierda significativa (falla cardíaca sistólica).
Los nitratos:
Son los antianginosos de segunda línea al igual que los calcioantagonistas.
Reducen la precarga (venodilatadores) y con ello el consumo de oxígeno.
Se usan los nitratos de acción prolongada (sintomáticos), como dinitrato de isosorbide.
Se pueden administrar por vía oral o parches.
Antiagregación plaquetaria
El AAS (ácido acetilsalicílico)
Reduce los niveles de tromboxano A2 al inhibir la ciclooxigenasa tipo 1 (COX 1) de las plaquetas.

1 (ENARM 2014) (ESSALUD 2022) 1


Ha demostrado reducir la incidencia de procesos coronarios agudos en pacientes de riesgo cardiovascular (también previene la preeclampsia y el cáncer colorrectal).
Dosis: por vía oral de 81 - 100 mg/día
La alternativa es el clopidogrel, que bloquea los receptores de ADP de las plaquetas (75 mg/día).
Estatinas

Los betabloqueantes se utilizan tanto para reducir el riesgo de infarto de miocardio y muerte (prevención secundaria) como para aliviar los síntomas (tratamiento antianginoso) en pacientes con angina estable.

Aprovechamos su efecto pleitrópico (antioxidante, antiinflamatorio), y se indica como estabilizador de la placa de ateroma, independientemente del colesterol de lipoproteínas de baja densidad (LDL) basal.
Se usan los más potentes, como rosuvastatina 40 mg/día y atorvastatina 80 mg/ día.
IECAS o ARA II
Está indicado en pacientes con diabetes mellitus (efecto antiproteinúrico), HTA, insuficiencia cardiaca (fracción de eyección < 40 %) o enfermedad renal crónica (TFG > 30 ml/min).
Tratamiento de revascularización
Si el paciente es refractario al manejo médico o presenta datos de alto riesgo en las pruebas funcionales, el siguiente paso sería la coronariografía con miras a la revascularización coronaria, donde se disponen de dos técnicas:
Cirugía de injerto de derivación de arteria coronaria (“BY-PASS”)
Indicaciones:
Enfermedad del tronco coronario izquierdo (estenosis > 50%)
Enfermedad severa de 2 vasos (estenosis > 70%) cuando uno de ellos es la ADA y se asocia a diabetes o a insuficiencia cardiaca (IC)
Enfermedad severa de 3 vasos (estenosis > 70%) con insuficiencia cardiaca (IC)
El injerto de elección es la arteria mamaria interna (arteria torácica interna). Como alternativa, se utilizarán los injertos venosos, p. ej., la vena safena mayor (interna), que tiene mayor tasa de oclusión.
Angioplastía coronaria transluminal percutánea (ACTP).
Indicaciones:
Cuando no se cumplan los criterios para la cirugía de bypass
Estenosis de by-pass previo





Modificaciones de estilo de vida

PA objetivo en hipertensión: < 130/80 mm Hg (beta bloqueadores)
Control glicémico HbA1c < 7% (metformina, inhibidores de SGLT-2)

Tasa de mortalidad anual: hasta el 5%
El 25% de los pacientes desarrollará un infarto de miocardio agudo en los primeros 5 años.



Se produce por un accidente de una placa vulnerable (ruptura) debido a que presenta una capa fibrosa delgada y núcleo lipídico grande. La exposición de colágeno activa la hemostasia, formándose un trombo que causa una oclusión aguda del flujo coronario y produce dos cuadros, según las alteraciones en el electrocardiograma (ECG).
Síndrome coronario agudo sin elevación del ST (SCASEST): cuando la placa trombótica provoca una oclusión parcial del flujo coronario y en el trombo predomina la agregación plaquetaria.
Síndrome coronario agudo con elevación del ST (SCACEST): cuando la placa trombótica produce una oclusión total del flujo coronario y en el trombo predomina la fibrina.


Capa Media


El síndrome coronario agudo que se manifiesta sin elevaciones del ST en el ECG comprende dos categorías
Angina inestable: biomarcadores negativos (troponinas -) Infarto agudo de miocardio no Q (IMA no Q): biomarcadores positivos (troponinas +)


La angina inestable es un dolor torácico que se presenta de manera súbita, de tipo opresiva, con su típica irradiación, y que se prolonga en el tiempo (duración > 20 minutos) . Puede desencadenarse incluso en el reposo (mañanas).


(ESSALUD 2022)
2 (ENAM 2012) (ENAM EXTRA 2020) (ENAM EXTRA 2021)



La angina inestable presenta las siguientes formas:
Angina de reposo de menos de una semana de evolución
Angina de inicio reciente (aparición de angina tras esfuerzo mínimo)
Angina progresiva (agravamiento reciente)
Angina post-infarto (< 48 horas)

3 (ENAM 2012) (ESSALUD 2022)


Angina variante de Prinzmetal (vasoespasmo coronario)
Electrocardiograma
El ECG de 12 derivaciones es la herramienta diagnóstica primordial en el paciente con un cuadro isquémico agudo, se debe realizar en los primeros 10 minutos desde el ingreso.
3 4
Pueden presentar diferentes alteraciones, infra desnivel del ST (descenso > 0.5 mm en derivaciones contiguas) que indica lesión miocárdica y alteraciones en la onda T (negativa y simétrica) que expresan isquemia, así mismo el ECG inicial puede ser normal, por tanto, debe repetirse a intervalos de 15 a 30 minutos durante la primera hora.



4 (ENAM 2012) (ENAM 2016)

En pacientes diabéticos con disnea súbita, se debe descartar enfermedad coronaria aguda (equivalente de angina disnea), por lo cual se solicitará EKG + troponinas de forma inmediata. (ENARM 2014).

Biomarcadores
Troponinas
Son los biomarcadores de necrosis miocárdica con más sensibilidad y especificidad; desempeñan un papel central para establecer el diagnóstico de infarto de miocardio. Permiten diferenciar entre angina inestable e IMA no Q, ya que en este último caso estarán positivas (elevación por encima del percentil 99).

El dolor torácico de la pericarditis cambia con la postura ( decúbito, sedestación) y en caso del síndrome de Tietze, con la respiración ( inspiración) buscar sensibilidad condrocostal (ENARM 2012).

CPK-MB (creatinfosfoquinasa)

Los hallazgos del ECG son dinámicos, pueden cambiar en cuestión de minutos. Las ondas T negativas indican isquemia, la elevación del segmento ST lesión del miocardio y, finalmente, la presencia de ondas Q necrosis (infarto) (ENARM 2010)
También indican lesión miocárdica . Es útil para detectar reinfartos por su menor tiempo de vida media. Se eleva a partir de las 4 horas, pico máximo 12 a 24 horas y se normaliza en 2 a 3 días.
Mioglobina
Es la primera enzima en elevarse en un infarto, pero tiene baja especificidad.
Otras enzimas
TGO: también es marcador de necrosis hepatocelular y hemolisis.
LDH: última enzima en elevarse en un infarto de miocardio.

MIOGLOBINA
Las troponinas inician su elevación a partir de las 4 horas posterior a un infarto de miocardio , y permanecen elevados hasta 10 a 14 días (troponina T/I). (ENAM 2010) (ENAM 2016) (ENAM EXTRA 2021) 5 (ENARM 2011) (ENARM 2014) (ENARM 2015) (ENARM 2020) (ENARM 2022) 6 (ENARM 2019)








(ENARM 2014) (ENARM 2012)

TRATAMIENTO
Manejo agudo inicial
Como en toda emergencia, primero A (vía área) – B (ventilación) – C (circulación)
Control del ataque anginoso con nitroglicerina 0.4 mg sublingual Si el dolor persiste, sulfato de morfina 2 a 4 mg.
Oxígeno solo cuando existe una saturación < 90 %
Antiagregación plaquetaria a dosis de ataque (AAS o clopidogrel 300 mg)
Control de frecuencia cardiaca con betabloqueantes cardioselectivos (metoprolol)
Estatinas, así tengan valores de colesterol normal, por su efecto pleitrópico (rosuvastatina – atorvastatina)
IECA, en casos de que tenga fracción de eyección deprimida (IC) o paciente con diabetes
Tratamiento antitrombótico
Está indicada la doble antiagregación, AAS + bloqueadores de la ADP (Clopidogrel, Prasugrel o Ticagrelor).
Tratamiento anticoagulante
Se debe iniciar tratamiento anticoagulante parenteral. Los más utilizados son la Heparina No fraccionada (HNF), la heparina de bajo peso molecular (Enoxaparina) o el Fondaparinux.

ESTRATIFICACIÓN DEL RIESGO

Lo que mejor disminuye la mortalidad en cardiopatías son los cambios en los estilos de vida (ENAM 2012).

9 (ENAM 2010) (ENAM 2016)


10 (ENAM 2010)


11 (ENAM 2010)


La nitroglicerina está contraindicada si el paciente está usando inhibidor de 5 PDE (Sildenafil) en las 24 horas anteriores, o si sospecha de infarto de ventrículo derecho.

Las últimas recomendaciones en el manejo del SCASEST indican la necesidad de evaluar el riesgo y contraponer el riesgo trombótico (escala TIMI) frente al riesgo hemorrágico (escala CRUSADE). Con estos datos, se obtendrá información sobre la actitud a seguir con estos pacientes.
Estrategia invasiva: se recomienda a los pacientes de alto riesgo (TIMI ≥ 2 puntos). Se basa en coronariografía precoz y en revascularización (ACTP vs Cirugía bypass), tras ver la anatomía coronaria (mismos criterios de angina estable).
Estrategia conservadora: para pacientes de bajo riesgo (TIMI < 2 puntos), donde solo debemos mantener el manejo farmacológico y seguimiento.

3 factoresn de riesgo CV
Estenosis coronaria > 50%
Uso de ASA en los útimos 7 días
Angina grave en las 24 hrs previas 1

Interpretación
< 2 (riesgo bajo) estrategia conservadora ≥ 2 (riesgo alto) estrategia invasiva


Siempre va acompañado de un ascenso y descenso de marcadores bioquímicos de necrosis (preferentemente, troponina cardiaca T o I), conocido con el nombre de infarto agudo de miocardio con onda Q (IMA + Q).
TIPO I:
Infarto primario producido por una trombosis aguda debido a erosión, ulceración, fisuras, disección o ruptura de una placa aterosclerótica. Es la forma más común de IMA.
TIPO II:
Infarto secundario a un aumento de las demandas de 02 (taquicardia, crisis HTA) o una disminución de la oferta.
TIPO III:
Infarto que produce la muerte súbita con datos sugerentes de isquemia en ECG o necropsia con trombo coronario (los biomarcadores no están disponibles).
TIPO IV:
Infarto relacionado con intervención coronaria percutánea (ACTP).
Tipo 4a: IMA ≤ 48 horas después de ACTP
Tipo 4b: IMA relacionado con la trombosis del stent
Tipo 4c: IMA asociado con reestenosis después de ACTP
TIPO V:
Infarto relacionado con cirugía cardiaca (bypass).








La obstrucción completa de la arteria provoca una elevación del segmento ST cóncava hacia abajo en derivaciones contiguas (> 1 mm en todas las derivaciones) . Por tanto, la localización del infarto se determina por las derivaciones, en las cuales se eleva el segmento ST:
Septal (obstrucción de ADA): V1-V2.
Anterior, incluido el ápex (obstrucción de ADA distal): V3-V4.
Lateral (obstrucción de arteria circunfleja): I, aVL (lateral alto) . V5-V6. (lateral bajo)
Anterior extenso (obstrucción de ADA proximal): V1-V6
Inferior o diafragmática (obstrucción de ADP, rama coronaria derecha): II, III aVF
4


3 (ENARM 2016) (ENARM 2010)


4 (ENARM 2017) (ENARM 2015) (ENARM 2011) (ENAM 2010) (ENAM 2010) (ENAM 2011) (ENAM 2017) (ENAM 2014) (ENAM 2019) (ENAM EXTRA 2020)



DATITO
Que el bloqueo completo de rama izquierda (BCRI) oculta la elevación de ST, por tanto, cuando aparezca esta arritmia, considere un infarto agudo de miocardio con onda Q ( ST = BCRI).


Así mismo, se debe pensar en un infarto de cara posterior (obstrucción de la ADP) cuando observe depresión o infradesnivel del ST en V1-V2, ya que son el espejo de las derivaciones V7-V8 ( ST V7-V8 = ST V1 – V2)

El infarto de la cara inferior (diafragmática) cursa con dolor epigástrico (imitando una dispepsia o enfermedad por reflujo) y bradicardia (estimulo vagal).




Tríada clínica en el infarto del ventrículo derecho: Hipotensión , presión venosa yugular elevaday campos pulmonares limpios (ausencia de crépitos).





El infarto con elevación del ST, generalmente, es transmural o subepicárdico y, por tanto, presentará ondas Q de necrosis (patológica cuando es > 0,04 s, con una amplitud de más del 25 % del QRS)


(ENARM 2010)
2014)





La secuencia de ECG cambia durante varias horas a días: onda T hiperaguda (isquemia) elevación del ST (lesión) onda Q patológica (necrosis) inversión onda T normalización ST normalización de la onda T. 7 (ENARM 2010)
BIOMARCADORES
Las troponinas siguen siendo los biomarcadores de elección para establecer el diagnóstico de infarto agudo de miocardio . Cabe recordar que es importante considerar su cinética para el diagnóstico. Se elevan a partir de las 4 horas y permanecen elevados hasta 10 a 14 días.
En la fase inicial del infarto, como toda emergencia, la secuencia A-B-C , monitorizar al paciente y tener preparadas las técnicas de reanimación (desfibrilador) y la misma secuencia que el síndrome coronario sin elevación del ST (nitroglicerina, betabloqueante, oxigeno, AAS, estatinas).
La diferencia fundamental radica que, en casos de un SICA con elevación del segmento ST, el tratamiento más importante y de elección es la reperfusión con angioplastia (colocación de stent coronario); cuando no esté disponible la alternativa, se tomará la terapia fibrinolítica, cuyo objetivo principal es limitar el área infartada.
Terapia de reperfusión (revascularización)
La ventana terapéutica es de 12 horas desde el inicio de los síntomas, y se indica en pacientes con elevación persistente del segmento ST o bloqueo completo de rama izquierda nuevo (BCRI) . Tenemos dos modalidades: La angioplastia coronaria transpercutánea (ACTP con colocación de stent)

Otras causas de elevación del segmento ST son: pericarditis, embolia pulmonar, hiperkalemia, síndrome de Brugada.

8 (ENARM 2011) (ENARM 2014) (ENARM 2015) (ENARM 2020) (ENARM 2022)
TRATAMIENTO (ENAM 2010) (ENAM 2016) (ENAM 2019) (ENAM EXTRA 2021) (ENAM EXTRA 2022)
Es la estrategia de reperfusión de elección en pacientes con IMA con onda Q (ST elevado o BCRI), siempre que se pueda realizar de manera precoz (< 120 min desde el contacto con el médico).
Se indica, sobre todo, en paciente inestables (edema agudo de pulmón, shock cardiogénico), o cuando esté contraindicada la terapia fibrinolítica.










(ENARM 2019) (ENARM 2007) (ENARM 2021) (ENARM 2023) (ENARM 2007)

La fibrinólisis (trombólisis)

En los casos en los que la angioplastia no pueda realizarse, se debe considerar la fibrinólisis o trombólisis precoz (< 30 min desde el contacto con el médico) como tratamiento alternativo.
Los agentes más utilizados: activador tisular del plasminógeno, como tenecteplasa o alteplasa, una opción menos costosa, pero con resultados inferiores es la estreptoquinasa.
Posfibrinólisis: transfiéralo a una instalación con capacidades de ACTP, así haya sido exitosa la fibrinólisis.
Contraindicaciones absolutas
Accidente cerebrovascular hemorrágico
Accidente cerebrovascular isquémico en los últimos 3 meses
Cirugía intracraneal o intraespinal en los últimos 2 meses
Disección de aorta
Malformación arteriovenosa cerebral (aneurismas)
Neoplasia intracraneal
Diátesis hemorrágica o hemorragia interna activa
Traumatismo encéfalo craneano severo en los últimos 3 meses

¡La revascularización inmediata con angioplastia es el tratamiento de elección en el SICA ST elevado!


Contraindicaciones relativas
HTA mal controlada
PAS actual > 180 mm Hg o PAD > 110 mm Hg
ACV isquémico > 3 meses
Ulcera péptica activa
Embarazo
Endocarditis infecciosa

Tratamiento antitrombótico
Se debe complementar con terapia antiagregante doble con AAS + clopidogrel si el paciente será sometido a fibrinólisis o con AAS + Ticagrerol / Prasugrel si el paciente es candidato a angioplastia (ACTP).
Tratamiento anticoagulante
Indicamos HNF (heparina no fraccionada) o bivalirudina (inhibidor directo de la trombina) si el paciente se somete a ACTP; en caso se indique fibrinólisis, se coloca HBPM (enoxaparina) o fondaparinux, este último si el paciente presenta alto riesgo de hemorragia.
COMPLICACIONES
Arritmias
Es la complicación inmediata más frecuente y principal causa de muerte temprana o extrahospitalaria (muerte súbita cardiaca).
La arritmia más frecuente post IMA es la extrasístole ventricular, pero la que tiene mayor mortalidad es la fibrilación ventricular.
En casos de IMA de cara inferior se produce bloqueo A-V de segundo grado (Mobitz I); en IMA de cara anterior, bloqueo A-V de segundo grado (Mobitz II).


Edema agudo de pulmón

15 (ENARM 2021) 16 (ENARM 2014)





Prasugrel no se administra si hay antecedentes de accidente cerebrovascular previo o ataque isquémico transitorio.

18 (ENAM EXTRA 2021) (ESSALUD 2018)


19 (ENAM EXTRA 2021)

Se produce cuando el infarto afecta a más del 25 % del ventrículo izquierdo y la presión capilar pulmonar es > 25 mmHg.
Se indica furosemida en bolo EV ( precarga).
Shock cardiogénico
Aparece cuando el infarto afecta a más del 40 % del ventrículo izquierdo. Hay hipotensión (presión sistólica menor de 90 mmHg) y datos de hipoperfusión, como oliguria, acidosis metabólica o índice cardíaco bajo (< 2.2 L/minuto/m 2).
Se recomienda inotrópicos (norepinferina o dobutamina).


(ENARM 2021) 20 (ENARM 2021)


Insuficiencia cardiaca
Es la complicación mecánica más frecuente.
Cursa con fracción de eyección baja (sistólica). Es la principal causa de muerte tardía o intrahospitalaria.
Pericarditis
Epistenocárdica: inicio temprano (< 7 días postinfarto) de tipo inflamatorio.
Síndrome de Dressler: inicio tardío (> 7 días postinfarto) de tipo autoinmune.
Otras complicaciones mecánicas
Rotura de músculos papilares insuficiencia mitral aguda (2 a 7 días después del infarto de miocardio)
Rotura del septo interventricular aparición aguda de un soplo pansistólico (3 a 5 días después del infarto de miocardio)
Rotura de pared libre del ventrículo izquierdo produce taponamiento cardíaco (5 y 14 días después del infarto de miocardio) cursa con hipotensión, ingurgitación yugular y ruidos cardíacos apagados (triada de Beck)
Aneurisma ventricular elevación del ST persistente (> 2 - 3 semanas después del IMA)

Tenemos el score de Killip que establece una clasificación clínica radiológica al ingreso del paciente con SCACEST.
También contamos con el score de Forrester, que correlaciona datos hemodinámicos, como índice cardíaco (IC) y presión capilar pulmonar (PCP), así como datos clínicos en los pacientes que sufren una insuficiencia cardiaca tras un infarto de miocardio (IC normal es > 2.2 L/minuto/m 2 y PCP normal < 18 mmHg).

Clase Hallazgos clínicos Mortalidad I Sin signos ni síntomas de 0 a 5%
estertores o crepitantes, 3er ruido o aumento de PV
10 a 20%
Edema pulmonar 35 a 45%
Shock cardiogénico: hipotensión y vasoconstricción periférica

85 a 95%



Un individuo adulto se considera hipertenso cuando presenta una presión arterial en 2 a 3 visitas al consultorio ≥ 140 / 90 mm Hg, o si es ≥ 180/110 mm Hg con evidencia de enfermedad cardiovascular se podría diagnosticar desde la primera visita. Si se sospecha HTA de bata blanca (solo presenta elevación de la presión en el consultorio o en el hospital) o hipertensión enmascarada (solo presenta elevación de la presión fuera del consultorio o del hospital), se debe realizar la automedición de presión arterial domiciliaria (AMPA) o mediante Monitorización Ambulatoria de la Presión Arterial (MAPA).

Criterios de HTA basadas en la consulta, en el monitoreo ambulatorio de la presión arterial (MAPA) y en la automedicación de la presión arterial domiciliaria (AMPA)
Sistólica/diastólica (mmHg)

PA en consulta
MAPA
Promedio en 24 horas
Promedio diur no
Promedio noctur no
AMPA
≥140 y/o 190
≥130 y/o 80
≥135 y/o 85
≥120 y/o 70
≥135 y/o 85

Sexo: más frecuente en mujeres (los hombres tienen peor pronóstico)
Raza: más frecuente, más grave, inicio temprano en la etnia afroamericana

1 (ENAM EXTRA 2020)


(ENAM EXTRA 2022)


Hipertensión en niños < 13 años: la presión arterial ≥ percentil 95 º o presión arterial sistólica ≥ 130 mm Hg y / o la presión arterial diastólica ≥ 80 mm Hg.

Edad: la edad avanzada se asocia con un aumento de la presión, en particular, la presión arterial sistólica
Antecedentes familiares: la hipertensión es, aproximadamente, dos veces más común en sujetos que tienen uno o dos padres hipertensos.
Obesidad: afecta al 60-75 % de los pacientes obesos y con sobrepeso
Hábitos: alcohol en consumos excesivos, tabaquismo y dieta rica en sodio (> 3 g / día)

La presión sistólica (PAS) es predictor de riesgo en pacientes mayores de 50 años. En los menores de 50 años, la presión arterial diastólica (PAD) es un mejor predictor de mortalidad.

Los dos factores de riesgo modificables son el consumo de alcohol y tabaco (ENARM 2011)


Categoría
Sistólica (mmHg)
Diastólica (mmHg)
PA nor mal <130 y <85
PA nor mal – alta (ENAM 2013) 130 - 139 y/o 85 – 89
HTA grado 1 140 – 159 y/o 90 – 99
HTA grado 2 ≥160 y/o ≥100

En HTA grado I controlamos la PA con 1 fármaco y en casos de HTA grado II con 2 fármacos (tiazida + IECA, tiazida + calcioantagonistas) (ENAM 2012)

Hipertensión arterial sistólica aislada
Definida como una PAS ≥140 mmHg y una PAD <90 mmHg. Se trata de pacientes adultos mayores con arteriosclerosis (rigidez arterial).
Hipertensión arterial sistólica y diastólica
Primaria o esencial (90-95 %): se presenta de manera gradual, en una persona entre 35 y 50 años, con antecedentes familiares y factores de riesgo (alcohol, tabaco, obesidad, síndrome metabólico), debido, fundamentalmente, al aumento de las resistencias periféricas.
Secundaria (5-10 %): sospechar cuando tenemos los siguientes datos:
Edad de inicio < de 30 o > 55 años
Inicio brusco de HTA
Empeoramiento brusco de HTA controlada previamente
HTA refractaria (3 fármacos no controlan la presión, incluido diuréticos o 4 fármacos que controlan PA)
HTA con daño de órgano severo
Clínica subyacente de la enfermedad
Las causas de HTA secundaria se mencionan a continuación:

Hipertensión renal
Enfermedad renal crónica o aguda (enfermedad parenquimatosa)
Causa más frecuente de HTA secundaria en adultos mayores
Estenosis de la arterial renal (HTA renovascular)
Se suele presentar con un soplo a nivel abdominal y/o lumbar.
En mujeres jóvenes displasia fibromuscular afectando la parte distal del vaso renal.
En varones mayores de 55 años aterosclerosis afecta al tercio proximal de la arteria renal (50 % de los casos es bilateral).
Tumor de Wilms (nefroblastoma)
Neoplasia maligna renal más común en los niños
Mutaciones genéticas (deleción cromosoma 11)

La causa de elevación de presión arterial en pacientes con estenosis de la arteria renal es por hipoperfusión renal: estimula la secreción de renina por las células yuxtaglomerulares activa al sistema renina angiotensina aldosterona. (ENARM 2013)

Masa abdominal (no sobrepasa la línea media) asociada con hematuria y / o hipertensión
Hipertensión endocrina
Hiperaldosteronismo primario
Cursa con hipertensión, hipopotasemia, cefalea y alcalosis metabólica
Por lo general, se debe a hiperplasia suprarrenal o adenoma suprarrenal (síndrome de Conn)
Síndrome de Cushing
Presenta obesidad central, estrías y cara de luna llena

Feocromocitoma
Triada clásica: cefalea, diaforesis y palpitaciones
Se trata de un tumor en la médula suprarrenal, secretor de catecolaminas
Se asocia con neoplasia endocrina múltiple (MEN tipo 2)
El diagnóstico es con el test de metanefrinas (ácido vanilmandélico)
La localización del tumor se identifica con una tomografía abdominal
Hipertiroidismo



(ENARM 2012) (ENARM 2017) (ENARM 2014) (ESSALUD 2015)


Cursa con intolerancia al calor, pérdida de peso, diarrea, taquicardia, temblor fino y debilidad muscular.
TSH y T4 libre
Hiperparatiroidismo primario
Las manifestaciones incluyen hipercalcemia, nefrolitiasis, dolor de huesos y articulaciones, anorexia, náuseas y estreñimiento.
Calcio sérico, nivel de PTH y fosfatos séricos
Acromegalia
Afección caracterizada por manos / pies agrandados, rasgos faciales toscos y crecimiento patológico de los órganos internos debido al exceso de hormona del crecimiento (GH) en adultos.
Hipertensión neurogénica
Hipertensión intracraneal
Cefalea, vómitos y edema de papila
Triada de Cushing: HTA, bradicardia y alteración de la respiración
Sección medular o polineuritis
Otras causas
Apnea obstructiva del sueño
Presenta ronquidos y somnolencia.
Generalmente, asociado con la obesidad, el consumo de alcohol y el tabaquismo.

Coartación de la aorta
Es la principal causa de hipertensión secundaria en los niños.
Defecto cardíaco congénito que implica el estrechamiento de la aorta en el istmo aórtico.
La forma más frecuente es postductal.
Presenta pulsos femorales disminuidos, presión en brazos mayor al de piernas.
Se asocia con válvula aórtica bicúspide (principal causa de estenosis aórtica en jóvenes) y síndrome de Turner.
Fármacos
Anticonceptivos orales, en particular los que contienen dosis más altas de estrógeno
AINES
Corticoides
Eritropoyetina
Ciclosporina
Drogas
Cocaína (inhibe la recaptación de norepinefrina)
Anfetaminas (aumenta la liberación de norepinefrina)


(ENARM 2006)


(ENAM 2020) (ENARM 2006) 4 3 4 5 5 (ENAM EXTRA 2020)



Aumentan la resistencia vascular periférica por el estímulo de los receptores alfa 1 (vasoconstricción)


La HTA supone un aumento de la poscarga para el ventrículo izquierdo, lo que produce una hipertrofia concéntrica. Con el tiempo, se produce insuficiencia cardiaca de tipo diastólico (altera el llenado) y luego, de tipo sistólico, por enfermedad coronaria.





La cardiopatía hipertensiva es la principal causa de muerte en el hipertenso. Puede diagnosticarse mediante criterios en el electrocardiograma (eje desviado a la izquierda entre - 30 a - 90 grados , ondas R altas > 25 mm, sokolow positivo), pero la prueba más sensible y de elección es el ecocardiograma. La HTA es el factor de riesgo más común de disección aórtica y también está asociado a la enfermedad de las arterias periféricas.





Sistema nervioso central
La hipertensión es el factor de riesgo más importante para el accidente cerebrovascular. La forma más frecuente es un infarto cerebral (isquemia) por trombosis , pero también predispone a hemorragia cerebral (rotura de microaneurismas de Charcot-Bouchard), cuya localización más típica es ganglios basales: putamen, en primer lugar. También puede producir síntomas comunes como cefaleas occipitales matutinas, mareos, vértigo, tinnitus, alteraciones visuales o síncope; sin embargo, la encefalopatía hipertensiva constituye una complicación aguda donde se altera la conciencia (confusión, estupor o coma).

ISQUÉMICO


(ENARM 2015) 3 (ENARM 2009) 4



Los cambios retinianos producidos por la HTA se clasifican según Keith-Wagener:
Grado I: vasoconstricción arterial y venas dilatadas, relación arteria/vena de 1:3
Grado II: arterias con brillantez, aumentada por esclerosis (hilo de plata y cobre) y signo de cruce arterio-venoso (Gunn y Salus)
Grado III: hemorragias y/o exudados algodonosos
Grado IV: edema de papila o atrofia óptica
El grado I-II representa el estadio crónico y tiene mejor pronóstico en comparación con el grado III-IV, que definen la HTA maligna, cuadro agudo que se asocia a mayor mortalidad.












RIÑÓN 6
La HTA es la segunda causa más frecuente de insuficiencia renal terminal (después de la diabetes).
La HTA produce arteriosclerosis de las arteriolas aferente y eferente, lo que causa disminución de la filtración glomerular y disfunción tubular.
Existen dos formas de angioesclerosis: la benigna hialina (depósito de proteínas debajo del endotelio) y la maligna hiperplásica (proliferación del músculo liso a nivel subendotelial en respuesta a una presión arterial muy alta).
Se manifiesta con proteinuria y hematuria.


(ENARM 2001) 6




Tratamiento no farmacológico


El tratamiento inicial consiste en promover estilos de vida saludable
Pérdida de peso (1 mmHg por cada 1 kg de reducción de peso), es el más efectivo
Dieta mediterránea: DASH (8-14 mmHg, rica en frutas y vegetales), tiene más impacto
Dieta baja en sal (< 6g) o sodio (< 2g) y rica en potasio (3.5 a 5 gr/día)
Ejercicio físico aeróbico (30-60 minutos, 5 a 7 días de la semana)
Consumo moderado de alcohol (10 a 20 gr al día), es cardioprotector
Tratamiento farmacológico



Diuréticos: hidroclorotiazida
Indicaciones
Contraindicaciones
Dejar de fumar: 3-5 mmHg después de 1 año 1 2



(ENAM 2017)
(ENARM 2016) 1 2 (ENARM 2010) 3

(ENARM 2018) 4

La terapia antihipertensiva farmacológica produce una del riesgo relativo de casi el 50 % en la incidencia de insuficiencia cardiaca, una del 30 al 40 % de accidente cerebrovascular y una del 20 al 25 % de infarto de miocardio.
HTA en adultos mayores
HTA sistólica aislada
HTA con osteoporosis
HTA en pacientes de etnia afroamericana

Reacciones adversas
Gota ( ácido úrico)
Dislipidemias
3 4 5
Síndrome metabólico
Hipercalcemia
Hiponatremia, hipokalemia, hipercalcemia, alcalosis metabólica
Pancreatitis aguda
Trombocitopenia

(ENARM 2021) 5


Inhibidores de la ECA (IECA: Captopril, Enalapril) -
Antagonistas de los receptores de la angiotensina II (ARA II: Losartán, Valsartán)
Indicaciones
HTA con diabetes mellitus
HTA con proteinuria o microalbuminuria
HTA de etnia caucásica
HTA con infarto agudo de miocardio (cardiopatía isquémica)
HTA con insuficiencia cardiaca sistólica (fracción de eyección deprimida)
HTA con hipertrofia ventricular izquierda (efecto antirremodelador)
HTA con enfermedad renal crónica (TFG > 30 ml/min o niveles K normales)




(ENARM 2004) (ENARM 2017) (ENARM 2020) 6

(ESSALUD 2010)

(ENARM 2017) (ENARM 2020) 7 (ESSALUD 2010) (ENAM 2020)




(ENARM 2005)

(ENAM 2020)
Una clase novedosa de antihipertensivos son los inhibidores directos de la renina (aliskirem), (ENARM 2015) que, al igual que los IECA y ARA II, bloquean el sistema renina angiotensina aldosterona.
Figura 29. Fármacos que bloquean al sistema renina angiotensina: DRI: inhibidores directos de la renina como aliskirem, ACE-I: inhibidores de la enzima convertidora de angiotensina como captopril o enalapril, ARB: bloqueadores de los receptores de angiotensina II como valsartán o losartán.

Contraindicaciones
Embarazo (son teratogénicos, FDA: clase D)
Estenosis bilateral de la arteria renal
Falla renal avanzada con hiperpotasemia
Reacciones adversas
Tos seca vespertina (RAM más frecuente de los IECA)
Angioedema que cursa con edema facial a predominio de párpados y labios (RAM más severa de IECA inducido por bradicinina)
Teratogenicidad (hipoplasia pulmonar, oligohidramnios), tanto IECA como ARA II

Cuando un paciente no tolera los IECA por los efectos adversos, se indica ARA II.

(ESSALUD 2019)




(ENARM 2004) (ENAM 2020)
(ENARM 2020)



30. Angioedema producido por IECA, inducido por el bradicinina.

Calcioantagonistas: Nifedipino, Amlodipino, Verapamilo, Diltiazem
Indicaciones
HTA en adultos mayores
HTA de etnia afroamericana
HTA sistólica aislada
HTA con fenómeno de Raynaud
HTA con angina de Prinzmetal
HTA con enfermedad renal avanzada (TFG < 30 ml/min o niveles de K > 5.5)
TA con arritmias supraventriculares
Contraindicación
Insuficiencia cardiaca sistólica




(ESSALUD 2015) (ENARM 2004) (ENARM 2019) (ESSALUD 2015)
Reacciones adversas (ENARM 2004)




Edemas (más frecuente) Cefalea Taquicardia refleja (nifedipino) Constipación
BETABLOQUEANTES: Metoprolol, Bisoprolol, Propranolol
Indicaciones
HTA con arritmias supraventriculares
(fibrilación auricular)
HTA con hipertiroidismo
HTA con migraña
HTA con temblor esencial
HTA con angina de esfuerzo
Hipertensión y gestantes

Contraindicaciones
Insuficiencia cardiaca descompensada EPOC o asma severa (no selectivos: propranolol)
Bloqueos A-V de segundo y tercer grado
Insuficiencia aórtica
Seguros: labetalol, nifedipino, metildopa e hidralacina
Contraindicados:IECA (enalapril), ARA II y nitroprusiato
También el manejo puede enfocarse según comorbilidades:
Hipertensión y cardiopatía isquémica:
El manejo debe incluir: IECA (ARA II) o betabloqueantes
Tratamiento hipolipemiante con un objetivo de LDL < 55 mg /dL
Tratamiento antiplaquetario con ácido acetilsalicílico de forma rutinaria
Hipertensión y ataque cerebrovascular previo:

Recuerda los beta bloqueadores cardioselectivos (beta 1) con la nemotecnia
MABE: Metoprolol, Atenolol (ENARM 2006), Bisoprolol y Esmolol.

(ESSALUD 2023)


(ENARM 2014) (ENARM 2018) 17



IECA (ARA II) + calcio antagonistas o IECA (ARA II) + diuréticos, son medicamentos de primera línea
El tratamiento hipolipemiante con un LDL objetivo < 70 mg / dL
El tratamiento antiplaquetario se recomienda habitualmente para el accidente cerebrovascular isquémico, pero no para el hemorrágico.
Hipertensión e insuficiencia cardiaca (IC):
Manejo con IECA (ARA II) + betabloqueantes + espironolactona (antagonistas de los receptores de mineral o corticoides) son efectivos para mejorar el resultado clínico y bajar la mortalidad, mientras que, para los diuréticos, la evidencia se limita a la mejoría sintomática.
Hipertensión y enfermedad renal crónica (ERC)
Los IECA y ARA II son medicamentos de primera línea porque reducen la albuminuria, además de lograr adecuado control de la PA. Se usan siempre y cuando la TFG > 30 ml/min o niveles K normales.
Los reemplazamos con calcioantagonistas si la TFG <30 ml / min / 1.73m2 o si los niveles de potasio están elevados
HTA y Diabetes
La estrategia de tratamiento debe incluir IECA (ARA II) + calcioantagonistas o IECA (ARA II) + diuréticos
El tratamiento debe incluir una estatina y lograr metas de reducción de LDL (menor a 70 mg / dL. o menor a 100 mg / dL, según la presencia o ausencia de daño de órgano, respectivamente).

(ENARM 2004) (ENARM 2019) 18 (ENARM 2017) (ENARM 2004) (ENARM 2020) 18



Importante aumento agudo de la presión arterial (presión sistólica ≥ 180 mmHg, diastólica ≥ 120 mmHg). Se evidencia:
URGENCIA HIPERTENSIVA
El paciente está sintomático (cefalea, mareos y/o vértigo), pero sin falla de órgano. Permite la reducción de la presión durante las primeras 24 horas, con tratamiento por vía oral (captopril).





2 1 (ENAM 2019)

1 (ENARM 2015) (ENARM 2019)


EMERGENCIA HIPERTENSIVA
El paciente presenta alteraciones orgánicas graves que comprometen la vida de modo inminente: encefalopatía hipertensiva (alteración del sensorio confusión, visión borrosa) , eclampsia (convulsión), edema agudo de pulmón (crépitos difusos), infarto agudo de miocardio, accidente cerebrovascular (déficit neurológico focal), retinopatía hipertensiva grado III – IV, disección de aorta (dolor torácico lancinante + pulsos asimétricos + ensanchamiento mediastino) o insuficiencia renal aguda (azoemia y / u oliguria, edema).
Requiere tratamiento endovenoso inmediato para reducir la presión un máximo de un 25 % de la basal . Tenemos algunas excepciones, en caso de un accidente cerebrovascular isquémico, no se reduce a menos que sea ≥ 185 / 110 mmHg en pacientes que son candidatos para la terapia de reperfusión (trombolítica) o ≥ 220/120 mmHg en pacientes que no son candidatos para la terapia de reperfusión, otro caso es la disección de aorta donde debemos conseguir de forma inmediata presiones sistólicas entre 100 y 120 mmHg (que se alcanzará en 20 minutos).
Los fármacos usados son:
Hidralacina: se emplea en HTA grave en gestantes (no disponible en Perú). Un efecto colateral es un síndrome tipo lupus y edema pulmonar.
Nitroglicerina: empleado en síndrome coronario agudo (angina inestable), la HTA después de la cirugía de derivación coronaria y en edema agudo de pulmón hipertensivo.
Furosemida: empleado en edema agudo de pulmón normotensivo.
Fentolamina o Fenoxibenzamina (alfa1 y alfa2 bloqueante): indicado en las crisis hipertensivas del feocromocitoma.
Labetalol: utilizados en casos de disección de aorta, gestantes con preeclampsia severa, accidente cerebro vascular y síndrome coronario agudo.
Nitroprusiato: relaja el músculo liso arterial y venoso (antihipertensivo más potente), elegido en casos de emergencias hipertensivas severas y refractarios (edema agudo de pulmón hipertensivo que no responde a nitroglicerina , disección de aorta que no responde a labetalol).

(ENARM 2023) (ENARM

(ESSALUD 2023) 4 5 6
Urgencia hipertensiva




Emergencia hipertensiva

Cefalea
Mareo, vértigo
Epistaxis






Inquietud, insomnio

Hemorragia intracraneal, apoplejía
Encefalopatía hipertensiva
Hemorragia retiniana
hipertensiva, infarto de miocardio
Edema pulmonar
Disección aórtica
Falla renal


ETIOLOGÍA
Las causas más frecuentes son la idiopática y la viral, donde destaca el virus coxsackie (tipos B) (pertenece al género enterovirus familia picornavirus)
En casos bacterianos (purulenta), se detectan estafilococo y estreptococo
Tuberculosis (cuadros subagudos a crónicos, principalmente)
Infarto de miocardio
Síndrome de Dressler: semanas a meses después de un infarto
Uremia (debido a insuficiencia renal)
Radiación
Neoplasia (linfoma de Hodgkin, cáncer de mama o pulmón)



Enfermedades autoinmunes del tejido conectivo (artritis reumatoide, lupus sistémico)
Trauma
FISIOPATOLOGÍA
Dolor retroesternal agudo y subagudo causado por inflamación de la pleura parietal que presenta inervación.

DIAGNÓSTICO
Dolor retroesternal (irradia a espalda y hombro izquierdo) típicamente agudo y pleurítico (hincada), que al sentarse e inclinarse hacia adelante y con el decúbito o inspiración.
En el examen físico, se advierte frote o roce pericárdico (forma seca); también se observa al signo de Ewart (matidez subescapular izquierdo por colapso alveolar a causa de un derrame pericárdico) en casos de pericarditis húmeda.
En el ECG, se establecen 4 fases:
I: Elevación del segmento ST de forma difusa (con la concavidad hacia arriba) , asociado a infradesnivel del PR (cambio + precoz)
II: A los 3-4 días, el segmento ST se vuelve isoeléctrico.
III: Posteriormente, onda T negativa y simétrica.
IV: Finalmente, hay un retorno a lo normal (en 2-3 meses).
En casos de derrame, hay alternancia del eje eléctrico.


DATITO
Derrame pericárdico severo da imagen en botellón en la radiografía de tórax. (ENAM EXTRA 2021)

(ENAM EXTRA 2022) (ENARM 2021)
(ENAM 2020)


3 (ESSALUD 2013) (ENARM 2021) (ENAM EXTRA 2022)





del ST cóncava hacia arriba) (ENARM 2021)
Ecocardiograma
Confirma el derrame pericárdico (efusión > 50 ml).


Figura 34. Alternancia eléctrica que se caracteriza por alternancia de latido a latido en la apariencia del QRS (se observa mejor en las derivaciones V2 a V4). Estos hallazgos sugieren fuertemente un derrame pericárdico.

Espacio anecoico entre el pericardio y el epicardio evalúa el volumen.
<10 mm: pequeño (300 ml)
10-20 mm: moderado (500 ml) > 20 mm: severo (> 700 ml)

DATITO
La ecocardiografía es la prueba de elección para detectar derrames pericárdicos y taponamiento pericárdico.
Criterios para hospitalización:
Fiebre > 38 grados
Curso subagudo (> 6 semanas)
Compromiso hemodinámico (taponamiento cardíaco)
Inmunosupresión
TRATAMIENTO
Para casi todos los pacientes con pericarditis aguda idiopática o viral, se recomienda la terapia combinada de AINES a dosis altas (aspirina 650 a 1000 mg tres veces al día, ibuprofeno 600 a 800 mg tres veces al día) más colchicina, esta última disminuye la recidiva.


pericárdico.

COMPLICACIONES
Pericarditis constrictiva
Trauma agudo
Tratamiento con anticoagulantes
Elevación de troponinas (miopericarditis)
Considere la prednisona solo en casos graves o en pericarditis causada por enfermedad del tejido conectivo.
Antibióticos para causas bacterianas.
Diálisis, en el caso de uremia.

Signo de Kussmaul: PVC (ingurgitación yugular) con inspiración.
Pulso paradojal
Taponamiento cardíaco
Triada de Beck: PA + PVC (ingurgitación yugular) + ruidos cardíacos.
Pulso paradojal


(ENARM 2020) (ENARM 2022) (ENAM EXTRA 2021) (ENAM EXTRA 2022) 4 4


EPIDEMIOLOGÍA
Se presenta en 1 al 2 % de los pacientes con tuberculosis pulmonar
Paciente con VIH casos de tuberculosis pericárdica.
PATOLOGÍA
FISIOPATOLOGÍA
Diseminación hematógena desde el lugar de la infección primaria
Diseminación linfática retrógrada de los ganglios linfáticos hiliares

Frente a un derrame sanguinolento, se debe pensar en tuberculosis, cáncer (linfoma, melanoma, cáncer de mama o pulmón) o cirugía poscardiaca.

Presenta las siguientes etapas patológicas:
Etapa 1: exudado fibrinoso que contiene neutrófilos y micobacterias
Etapa 2: derrame serosanguinolento con linfocitos, alta concentración de proteínas y micobacterias
Etapa 3: absorción de derrames y granulomas caseificantes.
Etapa 4: cicatrización con calcificación, lo que lleva a una pericarditis constrictiva ( diástole)

DIAGNÓSTICO
Síntomas constitucionales ( peso, fiebre y diaforesis vespertina)
Tos Dolor torácico
Disnea
Hallazgos clínicos típicos de pericarditis
Ecocardiografía: derrame o disminución de la motilidad de la pared, con evidencia de engrasamiento pericárdico, formación de puentes filamentosos y adherencias lineales (“corazón velludo”)
Pericardiocentesis:
Análisis: exudativo (purulento) o sanguinolento, proteínas y linfocitos
Microbiología: tinción ácido-resistente, PCR y cultivo
Adenosina desaminasa (ADA) > 30 a 60 unidades / L
Biopsia pericárdica: en casos dudosos después de una evaluación completa.
TRATAMIENTO
Derrame pericárdico (raramente, taponamiento cardíaco)
Pericarditis constrictiva
Pericarditis efusivo-constrictiva







Antituberculosos: el mismo que se sigue ante una tuberculosis pulmonar
Corticoides: prevención de la pericarditis constrictiva
Pericardiocentesis terapéutica
Pericardiectomía:
Pericarditis constrictiva persistente
Pacientes con hemodinámica que no mejora o hemodinámica que se deteriora después de cuatro a ocho semanas de tratamiento antituberculoso

DEFINICIÓN

La pericarditis constrictiva es el resultado de la formación de cicatrices y la consiguiente pérdida de la elasticidad normal del saco pericárdico.

PATOGENIA
La fibrosis o calcificación producto de la cicatrización reduce el llenado ventricular (diástole) en sus dos tercios finales elevación de la presión venosa sistémica y pulmonar.
ETIOLOGÍA
La causa más frecuente es idiopática o viral (40-60 %), seguido de la etiología postratamiento (después de cirugía cardiaca o radioterapia).



DIAGNÓSTICO
Clínica de falla cardiaca derecha (congestión sistémica): edemas, ascitis severa, hepatomegalia, esplenomegalia.
Signo de Kussmaul: distensión venosa yugular aumenta en inspiración.
Pulso paradójico: presión arterial sistólica > a 10 mmHg durante la inspiración.


Pulso venoso yugular: aumento de prominencia y profundidad del seno Y.



El pulso paradojal se presenta en varias entidades como taponamiento cardíaco (ENARM 2022), embolismo pulmonar, pericarditis constrictiva y crisis asmática severa.

Confirman el diagnóstico pues detectan un pericardio engrosado, con frecuencia calcificado, las imágenes de elección son: la tomografía o resonancia magnética (cabe resaltar el diagnóstico diferencial con la miocardiopatía restrictiva).
Las pruebas de imagen TRATAMIENTO
La pericardiectomía (mortalidad operatoria del 7-10 %) es la única opción de tratamiento definitivo para los pacientes con pericarditis constrictiva crónica, que tienen síntomas persistentes y prominentes.







La miocarditis es una enfermedad inflamatoria del músculo cardíaco, diagnosticada mediante biopsia endomiocárdica.



A menudo ocurre en pacientes jóvenes (edad promedio: 40 años)
En aproximadamente el 10% de las muertes súbitas en adultos jóvenes, la miocarditis se diagnostica en el examen post mortem


INFECCIOSA
Hasta el 50% de los casos de miocarditis se clasifican como idiopáticos.
Viral: Es la causa más frecuente, siendo Coxackie B1-B5 (picornavirus) el más asociado.
Con frecuencia va precedida de una infección de las vías respiratorias altas.
Bacteriana: Destaca difteria (Corynebacterium diphtheriae) en la que la afectación cardíaca representa la causa más frecuente de muerte
Protozoos: En estos casos tenemos Toxoplasma gondii (suele afectar a adultos inmunodeprimidos) y Tripanosoma cruzii (enfermedad de Chagas).
NO INFECCIOSA
Cardiotoxinas: Alcohol, antraciclinas (doxorrubicina), arsénico, cocaína, ciclofosfamida, Intoxicación por monóxido de carbono, veneno de viuda negra.
La enfermedad celiaca y enfermedad de Kawasaki también se asocian a miocarditis.

Fiebre, fatiga, dolor torácico (pacientes jóvenes), palpitaciones y clínica de insuficiencia cardíaca aguda (disnea, ingurgitación yugular y/o edema)
Laboratorio: Aumento transitorio de troponinas y CPK-MB (dato diferencial con pericarditis), elevación del segmento ST de forma difusa (miopericarditis)
1

ECG:
Arritmias supraventriculares (taquicardia sinusal o extrasístoles)
Bloqueos cardíacos (enfermedad de Lyme)
Radiología:
Cardiomegalia
Signos de congestión pulmonar.
Biopsia de miocardio:
Mediante cateterismo cardíaco y biopsia asistida por resonancia magnética
Se indica en casos de Insuficiencia cardíaca de nueva aparición, arritmias graves y resistencia al tratamiento

1 (ENAM EXTRA 2022)


Progresión a miocardiopatía dilatada (15% de los casos)

Insuficiencia cardíaca o muerte cardíaca súbita: probablemente debido a arritmias ventriculares (común en adultos <40 años)
Bloqueo auriculoventricular (Enfermedad de Lyme)


Reposo y manejo de la insuficiencia cardíaca y de las arritmias. Las posibles opciones para los pacientes refractarios a pesar de la terapia médica óptima incluyen el apoyo circulatorio mecánico
Dispositivos de asistencia ventricular
Trasplante cardíaco
En algunos casos se indica tratamiento inmunosupresor (miocarditis de células gigantes, sarcoidosis, miocarditis eosinofílica, miocarditis lúpica)


Definición
Son patologías intrínsecas del miocardio, generalmente primarias (etiología desconocida).


EPIDEMIOLOGÍA
Incidencia: 6 / 100.000 por año (miocardiopatía más común)
Sexo: > (aprox. 3: 1)
FISIOPATOLOGÍA 1
Existe una disminución del grosor de la pared ventricular produce falla sistólica (Fracción de eyección < 50 %).

DATITO

1 (ENAM 2011)

Gen TTN Gen en el brazo largo del cromosoma 2 codifica la titina, un componente estructural y funcional de los sarcómeros un defecto en este gen es una causa común de miocardiopatía dilatada familiar.
ETIOLOGÍA
Primaria: idiopática (50 % casos)
Secundaria:
Alcohol: causa secundaria más frecuente (reversible con abstinencia)
Miocarditis por virus (Echo, coxackie, parotiditis, VIH) , bacteriana (enfermedad de Lyme), micótica, protozoos (enfermedad de Chagas)
Alteraciones de electrolitos (hipocalcemia e hipofosfatemia)
Deficiencias nutricionales: tiamina (beriberi húmedo), selenio y niacina
Enfermedades neuromusculares (distrofia de Duchenne)
Fármacos (doxorrubicina, trastuzumab, hidroxicloroquina y clozapina)
Síndrome de Takotsubo (disfunción apical transitoria, reversible, inducido por estrés, similar a un cuadro isquémico coronario)
5



2 (ENAM EXTRA 2021)


3 (ENAM 2017)

DIAGNÓSTICO
Síntomas de insuficiencia cardiaca congestiva (disnea y edemas)
Pulso dicroto
Embolismos (asocia a fibrilación auricular)
Ritmo de galope: R3 ( sístole)
ECG: fibrilación auricular (ausencia de onda P y QRS irregulares)
Radiografía: cardiomegalia con hipertensión venosa pulmonar





4 (ESSALUD 2019)


5 (ENAM 2020)


6 (ENAM 2011)


TRATAMIENTO
Dieta hiposódica, diuréticos e IECA (similar a una insuficiencia cardiaca)
Colocación de DAI Si FEVI <35 % para prevenir la muerte cardiaca súbita causada por fibrilación ventricular
Cuando la enfermedad está avanzada y es refractaria al tratamiento médico, trasplante cardíaco (causa más frecuente en jóvenes).


GENERALIDADES
Segunda miocardiopatía más común
Se distinguen dos tipos:
Obstructiva: 70 % de los casos
Tipo no obstructivo: 30 % de los casos
Constituye la causa más frecuente de muerte súbita cardiaca en pacientes jóvenes, especialmente en deportistas de alta competencia.
Enfermedad cardiaca hereditaria más común.
FISIOPATOLOGÍA
Aumento de grosor del ventrículo izquierdo (su forma más frecuente es la hipertrofia septal asimétrica):
Alteración de la función diastólica (Fracción de eyección conservada)
Obstrucción del tracto de salida del ventrículo izquierdo (70 % de los casos)
ETIOLOGÍA

La miocardiopatía dilatada es la causa más frecuente de trasplante cardiaco en jóvenes y la cardiopatía isquémica en adultos.




(ENAM 2017) (ENAM 2020)

Primaria: herencia autosómica dominante (mutación en cadena pesada β de la miosina)
Secundaria: Ataxia de Friedreich
DIAGNÓSTICO
Disnea angina de pecho síncope (tipo obstructivo)
Pulso bisferiens
Arritmias ventriculares (muerte súbita en deportistas de competencia)
Soplo sistólico (formas obstructivas la maniobra de Valsalva y cuclillas o elevación pasiva de piernas)
Ritmo de galope: R4 ( diástole)
Síntomas: empeoran con el ejercicio, la deshidratación y el uso de fármacos inotrópicos positivos (digoxina)
ECG:
La combinación de hipertrofia de ventrículo izquierdo con agrandamiento de la aurícula derecha es muy sugestiva de esta miocardiopatía.
Se pueden observar ondas T profundamente invertidas (“ondas T negativas gigantes”) en las derivaciones precordiales. Presencia de arritmias ventriculares.
Ecocardiograma:
Aumento inexplicable de un espesor de la pared del ventrículo izquierdo ≥ 15 mm.
En las formas obstructivas, se observa el movimiento anterior sistólico (SAM) de la válvula mitral.


(ENAM 2017) (ENAM 2020)



TRATAMIENTO
Inotrópicos negativos: betabloqueantes o antagonistas del calcio
Antiarrítmicos: betabloqueadores; en casos refractarios, amiodarona
3
Miotomía de Morrow: resección quirúrgica del septum interventricular
Desfibrilador automático implantable (DAI): en pacientes con alto riesgo de muerte súbita por arritmias ventriculares
Paro cardíaco previo
Arritmias ventriculares sostenidas
Hipertrofia severa > 30 mm
Síncopes de causa desconocida
Historia familiar de muerte precoz
Hipotensión al ejercicio
Aneurisma apical de ventrículo izquierdo
Fracción de eyección < 50 %

La digoxina está contraindicada en la miocardiopatía hipertrófica por ser un inotrópico positivo.

3 (ENAM EXTRA 2020)

Trasplante de corazón: considerar en la forma no obstructiva en etapa terminal cuando la FEVI ≤ 50 %.



EPIDEMIOLOGÍA
Es la miocardiopatía menos común (representa ∼ 5 % de todas las miocardiopatías).
FISIOPATOLOGÍA
Produce una falla diastólica (Fracción de eyección conservada) debido al endurecimiento o infiltración de las paredes ventriculares (no hay hipertrofia ni dilatación).



ETIOLOGÍA
Primaria: idiopática
Secundaria:
Amiloidosis (causa más frecuente)
Hemocromatosis
Enfermedad por depósito de glucógeno
Sarcoidosis
Infiltración neoplásica
Casi todos los casos de amiloidosis cardiaca clínica (> 95 %) son causados por transtiretina (ATTR) o cadenas ligeras (AL).
DIAGNÓSTICO
Disnea (+ común)
Edema, ascitis e ingurgitación yugular (insuficiencia cardiaca derecha)
Signo de Kussmaul (similar a la pericarditis constrictiva)
Ritmo de galope: R4 ( diástole)
En la clínica extracardiaca de la amiloidosis, destaca la presencia de síndrome nefrótico, macroglosia, síndrome del túnel carpiano, etc.
Péptido natriurético cerebral (≥ 400 pg/ml) (diferenciarla de pericarditis constrictiva)
ECG: complejos QRS de bajo voltaje (amiloidosis cardiaca)
Ecocardiograma: engrosamiento simétrico de las paredes ventriculares; en amiloidosis, se denomina “corazón moteado”
Manejo de la insuficiencia cardiaca (diuréticos, IECA, betabloqueantes)
Hemocromatosis: flebotomías y quelantes del hierro (dexferroxamina)
Amiloidosis AL: quimioterapia (melfalán, dexametasona, bortezomib)
Amiloidosis ATTR: tafamidis o, en casos avanzados, trasplante doble (cardiaco y hepático)


Es una infección del endocardio de las válvulas (superficie anterior).

Válvula nativa:

Las válvulas derivan embriologicamente de las almohadillas endocárdicas y el corazón del mesodermo visceral. (ENARM 2023)

Endocarditis aguda causa más frecuente estafilococo aureus (estafilococo dorado) suele afectar a las válvulas sanas por lo general, fatal en 6 semanas si no se trata
Endocarditis subaguda causa más frecuente estreptococos del grupo viridans válvulas nativas dañadas previamente causa común de después de procedimientos dentales
En casos de estreptococo bovis se asocia con cáncer o pólipo en el colon.
Enterococos (especialmente, Enterococcus faecalis) causa común después de ITU nosocomiales
Endocarditis micótica causa más frecuente Cándida parapsilosis pacientes inmunodeprimidos (VIH o trasplante de órganos)

Válvula protésica (marcapasos o DAI):
Precoz: < 1 año tras la cirugía la etiología más frecuente es el estafilococo epidermidis (coagulasa negativo)
Tardía: > 1 año tras la cirugía destaca estafilococo aureus (coagulasa positivo)
ADVP (Adictos a droga por vía parenteral):
El germen más frecuente es S. aureus la válvula más afectada es la tricúspide


Las vávulas más afectadas son las izquierdas, aórtica seguida de la mitral y la válvula tricúspide es la válvula más comúnmente afectada en usuarios de drogas intravenosas (asociada S. aureus) (ENARM 2009)

(ENAM 2012) (ENAM 2009) (ESSALUD 2018)


2 (ENARM 2009)

Existen cardiopatías o procesos subyacentes que predisponen a una endocarditis:
Episodio previo de endocarditis
Prótesis valvulares (mecánicas o biológicas)
Valvulopatía reumática (estenosis o insuficiencia)


(ESSALUD 2012)

Cardiopatías congénitas (cianóticas > acianóticas), excepto CIA (comunicación interauricular)


El flujo turbulento daña el endotelio de las válvulas activando la hemostasia y se forman vegetaciones asépticas formadas por plaquetas y fibrina (trombo estéril). Luego, estas se contaminan debido a una bacteriemia por un foco séptico, formándose una verruga bacteriana (vegetación séptica), la cual puede destruir la válvula (rotura de cuerdas tendinosas, músculo papilar) y formar abscesos, produciendo la clínica cardiaca; los émbolos sépticos que pasan a la circulación sistémica dan lugar a la clínica extracardiaca (en casos de ADVP, predominan los émbolos pulmonares).

Endocarditis no infecciosa como la Endocarditis de Libman-Sacks lupus eritematoso sistémico o síndrome antifosfolípido y la endocarditis marántica se asocia a estados de hipercoagulabilidad (cáncer, enfermedades autoinmunes, VIH)





CLÍNICA
La triada clínica es fiebre (95 %), soplo de regurgitación (85 %) y esplenomegalia (30 %) . Además, podría haber clínica extracardiaca producto de los émbolos sépticos al territorio de la arteria cerebral media, como hemiparesia por un ictus isquémico en pacientes jóvenes o manifestaciones embólicas pulmonares (tos, disnea y hemoptisis), que son más frecuentes en los pacientes ADVP.
LABORATORIO



(ENAM 2011) 2 (ENAM 2017) (ENARM 2017) 3. (ENAM EXTRA 2020) (ENAM 2020)



Pueden incluir marcadores inflamatorios elevados (velocidad de sedimentación globular y/o proteína C reactiva elevada), anemia normocrómica - normocítica y factor reumatoide positivo.

CRITERIOS MAYORES
Hemocultivos positivos (95% de casos) para microorganismos típicos:
Estreptococos, Estafilococo y Enterococo
En caso de Coxiella Burnetii serología: IgG anticuerpo > 1:8000 Ecocardiografía positiva (80 % de casos)



2 (ENAM 2011) (ENARM 2015) (ENAM EXTRA 2020) (ENAM EXTRA 2023) 1
Masa oscilante sugerente de verruga o absceso o dehiscencia de prótesis.
Nueva regurgitación valvular (el aumento o cambio en el soplo preexistente)


(ENAM 2011) 3 (ESSALUD 2012) (ENARM 2016) (ENARM 2015)



Lesión predisponente o ADVP
Fiebre > 38°
Fenómenos embólicos: aneurismas micóticos (10 %), hemorragias conjuntivales, hemorragias “en astilla” en el lecho subungueal las lesiones de Janeway (indoloras, rojizas, en palmas y plantas).
Fenómenos inmunológicos: factor reumatoide positivo, nódulos de Osler (dolorosos, aparecen en los pulpejos y las manchas de Roth en el fondo de ojo).
Hemocultivos positivos que no alcanzan el criterio mayor.




La endocarditis infecciosa debe considerarse siempre como causa de fiebre de origen desconocido, especialmente en presencia de un nuevo soplo cardiaco.


El diagnóstico definitivo de endocarditis infecciosa se establece en presencia de cualquiera de los siguientes:
Criterios patológicos
Lesiones patológicas: como vegetación o absceso intracardiaco que demuestran endocarditis activa en la histología. Microorganismos: demostrados por cultivo o histología de una vegetación o un absceso intracardiaco.
Criterios clínicos
2 mayores, un mayor y 3 menores o 5 menores.





5 (ENARM 2023)


6 (ENARM 2023) (ENARM 2022)


4 (ENAM 2017) (ENARM 2022) (ENAM 2019)




Cardiacas (50 %): la insuficiencia cardiaca es la causa más frecuente de muerte, por insuficiencia valvular. Presencia de infartos de miocardio (émbolos sépticos en las arterias coronarias), bloqueos auriculo-ventriculares (descartar abscesos septales).
Cerebrales (40 %): las embolias más importantes y los aneurismas micóticos suelen afectar al territorio de la arteria cerebral media, que genera infartos en jóvenes.
Émbolos sépticos sistémicos:
Se producen infartos por los émbolos y glomerulonefritis que cursa con hematuria, proteinuria y pueden llevar a falla renal. También se reporta infarto de bazo y otros órganos. En pacientes con endocarditis derecha, se pueden observar émbolos pulmonares sépticos (ADVP).


El tratamiento antibiótico es de elección, usando sinergia: betalactámico + aminoglucósido.
Estreptococos
Sensible: penicilina G / ceftriaxona + gentamicina
En alérgicos o resistentes a betalactámicos: vancomicina + gentamicina
Estafilococos
Válvula nativa:
Sensible (SAMS): oxacilina / cotrimoxazol + clindamicina
Resistente (SAMR): vancomicina / daptomicina (más efectivo)
Válvula protésica:
Sensible (SAMS): oxacilina + gentamicina + rifampicina
Resistente (SAMR): vancomicina / daptomicina + gentamicina + rifampicina
Enterococo Ceftriaxona
Sensible: amoxicilina + gentamicina / ampicilina + ceftriaxona
Resistente: daptomicina o linezolid
Grupo HACEK (bacilos gram negativos)
Hongos
Cándida: anfotericina B + flucitosina
Aspergillus: voriconazol + equinocandina
CIRUGÍA
Se realiza recambio valvular en los siguientes casos:
Fracaso del manejo antibiótico
Insuficiencia cardiaca (principal indicación)
Insuficiencia valvular grave (sobre todo, aórtica)
Abscesos miocárdicos o perianulares
Embolismo recurrente





Las medidas preventivas, incluida la profilaxis antibiótica, pueden reducir el riesgo de endocarditis inicial y recurrente en pacientes con factores de riesgo relevantes (prótesis valvular o valvulopatía reumática) previo a intervenciones que favorecen una bacteriemia (procedimientos dentales, respiratorios, digestivos o génito-urinarios). DATITO
El antibiótico de elección es amoxicilina VO o ampicilina EV. En alérgicos a betalactámicos, clindamicina.
Si se sospecha enterococo, se puede añadir aminoglucósido.
La CIA y el prolapso de válvula mitral sin insuficiencia no predisponen a endocarditis.




La fiebre reumática aguda es una complicación no supurativa de la infección por estreptococo beta hemolítico del grupo A (Streptococcus pyogenes).

La mayoría de los casos ocurren en niños de 5 a 15 años, posterior a una faringitis bacteriana. Incidencia: 3 % en casos de una epidemia

Incidencia: 0.3 % en casos endémicos Es más común en los países subdesarrollados.

Se requiere infección faríngea estreptocócica y se cree que el mimetismo molecular, debido a la activación de células B y T autorreactivas por antígenos del estreptococo (proteína M), desempeña un papel importante en el inicio de la lesión tisular producto de una reacción cruzada.




Existe un período de latencia de dos a tres semanas:
La manifestación más frecuente y precoz es la artritis que, generalmente, es poliarticular, migratoria y compromete articulaciones grandes, más común en jóvenes.
La carditis es la manifestación más grave; lo más característico es una pancarditis (endocarditis, miocarditis y pericarditis).
La Corea de Sydenham (también conocida como corea menor o “baile de San Vito”) es un trastorno neurológico que consiste en movimientos involuntarios bruscos, no rítmicos, debilidad muscular y alteraciones emocionales. Tiene un período de latencia más prolongado que, por lo general, se presenta de uno a ocho meses después de la faringitis bacteriana.
El eritema marginado es una erupción no pruriginosa evanescente, rosada o ligeramente roja, que afecta al tronco y a las extremidades. La lesión se extiende de forma centrífuga y la piel del centro vuelve a tener un aspecto normal (eritema anular).
Los nódulos subcutáneos son lesiones firmes, indoloras, que van desde unos pocos milímetros hasta 2 cm de tamaño; suelen localizarse sobre una superficie o prominencia ósea o cerca de los tendones (generalmente, superficies extensoras) y suelen ser simétricos.
Criterios de JONES para el diagnóstico de la fiebre reumática:
Carditis y valvulitis (pancarditis)
Artritis (ENARM 2019)
Nódulos subcutáneos
Corea de Sydenham
(ENAM EXTRA 2022)
Eritema marginado
Fiebre (ENARM 2002)
Intervalo PR prolongado
Enfer medad reumática previa
PORCENTAJE
50 – 70 %
60 – 80 %
0 – 10%
10 – 30%

1 (ENARM 2019)


2 (ENARM EXTRA 2022)


Reactantes elevados: ↑ PCR ≥3,0 mg / dL
Artralgias





Tiene como objetivo el alivio sintomático de la artritis con terapia antiinflamatoria (AINES).

La erradicación de la infección por estreptococo con antibióticos, como penicilina o amoxicilina; en casos de alergia a betalactámicos, se indican macrólidos. El manejo de la insuficiencia cardiaca (corticoides)


PNC G Benzatínica 1.2 millones IM dosis única (niños: 0.6 millones)
Amoxicilina
Azitromicina (Alergia a penicilina)
500 mg / 12 horas VO por 10 días (niños: 25-50 mg/kg/día)
500 mg / 24 horas por 5 días (niños: 12 mg/kg/día)

La prevención primaria (infección inicial) se logra mediante el diagnóstico rápido y el tratamiento oportuno con antibióticos de la faringitis bacteriana.
La prevención secundaria se logra mediante la prevención de la faringitis recurrente por estreptococo. Se recomienda la profilaxis antimicrobiana continua. La duración depende de la severidad de los ataques iniciales, como se muestra en el siguiente cuadro:

CATEGORÍA
DURACIÓN
Fiebre reumática con carditis y secuela valvular 10 años después de la infección inicial o hasta los 40 años de eda
Fiebre reumática con carditis sola 10 años después de la infección inicial o hasta los 21 años de edad
Fiebre reumática sin carditis 5 años después de la infección inicial o hasta los 21 años de edad
El antibiótico parenteral preferido para la profilaxis es la penicilina G benzatínica de acción prolongada, administrada por vía intramuscular cada 21 a 28 días.



El paro cardiaco es el cese de la función cardiaca potencialmente reversible con las medidas de reanimación . Por cada minuto después del paro, se pierde 10 % de supervivencia.

En el adulto, según las recomendaciones de la AHA 2020:





En la edad pediátrica según las recomendaciones de la AHA 2020:





C: compresiones A: vía aérea B: ventilación

Primero asegúrese de que el entorno es seguro para los reanimados y para la víctima. Luego, se procede al reconocimiento del paro cardiaco, el paciente no respira o solo jadea/boquea (es decir, no respira normalmente); si no se detecta pulso palpable en un plazo de 10 segundos, entonces se activa el sistema de emergencia y se inicia la secuencia:


(ESSALUD 2015) 2 (ENAM EXTRA 2020) (ENAM 2020) (ENARM 2015)



Las compresiones torácicas (masaje cardíaco) son lo más importante y se efectúa antes de la ventilación en el soporte vital básico (ENARM 2015) (ENAM EXTRA 2020).

Las características de las compresiones torácicas de alta calidad son las que siguen:
Minimizar las interrupciones de las compresiones torácicas.
- A - B 1 2 3
Realizar compresiones con una frecuencia (100 a 120 compresiones/minuto) y profundidad adecuadas (5-6 cm o 2-2,4 pulgadas en adultos).
Lograr una completa expansión del tórax entre compresiones. Evitar una ventilación excesiva.
En los lactantes, las compresiones pueden ser con la técnica de los dos dedos (1 reanimador) o de los dos pulgares (2 reanimadores) en la mitad inferior del esternón . En niños y adultos, las compresiones se realizan sobre la línea intermamilar con las dos manos o, en caso de niños pequeños, con una mano.

Componente Adultos y Adolescentes
Relación Compresión: ventilación
Frecuencia
Profundidad de las compresiones 5 - 6 cm


Niños (entre 1 año de edad y la pubertad)
4 (ENAM 2016) 3 (ENAM 2016)


Lactante (menos de 1 año de edad, excluidos los RN)
1 o 2 reanimadores 30:2 (ENAM 2020)(ENARM 2015) (ENARM 2018) 1 reanimador 30:2 2 o más reanimadores 15:2 (ENARM 2016) (ENARM 2013)
100- 120 lpm (ENAM 2016)
Al menos 5 cm
Al menos 4cm (ESSALUD 2015) 4

Apófisís xifoides
Línea de pezón

Apófisis xifoldes sobre el hígado
Línea del pezón
55. Técnica de compresiones en lactantes (dos pulgares) 2 reanimadores.





Ante un adulto al que acaba de diagnosticar paro cardiorrespiratorio e iniciar reanimación cardiopulmonar básica (masaje cardiaco) la acción inmediata es conectarlo a un monitor/desfibrilador (ENAM EXTRA 2021)

Técnicas de compresión de pecho
Ritmo de compresiones: 100 - 120 por minuto (ENAM 2016)
Profundidad de compresiones: 2 - 2.5 (5-6 cm)
De 30 compresiones torácicas, seguidas de 2 respiraciones de rescate, y repita
(ENAM EXTRA 2023)


57. Las compresiones torácicas en el adulto se realizan con ambas manos (una encima de la otra, con los entrelazados), que deben estar en la mitad del esternón.

A continuación, se debe reconocer si el ritmo es desfibrilable, lo cual incluye la fibrilación ventricular y taquicardia ventricular sin pulso , donde se procede como sigue:

Energía de descarga eléctrica: 360 joule si es monofásico o 200 joule si es bifásico en adultos; 2 joule/kg la primera y luego 4 joule/kg las siguientes en pacientes pediátricos.


Figura 58. Colocación de palas para desfibrilación o cardioversión eléctrica. la paleta esternal se coloca a la derecha del esternón, justo debajo de la clavícula derecha en la línea medioclavicular. La paleta apical se coloca en 5 espacio intercostal izquierdo, con la línea axilar media o anterior, que corresponde a la posición de la punta del corazón.



2 (ENARM 2015)


Los desfibriladores bifásicos tienen una mayor tasa de éxito si utilizan una corriente más baja, lo que causa menos daño al tejido cardíaco. Primera descarga: 120-200 J Choques adicionales: 200–360 J



4 (ENAM 2017)

3 (ENAM EXTRA 2023) (ENAM EXTRA 2022)


Cuando no hay respuesta a la primera descarga eléctrica, se debe colocar epinefrina 1 mg EV cada 3 a 5 minutos en adultos; 0.01 mg/kg EV, en pacientes pediátricos.
Si persiste la ausencia de respuesta a la terapia eléctrica, se coloca amiodarona bolo EV de 300 mg en adultos o 5 mg/kg en niños o lactantes; también se recomienda como alternativa la lidocaína 1mg/kg EV
Si se presentan ritmos no desfibrilables, como asistolia o actividad eléctrica sin pulso (AESP), se procede después del RCP básico (compresiones):
Colocar de forma inmediata epinefrina 1 mg EV cada 3 a 5 minutos en adultos ; 0.01 mg/kg EV, en pacientes pediátricos. 1 2 4 5 1 (ENAM EXTRA 2021) (ENAM EXTRA 2022) (ENAM 2018) (ENARM 2015)









En casos de actividad eléctrica sin pulso, se deben descartar causas reversibles de paro con manejo específico. Cabe recordar las 5H Y 5T.
6 6




HIPOVOLEMIA
HIPOXIA
HIDROGENIONES (acidosis)
HIPO-HIPERPOTASEMIA
HIPOTERMIA

NEUMOTÓRAX A TENSIÓN
TAPONAMIENTO CARDÍACO
TÓXICOS
TROMBOSIS PULMONAR
TROMBOSIS CORONARIA

Retorno a la circulación cardíaca espontánea después de paro cardíaco (cualquier tipo de ritmo).
En su fisiopatología destaca:
Lesión cerebral: es la principal causa de morbimortalidad, ya que el cerebro es el órgano más vulnerable a la isquemia y el daño por reperfusión. Las neuronas más susceptibles se localizan en la corteza, el hipocampo, el cerebelo y el tálamo. Otros factores que impactan de forma negativa en el pronóstico neurológico es la hipertermia, hiperglicemia y convulsiones.


El bicarbonato se usa en casos de hiperkalemia grave (ENARM 2007) y acidosis metabólica. El factor pronóstico más importante en el síndrome posparo cardíaco encefalopatía anóxica (ENARM 2019).

Disfunción miocárdica: disminución de la fracción de eyección, aumento en la presión diastólica final del ventrículo izquierdo. Isquemia sistémica y daño por reperfusión: la deprivación de oxígeno tisular durante el paro activa el endotelio, la cascada de la coagulación deprime la respuesta inmune y disminuye los factores anticoagulantes. Esto se manifestará como trastornos de la microcirculación, inmunosupresión (son comunes las endotoxemias y el riesgo de infecciones se incrementa) y puede aparecer falla multiorgánica.
Persistencia de la patología de base.
Estrategia de manejo:
Monitoreo general (saturación, ECG, diuresis, T), hemodinámico (GC) y cerebral (EEG)
Optimización hemodinámica: PVC 8-12 mmHg, una PAM de 65-90 mmHg, ScVO2 > 70%, hematocrito > 30, lactato < 2 mmol y diuresis > 0.5 mL/kg/h
Oxigenación: se sugiere ajustar la FiO2 para mantener una SaO2 entre 94-96 %
Ventilación: mantener una PaCO2 en valores normales
Apoyo circulatorio
Manejo de síndrome coronario agudo
Hipotermia terapéutica


Definición

Síndrome clínico causado por la alteración del llenado ventricular ( diástole) o la eyección de sangre ( sístole), provocando una incapacidad del corazón para mantener un gasto cardíaco adecuado para las demandas metabólicas del organismo.

Etiología

La principal causa subyacente (determinante) es la cardiopatía isquémica , luego tenemos a la HTA . En niños, destacan las cardiopatías congénitas; también se advierten miocardiopatías, valvulopatías, etc.
El factor de descompensación (causa desencadenante) más importante es la suspensión del tratamiento (diuréticos), así como las infecciones, arritmias, anemia, tormenta tiroidea, crisis de angustia, aumento de sal en la dieta o fármacos (AINES o calcioantagonistas).

Las tres causas principales de insuficiencia cardíaca son la enfermedad de las arterias coronarias, la hipertensión (ENARM 2012) y la diabetes mellitus.

Epidemiología

(ENAM 2013)


2 (ENARM 2012) 1 (ENARM 2023)

La incidencia es mayor entre los afroamericanos y los hispanos. La incidencia aumenta con la edad: ∼ el 10 % de las personas > 60 años se ven afectadas. La cardiopatía sistólica es la forma más común de IC en general.

Insuficiencia cardiaca con fracción de eyección reducida (IC sistólica)

1 (ENARM 2023)


Reducción de la contractilidad disfunción sistólica disminución de la fracción de eyección ventricular izquierda (FEVI) gasto cardiaco
Insuficiencia cardiaca con fracción de eyección conservada (IC diastólica)
Disminución del llenado ventricular disfunción diastólica aumento de presión diastólica gasto cardiaco. 1
El común denominador de la insuficiencia cardiaca (IC) es la caída del gasto cardiaco, lo cual activa una serie de mecanismos neurohormonales, que al inicio buscan la homeostasis, pero al final son deletéreos para la función cardiaca.
Se activan el tono simpático (SA) secretando catecolaminas (norepinefrina) y el sistema renina angiotensina aldosterona (SRA-A) produciendo angiotensina II aumenta la secreción de aldosterona y ADH (vasopresina). Estas sustancias buscan aumentar la presión y la volemia para compensar la caída del gasto cardiaco y mantener la perfusión de los órganos esenciales.
La retención de sodio y agua por el riñón en la insuficiencia cardiaca se debe al flujo sanguíneo renal disminuido (por la GC) y por la fracción de filtración disminuida.
Al final, se produce un aumento de la poscarga ( resistencia vascular) y de la precarga ( volemia), lo cual genera un remodelado cardiaco (fibrosis, hipertrofia) que se asocia con la mortalidad del paciente.

Las sustancias que se contraponen a todos estos mecanismos cardiopatogénicos son los péptidos natriuréticos (PNB) , que interpretan la distención de las cavidades cardiacas como una situación real de hipervolemia, induciendo natriuresis ( precarga), vasodilatación ( poscarga) y es un antifibrótico (cardioprotector endógeno). Este efecto, sin embargo, es limitado y mucho menor a los anteriormente descritos.

Los cardioprotectores endógenos son los péptidos natriuréticos (PNB) y se metabolizan rápidamente por la neprilisina (ENAM 2010).




Figura 64. Fisiopatología de la insuficiencia cardiaca.

INSUFICIENCIA CARDIACA SISTÓLICA ( CONTRACTIBILIDAD)
Forma más frecuente de IC (70 % casos).



Se caracteriza por una hipertrofia excéntrica (dilatación) por sobrecarga de volumen.
Se ausculta un tercer ruido (R3: llenado rápido).
Presenta una fracción de eyección (FE) disminuida (< 50 %).
Es producida por la cardiopatía isquémica (principal causa), miocardiopatía dilatada, miocarditis, valvulopatías (insuficiencia aórtica).
Se caracteriza por una hipertrofia concéntrica por sobrecarga de presión.
Se ausculta un cuarto ruido (R4: contracción auricular).
Presenta una FE conservada (> 50 %).
Es causada por hipertensión arterial (también produce IC sistólica), miocardiopatías hipertrófica y restrictiva, valvulopatías (estenosis aórtica).





FRECUENCIA
HIPERTROFIA Excéntrica Concéntrica
FEY Disminuida Conservada
SÍNTOMAS Bajo gasto Congestivos
RITMO GALOPE R3 R4
PTDVI =/+ ↑

La clasificación actual de IC es con: Fracción de eyección (FE) reducida < 40 %
Con Fracción de eyección (FE) intermedia 41-49 %
Con Fracción de eyección (FE) conservada > 50 %

Insuficiencia cardiaca de gasto cardiaco
Es la falla cardiaca clásica que presenta circulación hipocinética, pulso de baja intensidad, manos y pies fríos. Lo produce la cardiopatía isquémica y la HTA.
Presenta datos clínicos de congestión.
IC izquierda congestión pulmonar IC derecha congestión sistémica

Insuficiencia cardiaca de gasto cardiaco
Se presenta en los estados hipercinéticos, pulso celer (saltón) y manos calientes (hipervolemia).
Lo produce el embarazo, anemia, tirotoxicosis, fístulas arteriovenosas (enfermedad de Paget), enfermedad de Beri Beri (déficit de tiamina).
La clínica es similar a la insuficiencia cardiaca clásica, pero sin síntomas congestivos.
Insuficiencia cardiaca izquierda
Es la forma más frecuente de IC.
Cursa con presión capilar pulmonar (PCP).
Cursa con congestión pulmonar disnea (síntoma precoz), ortopnea (disnea en decúbito) , crépitos pulmonares, dolor precordial.
También se consideran los síntomas de bajo gasto (hipotensión, astenia y obnubilación).
Las causas más frecuentes que lo producen son la cardiopatía isquémica e hipertensión arterial.









Insuficiencia cardiaca derecha
Produce aumento de la presión venosa central (PVC).
Cursa con congestión sistémica presentando edemas periféricos, hepatomegalia, ascitis, derrame pleural, ingurgitación yugular y reflujo hepatoyugular.
La causa más frecuente de insuficiencia cardiaca derecha es la disfunción ventricular izquierda; en caso del fallo derecho aislado, es la hipertensión pulmonar primaria o, más frecuentemente, secundaria, como en los casos de Cor pulmonar (EPOC, SDRA).

3 (ENARM 2014) (ENARM 2023)


CRITERIOS DE FRAMINGHAM
Criterios mayores
Presión venosa yugular aumentada (> 16 cm H2O)
Reflujo hepatoyugular positivo
Edema agudo de pulmón
Disnea paroxística nocturna síntoma más específico
Estertores o crepitantes síntoma más sensible




Cardiomegalia (índice cardiotorácico: > 0.5 en adultos > 0.6 en recién nacidos)
Ingurgitación yugular
Ritmo de galope (R3: protodiastólico, R4: telediastólico) signo más específico
El primer ruido cardiaco se produce por el cierre de las válvulas auriculoventriculares durante la fase de contracción isovolumétrica del ciclo cardiaco (ENARM 2023), el segundo ruido cardiaco es por el cierre de las válvula semilunares durante la fase de relajación isovolumétrica.
Criterios menores (ENAM 2010)
Edema en miembros (blando, simétrico, vespertino y obedece gravedad)
Tos nocturna
Disnea de esfuerzo
Hepatomegalia
Derrame pleural
Taquicardia (>120 Ipm)
BIOMARCADORES CARDIACOS
Péptidos natriuréticos cerebrales (BNP) o NT-proBNP (precursor del BNP):
Para establecer el diagnóstico de ICC (alto valor predictivo negativo)
Evaluación del pronóstico y la gravedad de la enfermedad (los niveles altos se asocian a peor pronóstico)


2010)




2011)
EXTRA 2021)





EXTRA 2022)
La obesidad y el edema pulmonar repentino pueden conducir a niveles de BNP normales o disminuidos.


2012)
(ENAM 2010) (ENAM 2012)


Estudio de elección para todos los pacientes con sospecha de insuficiencia cardiaca de nueva aparición (confirma el diagnóstico)
Cambios en las características clínicas en pacientes que reciben tratamiento (seguimiento)
Disfunción sistólica del ventrículo izquierdo: evaluada mediante FEVI
Cambios en la silueta cardiaca
Cardiomegalia: índice cardiotorácico > 0,5

El ecocardiograma confirma la IC sistólica porque evalúa la FE.
Corazón en forma de bota en la vista PA
Signos de congestión pulmonar (edema agudo de pulmón)





Clase I: asintomático con actividad física habitual.
Clase II: síntomas a moderados esfuerzos (leve limitación) síntomas después de subir 2 tramos de escaleras o levantar objetos pesados
Clase III: síntomas con mínimo esfuerzo (moderada limitación) síntomas durante las actividades diarias, como vestirse, caminar por las habitaciones.
Clase IV: síntomas en reposo (severa limitación).

















Clasifica a los pacientes según el estadio de la enfermedad.
Asintomáticos: Estadio A y B
A: pacientes con alto riesgo para desarrollar IC factores de riesgo cardiovascular (HTA, fumador, diabetes)
B: pacientes con disfunción ventricular asintomática o lesión estructural FE baja, infarto de miocardio y estenosis valvular
Sintomáticos: Estadio C y D
C: pacientes con disfunción ventricular sintomática responde al tratamiento
D: pacientes con síntomas refractarios al tratamiento convencional (etapa terminal)

Estadio A

Estadio B

Factores de riesgo
HTA OBESIDAD ANTECEDENTES FAMILIARES


Diseño estructural sin sintomas

IMA VALVULOPATÍAS FEy




Diseño estructural con sintomas de IC

DISNEA SEVERA
Estadio C IC severa IC AVANZADA
Figura 73. Estadios evolutivos de la ICC.
Estadio D



La Asociación Americana de Cardiología (AHA) recomienda diagnosticar la IC en estadio B (disfunción asintomática del ventrículo izquierdo).

En casos de una IC sistólica, se recomienda: DATITO
Manejar la causa desencadenante y estabilizar la causa subyacente
Dieta hiposódica e hipocalórica (restricción de agua solo en los casos más graves)
Inmunizaciones: vacuna antineumocócica y vacuna contra la influenza estacional
Evitar: calcioantagonista y AINES
Fármacos poscarga

Los fármacos más importantes en el manejo de la IC son los IECA; y en caso el paciente esté compensado, se usan los betabloqueadores el mejor, carvedilol (bloqueo mixto alfa y beta).
IECA (tratamiento de primera línea: captopril, enalapril y lisinopril) bloquean la síntesis de angiotensina II.
2 3
ARA II (valsartán, candesartán y losartán) bloquean los receptores AT1 de la angiotensina II.
Betabloqueadores inhiben los receptores beta 1 adrenérgicos del corazón están aprobados en IC compensada carvedilol, metoprolol, nevibolol y bisoprolol


(ENAM EXTRA 2020)

(ENAM 2010)



(ENARM 2003) 3 (ENAM 2010) (ENAM 2018) (ESSALUD 2015) (ENARM 2003)


Fármacos precarga:
Uso de diuréticos como tiazidas casos leves de congestión. Furosemida casos severos como edema agudo de pulmón. Aumentar la contractilidad miocárdica digoxina
Bloquea la bomba Na/K calcio intracelular inotropismo + Indicación: sobre todo, cuando la IC se asocia a taquiarritmias supraventriculares (fibrilación auricular) para control de la frecuencia cardiaca.
Intoxicación digitálica: se produce cuando la concentración sérica de digoxina es >2 ng/ ml, favorecida por ciertos factores, tales como:
Insuficiencia renal
Hipotiroidismo
Hipopotasemia ( K)
Hipoxemia


La triada del tratamiento de la IC sistólica es IECAS, diuréticos y betabloqueantes.


Acidosis
En relación a la clínica de la intoxicación digitálica, destaca:
Síntomas gastrointestinales (anorexia, náuseas, vómitos) los más precoces.
Xantopsias
Psicosis
Interacción con otros fármacos, como amiodarona, verapamilo y quinidina. 9
Toxicidad cardiaca manifestada en el ECG por infradesnivel del ST (“cubeta digitálica”)
La arritmia más específica de la intoxicación digitálica es la taquicardia auricular con bloqueo AV y la más frecuente, las extrasístoles ventriculares (bigeminismo).
Nuevos fármacos para IC:








(ENAM 2018)

Los INRA (inhibidores de neprilisina y receptores de angiotensina) representados por sacubitril/valsartán, indicados cuando no hay respuesta a los IECA
Empagliflozina fármaco inhibidor de los transportadores de glucosa (SGLT 2) aprobado en el control glicémico del paciente con diabetes y también en la IC
La ivabradina bloquea la corriente If del marcapaso cardiaco (nodo sinusal) y regula la frecuencia cardiaca alternativa a los betabloqueadores

Terapia de resincronización: indicaciones
Fracción de eyección del ventrículo izquierdo (FEVI) ≤ 35 % con tratamiento óptimo
QRS > 0.12 segundos
Bloqueo de rama izquierda
Una clase funcional II - IV de la New York Heart Association (NYHA)
Desfibriladores automáticos implantables (DAI) sirven para la prevención
Fracción de eyección del ventrículo izquierdo (FEVI) ≤ 35 %
Insuficiencia cardiaca asociada (IC) con clase funcional II - IV de la New York Heart Association (NYHA).
La terapia que mortalidad ( sobrevida) Fármacos antirremodeladores (antifibróticos)
IECA
Betabloqueantes
Espironolactona o eplerenona (antagonistas de la aldosterona) se indica en casos refractarios NYHA clase II-IV y una FEVI de <35 % a pesar del uso de IECA y diuréticos.
Resincronización ventricular o implantación de DAI
INRA (sacubitril/valsartán)
ARA II
Sintomáticos solo mejoran la clase funcional
Digoxina
Diuréticos (tiazidas y furosemida)
En casos de una IC diastólica:
Las acciones terapéuticas deben ir encaminadas a mejorar el llenado ventricular

Los diuréticos y la digoxina mejoran los síntomas y reducen significativamente el número de hospitalizaciones.





Los calcioantagonistas están contraindicados en IC sistólica, pero sí se emplean en IC diastólica.

Empleamos betabloqueantes o calcioantagonistas para mantener una frecuencia de 60 a 90 lpm (aumenta el tiempo de llenado), además reducen la rigidez ventricular y las presiones diastólicas elevadas.


Disfunción aguda del ventrículo izquierdo congestión pulmonar severa.


Aumento de la presión hidrostática o presión capilar pulmonar (PCP > 25 mmHg) que se mide con el catéter de Swan Ganz.
Puede ser producto de un infarto de miocardio necrosis > 25 % del ventrículo izquierdo.

DATITO
Edema agudo de pulmón no cardiogénico cursa con PCP normal y PaO2/FiO2 < 300 síndrome de distrés respiratorio agudo.

CLÍNICO
Disnea severa

1 (ENAM 2020) (ENARM 2021)



74. Macrófagos cargados de hemosiderina (células de insuficiencia cardiaca) en el tejido pulmonar sugieren insuficiencia cardiaca descompensada.

Crépitos difusos en ambos campos pulmonares
Tos o hemoptisis
RADIOLÓGICO
Redistribución vascular y dilatación de arterias pulmonares (PCP > 15 mmHg)
Edema intersticial (PCP > 20 mmHg) empieza a trasudar líquido con infiltración de los tabiques pulmonares (líneas A y B de Kerley)
Edema alveolar (PCP > 25 mmHg): infiltrado “en alas de mariposa” un grado mayor de la trasudación de líquidos que ocupa los alveolos
Derrame pleural, bilateral; si es unilateral, suele ser derecho (trasudado)

Posición sentada, con las piernas colgando en la cama
Oxigenoterapia:
Mascarilla con reservorio (flujos altos de O2)






2 (ENAM EXTRA 2021) 1 (ENAM EXTRA 2022) 3 (ENARM 2021)
Indicado para pacientes con una SaO 2 < 90 % o PaO2 < 60 mm Hg



Furosemida EV: de elección en edema de pulmón normotensivo (PAS < 110 mmHg) por su potencia diurética para reducir la precarga.
Nitroglicerina EV: de elección en edema de pulmón hipertensivo (PAS > 110 mmHg) por su efecto vasodilatador. También se puede usar nitroprusiato de sodio en casos refractarios.
Ventilación no invasiva con presión positiva (VNIPP): para pacientes con dificultad respiratoria, a pesar de oxígeno suplementario
Ventilación mecánica: en casos severos de hipoxia asociado a disminución severa del nivel de conciencia o está agotado.
Indicaciones:
Insuficiencia respiratoria hipoxémica que no responde a VNIPP
Hipoxemia refractaria (PaO 2 <60 mm Hg)
Acidosis (pH <7,35) 2 1 3
Hipercapnia (PaCO 2 > 50 mm Hg)


Trastornos del ritmo cardiaco que pueden ser regulares o irregulares (arritmias).


Clasificación
SUPRAVENTRICULARES

La despolarización del miocito cardiaco (fase 0) se produce por la entrada de sodio y la repolarización (fase 3) por la salida de potasio durante el potencial de acción. (ENARM 2023)

Presentan complejo QRS estrecho (< 0.12 s). A su vez, podemos dividirlas en:
TAQUIARRITMIAS
Taquicardia sinusal
Etiología
Producida por aumento del tono simpático, ya que la norepinefrina estimula los receptores beta 1 del corazón. La causa que lo desencadena es el ejercicio, estrés, fiebre, hipertiroidismo (su arritmia más frecuente) , hipoxia, anemia, tóxicos (café, tabaco, anfetaminas), fármacos (atropina, catecolaminas).
Es el trastorno de ritmo más frecuente en el adulto
ECG
Aumento de la frecuencia cardiaca a 100 - 150 lpm
1 2
Ritmo sinusal (onda P positiva en DII, negativa en aVR y QRS regulares)
Tratamiento
El manejo va enfocado a corregir la causa y, en algunos casos, se usan betabloqueantes (tirotoxicosis).

Taquicardia paroxística supraventricular (TPSV)
Etiología
Producida, principalmente, por circuitos de reentrada en la unión auriculoventricular. Es la alteración más frecuente del ritmo cardiaco en niños
4

1 (ENARM 2014)


2 (ENARM 2013)





Clínica
Se presenta más en mujeres jóvenes sin cardiopatía estructural, con palpitaciones regulares de inicio y fin súbito
ECG
La frecuencia es de 150 - 250 lpm de ritmo regular (conducción 1:1). La onda P queda escondida en el QRS ) o por detrás de esta (P retrógrada)






3 (ENARM 2023) (ENARM 2004) (ESSALUD 2013) (ENARM 2009) (ENARM 2006) (ENARM 2004) (ENAM 2014)




El tratamiento definitivo es con ablación transcatéter. Tratamiento
En relación con el manejo, el 80 % de los casos se controla con maniobras vagales, como el masaje del seno carotídeo (origen de la carótida interna)
En casos refractarios, se emplea adenosina 6 mg EV (antiarrítmico de elección) o, en su defecto, calcioantagonistas; asimismo, es posible usar amiodarona.
Si existe inestabilidad hemodinámica ( PA, alteración del sensorio) cardioversión eléctrica.


Síndrome de preexcitación
Etiología
El típico representante es el Wolf-Parkinson-White (WPW)
Producido por una vía accesoria (haz de Kent)

(ENARM 2021)
(ENAM 2019)


(ENARM 2006) (ENARM 2015) (ENARM 2019)




Clínica
(ENARM 2021) (ENARM 2023)

(ENARM 2021)




(ENAM 2017)
(ESSALUD 2016)

Debe sospecharse en jóvenes con palpitaciones. Generalmente, tiene buen pronóstico cuando no existe cardiopatía Subyacente.
En algunos casos, se asocia con la enfermedad de Ebstein (implantación baja de la válvula tricúspide), el prolapso mitral y la miocardiopatía hipertrófica.
ECG
Presenta intervalo PR corto (< 0.12 s).
Onda delta (vía accesoria)
Tratamiento

Existen dos tipos de conducción:
La forma ortodrómica (95 %) cursa con QRS estrechos (< 0.12 s). La forma antidrómica (5 %), cuyo QRS es ancho (> 0.12 s).
El manejo inicial en pacientes estables incluye maniobras vagales (masaje del seno carotídeo).
El manejo farmacológico es con frenadores del nodo AV (calcioantagonistas o adenosina).
El tratamiento definitivo es ablación con radiofrecuencia.
En casos de inestabilidad hemodinámica, se recomienda cardioversión eléctrica



Los agentes bloqueadores del nódulo AV y las maniobras vagales están indicadas en arritmias supraventriculares (TPSV – WPW).
Taquicardia auricular multifocal
Etiología
Caracterizada por múltiples focos de activación eléctrica en las aurículas, lo que resulta en una frecuencia cardíaca rápida e irregular.
Se asocia frecuentemente con condiciones subyacentes donde se incluyen: enfermedad pulmonar obstructiva crónica (EPOC) , insuficiencia cardíaca congestiva, hipokalemia, uso de teofilina, neumonía o postcirugía cardiaca.
Clínica
Presentan una variedad de síntomas como palpitaciones irregulares, disnea, dolor torácico, sincope.
ECG
Frecuencia auricular: Generalmente entre 100 y 150 latidos por minuto.
Ondas P: Al menos tres morfologías diferentes de ondas P en una sola derivación
Ritmo irregular: Los intervalos R-R son desiguales




2023)

2023)


Tratamiento
Corrección de factores precipitantes: Tratamiento de la hipoxia, corrección de desequilibrios electrolíticos (hipokalemia, hipomagnesemia).
Control de la frecuencia cardíaca: beta bloqueadores o calcio antagonistas.
o aleteo auricular
Etiología
Es un trastorno producido por macrorreentradas en la aurícula derecha.
Se presenta en adultos con cardiopatía estructural.
Su conducción más frecuente es 2:1. ECG
Cursa con ausencia de ondas P, reemplazadas por ondas de sierra (F).
QRS regulares.
Tratamiento
El manejo es similar a la fibrilación auricular.
En casos de inestabilidad hemodinámica, cardioversión eléctrica.
En casos refractarios, el manejo definitivo es la ablación en el istmo cavotricuspídeo.




EXTRA 2022)



Etiología
Es la arritmia más frecuente en la práctica clínica (hospitalizados).
Es la causa principal de cardioembolismo (forma trombos murales).
Es más frecuente en adultos mayores con cardiopatía estructural.
Su principal factor de riesgo es la cardiopatía hipertensiva; también se asocia a isquemia miocárdica, tirotoxicosis, estenosis mitral, miocardiopatía dilatada o cirugía cardiaca.
En su patogenia, presenta un trastorno mixto de formación de focos ectópicos y mecanismos de microrreentradas asociado a una dilatación de la auricular izquierda, que presenta estasis sanguínea con la consecuente formación de trombos murales (orejuela izquierda).
Clínica
Presenta disnea, palpitaciones y síncope.
En la exploración física, se evidencia un pulso deficitario e irregular.
Clasificación
Paroxística: dura menos de 48 horas, generalmente. Persistente: dura más de 7 días hasta un año.
Permanente: dura más de un año (no requiere cardioversión).
La FA se caracteriza por una actividad auricular desorganizada, con ausencia de ondas P (ritmo extrasinusal), que son sustituidos por ondas f.
Frecuencia alta > 250 lpm
QRS irregular


Complicaciones
IC aguda edema agudo de pulmón
Embolismo: ACV isquémico, infarto renal, infarto esplénico, isquemia intestinal, isquemia aguda de las extremidades, oclusión de arteria central de la retina (amaurosis fugaz).
Tratamiento
Cardioversión eléctrica cuando el paciente está hemodinámicamente inestable (hipotensión o con alteración del sensorio).
Anticoagulación: es importante prevenir el embolismo cardiaco (mejora el pronóstico). Se indica de manera directa cuando el paciente presenta prótesis valvular o valvulopatía mitral; en el resto de los casos, se usa el score de CHA2DS2. – VAS, para evaluar el riesgo.

En general, se recomienda la cardioversión eléctrica en todas las arritmias (excepto taquicardia sinusal) cuando se produce inestabilidad hemodinámica (hipotensión o alteración del sensorio).

(ENARM 2017) (ENARM 2007) (ENARM 2004) 19





(ENAM EXTRA 2021)

(ENAM EXTRA 2021) (ENAM 2012) (ESSALUD 2012) (ESSALUD 2010) (ESSALUD 2023)


23 (ENARM 2012) (ENARM 2023)


24 (ENARM 2022)





¡El cerebro, el riñón y el bazo son los tres órganos que tienen más probabilidades de resultar dañados por los émbolos!

(ENAM EXTRA 2020) (ENAM 2013)

(Hypertension)
≥ 75 (Age)(ENAM 2013)
Diabetes melitus (Diabetes mellitus)
S2 Accidente cerebrovascular (Stroke) 2
V Enfermedad vascular (Vascular disease). Infarto miocardio. Claudicación intermitente, etc. 1
A Edad 65-74 años (Age) 1
Sc Sexo femenino (Sex)

PUNTUACIÓN
≥ 2 (mujer)
≥ 1 (varón)

TRATAMIENTO RECOMENDADO
Anticoagulación (warfarina: INR 2-3)(ENAM EXTRA 2020)
Anticoagulación (Warfarina: INR 2-3)
0 (varón) o 1 (mujer) 75-325 mg diarias de aspirina o ningún tratamiento
Tabla 10. Score de CHA2DS2 – VAS para evaluar este riesgo trombótico.

RIESGO DE SANGRADO PUNTOS
H Hipertensión descontrolada TAS >160 1
A Alteración Renal (1pto) o Hepática (1pto) 1+
S ICTUS-AIT previos (Stroke) 1
B Hemorragias o predisposición (Bleeding) 1
L INR lábil 1
E Edad >65 años (Elderly) 1
D Fár macos (AINEs, Antiagregantes). Abuso del Alcohol o drogas (Drugs) 1+
máximo

Tabla 11. Score HAS-BLED para evaluar el riesgo de sangrado. (ENARM 2018) 26 (ENAM EXTRA 2020) (ENAM 2013) (ENARM 2019) (ENAM 2011) (ENARM 2023)








También es importante evaluar el riesgo de sangrado con el score HAS BLED, un puntaje ≥ 3 indica alto riesgo, por tanto, se prefieren anticoagulantes específicos, como dabigatrán (inhibidor factor II o trombina), rivaroxabán y apixabán (inhibidor del factor X). Si el puntaje es < 3, se mantiene la warfarina (INR 2-3).
Si la anticoagulación está contraindicada, puede realizarse la oclusión de la orejuela izquierda (manejo invasivo).
Control de la frecuencia cardiaca
Es importante en cuadros agudos, para los cuales se emplean frenadores del nodo AV; de primera línea, se consideran los betabloqueantes (labetalol, metoprolol) ; seguido de los calcioantagonistas no dihidropiridínicos (verapamilo, diltiazem), como alternativa.
En casos asociados a insuficiencia cardiaca, se indica digoxina.
En casos refractarios, amioadrona.
Control del ritmo
En pacientes estables, se indica cardioversión farmacológica que permite volver la FA a ritmo sinusal; también se indica en casos de FA paroxística y en algunas persistentes. Los fármacos que se utilizan son del grupo IC (flecainida, propafenona, ibutilida); y en casos de cardiopatía estructural severa (ICC avanzanda) usamos amiodarona.
En casos refractarios al manejo médico, se indica ablación transcatéter.

Bradicardia sinusal
Etiología
Producida por la hiperactividad del sistema parasimpático (aumento del tono vagal).
La acetilcolina estimula sus receptores muscarínicos (M2) del corazón.
En cuanto a su etiología, pueden mencionarse la hipotermia, hipotiroidismo, ictericia obstructiva, hipertensión endocraneal (reflejo de Cushing), drogas (digital, betabloqueantes, morfina).
ECG
Frecuencia cardiaca < 60 lpm
Ritmo sinusal (Onda P normal antes de cada complejo QRS)
Tratamiento
En relación con el manejo, no amerita si el paciente está estable o asintomático.Dar tratamiento cuando se producen síntomas, mediante sulfato de atropina (antagonista muscarínico); y en casos refractarios, isoproterenol (agonista beta 1 adrenérgico), epinefrina o dopamina.
Pacientes inestables hemodinámicamente y refractarios al manejo con fármacos estimulación transcutánea.
Tratamiento definitivo (en casos muy sintomáticos) con marcapasos.


Bloqueos A-V
Se caracteriza por un intervalo PR largo (> 0.20 s).
Bloqueo AV primer grado:

Evite la atropina en pacientes con infarto de miocardio o un trasplante de corazón reciente.

En realidad, es una conducción lenta, pues cada onda P continúa de un complejo QRS.
Puede ser normal o deberse a aumento del tono vagal o digitálicos.
Generalmente, es asintomático.



Generalmente, el nodo sinusal y nodo atrioventricular están irrigados por la arteria coronaria derecha (ESSALUD 2022, ESSALUD 2023)

Bloqueo AV segundo grado:
En este caso, si se advierten ondas P ausentes en algunos ciclos, después de un complejo QRS. Existen dos tipos:
MOBITZ I:
Se caracteriza por una prolongación progresiva del PR (fenómeno de Wenckebach).
La conducción más frecuente es 3:2.
Se observa en el infarto de cara inferior (diafragmática) por intoxicación digitálica y por aumento del tono vagal. Suele ser transitoria y no requiere tratamiento.





En este caso, el PR es prolongado pero constante.
La conducción más frecuente es 3:1.
Su causa es degenerativa (enfermedades de Lenegre), o bien se produce por un infarto de cara anteroseptal.
Presenta mal pronóstico, pues tiende a progresar a bloqueo completo, siendo indicación de marcapaso.

Latido perdido

Bloqueo AV tercer grado:
Es una disociación completa entre la aurícula y el ventrículo.

La disociación auriculoventricular siempre es secundaria o debida a otro trastorno en el ritmo cardiaco. Por ejemplo: se observa una disociación auriculoventricular por una taquicardia ventricular o por un bloqueo AV completo. En el primer caso, el tratamiento es desfibrilación; en el segundo, colocación de marcapaso. (ENAM 2018)



Puede aparecer de forma aguda (infarto de miocardio anterior) o crónica (por causa degenerativa).
La clínica es de insuficiencia cardiaca y/o de crisis de Stokes-Adamas (síncopes a repetición).
Produce las ondas “a” cañón en el pulso venoso yugular. El tratamiento consiste en la implantación de marcapasos.



Pausa sinusal
Etiología
Falla la formación de un impulso sinusal.
Suele deberse a estimulación vagal o intoxicación digitálica.
Puede ser una manifestación de disfunción del nódulo sinusal; en este último caso, cuando produce síntomas, se denomina enfermedad del nodo sinusal (síndrome taquicardia-bradicardia).
ECG
Hay una pausa entre 2 ondas P (patológico cuando dura > 3 s).
Para diagnosticar la disfunción del nódulo sinusal, resulta muy útil el estudio de Holter
Tratamiento
Su manejo es la colocación de marcapaso permanente Se indica también ante pausas sinusales > 3 s aún sin síntomas.


Presenta complejo QRS ancho (> 0.12 s), generalmente.
Extrasístoles ventriculares
Etiología
En los pacientes sin cardiopatía estructural, no se ha observado que se asocien a un incremento de morbimortalidad
Por el contrario, el riesgo de muerte súbita es mayor en los pacientes con cardiopatía isquémica, en especial, tras un infarto de miocardio o miocardiopatías.
Es la arritmia más frecuente de la intoxicación por digoxina (bigeminismo).

La principal indicación de marcapaso es la enfermedad del nodo sinusal (ENARM 2023), otras indicaciones son: bloqueo AV de II grado Mobitz II y bloqueo AV de III grado.

QRS anormal con pausa compensadora.
Tratamiento
Los individuos sin cardiopatías y asintomáticos no requieren tratamiento.
Si causan palpitaciones, angustia o en casos de enfermedad coronaria se indica betabloqueante.
Tradicionalmente, se usaba lidocaína en su manejo en pacientes con infarto de miocardio.







Taquicardia ventricular (TV)
Etiología
Cardiopatía isquémica (causa más común)
Miocardiopatías.
ECG
Presencia de 3 o más extrasístoles ventriculares consecutivas
Frecuencia superior a 100 Ipm
QRS anchos (> 0.12 s) y regulares, que pueden ser iguales (TV monomorfa), o de distinta morfología (TV polimorfa Torsades de Points)
Si dura menos de 30 s, se denomina no sostenida, pero la más peligrosa es la que persiste más de 30s (TV sostenida), que genera inestabilidad hemodinámica.
Tratamiento
En caso de que el paciente esté estable, puede emplearse procainamida (probablemente, el fármaco más eficaz), amiodarona o lidocaína (en contexto del IAM agudo).
Ante inestabilidad hemodinámica (hipotensión o alteración del sensorio), está indicada la cardioversión eléctrica. En casos de TV sin pulso, iniciar RCP Desfibrilación.


Torsades de Points (TV helicoidal o polimórfica)
Etiología





El manejo de la fibrilación ventricular y la TV sin pulso es el mismo, e incluye RCP y desfibrilación.

Producida por pospotenciales, cuyo factor de riesgo es intervalo QT largo (> 0.45 s o > 450 ms, o si el cambio en el intervalo QT es ≥ 60 ms desde el ECG basal).
La etiología es múltiple:
Fármacos: eritromicina, terfenadina , moxifloxacino, antidepresivos tricíclicos, hidroxicloroquina , procainamida y sotalol
Trastornos electrolíticos: hipokalemia, hipocalcemia e hipomagnesemia
Tóxicos: organofosforados y carbamatos
Trastornos congénitos, como síndromes de Romano (autosómico dominante) y de Nielsen (autosómica recesiva)
Es una TV polimórfica, no sostenida y con frecuencia entre 120-200.
Tratamiento
Con relación al manejo, el antiarrítmico de elección es el sulfato de magnesio en casos de etiología adquirida ; se emplean los betabloqueantes en los trastornos congénitos.
En casos de inestabilidad hemodinámica cardioversión eléctrica.

En la tratamiento del COVID 19 durante la pandemia se uso azitromicina e hidroxicloroquina, las cuales producen prolongación del intervalo QT y dieron origen a arritmias ventriculares (Torsades de Points) (ENAM EXTRA 2023)










Fibrilación ventricular
Etiología
Producen paro cardiaco y si no se tratan rápidamente, la muerte.
Su causa más frecuente es la cardiopatía isquémica.
Genera gasto cardiaco cero. ECG
El ritmo es caótico e irregular.
Frecuencia > 300 lpm
Tratamiento
Desfibrilación
Monofásico: 360 joule
Bifásico: 200 joule
Casos refractarios a la terapia eléctrica
Amiodarona

El sulfato de magnesio se usa en preeclampsia severa como prevención de las convulsiones en la gestante (eclampsia), y también es el antiarrítmico de elección en casos de Torsades de Points, cuando el paciente está estable.






La arritmia más frecuente postinfarto agudo de miocardio es la extrasístole
Ventricular, y la que genera mayor mortalidad por fibrilación ventricular.


ALTERACIONES DEL RITMO CARDIACO POR TRASTORNOS ELECTROLÍTICOS
Hiperkalemia (K> 5.5 mEq/L)
Produce las ondas T alta y picudas
Onda P plana
Prolongación del intervalo PR
Ensanchamiento del QRS (grave)



2011) (ENARM 2010) (ENARM 2022)




2022)
2014)



En casos severos de hiperkalemia (QRS ancho en el ECG o hipotensión con bradicardia), se usa gluconato de calcio para estabilizar la membrana del miocito. (ENARM 2023) Ca, K, Mg prolongan el intervalo QT Torsades de Points.

Hipokalemia (K<3.5 mEq/L)
Produce onda T plana
Aparece la onda U
Depresión del segmento ST
Se prolonga el intervalo QT


Hipocalcemia (< 8.5 mg/dl)
Intervalo QT largo (> 0.45 s).



Hipercalcemia (> 10 mg/dl)
Intervalo QT corto (< 0.30 s).

Los trastornos de calcio alteran el intervalo QT (ENARM 2018).





Insuficiencia circulatoria que origina hipoperfusión e hipoxia tisular, con compromiso de la actividad metabólica celular y función orgánica.

Se activan mecanismos neurohormonales:

2


Diagnóstico 1 (ENARM 2014) 2 (ENARM 2018) tono simpático taquicardia sinusal (primer mecanismo compensatorio) el eje suprarrenal con ACTH y cortisol
Desde el punto de vista fisiopatológico, se distinguen cuatro tipos de shock:
HIPOVOLÉMICO




SHOCK DISTRIBUTIVO
Fisiopatología



Se produce por una vasodilatación generalizada ( RVS).
Cursa con GC (shock con piel caliente).
Etiología
Sepsis (causa más frecuente)
Anafilaxia
Reacciones farmacológicas (sulfonamidas, alergia al medio de contraste) adultos
Picaduras de insectos (picaduras de abejas)
Alergias alimentarias (maní) niños
Se produce reacción hipersensibilidad tipo I.
Insuficiencia suprarrenal (síndrome de Addison)
Shock neurogénico (lesión cerebral traumática, lesión de la médula espinal)










Shock distributivo es la principal causa de shock en el adulto. El shock anafiláctico generalmente esta mediado por Ig E, basófilos y mastocitos (ENAM EXTRA 2020).
Clínica
Shock con piel caliente ( GC)
Pulmón seco ( PCP)
Sepsis: foco infeccioso + falla de órgano (oliguria, hipotensión, alteración sensoria, ictericia)
Anafilaxia: signos mucocutáneos (edema facial, urticaria) + falla de órgano (disnea, estridor, hipotensión)
Manejo
En casos de sepsis la fluidoterapia con cristaloides (NaCl 0.9 % 30 ml/kg) y aumento de cobertura antibiótica en la primera hora si persiste la hipotensión (shock séptico) se emplean vasopresores (primera línea: norepinefrina).
Ante anafilaxia, colocar de forma inmediata epinefrina 0.4 mg IM o SC en el adulto o 0.01 mg/Kg en lactantes (ampolla: 1/1000) si se usa la vía endovenosa, diluir 1/10 000.
SHOCK HIPOVOLÉMICO
Fisiopatología
Se produce por caída de la volemia > 30 % ( GC)
La precarga (volumen tele diastólico) disminuye.
Respuesta compensatoria: RVS y FC (taquicardia)
Etiología
Politraumatizado
Hemorragia digestiva
Hemorragia retroperitoneal (rotura de aneurisma)
Pérdidas gastrointestinales (diarrea o vómitos)
Pérdidas renales (diuresis osmótica o hipoaldosteronismo)
Pérdidas del tercer espacio (posoperatorio, obstrucción intestinal, lesión por aplastamiento, pancreatitis, cirrosis, grandes quemados)
Clínica
Shock con piel fría ( GC)
Pulmón seco ( PCP)
Llenado capilar lento
Mucosas secas
Taquicardia con hipotensión sostenida
Oliguria
Alteración del sensorio
Índice de shock = frecuencia del pulso / presión arterial sistólica
Rango normal: 0,4-0,7
Patológico > 0.9 consistente con shock circulatorio
Manejo



(ENARM 2022)


(ENARM 2015) (ENARM 2022)
(ENAM 2014)






(ENARM 2021) (ENARM 2020) (ENARM 2020) (ENARM 2021) (ENAM 2020) (ENAM 2012) (ENAM 2013)

(ENARM 2014)







Colocación de accesos vasculares periféricos y fluidoterapia inmediata
Para restablecer el volumen arterial efectivo con cristaloides (ClNa 0.9 %)
Hemorragia: 10 a 20 ml/kg (1 a 2 litros a chorro)
Ho hemorrágico: pérdidas insensibles (1.5 litros) + 20 ml/kg

El shock hipovolémico es la principal causa de shock en pediatría.

La triado mortal del shock hemorrágico: hipotermia, coagulopatía y acidosis metabólica. (ENARM 2015)


(ENARM 2014) (ENAM EXTRA 2023) (ENAM EXTRA 2021) (ENAM 2020)












Hemoderivados: en casos de hemorragia
Transfusión de paquete globular
Hemoglobina < 7 gr/dl en todos los pacientes
Hb < 9 gr/dl, en pacientes con cardiopatía isquémica o accidente cerebrovascular
Transfundir unidades de plaquetas
Plaquetas < 50 mil
El paciente está tomando aspirina.
Transfundir plasma fresco congelado
Se altera el perfil de coagulación ( TP o TPTa)





SNC Ansioso Confuso (ENARM 2016) Letárgico/Coma

SHOCK CARDIOGÉNICO
Fisiopatología
Se produce por falla en la sístole ( GC).
Respuesta compensatoria: RVS
Es característico la congestión pulmonar, PCP y sistémica
PVC
Etiología
Infarto de miocardio, que afecta > 40 % del ventrículo izquierdo (causa más frecuente)
Arritmias
Valvulopatías agudas (insuficiencias)
Shock con piel fría ( GC)
Pulmón húmedo ( PCP)




Congestión pulmonar (crépitos difusos) con disnea severa asociado a hipotensión
Caída del índice
Uso de inotrópicos
Primera línea, norepinefrina
También se pueden emplear dobutamina o dopamina.
Tratar la causa subyacente; en casos de infarto de miocardio, realizar angioplastia. En casos refractarios, se usan dispositivos de asistencia ventricular (balón de contra pulsación aórtica).











Los signos de insuficiencia cardiaca congestiva (edema agudo de pulmón), junto con hipotensión o IC bajo, sugieren un shock cardiogénico.

Extremis Paciente en parada soportado con RCP - ECMO.
Deterioro Paciente que no responde al manejo.
Clásico Paciente con hipoperfusión, requiere soporte vasoactivo, inotropico o asistencia circulatoria.
Beginning (incipiente)
Paciente con hipotenso o taquicardico, sin signos de hipoperfusión.
At risk (en riesgo)
Paciente con factores de riesgo para shock cardiogenico.
Biomarcadores ETAPA
E
Examen físico
Colapso cardiovascular Ha recibido terapia eléctrica
D Etapa C con deterioro
Piel moteada y fria, edemas
Killip 3-4
CB
ASoporte ventilatorio
Estado mental alterado
GU<30ml/hora
PVJ elevada, crepitos
No hipoperfusión periférica
Examen normal
pH: < 7.2
Lactato > 5
Etapa C con deterioro
Lactato > 2
BNP elevado
Creatinina al doble
Disfunsión hepática
Lactato normal
BNP elevado
Función renal alterada
Lactato normal
Función renal normal

SHOCK OBSTRUCTIVO
Fisiopatología
Se produce por falla en la diástole ( GC).
Etiología
Tromboembolismo pulmonar
Taponamiento cardiaco
Neumotórax a tensión
Pericarditis constrictiva




Al shock obstructivo también se le denomina

Hemodinámica
No hay TAS sin resucitación
AESP - FV/TVSP
Hipotensión a soporte máximo
Etapa C + múltiples presores
Soporte circulatorio temporal
TAS < 90 mmHg TAM < 60mmHg
Necesidad de vasopresores
IC < 2.2 L/min/M2, Cuña > 15mmHg IPC: < 0.6 Wl
TAS < 90 mmHg TAM < 60 mmHg
IC: >2.2 L/min/m2, Svc02: > 65%
FC: > 100 x min
TA normal, IC > 2.5 L/min/m2,
PVC < 10 mmHg



Figura 102. Taponamiento cardiaco cuando el volumen alcanza > 250 ml de forma aguda o > 2 litros de forma crónica.



Figura 104. Tromboembolismo pulmonar. En el ecocardiograma, es característico el signo de la “D” en el ventrículo izquierdo.
Clínica
Shock con piel fría ( GC)
Pulmón húmedo ( PCP)
Congestión sistémica (ingurgitación yugular)
El tratamiento es etiológico.

Figura 103. Taponamiento cardiaco. En el ecocardiograma, es característico el colapso de cavidades derechas (signo específico).


Figura 105. Neumotórax a tensión. En la radiografía, es característico el colapso pulmonar izquierdo como se muestra en la imagen, con desplazamiento de la tráquea hacia el lado contralateral (sano).



Manejo 30
Realizar pericardiocentesis en casos de taponamiento cardíaco.
Toracostomía (aguja gruesa o tubo de drenaje) en casos de neumotórax a tensión
Anticoagulación inmediata ante tromboembolismo pulmonar

Los objetivos generales en el manejo del paciente con shock son los siguientes:
Presión arterial media (PAM) > 65 mmHg
Presión capilar pulmonar (PCP) 15 - 18 mmHg
Índice cardiaco (IC) > 2.2 L/min/m2
Hemoglobina > 10 gr/dl
Diuresis > 0.5 ml/kg/hr
Reversión de la encefalopatía
Aclaramiento de lactato
El manejo específico se describió en cada tipo de shock a mayor detalle.
Sepsis fluidos vasopresores (norepinefrina) corticoides o hemoderivados
Anafilaxia epinefrina IM 1/1000 epinefrina EV 1/10 000 glucagón EV (sobre todo si está tomando betabloqueadores) adyuvantes (corticoides, antihistamínicos)
Shock neurogénico fluidos vasopresores atropina (manejo de bradicardia)
Shock cardiogénico inotrópicos (norepinefrina, dobutamina)
Shock hipovolémico fluidos (cristaloides) hemoderivados
Shock obstructivo manejo etiológico












Se trata de una respuesta inflamatoria desregulada frente a un foco infeccioso que lleva a la falla de órgano. La particularidad es que responde a la fluidoterapia temprana y tiene una mortalidad de 10 %.
Clínicamente, incluye a pacientes que cumplen con los criterios de sepsis, que, a pesar de una adecuada reanimación con líquidos:
Requieren vasopresores para mantener una presión arterial media (PAM) ≥ 65 mmHg
Un lactato > 2 mmol/L (> 18 mg/dL).
Presenta una mortalidad del 40 %.
Estado cínico con ausencia de respuesta a fluidos y vasopresores.

El foco infeccioso más frecuente es el pulmonar (neumonías). En caso de las gestantes, el foco urinario (infección de tracto urinario)
En relación con los agentes patógenos, el origen bacteriano más frecuente son los Gram positivos (estreptococo, estafilococo) seguido por Gram negativos (enterobacterias).
La incidencia de sepsis fúngica ha aumentado durante la última década, pero sigue siendo menor que la sepsis bacteriana.

La sepsis responde a fluidos; el shock séptico no responde a fluidos, pero sí a vasopresores; el shock séptico resistente no responde a fluidos ni a vasopresores.


(ENAM 2014)

(ENARM 2014) (ESSALUD 2011) (ENAM EXTRA 2023)



(ENARM 2019)





2014)


Existen tres vías patógenas que explican la disfunción orgánica en el cuadro de sepsis:
Respuesta inflamatoria y contrainflamatoria:
Las citosinas proinflamatorias son IL1, IL6, FNT alfa, IFN λ, que inducen la vasodilatación generalizada con shock distributivo y son responsables de los efectos sistémicos (fiebre, hipotensión).
El estado hiperinflamatorio iniciado por la sepsis activa también mecanismos inmunodepresores de contrarregulación, reflejado con la producción de mediadores antiinflamatorios (receptor soluble de TNF e IL-10).
Activación y lesión endotelial
Produce aumento de la permeabilidad vascular con fuga plasmática que empeora la perfusión tisular.
Estado procoagulante
Generación de una coagulación intravascular diseminada (CID) por aumento del factor tisular (III), XII y del sistema antifibrinolítico.
Alteraciones metabólicas: resistencia a la insulina e hiperglucemia.

(ESSALUD 2013)





Los pacientes con sepsis sospechada suelen presentar fiebre, hipotensión, taquicardia y Leucocitosis. A medida que empeora la gravedad, se desarrollan signos de shock (piel fría y cianosis) y disfunción orgánica (oliguria, encefalopatía).
Para evaluar la falla de órgano, se siguen actualmente los criterios de SOFA
Respiratorio: relación entre la presión parcial de oxígeno arterial (PaO 2) / fracción de oxígeno inspirado (FiO 2) ( )
Hematología: recuento de plaquetas ( )
Hígado: bilirrubina sérica ( )
Renal: creatinina sérica ( )
Sistema nervioso: puntaje de coma de Glasgow ( )
Cardiovascular: presión arterial ( )


(ENAM EXTRA 2021)





De manera práctica, puede usarse la puntuación qSOFA, que es fácil de calcular, ya que solo tiene tres componentes, cada uno de los cuales es fácilmente identificable al lado de la cama del paciente y se les asigna un punto (≥ 2 puntos: sepsis probable).
Frecuencia respiratoria ≥22 / minuto
Sensorio alterado (Glasgow < 15)
Presión arterial sistólica ≤100 mmHg


Las medidas más importantes en el manejo de la sepsis es la fluidoterapia con cristaloides (ClNa 0.9 % o lactato de Ringer) en un volumen de 30 ml/kg en las tres primeras horas.
Oxigenoterapia
Aumentar la cobertura antibiótica dentro de la primera hora, previa toma de cultivos.
Uso de vasopresores en el caso de shock séptico; de elección, la norepinefrina. en casos refractarios, vasopresina o epinefrina.
Para los pacientes que son refractarios a la terapia con fluidos intravenosos y vasopresores, se pueden administrar terapias adicionales, como glucocorticoides (hidrocortisona), terapia inotrópica y transfusiones de sangre (hemoglobina <7 g/dl).
FÁRMACO EFECTO INOTRÓPICO (beta) EFECTO VASOPRESOR (alfa)

En el paciente con sepsis pueden ser necesarios de 6 a 10 L de líquidos intravenosos durante las primeras 24 horas. La norepinefrina es de primera línea en el manejo del shock séptico y del shock cardiogénico.


(ENARM 2016) (ENAM 2012) (ENAM 2013) (ENARM 2015) (ESSALUD 2018) 2


(ESSALUD 2018)


1 (ESSALUD 2018) (ENARM 2021)











El capítulo de GASTROENTEROLOGÍA es considerado un CAPÍTULO INTERMEDIO debido al porcentaje moderado de preguntas que generalmente se incluyen en exámenes oficiales como ESSALUD, ENAM y ENARM. Por lo tanto, es recomendable revisar los temas más relevantes y consolidar los conceptos esenciales. Asigna repasos espaciados y realiza evaluaciones junto con capítulos menores para maximizar la eficiencia de tu tiempo de estudio.






Definición
Condición patológica que aparece cuando el reflujo del contenido del estómago produce manifestaciones clínicas y/o lesiones inflamatorias.
Epidemiología
Sexo: ♀ = ♂
Patología más frecuente de esófago
Fisiopatología
1 (ENARM 2015) 2 (ENARM 2006) (ENAM EXTRA 2022)
Desbalance entre los factores que promueven el reflujo (↑ácido, pepsina) y los mecanismos protectores (↓salivación, ↓ aclaramiento o peristaltismo).
Los mecanismos que los producen son los siguientes:
Mayor frecuencia de relajaciones transitorias del esfínter esofágico inferior (+ importante)
Desequilibrio entre las presiones intragástrica (↑) y del esfínter esofágico inferior (↓) 1
Esfínter esofágico corto (< 2 cm) o hipotónico (< 10 mmHg)
Anomalías anatómicas de la unión gastroesofágica (hernia de hiato tipo I) 2

Figura 1. Las relajaciones transitorias del esfínter esofágico inferior es el principal mecanismo para la ERGE.

Figura 2. Hernia del hiato tipo I (deslizamiento), que se asocia a ERGE (ENARM 2006)(ENAM EXTRA 2022), y la hernia del hiato tipo II, que (paraesofágica) se asocia a vólvulo gástrico.
Lesión histopatológica
Necrosis coagulativa superficial en el epitelio escamoso no queratinizado → esofagitis por reflujo
La transformación del epitelio escamoso → cilíndrico intestinal (células caliciformes) → metaplasia o esófago de Barrett (reflujo crónico) 3

3. Esófago de Barrett. Metaplasia intestinal de la mucosa esofágica inducida por reflujo crónico. Epitelio poliestratificado plano → monoestratificado cilíndrico intestinal (células caliciformes) (ENAM 2012)
Tabaquismo (nicotina)
Consumo de cafeína y alcohol
Estrés
Obesidad 1
Embarazo (↑ progesterona)
Ángulo gastroesofágico o de His (> 60 °)
Iatrogénico (p. ej., después de una gastrectomía)
ERGE no erosiva:
Factores protectores esofágicos inadecuados (↓saliva, ↓peristaltismo)
Esclerodermia (hipotonía del esfínter esofágico)
Hernia hiatal tipo I o deslizante (factor anatómico importante)
Asma
Síntomas característicos de la ERGE sin lesión esofágica, como esofagitis por reflujo en la endoscopia (50 – 70 % de los pacientes)
Disociación clínica endoscópica (más común)
ERGE erosiva:
ERGE con evidencia de lesión esofágica, como esofagitis por reflujo en la endoscopia (30 – 50 % de los pacientes).
3 (ENARM 2007) (ENARM 2002) (ENAM 2012)
La hernia del hiato tipo I (deslizamiento) se asocia a ERGE (ENARM 2006); la hernia del hiato tipo II (paraesofágica) se asocia a vólvulo gástrico.
La ERGE es la patología esofágica más frecuente y consulta más común a nivel ambulatorio.
1 (ENAM EXTRA 2020)

Diagnóstico
Síntomas esofágicos (típicos)
Pirosis (ardor retroesternal) → + frecuente 1
Regurgitación → + específico 2
Dolor torácico
Síntomas extraesofágicos (atípicos)
Tos crónica no productiva, vespertina 3
Ronquera (laringitis)
Erosiones dentales
Asma
Síntomas de alarma (injuria esofágica → complicaciones)
Odinofagia → esofagitis
Disfagia → estenosis péptica
Hemorragia digestiva → úlceras esofágicas
Baja de peso → esófago de Barret
Factores agravantes
Acostarse poco después de las comidas
Ciertos alimentos (grasas) / bebidas (alcohol)
Fármacos (nitratos, calcioantagonistas, benzodiacepinas, beta agonistas, teofilina)
Terapia empírica → inhibidores de bomba de protones (IBP)
Cuando el dolor torácico mejora con nitratos se trata de una angina; si empeora, es por ERGE.
1 (ENAM 2017) (ENAM EXTRA 2020) (ENARM 2009) (ENARM 2007) (ENARM 2023)
2 (ENAM EXTRA 2020) (ENARM 2023)
3 (ENAM EXTRA 2020)
4 (ENAM 2011) (ENAM 2010)
Refuerza el diagnóstico en pacientes con síntomas típicos en pacientes < 60 años de edad.
Monitoreo del pH esofágico (Phmetría)
Prueba + sensible y específica para confirmar reflujo ácido (estándar de oro) 4
Indicaciones
♦ Síntomas refractarios de ERGE a pesar de la terapia con IBP
♦ Confirmación de sospecha de ERGE no erosivo
♦ Síntomas atípicos o extraesofágicos

La clínica atípica más común de la ERGE es la tos crónica persistente, pero primero debemos descartar causas respiratorias.
Impedanciometría
Complementa para el diagnóstico de reflujo alcalino (sales biliares)
Endoscopía digestiva alta:
Solicitarla frente a síntomas de alarma (disfagia, odinofagia, hemorrragia, ↓ peso)
Factores de riesgo para el esófago de Barrett
Sin mejoría sintomática después del ensayo con IBP
Manometría esofágica
Descartar problemas motores del esófago (acalasia, esclerodermia)
Solicitarla antes de la cirugía

Esófago de Barrett
6. Esofagitis erosiva. Son visibles las múltiples úlceras y erosiones lineales y redondas (algunas de color rojo más oscuro, algunas cubiertas por un exudado fibrinoso gris).
Metaplasia intestinal de la mucosa esofágica inducida por reflujo crónico
♦ Epitelio poliestratificado plano → monoestratificado cilíndrico 1
Lesión premaligna que requiere una estrecha vigilancia.
♦ Metaplasia → displasia → adenocarcinoma 2
Incidencia: hasta el 15 % de los pacientes con ERGE 3
Factores de riesgo
♦ Sexo masculino
♦ Descendencia europea (etnia caucásica)
♦ Edad ≥ 50 años
♦ Obesidad
♦ Síntomas ≥ 5 años
Diagnóstico: endoscopía + biopsia
Clasificación:
♦ Segmento corto (< 3 cm)
♦ Segmento largo (> 3 cm) → mayor riesgo de cáncer (adenocarcinoma)
El hallazgo endoscópico más común asociado con la lesión de la mucosa esofágica es la esofagitis por reflujo.
1 (ENARM 2007) (ENARM 2002)
2 (ENAM 2020)
3 (ENAM 2010)

♦ Considere si es asintomático.
♦ Continúe la terapia de mantenimiento a largo plazo si presenta síntomas. Endoscopia con biopsias de cuatro cuadrantes en cada 2 cm del área sospechosa (mucosa de color rojo salmón)
♦ Si no hay displasia: repita la endoscopia cada 3-5 años.
♦ Si existe displasia de bajo grado: vigilancia cada 6-12 meses con biopsias cada 1 cm.
♦ Si hay displasia de alto grado:
– Tratamiento endoscópico de las irregularidades de la mucosa (ablación por radiofrecuencia, resección endoscópica).
– Considere la cirugía: esofaguectomía con anastomosis término–terminal.

→ el ácido del estómago daña el epitelio escamoso estratificado del esófago distal → que luego se reemplaza por epitelio columnar y células caliciformes.
Secuela más común de esofagitis por reflujo
Clínica: disfagia mecánica (alimentos sólidos > líquidos)
Esofagrama con bario
♦ Prueba inicial de elección
♦ Estrechamiento del esófago en la unión gastroesofágica
Endoscopia con biopsias:
♦ Para descartar malignidad
Tratamiento de primera línea
♦ Dilatación con dilatador bougie / dilatador con balón e IBP en pacientes con reflujo
En casos refractarios (recurrencias múltiples):
♦ Inyección de esteroides antes de la dilatación
♦ Incisión electroquirúrgica endoscópica
Complicaciones adicionales
Esofagitis por reflujo
♦ Complicación más común de la ERGE
Anemia ferropénica:
♦ Debido a erosiones y ulceraciones mucosas → hemorragia crónica
Anillos de Schatzki
♦ Se observa con mayor frecuencia en la unión escamoso-cilíndrica (línea Z).
♦ Generalmente, causado por reflujo ácido crónico.
♦ Puede provocar disfagia intermitente.
Complicaciones por aspiración de contenido gástrico
♦ Neumonía por aspiración
♦ Bronquitis crónica
♦ Asma (exacerbación)
Cambios en el estilo de vida
Recomendaciones dietéticas
♦ Porciones pequeñas (comidas fraccionadas)
♦ Evite comer al menos 3 horas antes de acostarse.
♦ Evite ciertos alimentos (grasas y azúcares simples) y bebidas (alcohol).
Recomendaciones físicas
♦ Pérdida de peso en pacientes con obesidad
♦ Eleve la cabecera de la cama (10-20 cm) para pacientes con síntomas nocturnos.
Reducir o evitar sustancias desencadenantes
♦ Nicotina, alcohol, cafeína
♦ Medicamentos que pueden empeorar los síntomas
– Nitratos, calcioantagonistas, benzodiacepinas, betaagonistas, teofilina
Terapia farmacológica
IBP (omeprazol, pantoprazol)
♦ Dosis estándar durante 8 semanas
♦ Fármacos de elección
♦ Ensayo empírico con IBP en pacientes con síntomas típicos
Antagonistas del receptor de Histamina H2 (ranitidina, cimetidina) 1
♦ Considérelos como terapia de mantenimiento alternativa.
Procinéticos (metoclopramida)
♦ Cuando predomina la regurgitación.
Terapia quirúrgica
Indicaciones
♦ Síntomas refractarios a la terapia médica
♦ Complicaciones a pesar del tratamiento médico óptimo (esofagitis grave, estenosis)
Funduplicatura: técnica quirúrgica de elección 2
♦ Abordaje laparoscópico o abierto
♦ Funduplicatura parcial: cuando se asocia patología motora del esófago (manometría anormal)
– Funduplicatura Dor (180 °)
– Funduplicatura de Toupet (270 °)
– Funduplicatura de Belsey
♦ Funduplicatura total: cuando no existe patología motora del esófago (manometría normal)
– Funduplicatura de Nissen (360 °)

Funduplicatura de Nissen (funduplicatura posterior 360°)
Funduplicatura de Dor funduplicatura anterior 180°


1 (ENAM EXTRA 2022) (ENARM 2023)
2 (ENARM 2012)
Belsey-Mark IV Plicatura anterior de la unión gastro-esofágica
Síntoma inespecífico que se refiere a la dificultad para la deglución 1 . Cuando existe dolor a la deglución se denomina odinofagia.
Disfagia orofaríngea (alta):
♦ Dificultad para iniciar el proceso de deglución (2 primeros segundos)
♦ Experimentado predominantemente en la garganta o el cuello
Disfagia esofágica (baja):
♦ Dificultad para culminar el proceso de deglución (> 3 segundos de iniciada la deglución)
♦ Experimentado, sobre todo, retroesternalmente
Disfagia motora:
♦ Disfagia debida a un defecto neurológico o muscular
♦ Dificultad, principalmente, para alimentos líquidos
Disfagia mecánica:
♦ Disfagia debida a una obstrucción mecánica o anatómica
♦ Dificultad, principalmente, para alimentos sólidos
Disfagia Orofaríngea - Motora
Debido a problemas neuromusculares
Enfermedad cerebrovascular
(causa + común)
Miastenia Gravis
Guillan Barre
Disfagia Orofaríngea - Mecánica
Divertículo de Zenker
Botulismo
Enfermedad de Parkinson
Distrofias musculares
Miopatías inflamatorias
♦ Ocurren con mayor frecuencia en hombres de mediana edad y ancianos.
♦ Divertículo falso (mucosa y submucosa) → se forma por pulsión → protruye por el triángulo de Killian
♦ Disfagia + halitosis 1
♦ Regurgitación de alimentos no digeridos 2
♦ Complicación: neumonía aspirativa
♦ Radiografía con contraste, mejor prueba de confirmación. Se deben evitar estudios endoscópicos por posible lesión del divertículo (perforación).
♦ Tratamiento médico
– IBP: para los síntomas del reflujo gastroesofágico
– Inyección de toxina botulínica: en pacientes sintomáticos con trastornos de la motilidad esofágica y contraindicaciones para la cirugía.
♦ Tratamiento quirúrgico
– Divertículos de Zenker sintomáticos – Asintomáticos con divertículo > 1 cm
(ENARM 2015)
La disfagia orofaríngea más frecuente es de origen motor, mientras que la disfagia esofágica es más frecuente por causas mecánicas.
El tercio superior del esófago contiene músculo esquelético y tiene inervación somática, mientras que en los dos tercios inferiores predomina el músculo liso, con inervación autonómica.
(ENARM 2016)
(ENARM 2016)

Síndrome de Plummer Vinson (síndrome de Patterson Kelly)
♦ Condición que afecta a mujeres de mediana edad (40 a 70 años)
♦ Causado por factores genéticos y déficit nutricionales
♦ Triada clínica
– Anemia ferropénica (coiloniquia)
– Disfagia
– Membranas esofágicas (no afectan la capa muscular)
♦ Se asocia a glositis atrófica y predispone carcinoma epidermoide de esófago
♦ Responden bien a la suplementación con hierro o a la dilatación endoscópica con balón en casos persistentes.



12. Una delgada membrana semilunar se proyecta hacia la luz en la parte superior del esófago, junto con la anemia por deficiencia de hierro (coiloniquia) y la disfagia forman parte de la triada clásica del síndrome de Plummer-Vinson.
Acalasia
♦ Problema motor producido por una aperistalsis del esófago asociado a un EEI hipertónico (ausencia de relajación del EEI) 3
♦ Disfagia motora + regurgitación + baja de peso 4
♦ Radiografía baritada: imagen en pico de pájaro o punta de lápiz
Espasmo difuso del esófago
♦ Producido por contracciones terciarias
♦ Dolor torácico con alimentos fríos o calientes
♦ Radiografía baritada: imagen en sacacorcho
Esclerodermia
♦ Producido por fibrosis y/o atrofia del esófago con un EEI hipotónico (reflujo)
♦ Pirosis + fenómeno de Raynaud
♦ Radiografía baritada: imagen en tubo rígido
Disfagia Esofágica-Mecánica
Cáncer de esófago
♦ Tipo edipdermoide (+ común 1/3 medio) → tabaco y alcohol
♦ Tipo adenocarcinoma (+ común 1/3 inferior) → esófago de Barret
♦ Cursa con disfagia progresiva + ↓ peso
B C 3 (ENARM 2020) 4 (ESSALUD 2010) (ENAM 2017)


disfagia
progresiva con pérdida de peso significativo.
Estenosis péptica
♦ Principal secuela de la ERGE
♦ Cursa con disfagia progresiva + historia de pirosis

15. Estenosis péptica, principal secuela de la ERGE.
Radiografía con contraste de bario
♦ Prueba inicial de elección para disfagia de tipo motora
♦ Ideal para disfagia orofaríngea
Anillos esofágicos (anillo Schatzki)
♦ Se observa con mayor frecuencia en la unión escamo–columnar (línea Z).
♦ Generalmente, causado por reflujo ácido Crónico.
♦ Produce disfagia intermitente.

Figura 16. Anillos esofágicos (anillo Schatzki) localizados en la línea Z (unión escamocolumnar).
♦ Proporciona una evaluación funcional de la deglución y se puede utilizar para evaluar el riesgo de aspiración.
Manometría esofágica
♦ Prueba de elección para confirmar problemas motores del esófago (Gold estándar)
Endoscopía
♦ Prueba de elección para disfagia mecánica
♦ Se pueden tomar biopsias durante el procedimiento.
♦ Descartar malignidad cuando se presenten los siguientes datos:
– > 50 años
– Pérdida de peso involuntaria, clínicamente significativa
– Progresión de los síntomas durante un período corto de tiempo (< 4 meses)
– Evidencia de hemorragia gastrointestinal
– Vómitos recurrentes
– Historia de cáncer
Trastorno de la motilidad esofágica de origen, generalmente, primario.
Etimología: A (ausente) - calasia (relajación)
Caracterizado por una relajación inadecuada del esfínter esofágico inferior (EEI) 1 → esfínter hipertónico
→ ↓ neuronas inhibidoras (ON, VIP) → ↑ neuronas excitadoras (acetilcolina, sustancia P)
Contracciones no peristálticas en los dos tercios distales del esófago
→ debido a la degeneración del plexo mientérico de Auerbach
→ pérdida de receptores de acetilcolina 2 .
1 (ENARM 2004)
2 (ENAM 2015, ENAM 2011)
Acalasia primaria (más común): idiopático
Acalasia secundaria (pseudoacalasia):
♦ Enfermedad de Chagas (común en nuestro medio) 1
♦ Cáncer de esófago
♦ Carcinoma de cardias
♦ Amiloidosis
♦ Neurofibromatosis tipo I
♦ Sarcoidosis
1 (ENARM 2007)
Más comúnmente se produce en individuos de mediana edad (25 a 60 años)

Figura 17. La pérdida de neuronas inhibidoras que secretan VIP y NO conduce a una actividad excitadora (Ach, sustancia P) sin oposición y al fracaso de la relajación del EEI (hipertónico). Ach, acetilcolina; NO, óxido nítrico; VIP, péptido intestinal vasoactivo.
Disfagia a sólidos y líquidos (motora): síntoma cardinal y precoz 1
Disfagia paradójica: dificultad para ingesta de líquidos, mientras que los sólidos se ingieren con normalidad.
Regurgitación
Pérdida de peso 2
Dolor retroesternal (torácico)
Para evaluar la severidad y la respuesta al tratamiento → el score de Eckardt
1 (ENARM 2007) (ESSALUD 2010) (ENAM 2017)
2 (ENARM 2007) (ENAM 2017)
3 Con cada comida Con cada comida Con cada comida >10
Los trastornos de la motilidad esofágica suelen causar disfagia tanto con sólidos como con líquidos. La disfagia que predomina con sólidos sugiere una obstrucción mecánica.
Radiología (con bario)
♦ Megaesófago afilado en la punta
♦ Imagen “pico de pájaro”, “punta de lápiz”, “cola de ratón”
♦ Nivel hidroaéreo en el mediastino
♦ Mediastino ensanchado
Endoscopia
♦ Descarta causas secundarias (pseudoacalasia)
♦ Lo más importante es descartar malignidad (> 60 años, ↓peso, presentación aguda) 3

Figura 18. Radiología baritada en acalasia. Esófago con imagen en “cola de ratón” o “pico de pájaro”.
Riesgo quirúrgico bajo
Manometría
♦ Prueba de elección para confirmar el diagnóstico (prueba de oro)
♦ Hallazgos patológicos:
– Perístasis alterada en el cuerpo del esófago → más común aperistalsis 4
– Ausencia de relajación del EEI → esfínter hipertónico 5
Manometría de alta resolución
♦ Permite su clasificación en tres subtipos (clasificación de Chicago):
– subtipo I (acalasia clásica) → respuesta parcial al tratamiento
– subtipo II (+ común) → respuesta favorable al tratamiento
– subtipo III (acalasia espástica) → pobre respuesta al tratamiento

SUBTIPO I – II (CLASIFICACIÓN DE CHICAGO)
Dilatación neumática con balón
♦ Tratamiento no quirúrgico más eficaz
♦ Mayor riesgo de perforaciones
Miotomía extramucosa de Heller 1 :
♦ Procedimiento quirúrgico en el que se hace una incisión longitudinal en el esfínter esofágico inferior para volver a permitir el paso de alimentos o líquidos al estómago.
3 (ESSALUD 2014)
4 (ENARM 2020)
5 (ENARM 2020)
1 (ESSALUD 2010)
♦ Tratamiento más efectivo y seguro a largo plazo
♦ Técnica de elección: miotomía laparoscópica
♦ Mayor riesgo de ERGE y estenosis
SUBTIPO III (CLASIFICACIÓN DE CHICAGO)
Miotomía endoscópica por vía oral (POEM)
Riesgo quirúrgico alto
Inyección de toxina botulínica en el EEI
Farmacoterapia: nitratos o bloqueadores de los canales de calcio


Hay diarrea si se cumple uno de los siguientes criterios:
Defecación frecuente: ≥ 3 veces al día
Consistencia de las heces alterada: mayor contenido de agua
Aumento de la cantidad de heces: más de 200-250 g por día
Diarrea crónica: que dura > 30 días
Diarrea secretora
Secreción activa de agua en la luz intestinal a través de la inhibición/activación de enzimas (↑ actividad de AMPc) → pérdida de electrolitos K y HCO3
Diarrea osmótica/ Malabsortiva
La mala absorción o la ingestión excesiva de sustancias hidrófilas (sales y azúcares, laxantes) hace que el agua ingrese a la luz intestinal.
Diarrea inflamatoria
El daño a la mucosa intestinal puede causar hipersecreción de agua inducida por citocinas, afectar la absorción de sustancias osmóticamente activas o grasas y / o interrumpir la absorción de agua y electrolitos. Moco, sangre y leucocitos presentes en las heces.

Diarrea funcional
Principal causa
→ síndrome de intestino irritable
Hipertiroidismo
Fármacos (eritromicina)
Diarrea orgánica
Tiene varios subtipos:
En caso de diarrea aguda, su duración es ≤ 14 días y su principal causa es infecciosa, mientras que la diarrea crónica es, principalmente, por problemas funcionales.
♦ Diarrea secretora → tumores gastrointestinales (gastrinoma, carcinoide, vipoma), fármacos (colchicina)
♦ Diarrea osmótica → uso de laxantes, intolerancia a la lactosa 1
♦ Diarrea malabsortiva → pancreatitis crónica, enfermedad celiaca, enfermedad de Whipple
♦ Diarrea inflamatoria → colitis inflamatoria, isquémica, infecciosa
La lactosa es un disacárido que se fragmenta a galactosa y glucosa (ENARM 2018)
1 (ENARM 2018)
INFLAMATORIA
Enf. de Crohn Insuf. pancreática
Colitis isquémica
Enterocolitis por radiación
Diarrea funcional
Uso de laxantes (lactulosa)
Enfermedad celiaca Intolerancia lactosa
Enfermedad de Whipple
Hidróxido de magnesio
Más frecuente en mujeres de mediana edad
No tiene datos de organicidad (↓peso, anemia, sangre en heces)
Principalmente, matutino (respeta el sueño)
Mejora del dolor abdominal después de la defecación (intestino irritable)
Alterna periodos de estreñimiento con diarrea (intestino irritable)
Diarrea orgánica
Presenta datos de organicidad
♦ Presencia de sangre en las heces
♦ Aparición de fiebre
♦ Pérdida reciente de peso (>5kg)
♦ Aparición en edades avanzadas (>40 años)
♦ Historia familiar de cáncer
♦ Diarrea nocturna
♦ Diarrea que persiste tras el ayuno
♦ Heces muy abundantes o esteatorreicas
♦ Volumen de heces de 24h >400 ml/día
♦ Anomalías en la exploración física
♦ Presencia de anemia, hipoalbuminemia
♦ Elevación de reactantes de fase aguda
Síndrome carcinoide, Vipoma
Síndrome Intestino Irritable
Gastrinoma Hipertiroidismo
Enteropatía por sales biliares
Síndrome post. Vagotomía
Se presenta en las mañanas y las noches
Tiene varios subtipos
♦ Diarrea secretora
– Brecha osmótica en heces baja (<50 mOsm / kg)
– Peso > 1000 gr/día
– Pérdida de K, HCO3, Na
– Ph alcalino heces (lactato negativo)
♦ Diarrea osmótica
– Brecha alta (> 120 mOsm / kg)
– Peso 500 a 1000 gr/día
– No pérdida de electrolitos
– Ph ácido heces (lactato positivo)
♦ Diarrea malabsortiva
– Esteatorrea (grasa en heces > 7gr/día) 1
– Heces lientéricas
– Pérdida de peso 2
– Déficit nutricional (anemia megaloblástica, ferropénica)
♦ Diarrea inflamatoria
– Brecha osmótica en heces normal
– Peso < 500 gr/día
– Moco, sangre y leucocitos presentes en las heces
Gap Osmolar en Materia Fecal 1 (ENAM 2020) 2 (ENAM 2020)
Osmolaridad 290 Cálculo 290 - 2 (Na + K)
= 50 a 125
Figura 20. Fórmula para calcular el GAP
Brecha osmótica de las heces
→ una ecuación utilizada para identificar si la diarrea acuosa tiene una etiología osmótica o secretora.
Definición
1 (ENARM 2010)
Afección crónica funcional 1 muy común que afecta del 20 al 50 % de los pacientes con molestias gastrointestinales.
1 (ENAM 2015)
Edad: mayor prevalencia en personas de 20 a 39 años (< 50 años) 1
1 (ENARM 2010, 2007, 2018)
El SII es un trastorno gastrointestinal funcional, recurrente, sin una causa orgánica específica 1
Los procesos fisiopatológicos que conducen al SII son multifacéticos y aún no se comprenden completamente.
Los hallazgos más comunes asociados son:
♦ Motilidad gastrointestinal alterada
♦ Hipersensibilidad / hiperalgesia visceral
Diagnóstico
Dolor abdominal crónico (matutino) 1
♦ Permeabilidad alterada de la mucosa gastrointestinal
♦ Aspectos psicosociales
♦ Típicamente relacionado con la defecación (mejora con la defecación) 2
Cambios en los hábitos intestinales 3
♦ Periodos de diarrea (Bristol 5-7) y de estreñimiento (Bristol 1-2) 4
Otros síntomas gastrointestinales:
♦ Náuseas, reflujo, saciedad precoz
♦ Distensión abdominal
Síntomas extraintestinales:
♦ Síntomas somáticos generalizados (dolor o fatiga, como en la fibromialgia)
♦ Función sexual alterada
♦ Dismenorrea
♦ Aumento de la frecuencia y urgencia urinarias
Exploración física: normal (no hay datos de organicidad) 5
El SII es un diagnóstico clínico basado en la historia del paciente (criterios de Roma IV) y los síntomas.
Criterios de Roma IV
Dolor abdominal recurrente en promedio al menos 1 día a la semana durante los 3 meses anteriores, que está asociado con 2 o más de los siguientes:
♦ Dolor relacionado con la defecación 6
♦ Cambio en la frecuencia de las deposiciones 7
♦ Cambio en la forma o apariencia de las heces
Con inicio de los síntomas al menos 6 meses antes del diagnóstico
Otros síntomas compatibles con el SII
Un historial familiar de enfermedad inflamatoria intestinal, enfermedad celíaca o cáncer colorrectal es inusual en pacientes con SII
Si no se sospecha ningún otro diagnóstico diferencial, las pruebas de laboratorio y las imágenes, generalmente, no se recomiendan para personas menores de 50 años si muestran signos típicos de SII y carecen de signos de alarma, como anemia por deficiencia de hierro, pérdida de peso o antecedentes familiares de enfermedades orgánicas gastrointestinales.
1 (ENARM 2004)
2 (ENARM 2004, 2018) (ESSALUD 2014) (ENAM EXTRA 2022)
3 (ENARM 2007) (ENARM 2018)
4 (ENARM 2007) (ENAM 2015)
5 (ENARM 2007) (ENARM 2004)
6 (ENARM 2004) (ENARM 2018)
7 (ENARM 2007) (ENARM 2018)
Algunos datos de alarma en diarrea son → diarrea nocturna y dolor abdominal, fiebre, heces con sangre, pérdida de peso y síntomas de aparición aguda.

Figura 21.
La presencia de dolor abdominal que mejora con la defecación y alternancia de periodos de estreñimiento con diarrea nos debe hacer sospechar en SII.
TIPO 1
Trozos duros separados, como nueces, que pasan con dificultad
TIPO 2
Con forma de salchicha, pero compuesta de fragmentos duros apelotonados
TIPO 3
IBS-D (la diarrea es el síntoma predominante)
IBS-C (el estreñimiento o constipación es el síntoma predominante)
IBS-M (mixtos, diarrea y estreñimiento)
IBS-A (alternancia de diarrea y estreñimiento) 1

Como una salchicha, pero con grietas en la superficie
TIPO 4
Como una salchicha, lisa y suave
TIPO 5
Trozos pastosos con bordes bien definidos
TIPO 6
Pedazos blandos y esponjosos con bordes irregulares
TIPO 7
Acuosa, sin pedazos sólidos, totalmente líquida
Medidas generales
Consultas periódicas y tranquilidad de que la enfermedad, aunque crónica, es benigna
Cambios en el estilo de vida
♦ Mucha hidratación
♦ Alimentos ricos en fibra
♦ Evitar alimentos que producen gases (frijoles, cebollas, ciruelas pasas), lactosa, gluten.
Actividad física
Manejo del estrés (terapia de relajación)
Terapia psicológica (terapia cognitivo-conductual)
1 (ENARM 2007) 1 (ENARM 2013) 2 (ENARM 2013) 3 (ENARM 2013)
Terapia médica
Diarrea
♦ Antidiarreicos (loperamida) 1
♦ Rifaximina
♦ Alosetrón (antagonista de 5-HT3)
Estreñimiento
♦ Fibras solubles / laxantes formadores de masa (psyllium) 2
♦ Laxantes osmóticos (polietilenglicol) 3
♦ Lubiprostona (activador del canal de cloruro)
Dolor abdominal
♦ Antiespasmódicos (diciclomina, hiosciamina)
♦ Antidepresivos tricíclicos (amitriptilina, nortriptilina)
Infección producida por la toxina de Clostridium difficile 1
1 (ENAM 2012) (ENARM 2018)
Patógeno causante: Clostridium difficile
Bacilo Gram positivas, anaerobio obligado
Cepas toxigénicas causan infección por C. difficile
Forma esporas resistentes al medio ambiente (capaces de resistir el calor y el ácido)
Altamente contagioso
Presente ubicuamente
Vía de transmisión fecal-oral (comunidad) o a través de superficies y equipos médicos contaminados (hospitalaria)
Tratamiento antibiótico reciente (+ importante) 1
♦ Clindamicina (+ frecuente) 2
♦ Cefalosporinas
♦ Fluoroquinolonas
Edad avanzada
Supresión de ácido gástrico (IBP)
Principal causa de diarrea nosocomial (atención hospitalaria en las 12 semanas anteriores)
Más comunes en las personas de edad > 65 años

Alimentación enteral
Enfermedades graves
Hospitalización reciente
Inmunosupresión
Enfermedad inflamatoria intestinal
1 (ENARM 2018) (ENARM 2006) 2 (ESSALUD 2013)
Los antibióticos destruyen la flora bacteriana intestinal normal → prolifera C. difficile, ya que es resistente a la mayoría de los antibióticos de uso común → coloniza el tracto intestinal
→ produce toxinas→ diarrea (colitis).
C. difficile posee una gama de factores de virulencia, la más importante, de las cuales son las toxinas A y B.
Toxina A (enterotoxina)
♦ Mecanismo de acción: unión al borde en cepillo de los enterocitos.→ endocitosis mediada por receptores → cambio de conformación → exposición del dominio activo → glicosilación de proteínas diana (Rac, Cdc42, RhoA) → alteración del funcionamiento del citoesqueleto de actina→ aumento de la permeabilidad epitelial y apoptosis → diarrea
Toxina B (citotoxina)
♦ Mecanismo de acción: igual que en la toxina A, pero también puede causar la formación de poros dentro de la membrana endosomal mediante la inserción del dominio de translocación → liberación del contenido endosómico en el citosol → efecto citopático

Los síntomas se desarrollan típicamente durante el tratamiento con antibióticos 2 a 10 días después de su inicio; sin embargo, entre el 25 y el 40 % de los casos se manifiestan hasta 10 semanas después del tratamiento.
Diarrea acuosa → inflamatoria 1
♦ ≥ 3 deposiciones por día asociadas con un olor característico
♦ Puede contener trazas de moco o sangre oculta.
Dolor abdominal, náuseas, anorexia
Fiebre y deshidratación (especialmente, en casos graves)
La forma fulminante puede manifestarse con distensión abdominal e hipovolemia grave
♦ Debido a megacolon tóxico, íleo paralítico
Dosaje de toxina en heces de C. difficile (↑ especificidad)
LEVE: leucocitosis <15.000 células / mm 3 y creatinina sérica < 1,5 mg / dL
GRAVE: leucocitosis ≥ 15.000 células / mm 3 o creatinina sérica ≥ 1,5 mg / dL
FULMINANTE: ≥ 1 criterio del cuadro grave más hipotensión, shock, íleo y / o megacolon tóxico
Médico
Vancomicina VO 125 mg c/6 horas por 10 días (+ efectivo) 1
Fidaxomicina VO
Alternativa: metronidazol VO
Casos fulminantes → vancomicina VO
↑ dosis + metronidazol EV

1 (ENARM 2018) (ENARM 2006) 1 (ENARM 2015)
Indicaciones: pacientes críticamente enfermos , con cuadro grave o fulminante, refractaria a la terapia con antibióticos, especialmente si ≥ 1 de los siguientes están presentes:
♦ Leucocitosis grave o lactato sérico ↑↑
♦ Complicaciones: megacolon tóxico, isquemia o perforación intestinal Procedimientos
♦ Colectomía total con ileostomía terminal y muñón rectal engrapado
Enteropatía inmune debida a una intolerancia al gluten → trigo (gliadina), centeno (secalina), cebada (hordeína), avena (avenina).
También se denomina → esprúe celíaco o esprúe no tropical.
Epidemiología
Sexo: ♀ > ♂
Edad de inicio → bimodal
♦ A los 8-12 meses
♦ Tercera a cuarta década de la vida
Raza: más común en individuos de ascendencia del norte de Europa.
Factor genético: HLA DQ2 (90 a 95 %) – DQ8. (5-10 %)
Familiares de primer grado
Síndrome de Down

26. Enfermedad celiaca: intolerancia al gluten.
Diabetes mellitus tipo 1
Tiroiditis autoinmune
Déficit selectivo de IgA
Los síntomas se manifiestan cuando un individuo genéticamente predispuesto desarrolla una respuesta inmunológica a la gliadina (una fracción del gluten).
Consumo de alimentos que contienen gluten → se libera transglutaminasa tisular → modifica la gliadina de las proteínas del gluten → las células T patógenas reaccionan y son activadas por la gliadina modificada → median en la inflamación intestinal crónica → daño epitelial que produce atrofia de las vellosidades e hiperplasia de las criptas 1 con pérdida del borde en cepillo → absorción deficiente de nutrientes en el intestino delgado (especialmente, en el duodeno distal y yeyuno proximal.
1 (ENARM 2006)
Diarrea crónica y recurrente (esteatorrea)
Raro: estreñimiento
Malabsorción específica de nutrientes:
♦ Anemia ferropénica
♦ Osteoporosis
♦ Hipocalcemia
Distensión abdominal y flatulencia
Desnutrición
Anorexia
Náuseas, vómitos
Retraso del desarrollo (crecimiento y pubertad)
Niveles elevados de transaminasas hepáticas
Las asociaciones dermatológicas: dermatitis herpetiforme (ver Figura 51)
Aumenta el riesgo de → linfom
Serología
♦ Anticuerpo transglutaminasa tisular IgA (tTG IgA) → prueba inicial (↑ sensibilidad)
♦ Anticuerpo anti-endomisial (EMA): posible prueba confirmatoria de segunda línea (↑especificidad)
Prueba de HLA: prueba de segunda línea después de una evaluación inicial poco clara
♦ Evalúa los haplotipos HLA-DQ2 y HLA-DQ8 (↑VPN)
Endoscopía con biopsia de intestino delgado (prueba de confirmación)
♦ Indicaciones: serología positiva o alta sospecha clínica a pesar de serología negativa
♦ Se deben tomar al menos cinco biopsias duodenales.
♦ Infiltración linfocítica intraepitelial
♦ Hiperplasia de criptas 1
♦ Atrofia de las vellosidades 2
Dieta → Los síntomas suelen mejorar rápidamente.


(ENARM 2006) 2 (ENARM 2006)
♦ Dieta estricta → abstenerse de productos que contengan trigo, centeno, cebada o espelta
♦ Alimentos recomendados: arroz, maíz, soja
♦ Pacientes con deficiencia secundaria de lactasa: evite los productos lácteos.
♦ Suplementos de hierro y vitaminas Casos refractarios → corticoides
Enfermedad infecciosa causada por el Tropheryma whipplei, un bacilo gram- positivas que tiene poca virulencia, pero alta infecciosidad.
Muy raro.
Ocurre con mayor frecuencia en hombres mayores de 40 años.
Asociado a HLA B 27.
1 (ENARM 2020) 2 (ENARM 2020) 3 (ENARM 2020)
Manifestaciones intestinales
Dolor abdominal
Diarrea → síntoma más frecuente 1
Síndrome de malabsorción (esteatorrea) → tardío
Manifestaciones extraintestinales
Artritis (60 % de los casos) → síntoma precoz 2
♦ No deformante, migratoria, pequeñas y grandes articulaciones
♦ Dedos en palillo de tambor
Artralgias y, especialmente, sacroileítis (40 % de los casos)
Fiebre
Poliserositis
Linfadenopatía
Síntomas cardiacos (insuficiencia valvular)
Síntomas neurológicos (demencia, oftalmoplejía, mioclonías)
Afectación ocular: uveítis
Biopsias de intestino delgado:
♦ Detección de macrófagos espumosos con gránulos PAS + en la lámina propia 3
Prueba de PCR y tinción inmunohistoquímica
Las imágenes pueden mostrar agrandamiento de los ganglios mesentéricos.



Figura 29. La triada clásica de la enfermedad de WHIPPLE es la presencia de diarrea, artritis y fiebre. (ENARM 2020)
Ceftriaxona 2 g intravenosa una vez al día durante 2 semanas.
♦ Alergia a penicilina: meropenem

Figura 30. Macrófagos PAS positivos en el intestino delgado de un paciente no tratado con enfermedad de Whipple.
Tratamiento de mantenimiento con trimetoprim-sulfametoxazol oral durante 1 año
♦ Alergia a sulfas: doxiciclina + hidroxicloroquina
Definición
Tumor neuroendocrino secretor de gastrina (hormona que estimula la secreción de ácido).
1 (ENARM 2020)
Forma esporádica (80 % de los casos)
Asociación con la neoplasia endocrina múltiple tipo 1 (MEN 1) (20 % de los casos) 1
Localización más frecuente → 1. Duodeno 2. Páncreas
1 (ESSALUD 2018)
Los gastrinomas son tumores neuroendocrinos del tracto GI que secretan gastrina.
Hipergastrinemia → estimulación de las células parietales → hipersecreción de ácido gástrico 1 , que conduce a:
♦ La enfermedad de úlcera péptica (úlceras duodenales múltiples)
♦ El daño al epitelio intestinal y la inhibición de la absorción de sodio y agua → diarrea secretora
♦ Inactivación de enzimas pancreáticas → malabsorción (esteatorrea)
Síndrome de Zollinger-Ellison
♦ Dolor abdominal
♦ Diarrea secretora → esteatorrea
♦ Hemorragia digestiva alta (úlceras duodenales múltiples) 1
♦ Pérdida de peso
Gastrina > 1000 pg / ml (prueba confirmatoria)
Prueba de estimulación de secretina
♦ Si la prueba de gastrina sérica en ayunas no es concluyente
Las células parietales u oxínticas secretan a la luz gástrica iones H y K para formar ácido clorhídrico (ENAM 2017) y también producen FIC (factor intrinseco de Castle) importante para la absorción de la vitamina B12. (ESSALUD 2023)
1 (ESSALUD 2018)
Tomografía: determina la localización
♦ La mayoría de los gastrinomas se encuentran en un área llamada triángulo del gastrinoma (ver Figura 58)
♦ Duodeno (70 % de los casos)
♦ Páncreas (25 % de los casos) → típicamente la cabeza
♦ Ubicaciones ectópicas (5 a 15 % de los casos): hígado, ganglios linfáticos peri pancreáticos, ovarios

Figura 31. Prueba de secretina para gastrinoma. La hipersecreción marcada de gastrina ocurre después de la administración de secretina en un paciente con un gastrinoma (síndrome de Zollinger-Ellison) en comparación con la falta de respuesta en sujetos normales.
En un paciente que se presenta con diarrea secretora, hemorragia digestiva (úlceras duodenales múltiples), considérese un gastrinoma.

Figura 32. Triángulo del gastrinoma → El vértice superior está formado por la unión de los conductos biliar y cístico, el vértice medial por el cuello del páncreas y el vértice inferior por la tercera porción del duodeno.
Enfermedad infecciosa causada por el Tropheryma whipplei, un bacilo gram- positivas que tiene poca virulencia, pero alta infecciosidad.
Predisposición genética → HLA DR2, HLA B 27
Etnia (↑etnia caucásica, judía)
↑Etnia caucásica, judía > etnia afroamericana, hispana o asiática
Sexo: ♂ = ♀
Incidencia pico: 15 a 35 años (otro pico más pequeño en individuos > 55 años)
Colitis ulcerosa más prevalente enfermedad de Chron
Antecedentes familiares de enfermedad inflamatoria intestinal Episodios de infección intestinal previa

Aumento de la ingesta de grasas (especialmente grasas saturadas y grasas animales)
Ingesta de anticonceptivos orales
Los AINES pueden exacerbar la CU

La apendicectomía y el tabaco (fumador) son factores protectores para colitis ulcerosa. DATITO
1 (ENARM 2015) 2 (ENARM 2023) 2 (ENAM EXTRA 2021)
Diarrea sanguinolenta con moco → rectorragia
Dolor abdominal
Síntomas extraintestinales
♦ Articulares (más común) 1 – artritis periférica → colitis dependiente – espondilitis → asociado a HLA B 27 y colitis 2 independiente 3
♦ Ocular → uveítis anterior asociado a HLA B 27 y colitis dependiente
♦ Biliar → colangitis esclerosante primaria (ANCA P +), colitis independiente
♦ Cutáneo → pioderma gangrenoso (se trata de una lesión pustulosa dolorosa de bordes necróticos, que evoluciona hasta provocar úlcera)
♦ Hematológica → anemia ferropénica
♦ En niños / adolescentes → retraso del crecimiento y de la pubertad


↑ VSG, ↑ PCR, leucocitosis
ANCA P positivo (↑ especificidad)
Colonoscopía→hallazgos histopatológicos
♦ Zona más afectada recto sigmoides 4
♦ Afectación continua (difusa, pancolitis)
♦ Afectación parcial (mucosa – submucosa)

Sangre en heces
Frecuencia cardiaca (lpm)
Hemoglobina (g/L)
(mm/h)
Leucocitos
El ectima gangrenoso es producido en la bacteriemia por pseudomona y el pioderma gangrenoso por colitis ulcerosa.
4 (ENARM 2004)
5 (ENARM 2021) (ENAM EXTRA 2021)
♦ Formación de pseudopólipos y abscesos crípticos (acúmulo de PMN en la luz de las criptas) 5
♦ Metaplasia de células de Paneth

El curso clínico más común de la colitis ulcerosa es la forma crónica intermitente (la exacerbación va seguida de una remisión completa).
La colonoscopia está contraindicada en pacientes con colitis ulcerosa que cursan con un brote agudo, debido al alto riesgo de megacolon tóxico (perforación).
Hemorragia digestiva baja (masivo)
Megacolon tóxico
♦ Distensión y dolor abdominal
♦ Signos de sepsis (fiebre, taquicardia, hipotensión) y deshidratación
♦ Dilatación del colon (diámetro del colon transverso > 6 cm)
♦ Leucocitosis neutrofílica (> 10,500 / μL) y anemia
Perforación → peritonitis
Colitis fulminante: inflamación severa que causa típicamente
> 10 deposiciones por día, sangrado gastrointestinal, dolor y distensión abdominal
↑ Riesgo de cáncer colorrectal
♦ Afectación pancolónica
♦ Inicio en la infancia o en la adolescencia
♦ Curso de tipo crónico-continuo
♦ Duración mayor de 10 años
♦ Historia familiar de cáncer de colon
↑ Riesgo colangiocarcinoma
Anemia hemolítica autoinmune → anticuerpos calientes
Amiloidosis secundaria (+ frecuente en enfermedad de Crohn)
Médico → brotes agudos
Derivados del ácido
5-aminosalicílico (5-ASA) →
Mesalamina, Sulfasalazina
Corticosteroides tópicos →
Budesonida
Corticosteroides sistémicos solo si no hay respuesta
Antagonistas de la calcineurina →
Ciclosporina
Terapia anti-TNF (adalimumab o infliximab)
Vedolizumab (antagonista del receptor de integrina)
Para el mantenimiento de la remisión considere la mesalamina (oral, tópico, con la adición de azatioprina o medicamentos antiTNF, si los síntomas continúan.
Cirugía
Indicaciones
♦ Complicaciones agudas a pesar de un tratamiento conservador adecuado (megacolon tóxico,

Figura 39. Megacolon tóxico. El colon transverso y el colon descendente carecen de rasgos distintivos, con pérdida de las marcas haustrales. El colon transverso está dilatado hasta un diámetro > 6 cm y son visibles algunos pseudopólipos.
perforación, sepsis, hemorragia incontrolada)
♦ Recaídas graves, dependencia a largo plazo de esteroides, deterioro del estado general del paciente
Procedimiento → proctocolectomía con anastomosis bolsa ileal-anal (bolsa J)
Megacolon tóxico
Reposo intestinal completo: NPO
Inserción de sonda nasogástrica
Líquidos intravenosos
Antibióticos intravenosos de amplio espectro (ampicilina, gentamicina y metronidazol)
Evite todos los medicamentos anticolinérgicos o narcóticos
Esteroides intravenosos (hidrocortisona, dexametasona)
Cirugía → no hay respuesta al tratamiento médico en un plazo de 24 a 72 horas
Factores desencadenantes para megacolon tóxico → estudios baritados, colonoscopia, uso excesivo de opioides o anticolinérgicos, hipopotasemia. Los corticosteroides sistémicos solo deben usarse para el tratamiento de un brote activo y no se recomiendan como medicamento de mantenimiento para la colitis ulcerosa.
La enfermedad de Crohn (EC) forma parte de la enfermedad inflamatoria intestinal (EII) caracterizada por una inflamación transmural que afecta a cualquier región del tracto gastrointestinal desde la boca hasta el área perianal. Definición
↑Etnia caucásica (norte de Europa), judía
Sexo: ♂ = ♀
Edad típica de aparición: distribución bimodal con un pico a los 15-35 años y otro a los 55-70 años
Predisposición genética → HLA DR5, HLA B 27, Mutación del gen NOD2
Antecedentes familiares de enfermedad inflamatoria intestinal Tabaquismo activo y pasivo

El tabaco (fumador) es factor protector para colitis ulcerosa (= preeclampsia) y factor de riesgo para enfermedad de Crohn.

Síntomas constitucionales 1
♦ Fiebre
♦ Pérdida de peso
♦ Fatiga
Síntomas intestinales
♦ Diarrea crónica, por lo general, no sanguinolenta
♦ Dolor abdominal
♦ Malabsorción
♦ Masa abdominal palpable en fosa iliaca derecha
♦ Enfermedad perianal → fístulas y abscesos 2
Síntomas extraintestinales
♦ Articulares (más común) 3
– Artritis periférica → colitis dependiente
– Espondilitis → asociado a HLA B 27 y colitis independiente
♦ Ocular → uveítis anterior asociado a HLA B 27 y colitis dependiente, epiescleritis
♦ Biliar → colelitiasis
♦ Cutáneo → eritema nodoso (nódulos subcutáneos rojo violáceos, calientes, dolorosos, de localización pretibial)
♦ Hematológica → anemia megaloblástica
♦ Renal → litiasis de oxalato de calcio

↑ VSG, ↑ PCR, leucocitosis
(ENARM 2004)
(ENARM 2004)
(ENARM 2015)

Figura 42. Masa abdominal secundaria a enfermedad de Crohn. Se puede ver una gran masa, con eritema de la piel suprayacente, en el cuadrante inferior derecho del abdomen.

ASCA positivo (anti-Saccharomyces cerevisiae)
Colonoscopía → hallazgos histopatológicos
♦ Zona más afectada ileocecal 4
♦ Afectación discontinua (parches o segmentario)
♦ Afectación transmural 5
La mayoría de los casos de eritema nodoso son idiopáticos, pero pueden estar asociados con infecciones (tuberculosis) y trastornos autoinmunitarios (EII).
El curso clínico más común de la enfermedad de Crohn es la forma diarreica clásica.
♦ Formación de granulomas sin caseum y úlceras aftosas (aspecto en “empedrado”) 6 Metaplasia de glándulas pilóricas 4 (ENARM 2004) 5 (ENARM 2004) 6 (ENARM 2004) (ENAM 2016)

que muestra ulceraciones lineales y serpiginosas.

Producen granulomas no caseificantes, sarcoidosis, pleuritis reumatoide y beriliosis, a parte de la enfermedad de Crohn
Variable Parámetro a Cuantificar para el Cálculo del CDAI Factor
1 Número de deposiciones líquidas o blandas al día x02
2 Dolor abdominal: O = ausente; 1 = leve; 2 = moderado; 3 = severo x05
3
Bienestar general: O = Bien; 1 = Regular, 2 = Mal; 3 = Muy mal; 4 = Terrible. x07
Presencia de:
- Artritis/Artralgias
- Iritis/Uveítis
4
- Eritema nodoso, pioderma gangrenoso, estomatitis aftosa
- Fisura, fístula o absceso anal
- Otra fístula
- Fiebre > de 37,8° C durante la semana previa. x20
5 Necesidad de Difenoxilato o loperamida : 0 = no; 1 = si x30
6 Masa abdominal: O = no; 2 = cuestionable; 5 = definitivo. x10
7 Hematocrito (Hto): Hombres = 47- Hto: Mujeres = 42- Hto x06
8 Peso corporal: (1-peso/peso ideal) x01
Crohn Disease Activity Index (CDAI, por sus siglas en inglés). Tras la suma de los 8 variables, se obtendrá una puntuación que corresponderá a la actividad de la enfermedad en cada paciente, la cual se interpretará asf: CDAI < 150 - Remision, CDAI de 150 a 219 - actividad love; CDAI de 220 a 450Actividad moderada; CDAI > 450 - Actividad severa.
Estenosis → obstrucción intestinal
Fístulas y abscesos intestinales 1
♦ Por lo general, afectan el íleon terminal y / o la región perianal.
Colitis fulminante: inflamación severa que causa típicamente > 10 deposiciones por día, sangrado gastrointestinal, dolor y distensión abdominal
↑ Riesgo de cáncer colorrectal (pancolitis) y de intestino delgado
↑ Riesgo de linfoma no Hodkin
Amiloidosis secundaria
Modificaciones de estilo de vida
Dejar de fumar
Evitar ciertos medicamentos (AINES)
Minimizar el estrés
Médico → brotes agudos
Derivados del ácido 5-aminosalicílico (5-ASA) → Tiene poca eficacia
Corticosteroides tópicos → Budesonida
Corticosteroides sistémicos solo si no hay respuesta
♦ VO: prednisona
♦ EV: Metilprednisolona
Análogos de tiopurina → Azatioprina, 6- Mercaptopurina
Terapia anti-TNF (adalimumab o infliximab)
Natalizumab (antagonista del receptor de integrina)
Para el mantenimiento de la remisión, considere el uso de metotrexate, azatioprina o medicamentos anti-TNF, si los síntomas continúan.
Cirugía
Indicaciones
♦ Cuando la terapia médica falla o el paciente desarrolla complicaciones graves (obstrucción 1 , estenosis, absceso)
Procedimiento
♦ Dilatación con balón: para tratar la estenosis intestinal
♦ Drenaje percutáneo: previene la retención de secreciones y abscesos
♦ Drenaje quirúrgico: cuando falla la aplicación del drenaje percutáneo
♦ Resección limitada (proctocolectomía): en caso de obstrucciones o estenosis
Fistulas perianales
♦ Ciprofloxacino o metronidazol (terapia de primera línea)
♦ Azatioprina 2-3 mg / kg / día o 6-mercaptopurina 1-1.5 mg / kg / día
♦ Terapia biológica → anti-TNF
Los corticosteroides no deben usarse para la terapia de mantenimiento a largo plazo, tanto en enfermedad de Crohn como en la colitis ulcerosa.
Se ha demostrado que la 5-ASA / sulfasalazina es ineficaz en brotes agudos y en la terapia de mantenimiento de la enfermedad de Crohn.


La dispepsia es una afección común, definida como dolor o ardor predominantemente epigástrico que dura al menos un mes.
Ocurre en al menos el 20 % de la población.
↑ prevalente en mujeres, fumadores y personas que toman AINES
Dispepsia funcional (75 % casos) → + común, idiopática (no ulcerosa) 1
♦ Diagnóstico de exclusión

Dispepsia orgánica (25 % casos) → tiene una patología orgánica subyacente
♦ Enfermedad de úlcera péptica → causa benigna + frecuente
♦ Enfermedad por reflujo gastroesofágico
♦ Los medicamentos (AINES → más común)
♦ Cáncer gástrico (adenocarcinoma) → causa maligna + frecuente
♦ Dolor biliar
1 (ENAM EXTRA 2021)
♦ Pancreatitis agua
♦ Alteraciones metabólicas (hipercalcemia, hiperpotasemia)
♦ Carcinoma hepatocelular
♦ Trastornos sistémicos (diabetes mellitus, trastornos tiroideos y paratiroideos, enfermedad del tejido conectivo)
1 (ENAM EXTRA 2021) 2 (ENARM 2019) 3 (ENAM EXTRA 2021)
La historia clínica, el examen físico y el laboratorio son los primeros pasos en la evaluación de un paciente con una nueva aparición de dispepsia. El objetivo de la evaluación inicial es identificar los síntomas de alarma que orienten a una neoplasia maligna gastroesofágica.
♦ Pérdida de peso involuntaria (> 5 % en 6 meses/ > 10 % en 12 meses)
♦ Disfagia
♦ Odinofagia
♦ Anemia ferropénica
♦ Vómitos persistentes
♦ Masa palpable o linfadenopatía
♦ Antecedentes familiares de cáncer gastrointestinal superior
Endoscopia digestiva alta
♦ Paciente ≥ 60 años con historia de dispepsia
♦ Paciente < 60 años con algún síntoma de alarma o hemorragia digestiva
Dispepsia funcional (idiopática o no ulcerosa)
Criterios de Roma IV
♦ Cualquiera de los siguientes síntomas experimentó al menos 3 días a la semana durante los últimos 3 meses
♦ Ardor epigástrico 1
♦ Dolor epigástrico
♦ Saciedad precoz
♦ Plenitud posprandial (síntoma + intenso)
♦ Interferencia con las actividades diarias
♦ Duración de los síntomas ≥ 6 meses 2
♦ Ausencia de enfermedad estructural (incluyendo en la endoscopia superior) para explicar los síntomas 3
Dispepsia funcional (Idiopática o no ulcerosa)
1 (ENARM 2021)
Tratamiento de primera línea → inhibidores de la bomba de protones durante 8 semanas en dosis estándar 1
Tratamiento de segunda línea → antidepresivos tricíclicos (amitriptilina)
Tratamiento de tercera línea → procinéticos (metoclopramida)
Terapia psicológica (terapia cognitivo-conductual)
Defecto de la mucosa gástrica o duodenal con un diámetro de al menos 5 mm (0.5 cm) y una profundidad que alcanza la muscularis mucosa. Definición
Epidemiología
Afecta al 10-12 % de la población a lo largo de su vida.
Sexo: ♂ = ♀
Frecuencia: úlcera duodenal > úlcera gástrica
Pico de incidencia: 55-65 años (edad más avanzada en la gástrica)
Las úlceras duodenales ocurren, en promedio, 10 a 20 años antes que las gástricas,
Etiología
U. duodenal → estados hipersecretores de ácido
95 % H. Pylori (+ frecuente) 1
5 % AINES
Las lesiones más superficiales se denominan erosiones, que no sobrepasan la muscularis mucosae. DATITO

<1 % otras → gastrinomas (células no beta) → síndrome Zolinger Ellison 2
U. gástrica → estados hiposecretores de ácido (→ barrera protectora)
70 % H. Pylori 3
25 % AINES → ketorolaco, piroxicam (+ gastrolesivos) 4
5 % Adenocarcinoma gástrico
El gastrinoma se asocia a úlceras múltiples en el duodeno, principalmente, + diarrea secretora. (ENARM 2017) DATITO

A menudo, existen factores de riesgo adicionales presentes que aumentan la probabilidad de desarrollar una úlcera, p.ej.:
Tabaquismo y consumo excesivo de alcohol
Glucocorticoides 5
Cafeína
Dieta → una alta ingesta de frutas, verduras, fibra y vitamina A puede proteger contra el desarrollo de UP
Factores psicológicos (ansiedad, estrés, trastorno de estrés postraumático)
Factores genéticos
Figura 49.
Los dos principales factores que contribuyen al desarrollo de la úlcera péptica son la infección gastrointestinal con H. pylori y el uso de AINES.
Otras causas menos frecuentes de úlcera péptica son:
Hipersecreción gástrica 6
Gastrinoma
Mastocitosis
Hiperparatiroidismo
Hiperplasia de células G antrales
Infecciones virales: VHS, CMV
Obstrucción duodenal
Radiación
Quimioterapia (5-fluorouracilo)
Otros fármacos (bifosfonatos, ISRS, micofenolato)
Uso de drogas ilícitas (cocaína, metanfetamina)
5 (ENARM 2010)
6 (ENARM 2010)
Toda úlcera gástrica se biopsia y se confirma su cicatrización, ya que está asociado a cáncer gástrico (ENARM 2003).
1 (ENAM 2016)
Generalmente, ubicada en la pared anterior o posterior del bulbo duodenal (primera porción del duodeno) → 90 % casos 1
Miden > 2 cm → úlceras gigantes asociado a complicaciones


En las úlceras duodenales múltiples postbulbares se debe descartar gastrinoma.
Úlcera gástrica
Típicamente, ubicada a lo largo de la curvatura menor en la porción de transición entre el cuerpo y el antro (incisura angularis)
Mide > 3 cm → úlceras gigantes localizadas en el fondo → asociado a malignidad (adenocarcinoma)
CLASIFICACIÓN DE JOHNSON → ÚLCERA GÁSTRICA
Grado I: úlcera de localización en la curvatura menor
♦ Relacionada con una secreción de ácido normal
♦ Constituye del 50 al 60 % de las úlceras gástricas (+ frecuente)
Grado II: úlcera de localización gástrica y duodenal 2
♦ Relacionada con una ↑↑ secreción de ácido
♦ Constituye el 20 % de las úlceras gástricas
Grado III: úlcera de localización prepilórica (antro)
♦ Relacionada con una ↑↑ secreción de ácido
♦ Constituye el 20 % de las úlceras gástricas
Grado IV: úlcera en el fondo gástrico o alta de la curvatura menor 3
♦ Úlceras con una frecuencia igual o menor al 10 %
Grado V: úlceras múltiples asociadas al uso prolongado de AINEs
♦ Úlcera con alto riesgo de perforación y hemorragia
♦ Habitualmente, asintomática
2 (ENARM 2015)
3 (ESSALUD 2022)


H. pylori → úlceras duodenales → ↑ factores agresivos (ácido, pepsina) ↑ secreción gastrina y ↓ somatostatina →↑ secreción ácida → afecta la mucosa del duodeno
H. pylori → úlceras gástricas → ↓ factores defensivos (moco, bicarbonato)
H. pylori secreta ureasa (principal factor de virulencia) → conversión de urea en NH 3 → alcalinización del ambiente ácido → supervivencia de bacterias en la luz gástrica
Colonización bacteriana y unión a células epiteliales → liberación de citotoxinas (Toxina cagA) → ruptura de la barrera mucosa y daño a las células subyacentes
Aines
Inhibir COX-1 y COX-2 → disminución de prostaglandinas → erosión de la mucosa gástrica ↓ el flujo sanguíneo de las mucosas.
Inhibir la proliferación de células de la mucosa.
Hipersecreción ácida:
Hipersecreción de ácido (síndrome de Zollinger-Ellison) y aumento de la producción de gastrina → ↑ secreción de H + y masa de células parietales → entrega de ácido excesivo al duodeno.
Daño agudo de la mucosa gástrica resultante de la disminución del flujo sanguíneo 1 Úlceras de Curling → grandes quemados
♦ Disminución del volumen plasmático → disminución del flujo sanguíneo gástrico → lesión del tejido hipóxico del epitelio de la superficie del estómago→ debilitamiento de la barrera mucosa normal Úlceras de Cushing → politraumatizados (TEC)
♦ Lesión cerebral → aumento de la estimulación vagal → aumento de la producción de ácido estomacal a través de la liberación de acetilcolina
1 (ENARM 2009)
Hasta el 70 % de los pacientes con úlceras pépticas son asintomáticos.
Los pacientes que toman AINES tienen más probabilidades de tener úlceras asintomáticas y presentar complicaciones de la úlcera péptica (hemorragia).
Dolor abdominal
♦ El síntoma más común
♦ Comúnmente ubicado en el epigastrio (dispepsia ulcerosa)
♦ Tipo ardor, ↑ ayuno, ↓ ingesta de alimentos → U. duodenal
♦ Tipo opresivo, ↑ ingesta de alimentos → U. gástrica
♦ Nocturno (no respeta el sueño) → principalmente, en U. duodenal (dispepsia orgánica)
Náuseas y / o vómitos
Distensión / plenitud abdominal
DUODENAL
GÁSTRICA
Frecuencia +++ +
Edad 35 – 45 50 – 60
Herencia Grupo O Grupo A
Hábitos Alcohol, tabaco Fármacos (AINES)
Dolor Urente Mal definido
Cronología Ayuna empeora, la comida lo alivia La comida despierta el dolor
Tabla 05. Diferencias entre úlcera duodenal y gástrica
El dolor nocturno es uno de los síntomas más discriminativos y más frecuentes para diferenciar la dispepsia funcional de la orgánica (úlcera péptica).
Endoscopia digestiva alta → la prueba más precisa para confirmar el diagnóstico.
♦ Paciente ≥ 60 años con historia de dispepsia
♦ Paciente < 60 años con algún síntoma de alarma o hemorragia digestiva
♦ Prueba de detección de malignidad → toma de biopsias
♦ Se recomiendan biopsias en la mayoría de los casos de úlcera gástrica 1
♦ Obtenga biopsias de úlceras duodenales con características endoscópicas que sugieran malignidad 2
♦ Pruebas directas para H. pylori (ureasa, histología, cultivo) 1 (ENARM 2003) 2 (ENARM 2003)
Las úlceras duodenales suelen ser benignas y no requieren biopsia de rutina.
Medidas no farmacológicas: p.ej., evitar los AINES, restringir el consumo de alcohol y tabaco
Farmacoterapia
♦ IBP (omeprazol)
♦ Citoprotectores (sucralfato) → forma un polímero pegajoso que se adhiere a las células epiteliales y base de las úlceras 1
♦ Antibióticos (erradicar H. pylori)
Cirugía → indicaciones
♦ Síntomas refractarios o recurrencia de la enfermedad a pesar del tratamiento médico adecuado
♦ Enfermedades que requieren la continuación de los
Hemorragia digestiva alta
La complicación más frecuente de la úlcera péptica 1
(ENARM 2021)
♦ Incapacidad para tolerar el tratamiento médico.
♦ Ante complicaciones → hemorragia masiva y refractaria, perforación libre
Procedimientos
♦ Vagotomía + técnicas de drenaje (piloroplastía) → U. duodenal
♦ Gastrectomía parcial (Billroth) y reconstrucción → U. gástrica
♦ Gastrectomía total y reconstrucción en Y de Roux →U. gástrica
Potencialmente mortal, sobre todo en adultos mayores (primera causa de muerte) 2
Principal indicación de cirugía
Las úlceras duodenales posteriores tienen más probabilidades de sangrar que las úlceras anteriores.
Las úlceras gástricas → causan sangrado por la arteria gástrica izquierda.
Las úlceras duodenales → causan sangrado por la arteria gastroduodenal.
Clínica → Hematemesis y melena (anemia ferropénica cuando es sangrado crónico)
Tratamiento → NPO, reanimación volumétrica, transfusión, IBP, endoscopia, cirugía (hemorragia masiva y refractaria)
Perforación
La segunda complicación más común de la úlcera péptica.
Las úlceras gástricas prepilóricas → son la causa más común de perforación.
Las úlceras duodenales de la pared anterior tienen más probabilidades de perforarse que las úlceras de la pared posterior 3
Clínica → dolor súbito, severo y rigidez abdominal (rebote +) repentinos y difusos 4 , signo Jobert + (desaparición de matidez hepática) 5
Confirma → radiografía simple toraco-abdominal en bipedestación 6

→
2 (ENAM 2010)
4 (ENAM 2015) (ENARM 2017, 2015, 2014, 2018)
(ENARM 2012) 3 (ENARM 2007) 5 (ESSALUD 2010) (ENAM 2015) 6 (ENAM 2011) (ENARM 2017) (ENARM 2015) (ENARM 2014) (ENARM 2007)
DATITO
Los IBP son el tratamiento de elección en patología ácido péptica (ERGE, gastritis, úlcera péptica) (ENARM 2021)
Signos de neumoperitoneo:
♦ Signo de Popper
♦ Singo de alas de gaviota
♦ Observación del ligamento falciforme (el aire libre puede delinear el ligamento falciforme)
Tratamiento → cirugía de emergencia
♦ Parche de Graham: reparación quirúrgica de una úlcera duodenal perforada pequeña (generalmente, <5 mm), utilizando un trozo de epiplón para cerrar la perforación

Penetración de una úlcera péptica a través de la pared gástrica o duodenal
U. gástrica → hacia hígado o colon
U. duodenal → hacia páncreas 7
Las úlceras duodenales posteriores tienen más probabilidades de penetrarse que las úlceras anteriores.
Clínica: dispepsia constante no alivia con antiácidos, irradia espalda. Eleva amilasa.
Tratamiento → manejo conservador (médico)
Obstrucción mecánica del conducto pilórico o duodeno
Complicación más rara de la úlcera péptica
Clínica → vómitos posprandiales que no son biliares, saciedad precoz
Tratamiento → succión nasogástrica, reposición de electrolitos y líquidos y nutrición parenteral, dilatación endoscópica (70 % casos), casos refractarios → cirugía (30 % casos)
7 (ENARM 2010)

Figura 56. Las principales complicaciones de la úlcera péptica son: hemorragia (A), perforación (B), penetración (C) y (ENARM 2013)
Bacilo curvo, con forma de “S”, flagelado, gramnegativo y microaerófilo 1
1 (ENARM 2004)
Reservorio: mucosa gástrica (sobre todo, predilección por antro). También puede encontrarse en mucosa duodenal, principalmente si hay metaplasia gástrica.

Figura 57. Helicobacter pylori. Bacteria en forma de espiral con una longitud de 3 μm y flagelos.
Transmisión → mecanismo fecal – oral (alimentos o agua contaminada)
El 50 – 60 % de la población está infectada.
Los humanos son los huéspedes predominantes.
bacterianos
Estructura
Adhesinas
Porinas
Enzimas (ureasa, vac A, cag A, etc.)
Factores del hospedador
Duración
Localización
Respuesta inflamatoria ¿Genéticos?
Gastritis crónica Úlcera péptica
Neoplasia MALT gástrica
Cáncer de estómago
Figura 58. Factores patogénicos en la infección por Helicobacter pylori.
Relacionado con bajo nivel socioeconómico. El H. pylori es la infección bacteriana crónica más común en los seres humanos.
Actividad UREASA positiva (principal factor de virulencia) 1
♦ Enzima que convierte la urea en amoníaco y dióxido de carbono, lo que produce un aumento del pH.
♦ La formación de amoniaco aumenta el pH y permite la supervivencia en el ambiente ácido del intestino.
Catalasa y oxidasa positivo
El gen CagA
♦ Se asocia a una citotoxina, incrementa el riesgo de que la infección se asocie a úlcera o a cáncer (es el factor citotóxico más importante)
♦ Induce inflamación por la secreción a la IL8
Gen vacA:
♦ Codifica la proteína vacuolizante.
La ureasa también se encuentra en Proteus sp, asociado a cálculos renales de estruvita (fosfatomagnesio-amonio).
1 (ENARM 2006, 2004
Helicobacter Pylory
Ureasa
HIDRÓLISIS
ÚREA

• Daño celular directo
• Retrodifunción de iones H
• Inactiva el complemento
La mayoría cursa de forma asintomática. Está asociado con las siguientes patologías:
♦ Gastritis aguda
♦ Gastritis crónica activa (tipo B)
♦ Gastritis crónica atrófica multifocal 1
♦ Úlcera péptica (duodenal > gástrica)
♦ Adenocarcinoma gástrico 2
♦ Linfoma gástrico (MALT) 3
♦ Linfoma NO Hodkin de bajo grado Enfermedades extradigestivas:
♦ PTI refractario a corticoides
♦ Anemia ferropénica refractaria a suplemento
Ph
de
1 (ENARM 2004) 2 (ENARM 2004) 3 (ENARM 2007)

La causa más frecuente de gastritis aguda son los AINES y de la gastritis crónica, es la infección por Helicobacter pylori.
La gastritis atrófica más frecuente producida por H. pylori es de la región antral, pero la gastritis del cuerpo gástrico se asocia más, en su evolución, a adenocarcinoma gástrico (ENAM 2010)
4 (ENAM 2010) 5 (ENARM 2016) 6 (ENARM 2006)
PRUEBAS DIRECTAS → endoscopía + biopsia → confirman el diagnóstico
Test de ureasa → prueba confirmatoria 4
♦ La sensibilidad y especificidad de la prueba es de aproximadamente el 90 % y el 95 %, respectivamente.
Histología (tinción Giemsa) → prueba de oro (Gold estándar)
♦ Las biopsias para histología deben tomarse tanto del antro como del cuerpo del estómago.
♦ La sensibilidad y especificidad de la histología para el diagnóstico de la infección por H. pylori son del 95 % y el 98 %, respectivamente.
Cultivo → ↑ especificidad → si hay sospecha de cepas resistentes a los antibióticos.
PRUEBAS INDIRECTAS → sirven para monitorizar el Tratamiento.
Test de aliento → principalmente, sirve para monitorizar el tratamiento, es decir, confirma si hay erradicación con la terapia 5
♦ La sensibilidad aumenta si se suspenden los IBP durante al menos 2 semanas antes de la prueba.
Serología → no sirve en la práctica clínica por su ↓ sensibilidad y especificidad 6
♦ Sirve para estudios epidemiológicos.
Antígeno en heces → alternativa al test de aliento.

Tratamiento 1 (ENARM 2009) 2 (ENARM 2009) 3 (ENARM 2009)
Terapia de erradicación de Helicobacter pylori 1
Triple terapia (aprobado por FDA)
Un régimen común de elección es de 10 a 14 días de 3 medicamentos dos veces al día: un IBP (omeprazol 20 mg /12 horas), claritromicina 500 mg /12 horas y amoxicilina 1gr /12 horas 2
Un régimen común de elección es de 10 a 14 días de 4 medicamentos: un IBP (omeprazol 20 mg /12 horas), bismuto, tetraciclina 500 mg/6 horas y metronidazol 500 mg mg/6 horas 3
Posterior al tratamiento
Confirme que el H. pylori se haya erradicado 4-6 semanas después de completar el régimen de tratamiento.
Modalidades preferidas: test de aliento
Método diagnóstico S (%) E (%)
Métodos directos
Test ureasa 85-95 95-100
Histología 85-95 95-100
Cultivo 75-90 100
Métodos indirectos
Serología 85-95 85-95
Test de Aliento 90-100 >95
Antígeno en heces 90-100 90-100
Opciones de primera línea para el tratamiento de erradicación de H. pylori
Triple terapia con claritromicina
Preferida en áreas con niveles bajos (<15%) de resistencia a claritromicina
Terapia cuádruple de bismuto
Se prefiere en áreas con niveles altos (≥ 15% ) de resistencia a claritromicina.
IBP en dosis estándar o doble dos veces al día (omeprazol)
MÁS claritromicina
MÁS amoxicilina
IBP en dosis estándar dos veces al día (omeprazol)
MÁS bismuto
MÁS tetraciclina
MÁS metronidazol


1 (ENARM 2002)
Sangrado proveniente del tracto gastrointestinal desde la boca hasta el duodeno, a la altura del ligamento de Treitz (ligamento suspensorio del duodeno) 1
Enfermedad por úlcera péptica (causa + frecuente) 1
♦ Úlcera duodenal más frecuente 2
♦ Úlcera gástrica más grave (peor pronóstico)
♦ Antecedentes de infección por Helicobacter pylori (H. pylori)
♦ Uso de antiinflamatorios no esteroideos (AINE) 3
Esofagitis → Complicación de ERGE
Gastritis erosiva → producida principalmente por AINES (ketorolaco, piroxicam, indometacina) 4
Varices esofágicas / gástricas → pacientes con cirrosis que presentan hipertensión portal 5
♦ Sangrados masivos y bruscos (↑↑ mortalidad: 20 % casos)
♦ Várices gastro-esofágicas más frecuentes → cirrosis (HTP) 5
♦ Varices gástricas más raras → trombosis de la vena esplénica
Lesión de Dieulafoy → malformación vascular, sobre todo de la arteria gástrica izquierda 7
Cáncer de estómago (adenocarcinoma) / cáncer de esófago
Síndrome de Mallory-Weiss → pacientes con vómitos severos → laceración de la línea Z (unión gastroesofágica) 8
Síndrome de Boerhaave → ruptura total (transmural) de esófago proximal
Después de una cirugía abierta o endoscópica

1 (ENARM 2015) (ENARM 2014)
2 (ENARM 2002)
3 (ENARM 2002) (ENARM 2023)
4 (ENARM 2002) (ENAM 2010)
5 (ENARM 2002) (ENAM 2010)
6 (ENAM 2016)
7 (ESSALUD 2012)
2 (ENARM 2016, 2002) (ENAM EXTRA 2022) (ESSALUD 2022)
DIAGNÓSTICO FRECUENCIA ÚLCERA PÉPTICA 35 – 50 %
GD 8 – 15 %
Hematemesis: vómitos de sangre, que puede ser de color rojo (sangrado activo) o café (sangrado reciente) → 40 a 50 % de los casos 1
Melena: heces negruzcas, pegajosas de mal olor (color brea) → 90 a 98 % los casos 2
♦ Sangrado permanece en tracto digestivo > 14 horas
Los síntomas que acompañan a estos signos varían dependiendo de la causa subyacente:
♦ Úlcera péptica → dolor en epigastrio 3
♦ Úlcera esofágica → odinofagia, reflujo gastroesofágico, disfagia
♦ Síndrome de Mallory-Weiss → vómitos intensos, tos previa al sangrado
♦ Hemorragia variceal → ictericia, ascitis, circulación colateral, esplenomegalia 4 (espacio de Traube ocupado) 5
♦ Neoplasia maligna → disfagia, llenura precoz, pérdida involuntaria de peso, caquexia
Evaluación del estado hemodinámico: nivel de gravedad
♦ LEVE: presión y frecuencia cardiaca normal, test Tilt negativo, pérdida volemia de 10 % (500 ml).
♦ MODERADO: PA > 100 mmhg, FC: 100 lat/min, test Tilt positivo, pérdida volemia de 10 - 20% (500 - 1000 ml). 6
♦ GRAVE: PAS < 100 mmhg, FC > 100 - 120 lat/min, shock, pérdida volemia de 2035% (1000 - 1750 ml).
♦ MASIVA: PAS < 60 mmhg, FC > 120 lat/min, estupor, pérdida volemia > 35 % (>1750 ml).
Hemograma → hemoglobina y recuento de plaquetas
♦ VCM bajo (microcitosis) → indica una pérdida crónica de sangre y anemia por deficiencia de hierro, VCM normal (normocítica)→ se presenta en sangrado agudo
Cociente: ↑ BUN / creatinina (> 30: 1) o ↑urea/creatinina (> 100: 1)
Endoscopia digestiva alta (pacientes hemodinámicamente estables) 7
♦ Solicitar entre las 6 a 24 horas
♦ Paciente en shock, realizarlas dentro de las 12 horas (previa resucitación hemodinámica)


1 (ENARM 2002, 2023) (ENAM EXTRA 2022)
2 (ENARM 2023) (ENAM EXTRA 2022) 3 (ENAM EXTRA 2020)

Para producirse melena la pérdida de sangre en el tubo digestivo alto debe ser más de 60 - 80 ml y debe permanecer 14 hrs en el tracto digestivo para oxidar la hemoglobina. DATITO
El test Tilt es una prueba con la camilla basculante, donde se evalúa el cambio de presión arterial en decúbito y posición sentada. Es positivo cuando cambia el valor de presión arterial (disminuye al sentarse).
Ante pacientes hemodinámicamente inestables (hipotensión) la primera conducta es la resucitación hemodinámica (reponer el volumen arterial efectivo).
2018)
EXTRA 2020)
Los factores asociados a resangrado (principal factor pronóstico de mortalidad) son:
Inestabilidad hemodinámica (presión arterial sistólica < 100 mmHg, frecuencia cardiaca > 100 latidos por minuto)
Hemoglobina < 10 g / L
Sangrado activo en el momento de la endoscopia
Tamaño grande de la úlcera (mayor de 1 a 3 cm en varios estudios)
Ubicación de la úlcera (bulbo duodenal posterior o curvatura gástrica menor alta)
Índice de Glasgow – Blatchford (evaluación preendoscópica)
Permite estimar la probabilidad de resangrado, la necesidad de control hemostático urgente (endoscopía) y la mortalidad.
Puntaje 0 – 1 punto → sugerimos que el médico tratante indique el alta sin necesidad de realizar una endoscopía.
Puntaje ≥ 2 puntos → serán evaluados por el especialista gastroenterólogo para la realización de una endoscopía urgente.
III: INACTIVO (ENARM 2002, 2023) III Úlcera de base plana (Fibrina) < 5%
Clasificación de Forrest (evaluación endoscópica)
Se usa comúnmente para determinar la necesidad de intervenciones hemostáticas durante el procedimiento y puede ayudar a guiar la disposición al predecir el riesgo de resangrado.
Alto riesgo de resangrado: IA – IB – IIA – IIB → por lo general , requieren atención hospitalaria 1
Bajo riesgo de resangrado: IIC – III → generalmente, se puede tratar como pacientes ambulatorios 2
Score de Rockall (evaluación postendoscópica)
3 variables clínicas (edad, estado circulatorio, comorbilidades)
2 variables endoscópicas (diagnóstico, estigma de sangrado reciente)
Puntaje ≤ 2: pensar en dar alta precoz
Puntaje > 2: hospitalizar 1 (ESSALUD 2015) 2 (ENARM 2002)


Reponer la volemia → pacientes inestables (hipotensión arterial o sensorio alterado) 1
Los pacientes deben tener un mínimo de dos catéteres de acceso periférico de gran calibre (al menos calibre 16-18).
Se deben administrar cristaloides por vía intravenosa → NaCl 0.9 % 10 a 20 ml/Kg (500 a 1000 ml por bolo) 2
Transfusión de paquete globular
♦ Hemoglobina < 7 gr/dl → todos los pacientes (2 unidades)
Manejo del control de sangrado (específico)
HDA NO VARICEAL (úlcera péptica)
Farmacoterapia:
♦ Sugerimos que antes de la realización de la endoscopía digestiva alta se brinde omeprazol IV 80mg en bolo seguido de 40mg cada 12 horas o infusión de 8mg/hora. 4
Terapia endoscópica:
♦ Forrest IA-IB-IIA (Forrest IIb, en los que al retirar el coágulo hayan presentado sangrado) → inyectoterapia (epinefrina), termoterapia (coagulación) o mecanoterapia (clips). 5
♦ Recomendamos usar terapia dual (es decir, adrenalina junto con una terapia térmica o mecánica), en vez de usar monoterapia con adrenalina.
♦ Si un paciente tiene una úlcera Forrest IIC – III (Forrest IIb, en los que al retirar el coágulo no hayan presentado sangrado): no amerita manejo endoscópico ni endovenoso.
Terapia en casos refractarios:
♦ En pacientes con HDA no variceal en los que el sangrado no puede controlarse endoscópicamente, realizar terapia por radiología intervencionista (embolización) o cirugía.
♦ Hemoglobina < 9 gr/dl → pacientes de alto riesgo: enfermedad coronaria (cardiopatía isquémica), accidente cerebrovascular, ataque isquémico transitorio, o enfermedad vascular periférica (2 a 4 unidades)
Transfusión de plaquetas
♦ Cuando el paciente está tomando aspirina
♦ Recuento de plaquetas < 50 mil
Transfusión de plasma fresco congelado
♦ Alteración del perfil de coagulación (↑ TP y ↑ TPTa)
Transfusión de sangre total 3
♦ Cuando la hemorragia digestiva es masiva
Ante paciente con hemorragia, en general, inestable hemodinámicamente (hipotensión), la primera conducta es reponer la volemia (resucitación hemodinámica) (ENAM 2014).

(ENARM

Administración IV de IBP + tratamiento endoscópico


Administración IV de IBP +/tratamiento endoscópico


I - II a II b II c III

No se administra IBP IV ni se efectúa tratamiento endoscópico
67. Manejo específico de la úlcera péptica.


No se administra IBP por vía IV ni tratamiento endoscópico
(várices gastro-esofágicas)
Farmacoterapia
♦ Administrar octreótide (un análogo de la somatostatina) 0.2 mg/ml IV en bolo de 50 microgramos seguido de infusión de 50 microgramos/hora durante 5 días 1
♦ También se puede usar terlipresina (análogo de vasopresina)
♦ Profilaxis antibiótica → prevenir infecciones (peritonitis bacteriana espontanea, infección del tracto urinario, neumonía) – Ciprofloxacino IV 200mg cada 12 horas por 7 días
Terapia endoscópica (+ importante)
♦ Primera opción → ligadura con bandas elásticas 2
♦ Segunda opción → escleroterapia
♦ En pacientes con HDA de várices esofágicas en los cuales no se puede controlar el sangrado durante la endoscopía, colocar una sonda de Sengstaken – Blakemore o de Minnesota (2 balones), la cual debería ser retirada antes de las 24 horas. 3
Terapia en casos refractarios:
♦ Si luego de colocar la sonda el sangrado persiste, realizar TIPS o cirugía, de acuerdo con disponibilidad de equipos y personal.
1 (ENAM 2017, ENAM 2019) 2 (ENAM EXTRA 2021) 3 (ESSALUD 2023)
Linton-Nachlas
Sengstaken-Blakemore
El taponamiento con sondas se puede realizar como medida temporal para pacientes con hemorragia incontrolable debido a várices gastroesofágicas, mediante el uso de varios dispositivos (Sonda de Sengstaken-Blakemore, sonda de Minnesota); la intubación traqueal es necesaria si se va a colocar dicho dispositivo.
Prevención 1 (ENARM 2014)
HDA NO VARICEAL (úlcera péptica)
Erradicar H. pylori → triple terapia
Uso de AINES → usar IBP 1
HDA VARICEAL
Prevención primaria
♦ Várices < 5 mm → betabloqueadores no selectivos (propranolol, nadolol)
♦ Várices > 5 mm o pacientes de alto riesgo de sangrado (cirrosis Child B –C, coagulopatía o várices Paquet grado II) → terapia endoscópica
Prevención secundaria
♦ Betabloqueadores + terapia endoscópica
En pacientes con HDA por várices gástricas (producidas por trombosis de vena esplénica), recomendamos el uso de cianoacrilato en vez de ligadura con bandas elásticas; y en casos refractarios, usar la sonda de Linton (1 balón).
Hemorragia distal al ligamento de Treitz, por lo general, en el colon.
Equivale al 20-30 % de las hemorragias gastrointestinales. Afecta, generalmente, a individuos de edad avanzada y, a menudo, con comorbilidades graves.
Entre el 80 % y el 85 % de las hemorragias digestivas bajas se originan distalmente a la válvula ileocecal (colon).
Su mortalidad es relativamente baja (2-4 %).
Diverticulosis
♦ Causa + frecuente de HDB en adultos > 50 años 1
♦ Sangrado principalmente arterial
♦ Si bien la mayoría de los divertículos están en el colon distal (izquierdo), el 50 % de las hemorragias diverticulares se originan en el colon proximal (derecho).
♦ Pacientes de edad avanzada, en particular mayores de 80 años, pacientes con estreñimiento crónico 2 Sangrado masivo 3 – indoloro – autolimita
♦ Asocia a hernia de hiato y colelitiasis (triada de Saint).
1 (ENARM 2014, 2007, 2000, 2006) (ESSALUD 2014)
2 (ENARM 2007)
3 (ENARM 2007, 2000, 2006) (ESSALUD 2014)

Divertículo sangrante
Ante pacientes hemodinámicamente inestables (hipotensión), la primera conducta es la resucitación hemodinámica (reponer el volumen arterial efectivo).
Figura 69. Los divertículos son las causas más frecuentes de HDB grave en adultos
Angiodisplasia
♦ Sangrado principalmente venoso
♦ Localización → lado derecho (colon ascendente) 4
4 (ENARM 2016)
♦ Asocia a estenosis aórtica (síndrome de Heyde)
♦ Sangrado masivo – indoloro – recidivante
Enfermedad inflamatoria intestinal (EII): colitis ulcerosa y enfermedad de Crohn Diarrea invasiva o inflamatoria: Shigella, Escherichia coli enterohemorrágica.
Hemorroides
♦ Sangrado leve
♦ La causa más común de hemorragias digestivas bajas en pacientes menores de 50 años. Isquemia (colitis isquémica, isquemia mesentérica)
Cáncer colorrectal 5
♦ Sangrado moderado – doloroso 6
♦ Sangrado crónico (anemia ferropénica, thevenon +)
♦ Fisuras anales → causa más frecuente de HDB en población pediátrica 7
♦ Divertículo de Meckel → tejido ectópico gástrico (sangrado indoloro)

Hematoquecia → sangrado rojo vinoso
♦ Más común en HDB (colon)
Rectorragia → sangrado rojo rutilante
Melena: también puede ocurrir en el tracto gastrointestinal inferior cuando se presenta un tránsito intestinal lento.

5 (ENARM 2010)
6 (ENARM 2010)
7 (ESSALUD 2013)
En pacientes jóvenes, las causas más frecuentes de HDB grave son la enfermedad inflamatoria intestinal y las colitis infecciosas; en adultos > 50 años, destaca la hemorragia masiva por divertículo (ENARM 2007) (ENARM 2000) (ENARM 2006) y angiodisplasia.
Sangrados masivos → inestabilidad hemodinámica (hipotensión)
♦ Descartar divertículos o angiodisplasia
Prueba de primera línea: colonoscopia
♦ Angiodisplasias: aspecto similar a las arañas vasculares, vasos ramificándose en estrella, submucosos.

El cáncer colorrectal del lado derecho produce sangrado, mientras que del lado izquierdo genera obstrucción (estenosante). DATITO
Angiografía
♦ Si sangrado es constante → requiere pérdida sanguínea de 0.5 mI/min. Gammagrafía con eritrocitos marcados con Tecnecio 99
♦ Requiere pérdida de sangre de solo 0,1 mI/min, y por ello es más sensible que la arteriografía, aunque menos específica.
♦ Prueba de elección en divertículo de Meckel
Reponer la volemia → pacientes inestables (hipotensión arterial o sensorio alterado)
Los pacientes deben tener un mínimo de dos catéteres de acceso periférico de gran calibre (al menos calibre 16-18).
Se deben administrar cristaloides por vía intravenosa →NaCl 0.9 % 10 a 20 ml/Kg (500 a 1000 ml por bolo)
Transfusión de paquete globular
♦ Hemoglobina < 7 gr/dl → todos los pacientes (2 unidades)
♦ Hemoglobina < 9 gr/dl → pacientes de alto riesgo: enfermedad coronaria (cardiopatía isquémica), accidente cerebrovascular, ataque isquémico transitorio, o enfermedad vascular periférica (2 a 4 unidades)
Manejo del control de sangrado (específico)
Terapia endoscópica (colonoscopía)
♦ Divertículos → sonda bipolar de coagulación, inyección de epinefrina o clips metálicos
♦ Angiodisplasia → terapia térmica (la electrocoagulación, la coagulación con plasma de argón)
Embolización por arteriografía
Cirugía → hemicolectomías
♦ Inestabilidad hemodinámica persistente con sangrado activo
♦ Sangrado recurrente o persistente



PANCREATITIS AGUDA
Definición
Condición inflamatoria del páncreas más comúnmente causada por enfermedad del tracto biliar o abuso de alcohol.
Causa frecuente de abdomen agudo médico 1
La mortalidad varía del 3 % en pacientes con pancreatitis edematosa intersticial (leve) al 17 % en pacientes que desarrollan necrosis pancreática (severa).
La incidencia de pancreatitis aguda es solo del 3 al 7 % en pacientes con cálculos biliares y del 10 % en alcohólicos.
1 (ENARM 2011)

Figura 74. La patología biliar (colelitiasis → coledocolitiasis) es la causa más frecuente de pancreatitis aguda.
Alcoholismo → 20 % de los casos
♦ Lesión directa (citotoxicidad)
♦ Más frecuente en varones.
Idiopático → 25 % de los casos (microcristales vesiculares)
Hipertrigliceridemia severa (>1,000 mg/dl)
Hipercalcemia
Post-CPRE (su principal complicación)
Patología biliar → 40 % de casos → colelitiasis
♦ Causa + frecuente en nuestro medio 1
♦ Cálculos pequeños (< 5 mm) atraviesan el conducto cístico y obstruyen el tercio distal del colédoco (ampolla de Vater)
♦ Más frecuente en mujeres.
1 (ENARM 2014) (ENARM 2005) (ENARM 2020) (ENAM 2013)
DATITO
La parotiditis se complica con meningoencefalitis y pancreatitis aguda.
Pancreatitis inducida por fármacos
♦ Azatioprina y 6 - mercaptopurina
♦ Sulfonamidas y tetraciclinas
♦ Diuréticos de asa y tiazídicos
♦ Valproato
♦ Estrógeno
♦ Inhibidores de la proteasa → didanosina
Picaduras de escorpión
Infecciones virales (paperas → fiebre urleana)
Infecciones parasitarias (Ascaris lumbricoides, Schistosoma Manzoni)
Trauma abdominal cerrado (especialmente, en niños)
Trastornos autoinmunitarios (síndrome de Sjögren)
Úlcera péptica (duodenal) penetrada
Páncreas divisum
Hereditario (mutación del gen PRSS1, fibrosis quística)
En pacientes con pancreatitis aguda a una edad temprana (<35 años) o antecedentes familiares de pancreatitis, se deben realizar pruebas genéticas para pancreatitis hereditaria (PRSS1, SPINK1, CFTR, CTRC, CASR y Claudin-2).
Activación intrapancreática de las enzimas proteolíticas (tripsina, elastasa) y lipolíticas (fosfolipasa)
♦ Secundaria a la obstrucción del flujo de salida del conducto pancreático (cálculos biliares, fibrosis quística) o lesión directa de las células acinares pancreáticas (alcohol, fármacos)
Atracción de células inflamatorias (neutrófilos, macrófagos) → liberación de citocinas inflamatorias
→inflamación pancreática (pancreatitis) → síndrome de respuesta inflamatoria sistémica (falla multiorgánica)

Anatomo-patológica
EDEMATOSA O INTERSTICIAL → Pancreatitis
leve (80 % casos)
♦ La más frecuente
♦ Mínima alteración del órgano
♦ Recuperación sin incidentes
Clasificación de Petrov
NECROHEMORRÁGICA → Pancreatitis severa (20 % casos)
♦ Asociada a fallo multiorgánico
♦ Complicaciones locales: necrosis, pseudoquiste, absceso
♦ LEVE → Se caracteriza por la ausencia tanto de necrosis pancreática como de fallo orgánico (FO).
♦ MODERADA → Se caracteriza por la presencia de necrosis pancreática estéril o FO transitorio (< 48 horas)
♦ GRAVE → Se caracteriza por la presencia de cualquier tipo de necrosis pancreática infectada o FO persistente (> 48 horas)
♦ CRÍTICA → se caracteriza por la presencia de necrosis pancreática infectada y FO persistente (> 48 horas) 1
Clasificación de Atlanta
♦ Pancreatitis aguda leve → se caracteriza por la ausencia de insuficiencia orgánica y complicaciones locales o sistémicas.
♦ Pancreatitis aguda moderadamente grave → se caracteriza por ausencia de insuficiencia orgánica o insuficiencia orgánica transitoria (<48 horas) y / o complicaciones locales.
♦ Pancreatitis aguda grave → se caracteriza por insuficiencia orgánica persistente (> 48 horas) que puede afectar uno o varios órganos.
Dolor epigástrico intenso y constante 1
♦ Irradiación hacia la espalda o dorso (cinturón o faja) 2
♦ Empeora después de las comidas (copiosas) 3 y en decúbito supino
♦ Mejora al inclinarse hacia adelante
Náuseas y vómitos, RHA ausentes
→ íleo paralítico 4
Fiebre
Insuficiencia respiratoria
♦ complicación sistémica + frecuente
♦ derrame pleural izquierda (exudado) y/o SDRA
Necrosis pancreática y/o peripancreática No
Estéril y/o transitoria
Infectada o persistente Infectada y persistente Falla orgánica múltiple No
Signos de shock: taquicardia, hipotensión
Insuficiencia renal: oliguria / anuria
Signos de hemoperitoneo (pancreatitis necrohemorrágica)
♦ Signo de Cullen → equimosis periumbilical 4
♦ Signo de Grey Turner → equimosis en flanco 6
♦ Signo de Fox → equimosis sobre el ligamento inguinal
♦ Signo de Bryant → equimosis escrotal
1 (ENARM 2014, 2007, 2006)
4 (ENARM 2007) (ENAM EXTRA 2021)
2 (ENAM EXTRA 2021) (ENARM 2006, 2013)
Los pacientes con insuficiencia orgánica persistente y complicaciones locales extensas (pancreatitis moderada – grave – crítica) deben ser trasladados a centros especializados → UCI.
3 (ENARM 2014)
5 (ENARM 2014, 2009) (ENAM EXTRA 2021) 6 (ENARM 2013)




↑ Enzimas pancreáticas séricas → confirma el diagnóstico clínico 7
♦ ≥ 3 veces el rango de referencia superior
♦ No se correlacionan con la gravedad (no evalúan pronóstico) 8
Amilasa 9 :
♦ Se eleva a partir de las 6 - 12 horas hasta 3 a 5 días 10
♦ ↑ sensibilidad, pero ↓ especificidad 11
♦ Suele ser más elevada en las pancreatitis biliares.
♦ Puede ser normal en caso de triglicéridos > 1.000 mg/dl, consumo de alcohol o en casos tardíos (> 72 horas de iniciado la clínica).
♦ También se puede elevar en otras patologías (insuficiencia renal, quemaduras, embarazo, perforación, obstrucción o infarto intestinal, rotura de embarazo ectópico, aneurisma de aorta) 12
Lipasa:
♦ Se eleva a partir de las 4 – 8 horas hasta 8 a 14 días 13
♦ ↑sensibilidad y ↑ especificidad
♦ Mayor elevación en etiología alcohólica.
♦ Prueba de elección cuando la causa es ↑ triglicéridos o alcohol.
♦ Confirma el diagnóstico en casos tardíos (> 48 a 72 horas) 14
Estudios de imagen → ecografía – tomografía (elección) 15
♦ Útil para confirmar el diagnóstico cuando las enzimas son negativas y la sospecha clínica es alta.
♦ Ecografía (prueba inicial más útil) → detección de cálculos biliares
♦ La tomografía también sirve para evaluar la gravedad.
♦ Método de elección para el diagnóstico de complicaciones locales (pseudoquistes, abscesos)
Los signos de hemorragia retroperitoneal también se presentan en rotura de aneurisma de aorta abdominal, embarazo ectópico roto, trauma abdominal severo → hemoperitoneo.
La amilasa y la lipasa, que se utilizan para el diagnóstico de pancreatitis, no se pueden utilizar para predecir el pronóstico. (ENARM 2017)
Pancreatitis con amilasa normal → cuando la etiología es por alcohol (20 % casos) y triglicéridos (50 % casos)
Pruebas para evaluar la gravedad → identificar a pancreatitis potencialmente grave
Marcadores clínicos
IMC > 30 (obesidad)
Edad > 55 años
Derrame pleural
Marcadores de laboratorio
Hemoconcentración (indica pérdida de líquido por tercer espacio) > 44 %
↑ PCR > 150 mg/L → marcador bioquímico ideal 1
↑ Procalcitonina
↑ Interleucina 6
Leucocitosis
Hipocalcemia 2
Sistemas de puntuación 1 (ENARM 2012)
RANSON ≥ 3 3
Los criterios de Ranson constan de 11 parámetros. Cinco de los factores se evalúan al ingreso y seis, durante las próximas 48 h.
La mortalidad fue del 0 al 3 % cuando la puntuación fue < 3; del 11 al 15 % cuando la puntuación fue ≥3; y del 40 % cuando la puntuación fue ≥ 6.
A la admisión (0 h)
♦ Leucocitos > 16 mil 4
♦ LDH > 350 UI/L
♦ Edad > 55 años 5
♦ Glucosa > 200 mg/dl 6
♦ AST (TGO) > 250 UI/L 7
A las 48 h 8
♦ HTO baja > 10 % 9
♦ BUN aumento > 5mg/dl
♦ Calcio < 8 mg/dl 10
♦ PaO2 < 60 mmHg 11
♦ Déficit de bases > 4 mEq/L
♦ Déficit de fluidos > 6 L
BISAP > 2
A los pacientes se les asigna 1 punto por cada uno de los siguientes parámetros durante las primeras 24 horas:
BUN > 25 mg/dl
Impaired mental (Glasgow < 15) SIRS (síndrome de respuesta inflamatoria sistémica)
Age (edad) > 60 años
Pleural effusions (derrame pleural)
APACHE > 8
Desarrollado originalmente para pacientes en estado crítico en unidades de cuidados intensivos (UCI). Tiene 12 medidas fisiológicas y puntos extra según la edad y la presencia de enfermedad crónica. Los estudios sugieren que la mortalidad es inferior al 4 % con una puntuación <8 y es del 11 al 18 % con una puntuación > 8.
MARSHALL ≥ 2
SIRS ≥2
CRITERIOS DE RANSON
PARA SEVERIDAD DE PANCREATITIS AGUDA (ESSALUD 2022)
La mortalidad aumenta cuando se cumplen mjás de 3 criterios 0 horas 48 horas
Edad > 55 Hematocrito Caida 10%
Conteo leucocitario > 16000/cc BUN Incremento 5 mg/dL
Clucosa sérica >200 mg/dL Calcio sérico <8 mg/dL
LDH >350 U/L PaO2 <60 mmHg
AST >250 U/L Déficit de base >4 MEq/L
Secuestro de líquido >6 L
2 (ESSALUD 2018)
3 (ENARM 2015) (ENARM 2002) (ESSALUD 2022)
4 (ENARM 2003)
5 (ENARM 2003) (ENAM EXTRA 2022)
6 (ENARM 2003)
7 (ENAM 2013)
8 (ESSALUD 2012)
9 (ENARM 2004)
10 (ESSALUD 2018)
11 (ESSALUD 2012)
La determinación de los valores de calcio es muy importante: la hipercalcemia puede causar pancreatitis, que, a su vez, puede causar hipocalcemia (dato de gravedad). DATITO
CARDIOVASCULAR T/A
SISTÓLICA EN MM DE HG >90 <90 con respuesta a líquidos <90 sin respuesta a líquidos
Un puntaje de 2 o más en cada uno de esos sistemas define la falla orgánica
Tomografía computarizada 1 → solicitarla a las 72 horas de iniciada la clínica 2
♦ Evaluamos el índice de severidad tomográfica (IST) = grados de Baltazar + porcentaje de necrosis 3
♦ TAC sin contraste → grados de Baltazar
♦ TAC con contraste → porcentaje de necrosis
Grado Puntos
Descripción morfológica
A 0 Páncreas normal
B 1 Aumento focal o difuso del páncreas
C 2 Inflamación peripancreática (ENARM 2007)
D 3 Colección líquida única
E 4 > 2 colecciones líquidas o 1 gas
Locales
Pseudoquistes pancreáticos
♦ Colección líquida rica en enzimas pancreáticas rodeada por una pared no epitelializada, que consta de fibrina y tejido de granulación 1
♦ Complicación local más frecuente.
♦ Suele ocurrir varias semanas después de la pancreatitis (> 4 semanas) 2
♦ Generalmente, asintomático → dolor abdominal o masa abdominal indolora 3
♦ Cura con elevación de amilasa persistente (> 5 días) 4
♦ TAC: colección homogénea ovalada única, con pared bien definida → localizado frecuentemente en cuerpo o cola de páncreas 5
♦ Resolución espontánea (+ frecuente) → conducta expectante (vigilancia).
♦ Complicaciones: rotura 6 , infección o sangrado
♦ Cirugía: técnicas de drenaje cuando presenta complicaciones o mide > 6 cm y persiste > 6 semanas.
(ENAM 2017) 1 (ENARM 2006)
1 (ENAM 2011)
2 (ENAM 2017) (ENARM 2014, 2005) (ESSALUD 2012)
3 (ENAM 2011)

Figura 80. Pseudoquiste pancreático. 5 (ENARM 2004)
(ENARM 2003) 2 (ENARM 2014) (ENAM 2017) 3 (ENARM 2004, 2014) (ENAM 2017)
7 (ENARM 2015)
Absceso pancreático:
♦ Tejido necrótico infectado que típicamente se desarrolla > 4 semanas después de un ataque de pancreatitis aguda
♦ Germen más frecuente: E. Coli
♦ Cursa con fiebre, dolor abdominal, leucocitosis con desviación izquierda
♦ TAC: colección de líquido con burbujas de aire 7
♦ Manejo con antibióticos + cirugía (drenaje)
Necrosis pancreática
♦ Áreas focales o difusas de parénquima con tejido necrótico
♦ TAC: zona heterogénea que no capta contraste
♦ Tipos: estéril (buen pronóstico) e infectada (peor pronóstico)
♦ La mayoría de las infecciones (aproximadamente 75 %) son monomicrobianas, con organismos derivados del intestino (Escherichia coli, Pseudomonas, Klebsiella y Enterococcus).
♦ Necrosis infectada → principal causa de muerte > 2 semanas (fase tardía)
♦ Fiebre y evolución desfavorable
♦ TAC: aire en zona de necrosis
♦ PAAF: cultivo y gram positivo
♦ Complicación local más severa (mortalidad del 30 %)
♦ Necrosis estéril→ conducta expectante
♦ Necrosis infectada → antibióticos + cirugía (desbridamiento míninamente invasivo)

Sistémicas
8 (ENARM 2016)
Insuficiencia respiratoria: PaO2 ≤ 60mmHg (+ frecuente)
Shock: presión arterial sistólica < 90mmHg
Insuficiencia renal: creatinina >2 mg/dl (prerrenal por depleción de volumen)
SIRS, sepsis, CID
Falla multiorgánica
Principal causa de muerte en las primeras 2 semanas (fase precoz) 8
Los pacientes con pancreatitis aguda moderada o grave, signos de sepsis o deterioro clínico 72 horas después de la presentación inicial, deben someterse a una tomografía computarizada con contraste para evaluar la presencia de necrosis pancreática o extrapancreática y complicaciones locales.

< 4 semanas >4 semanas
Sin necrosis Colección liquida aguda peripancreática Pseudoquiste*
Con necrosis Colección necrótica aguda Necrosis encapsulada*
*Estéril infectada
Medidas generales
♦ Admisión al hospital y evaluación de la gravedad de la enfermedad (considerar la admisión a la UCI)
♦ Reanimación con líquidos: hidratación agresiva con cristaloides (solución de lactato Ringer > solución salina normal) 1
Nutrición
♦ La alimentación oral puede iniciarse temprano (dentro de las 24 horas) → casos leves.
♦ Alimentación enteral (sonda nasogástrica / nasoyeyunal) → casos severos
♦ Ayuda a mantener la barrera intestinal y previene la translocación bacteriana.
♦ Se prefiere la nutrición enteral > NPT.
♦ Nutrición parenteral total (NPT): solo en pacientes que no pueden tolerar la alimentación enteral (aquellos con íleo y dolor abdominal persistente)
♦ Iniciar tolerancia oral → dieta blanda y baja en residuos, baja en grasas
– Paciente asintomático
– RHA presentes (ausencia de íleo)
– PCR y amilasa normal
1 (ENAM 2018) (ENAM EXTRA 2023)
Antibióticos:
♦ No se recomienda la terapia antibiótica profiláctica.
♦ Solo deben usarse en pacientes con evidencia de necrosis infectada o absceso 2
♦ Elección → carbapenem (imipenem + cilastatina)
♦ Alternativa → ciprofloxacino + metronidazol
CPRE → esfinterotomía precoz
♦ Cuando existe obstrucción de la vía biliar prolongada
♦ Pancreatitis leve > 72 horas
♦ Pancreatitis severa 24 a 48 horas
♦ Colangitis < 24 horas Colecistectomía
♦ Pancreatitis leve → a los 4 a 6 días
♦ Pancreatitis severa → a las 6 semanas
Cirugía → STEP UP (drenaje → desbridamiento mínimamente invasivo → laparotomía) 3
♦ Necrosis pancreática infectada 4
♦ Absceso pancreático
♦ Pseudoquiste infectado o complicado
♦ Falla multiorgánica (ausencia de respuesta al manejo médico) 5
La medida terapéutica más importante es la reposición adecuada de líquidos (mínimo de 3 a 4 litros de cristaloides por día) (ENAM 2018).
En pacientes con pancreatitis grave, recomendamos la nutrición enteral a través de una sonda nasoyeyunal colocada por vía endoscópica o radiológica en lugar de iniciar la nutrición parenteral.
2 (ENAM EXTRA 2022) 4 (ENARM 2007) 5 (ENARM 2020)
Resucitación agresiva con fluidos en las primeras 24 horas
Mortalidad
3 (ENARM 2020) (ENAM EXTRA 2022)
Nutrición enteral después de 5 días si no hay tolencia a la alimentación oral
La mitad de todas las muertes ocurren en las primeras 2 semanas y son principalmente debido al fallo de múltiples sistemas orgánicos
Antibióticos en infección documentada
Terapia mínimamente invasiva para las complicaciones locales (Ej, necrosis infectada)
La mitad de todas las muertes ocurren despues de las 2 semanas y son principalmente debido a infeciones pancreáticas o extrapancreáticas
Inflamación progresiva y un daño irreversible a la anatomía y función (exocrina y endocrina) del páncreas
1 (ENARM 2012)
Consumo excesivo crónico de alcohol
♦ 60-70 % de los casos → causa más frecuente
♦ Especialmente, hombres
♦ Consumo 40 a 50 gr/día
Pancreatitis tropical
♦ Causa común en países subdesarrollados (Sudáfrica)
♦ Edad temprana de inicio
♦ Implicación de factores nutricionales (desnutrición crónica) 1
♦ Muy probablemente causado por un defecto genético (mutaciones SPINK1) y factores ambientales (el alto consumo de yuca se ha implicado en su patogénesis).
En la pancreatitis autoinmune, existe fibrosis e infiltración linfoplasmocitaria, con ausencia de calcificaciones pancreáticas.
1 (ENARM 2000)
Exposición a toxinas y / o mediadores inflamatorios (alcohol, citocinas) → activación de células estrelladas pancreáticas → fibrosis (calcificación) 1
Clasificación Factores de riesgo
Alcohol
Insuficiencia renal crónica
Hipercalcemia
Tóxicometabólicas
Idiopática
Genéticas
Autoinmune
Pancreatitis aguda severa o recurrente
Obstructiva
Dolor abdominal epigástrico (síntoma principal) → leve a moderado
♦ El dolor se irradia hacia la espalda, se alivia al inclinarse hacia adelante y se agrava después de comer (grasas).
♦ El dolor es inicialmente episódico y se vuelve persistente a medida que avanza la enfermedad.
Hiperlipidemia
Medicamentos
Tabaco
Toxinas
De inicio temprano o tardío
Pancreatitis tropical
PRSS-1
SPINK-1
CFTR
CTRC
Tipo 1 –esclerosantelinfoplasmático
Tipo 2ductocentricaidiopática
Irradiación posnecrótica
Pancreatitis aguda recurrente
Isquemia
Páncreas divisum
Disfunción del esfínter de Oddi
Obstrucción de ducto pancreático
Habitualmente, la primera manifestación de la pancreatitis crónica etílica es un episodio de pancreatitis aguda.
A menudo, asociado con náuseas y vómitos.
Características de la insuficiencia pancreática exocrina:
♦ Manifestación tardía → después de que se destruye el 90 % del parénquima pancreático
♦ Esteatorrea (mala digestión por ↓ enzimas)
♦ Malabsorción → vitamina B12
♦ Pérdida de peso
Características de la insuficiencia pancreática endocrina:
♦ Diabetes pancreática (deficiencia de hormonas endocrinas)
♦ Para que se presente diabetes, se requiere la destrucción del 75 % de la glándula.
♦ Precede a la esteatorrea.
Niveles séricos de enzimas pancreáticas: la lipasa (específica) y la amilasa (inespecífica) suelen ser normales.
Pruebas de función pancreática indirectas:
♦ Actividad elastasa fecal - 1 (FE-1): confirma que la esteatorrea se debe a la ↓ lipasa pancreática
♦ Estimación cuantitativa de grasa fecal en 72 horas
– La grasa fecal > 7 g por día es un diagnóstico de esteatorrea
Pruebas de función pancreática directas:
♦ Prueba de colecistoquinina: ↓ enzimas
♦ Prueba de secretina: ↓ bicarbonato (↑ sensibilidad)
♦ Tripsinógeno < 20 ng/ml (↑especificidad)
Pruebas de imagen → confirman el diagnóstico
♦ TC abdominal (TC simple y con contraste) → prueba inicial de elección
♦ Dilataciones y calcificaciones de los conductos pancreáticos en la TC simple y atrofia pancreática
CPRE → Gold estándar
♦ Diagnóstica y terapéutica
♦ Apariencia de “cadena de lagos” o “collar de perlas” (rasgo característico) →estenosis y dilataciones ductales
♦ Calcificaciones pancreáticas
Estudio diagnostico Sensibilidad (%) Especificidad (%)
Radiografía de abdomen NA NA
Ultrasonido 60-70 80-90
Tomografía axial computarizada 75-90 85
Colangiopancreatografía por resonancia magnética 85 100
Ultrasonido endoscópico 97 60
Colangiopancreatografía retrógrada endoscópica 76-95 90

en pancreatitis crónica.

El diagnóstico se basa en la identificación de alteraciones morfológicas del páncreas → fibrosis o calcificación (criterio mayor).
La nemotecnia CED: calcificación + esteatorrea + diabetes = pancreatitis crónica.
Sospecha de pancreatitis crónica (dolo abdiminal y/o digestión deficiente)

El astasa fecal o tripsinógeno sérico

Anor mal

Enzimas pancreáticas


Nor mal

Prueba de secretina TAC

Anor mal


Anor mal

Enzimas pancreáticas CPRE intervencionista Cirugía

Medidas generales
86. Algoritmo diagnóstico de pancreatitis crónica
♦ Abstinencia de alcohol y nicotina
♦ Reemplazo de enzimas pancreáticas → lipasa (con las comidas)
♦ Administración parenteral de vitaminas liposolubles (A, D, E, K) si es necesario
♦ Insuficiencia endocrina: administración de insulina
Manejo del dolor
♦ Analgésicos: AINES → opioides para el dolor intenso (fentanilo/morfina de acción prolongada) →antidepresivos tricíclicos a dosis baja (amitriptilina)
♦ Dolor intratable: – Bloqueo del ganglio celíaco (ofrece alivio temporal) – Papilotomía endoscópica con dilatación ductal, colocación de stent y extracción de cálculos, si los hubiera – Litotricia extracorpórea por ondas de choque (LEOC): para cálculos intraductales Cirugía
♦ Indicación: si se sospecha cáncer de páncreas o en personas con dolor intratable
♦ Técnicas de drenaje → Pancreatoyeyunostomía → si el conducto pancreático principal está dilatado (> 5 mm)
♦ Técnicas de resección → procedimiento de Whipple → si el conducto pancreático principal está estenosado


Coloración amarillenta de la piel, esclerótica y membranas mucosas debido a la deposición de la bilirrubina.
La ictericia escleral se desarrolla a niveles de bilirrubina sérica > 2 a 3 mg / dl.
La ictericia de la piel se hace evidente con niveles de bilirrubina sérica > 4-5 mg / dl.


Figura 87. Ictericia → pigmentación amarillenta de la piel (mucosas) y esclera.
1 (ENAM 2020)
Hiperbilirrubinemia no conjugada (indirecta)
↑ Producción de bilirrubina (↑ degradación de la hemoglobina)
♦ Hemólisis → congénita (talasemia) o adquirida (autoinmune, infecciosa)
♦ Ictericia fisiológica del recién nacido
– TVM de glóbulos rojo es de 90 días (prematuro 60 días)
– Inmadurez hepática
♦ Extravasación de sangre a los tejidos (cefalohematoma)
♦ Diseritropoyesis → anemia perniciosa (eritropoyesis ineficaz)
♦ Enfermedad de Wilson
Deterioro de la captación hepática de bilirrubina
♦ Fármacos (Rifampicina, Probenecid, sulfonamidas) 1
♦ Derivación portosistémica
♦ Insuficiencia cardiaca
Conjugación defectuosa
♦ Hiperbilirrubinemia hereditaria (déficit de la UGT)
– Síndrome de Gilbert → déficit enzimático leve 2
– Síndrome de Crigler-Najjar → déficit enzimático moderado a grave
♦ Enfermedad del hígado (hepatitis, cirrosis)
♦ Síndrome de Arias (ictericia por leche materna)
♦ Enfermedad de tiroides
– Hipertiroidismo
– Hipotiroidismo
♦ Etinilestradiol
2 (ENAM 2015) (ENAM EXTRA 2021, 2023)
La pseudoictericia es una coloración amarillenta de la piel (esclera está normal) se debe a un exceso de betacaroteno (consumo de zanahorias, naranja) (ENAM EXTRA 2020, ENAM 2014) La enzima uridina difosfoglucuronatoglucuronosiltransferasa (UGT) es la encargada de conjugar a la bilirrubina indirecta y convertirla en B. directa (ENAM EXTRA 2021)
Hiperbilirrubinemia conjugada (directa)
Disminución de la excreción / alteración de la recaptación de bilirrubina 3
♦ Síndrome de Dubin-Johnson → alteración en el transporte canalicular 4
♦ Síndrome del Rotor → Defecto de la recaptación sinusoidal de bilirrubina conjugada
♦ Atresia biliar → colestasis neonatal (B. directa > 20 % bilirrubina total)
Necrosis hepatocelular
♦ Hepatitis alcohólica
♦ Hepatitis viral
♦ Hepatitis autoinmune
♦ Hepatotoxicidad por fármacos
– Acetaminofén (paracetamol) → necrosis centrolobulillar
– Isoniazida 5
– Metotrexate
Colestasis intrahepática
♦ Cirrosis
♦ Hepatopatía congestiva (insuficiencia cardiaca)
♦ Colangitis biliar primaria (cirrosis biliar primaria)
♦ Colestasis posoperatoria
♦ Síndrome de Alagille → trastorno genético caracterizado por aplasia o hipoplasia del árbol biliar intrahepático
♦ Trastornos infiltrativos
– Tuberculosis – Sarcoidosis – Amiloidosis
– Linfoma
♦ Metildopa 6
♦ Nitrofurantoína → también produce neuropatía periférica
♦ Estatinas → también son miotóxicas
♦ Corticoides
♦ Diclofenaco 7
♦ Amiodarona
♦ Ketoconazol 8
♦ Fármacos
– Esteroides anabólicos.
– Amoxicilina-clavulanato
– Captopril
– Clorpromacina 9
– Anticonceptivos hormonales 10
– Fenitoína, Valproato, carbamazepina 11
– Sulfas
– Tetraciclina
– Macrólidos
– Ampicilina, ceftriaxona 12
– Metimazol 13
♦ El embarazo → colestasis gravídica
♦ Nutrición parenteral total
♦ Crisis hepática en la anemia de células falciformes
♦ Septicemia
Colestasis extrahepática (obstrucción biliar)
♦ Patología biliar → coledocolitiasis, colangitis, síndrome de Mirizzi
♦ Tumores periampulares → cáncer de páncreas (más frecuente), colangiocarcinomas
♦ Malformaciones de los conductos biliares (estenosis posoperatorias / inflamatorias y quistes biliares)
♦ Colangitis esclerosante primaria
♦ Pancreatitis aguda y crónica
♦ Infecciones parasitarias → trematodos (Fasciola, Schistosoma), áscaris lumbricoides
♦ Enfermedad de Weil → una forma grave de leptospirosis (diátesis hemorrágica, disfunción hepática, disfunción renal)
♦ Fiebre amarilla → fiebre hemorrágica viral aguda causada por un virus de la familia Flaviviridae, transmitida por la picadura de un mosquito, Aedes aegypti.
3 (ESSALUD 2023)
4 (ENARM 2015)
5 (ENARM 2020)
6 (ENARM 2020)
7 (ENARM 2020)
8 (ENARM 2020)
El síndrome de Mirizzi es la compresión inflamatoria del conducto biliar extrahepático por una colecistitis.
El síndrome de Alagille suele ser causado por una mutación del gen JAG1 en el cromosoma 20. Se presenta con ictericia colestásica, defectos cardíacos congénitos, vértebras en mariposa, dismorfia facial y embriotoxon posterior (disgenesia del segmento anterior del ojo). DATITO
Diagnóstico
(ENARM 2014)
(ENARM 2014)
Los rangos de referencia de las pruebas hepáticas variarán de un laboratorio a otro → los rangos de referencia normales para adultos son los siguientes:
Bilirrubina, total: 0.0 a 1.0 mg / dL
Bilirrubina, directa: 0.0 a 0.4 mg / dL
Fosfatasa alcalina (FA) → marcador de colestasis 1
♦ Hombres: 45 a 115 unidades internacionales / L
♦ Mujeres: 30 a 100 unidades internacionales / L
Gamma-glutamil transpeptidasa (GGT) → marcador + sensible de colestasis 2
♦ Hombre: 8 a 61 unidades internacionales / L
♦ Mujeres: 5 a 36 unidades internacionales / L
(ENARM 2020) 3 (ENAM EXTRA 2021) (ENARM 2020)
Alanina aminotransferasa (ALT = TGP) → marcador específico de necrosis hepatocelular 3
♦ Hombres: 10 a 55 unidades internacionales / L
♦ Mujeres: 7 a 30 unidades internacionales / L
Aspartato aminotransferasa (AST = TGO) → marcador sensible de necrosis hepatocelular
♦ Hombres: 10 a 40 unidades internacionales / L
♦ Mujeres: 9 a 32 unidades internacionales / L
Tiempo de protrombina (TP): 11,0 a 13,7 segundos → marcador de falla hepática aguda (precoz)
Albúmina: 3.3 a 5.0 g / dL (33 a 50 g / L) → marcador de falla hepática crónica 4
Pruebas bioquímicas
Utilidad clínica
Alanina aminotransferasa Daño hepatocelular (ENAM EXTRA 2021)
Aspartato aminotransferasa Daño hepatocelular (ENAM EXTRA 2021)
Fosfatasa alcalina
Gamma glutamil transferasa
Bilirrubina
Albúmina
Tiempo de protrombina
Colestasis, enfermedad infiltrativa, obstrucción biliar
Colestasis u obstrucción biliar
Colestasis, defectos en la conjugación, obstrucción biliar
Función hepática
Función hepática
14. Pruebas bioquímicas para la valoración de la función y daño hepático.
Es importante identificar la causa subyacente que está produciendo este signo clínico (ictericia).
Hemólisis
♦ Triada: anemia + esplenomegalia + ictericia
♦ ↑ reticulocitos, ↑ bilirrubina indirecta, ↓ haptoglobina, ↑LDH
♦ ↑ Urobilinógeno urinario
Síndrome de Gilbert 5 :
♦ Más frecuente en varones jóvenes
♦ Déficit leve de la enzima (UGT)
♦ Sigue una herencia autosómica dominante.
♦ Ictericia hereditaria más frecuente (predominio B. indirecta)
♦ Perfil hepático normal, excepto ↑ bilirrubina indirecta
♦ Test de Coombs + → anemia hemolítica autoinmune
♦ Esquistocitos+→hemólisis microangiopática (PPT, SHU, síndrome Hellp)
♦ Se exacerba con el ayuno, ejercicio, intervenciones quirúrgicas, fiebre o infecciones.
♦ Diagnóstico: test de ayunas
♦ Respuesta total a fenobarbital (inductor enzimático)
♦ No se requiere una terapia específica.
5 (ENAM 2015) (ENAM EXTRA 2021)
Síndrome de Crigler-Najjar tipo II
♦ Más frecuente en lactantes
♦ Déficit moderado de la enzima (UGT)
♦ Sigue una herencia autosómica dominante.
♦ Perfil hepático normal, excepto ↑ bilirrubina indirecta
♦ Respuesta parcial a fenobarbital
Síndrome de Crigler-Najjar tipo I
♦ Más frecuente en lactantes (Kernicterus)
♦ Déficit severo de la enzima (UGT)
♦ Sigue una herencia autosómica recesiva.
♦ Perfil hepático normal, excepto ↑ bilirrubina indirecta
♦ Ausencia de respuesta a fenobarbital
♦ Tratamiento → trasplante hepático
Síndrome de Dubin-Johnson
♦ Alteración en el transporte canalicular (Mutación del MRP-2)
♦ Herencia autosómica recesiva
♦ Ictericia hereditaria a predominio de B.directa más frecuente
♦ Perfil hepático normal, excepto ↑ bilirrubina directa
♦ Pigmento melanoide hepático (hígado negro)
Síndrome del Rotor
♦ Defecto de la recaptación sinusoidal de bilirrubina (almacenamiento)
♦ Herencia autosómica recesiva
♦ Perfil hepático normal, excepto ↑ bilirrubina directa
♦ Hígado normal en la histología
Bilirrubina aumentada Indirecta (no conjugada) Indirecta (no conjugada) Indirecta (no conjugada)
Defecto metabólico Déficit parcial (UDP-GT) Déficit completo (UDP-GT) Déficit casi completo (UDP-GT)
Tipo de herencia
Autosómica dominante Autosómica recesiva Autosómica dominante
Curso Benigno Ictericia de estrés Muerte 1-2 años Ictericia Aumenta en estrés
Bilirrubina aumentada
Defecto metabólico
Tipo de herencia
Directa (conjugada)
Directa (conjugada)
Alteración excreción aniones orgánicos Defecto almacenamiento bilirrubina
Autosómica recesiva
Autosómica recesiva
Curso Benigno Benigno
Necrosis hepatocelular
♦ Fiebre, anorexia, dolor en hipocondrio derecho
♦ ↑ transaminasas ( ↑TGO - ↑ TGP) 6
♦ ↑ bilirrubina directa > indirecta
♦ Serología positiva → hepatitis viral
♦ Cociente TGO/TGP > 2 → hepatitis alcohólica
♦ Anticuerpos antimúsculo liso → hepatitis autoinmune
Colestasis
♦ Triada: ictericia + coluria + acolia
♦ Prurito asociado 7
♦ ↑FA y ↑ GGT 8
♦ ↑ bilirrubina directa > indirecta
♦ Anticuerpos antimitocondrial → colangitis biliar primaria
♦ Anticuerpos ANCA P + → colangitis esclerosante primaria
♦ Estudios de imagen (ecografía – colangioRMN)
– Colédoco normal → colestasis intrahepática (signo de escopeta de doble cañón)
– Colédoco dilatado (> 7 mm) → colestasis extrahepática (signo de doble conducto)
♦ Benigno: coledocolitiasis → dolor abdominal + ictericia
♦ Maligno: cáncer de páncreas (Ca 19.9 ↑) → dolor abdominal + ictericia + ↓ peso
6 (ENAM EXTRA 2021) 7 (ESSALUD 2010) 8 (ENARM 2014)


Definición
La hepatitis A es una enfermedad viral causada por el virus de la hepatitis A hepatotrópico (VHA) → familia Picornavirus.
Epidemiología
La hepatitis A es muy común en las regiones tropicales y subtropicales.
Los programas de vacunación han hecho que la enfermedad sea bastante rara en los niños; la infección está ahora más extendida en adultos.
Clásicamente, afecta en la edad pediátrica 1 .
Etiología
Patógeno: virus de la hepatitis A (enterovirus)
Pertenece a la familia Picornaviridae y al género Hepatoviridae

Virus pequeño (27 nm de diámetro), sin envoltura, con ARN monocatenario de sentido positivo
Vía de transmisión: fecal-oral 2
Agua y alimentos contaminados (mariscos crudos) 3
Grupos de riesgo: residentes de hogares de ancianos, viajeros internacionales, niños sin vacunación, guarderías 4
Período de incubación: 2 a 6 semanas
Periodo infeccioso (contagio): 2 semanas antes a 1 semana después del inicio de la enfermedad
Diagnóstico
La infección por VHA en niños suele ser asintomática (anictérica).
El riesgo de enfermedad sintomática (ictericia) aumenta con la edad.
Fases de la hepatitis viral aguda:
♦ Fase prodrómica: 1 a 2 semanas –
Dolor en el cuadrante superior derecho, hepatomegalia dolorosa 5
– Fiebre, malestar 6
– Anorexia, náuseas, vómitos 7
Diarrea → 20 % de los adultos y el 60 % de los niños
♦ Fase ictérica: > 2 semanas
– Ictericia (+ común en adultos) 4
– Coluria, acolia 9
– prurito 10
♦ Resolución de síntomas (no crónica)
Evalúa la gravedad (severidad) → tiempo de protrombina 11
1 (ENAM EXTRA 2020, 2022)(ENAM 2014)
2 (ENARM 2011) (ESSALUD 2011)
3 (ENAM EXTRA 2020)
4 (ENARM 2009) (ENAM 2014)
5 (ENARM 2009, 2018) (EXTRA 2020, 2022) (ENAM 2014, 2020)
6 (ENARM 2009, 2000) (ENARM 2018) (ENAM EXTRA 2022)
7 (ENARM 2000) (ENAM EXTRA 2022)
8 (ENARM 2000) (ENARM 2018)
9 (ENARM 2000) (ENAM EXTRA 2020) (ENAM 2020)
10 (ENAM EXTRA 2023)
11 (ENARM 2011) (ENARM 2003)
Pruebas de laboratorio
↑ Niveles de transaminasas séricas (AST=TGO, ALT=TGP) 12
La relación AST / ALT suele ser < 1.
↑ Bilirrubina total (↑ B. directa > indirecta)
↑ Anticuerpos IgM anti-VHA (Prueba de confirmación) 13 → infección activa (hepatitis aguda)
↑ Anticuerpos IgG anti-VHA → curado o vacunado
↑ tiempo de protrombina (INR) → indica falla hepática aguda 14

Tratamiento
La hepatitis A, generalmente, se autolimita.
12 (ENAM 2012) (ENAM EXTRA 2021)
13 (ENAM 2012, ENAM 2020)
14 (ENARM 2011) (ENARM 2003) (ESSALUD 2012)
La presencia de anticuerpos IgM anti-VHA confirma la hepatitis A activa aguda (ENAM 2020) La detección de anticuerpos IgG anti-VHA indica inmunidad contra VHA, debido a una infección (curado) o vacunación previa.
Se pueden ofrecer cuidados de apoyo: descanso según sea necesario, tratamiento sintomático, (antieméticos) 15
Prevención
Principales medidas preventivas: seguridad alimentaria y del agua.
Inmunización activa → vacuna contra la hepatitis A (virus vivo atenuado)
Se administran 2 o 3 dosis por vía intramuscular; indicaciones:
♦ Todos los niños > 12 meses de edad
♦ Individuos con enfermedad hepática crónica (VHB – VHC)
♦ Se consideran protectores títulos de anti-VHA superiores a 20 mU/ml.
Pronóstico
La tasa de mortalidad es de 0.1 a 0.3 % porque pocos pacientes progresan a insuficiencia hepática aguda. Los individuos afectados por la hepatitis A (a diferencia de la hepatitis B y la hepatitis C) no se convierten en portadores ni desarrollan hepatitis crónica.
15 (ENAM 2017)
Definición
La hepatitis B es una enfermedad viral causada por el virus de la hepatitis B hepatotrópico (VHB) → familia de los hepadnavirus.
Epidemiología
Infección viral crónica más común de los virus hepatotrópicos. Causa importante de cirrosis (después de la etiología alcohólica)
Cuanto más joven es el infectado, más probabilidades hay de que el paciente desarrolle VHB crónico → cirrosis
♦ Solo el 5 % de los adultos
♦ 50 % de niños entre 1 y 5 años
♦ 90 % recién nacidos

Curación
90 - 95%

Infección aguda por el HBV

5 - 10%
HB eA g+ y DNA+ Infección crónica
Crónica

Cirrosis
15 - 20%

Car nicoma hepatocelular


Infección
Fulminante <1%
Figura 92. Conductos biliares intrahepáticos dilatados (signo de escopeta de doble cañón)
Etiología
Patógeno
♦ Virus de la hepatitis B (VHB) → miembro de la familia de los hepadnavirus.
♦ Virus de ADN circular, parcialmente bicatenario 1
Transmisión
Otros virus hepatotropos: CMV, VEB, virus de la fiebre amarilla.


Figura 93. Transmisión por vía sexual y perinatal en infección por VHB.
1 (ENAM 2015)
♦ Sexual: se transmite cuando los fluidos corporales entran en contacto con la piel lesionada o las membranas mucosas (boca, genitales o recto). Los grupos de riesgo incluyen:
– Hombres que tienen sexo con hombres
– Personas con múltiples parejas sexuales o parejas sexuales de personas con VHB positivo
– Trabajadoras sexuales
♦ Parenteral: por agujas o instrumentos contaminados que entran en contacto con la sangre del paciente. Transplacentaria o vertical → transmisión de madre a hijo
– Tiene mal pronóstico.
Período de incubación: 1 a 6 meses


95. La biopsia de hígado de un paciente con infección crónica por el virus de la hepatitis B muestra hepatocitos en vidrio esmerilado (flechas gruesas).
Infección aguda VHB → infección adquirida en los últimos 6 meses
♦ Período prodrómico (preictérico) 1 a 2 semanas después de la infección: erupción cutánea, artralgias, mialgias, fiebre
♦ Hepatitis subclínica → asintomática (70 % de los casos)
♦ Hepatitis sintomática (30 % de los casos)
♦ Fiebre, erupción cutánea, artralgias, mialgias, fatiga
♦ Náuseas, anorexia
♦ Ictericia
♦ Dolor en el cuadrante superior derecho
♦ Los síntomas generalmente se resuelven después de algunas semanas, pero pueden durar hasta 6 meses.
♦ Puede convertirse en hepatitis fulminante (0,5 % de los casos)
Infección crónica VHB→ infección que persiste durante más de 6 meses con detección de HbsAg +
♦ La mayoría de los pacientes son portadores inactivos y no contagiosos.
♦ La posible reactivación de la hepatitis crónica inactiva puede manifestarse de forma variable de las siguientes formas:
– Asintomático
– Síntomas inespecíficos
– Astenia
– Náuseas, anorexia
– Dolor abdominal inespecífico
– Falla hepática → prolongación TP, encefalopatía
Características extrahepáticas:
♦ Poliartritis crónica (+ frecuente)
♦ Acrodermatitis papular de Gianoti
♦ Poliarteritis nodosa 2
♦ Glomerulonefritis membranosa
♦ Anemia aplásica
Marcadores serológicos:
♦ Antígeno de superficie de Hepatitis B (HBsAg)
– Primera evidencia de infección (primer marcador serológico) 3
– También se denomina antígeno australiano.
– Confirma la infección (hepatitis) 4
– Positivo > 6 meses → infección crónica (estado portador)
2 (ENAM 2010)
3 (ENARM 2015) (ENARM 2002)
4 (ENAM 2010) (ENARM 2017) (ENARM 2018) (ENARM 2020)
♦ Anticuerpo contra Antígeno de superficie de Hepatitis B (Anti-HBs)
– Indica inmunidad a VHB debido a una infección resuelta (curado) 5
– Indica también inmunidad cuando hay vacunación (Único marcador presente en los vacunados) 6
– Usualmente, aparece 1–3 meses después de la infección o vacunación.
♦ Anticuerpo contra antígeno core de Hepatitis B (Anti-HBc)
♦ Anti-HBc IgM:
– Indica hepatitis AGUDA (≤ 6 meses) 7
Primer marcador de la respuesta inmune frente a la infección por VHB
– Marcador serológico que mejor define la existencia de una hepatitis aguda por el virus B
Presente en el periodo de ventana
– EI factor reumatoide puede dar falsos positivos.
♦ Anti-HBc IgG:
– Indica hepatitis CRÓNICA (> 6 meses) 8
– Resolución reciente de una infección por VHB (curado reciente)
♦ Antígeno de envoltura de Hepatitis B (HBeAg)
– Indica una replicación viral activa y, por lo tanto, una alta transmisibilidad (contagio) 9
Marcador de replicación cualitativo (↑sensibilidad)
– Traduce hepatitis ACTIVA 10
♦ Anticuerpo contra antígeno de envoltura de hepatitis B (Anti-HBe):
– Indica la eliminación a largo plazo de VHB y, por lo tanto, la baja transmisibilidad.
–
Traduce hepatitis INACTIVA.
PCR VHB
♦ Determina la carga viral → PCR detectable a partir de 15 UI/ml
♦ Equivalencia 1 UI/ml → 5.3 copias /ml
♦ Marcador de replicación cuantitativo (↑ especificidad)
♦ En pacientes inmunocompetentes, sus títulos se relacionan con el grado de daño hepático y con el riesgo de descompensación, cirrosis y carcinoma.
Algoritmo de pruebas diagnósticas:
♦ Tamizaje: medir HBsAg e IgM anti-HBc
♦ Si HBsAg es positivo: mida HBeAg y PCR - ADN del VHB para determinar la transmisibilidad.

5 (ENARM 2014)
6 (ENARM 2009) (ENARM 2022)
7 (ENAM 2019) (ENARM 2018) (ENARM 2020)
8 (ENARM 2017) (ENAM 2010)
9 (ENARM 2006)
10 (ENARM 2017) (ENARM 2018)
+ - IgM + -
+ - IgG + -
+ - IgG - +
Hepatitis aguda (ESSALUD 2022)
Hepatitis crónica activa
Hepatitis crónica inactiva + + + +/- +/- P. de convalecencia (ENARM 2014)
- - IgM +/- +/- P. de ventana
- + IgG +/- Curado reciente
- + - -Curado lejano o postvacunado (ENARM 2022)
PCR: Carga viral++ - - Mutante precore

Agsup + (HEPATITIS)

IgM core (AGUDA)

Age (ACTIVA)

IgG core (Crónico)

Ac - Age (INACTIVA)

PCR + ESPECÍFICO (CV). Replicación


VACUNADO (>30d) (>10ml)
Ac - Agsup CURADO Pasado Reciente Pasado Lejano



IgG core

IgG core

Agsup y Ac- Agsup
= PERIODO CONVALECENCIA
La seroconversión de HBsAg a AntiHBs indica una resolución aguda de la hepatitis: cuando los dos están positivos, indica periodo de convalecencia (HBsAg + y Anti-HBs +) (ENARM 2014); HBeAg indica que el paciente es altamente infeccioso (marcador de contagiosidad).
Durante el período de la ventana, IgM anti-HBC resulta positivo y HBsAg, negativo. El VHB se denomina mutante precore cuando HbeAg resulta negativo, pero la carga viral es alta detectada por PCR – VHB.
Age y PCR ↑ CV + + +-
Agsup y Ig Mcore
= PERIODO VENTANA
= MUTANTE PRECORE
Tratamiento
Tratamiento antiviral
♦ Hepatitis B aguda: por lo general, el tratamiento farmacológico no está indicado y los cuidados de apoyo son suficientes.
♦ Hepatitis B crónica → indicados en pacientes con enfermedad hepática descompensada y compensada
♦ Elección → Tenofovir (análogos de nucleótidos)
♦ Alternativa → Entecavir (análogos de nucleósidos)
– Cuando hay falla renal (TFG < 50 ml/ min), enfermedad hematopoyética u osteoporosis
♦ Respuesta favorable al tratamiento
– Normalización de enzimas hepáticas
– Seroconversión (serologías cada 3 meses):
Ag HBe– Anti- Hbe +
PCR DNA -
MEDICAMENTO ANTIVIRAL
DOSIS RECOMENDADA
Tenofovir disoproxil fumarato 300 mg (TDF) 300 mg (1tab) una vez al día
Entecavir 0,5 mg
ESCENARIOS CRITERIOS ESCENARIO 1 ESCENARIO 2 ESCENARIO 3
0,5 mg (1tab) una vez al día 1 mg (2tab de 0,5 mg) una vez al día
ESCENARIO 4 (con edad ≥30 años) ESCENARIO 5
ESCENARIO 6 (con edad <30 años) ESCENARIO 7
CIRROSIS Si No No No No No No
ALT (o TGO) Independiente del resultado ≥2 veces p0or encima del LSN Persistentemente anormal Persistentemente normal Dentro del LSN Persistentemente normal Persistentemente normal
CARGA VIRAL (UI/ml) Independiente del resultado >2000 UI/ml >2000
HBeAg Independiente del resultado Independiente del resultado Independiente del resultado positivo Independiente del resultado positivo negativo
Definir tratamiento e iniciar el proceso
Diferir tratamiento y realizar seguimiento
DECISIÓN Iniciar tratamiento Iniciar tratamiento Iniciar tratamiento Iniciar tratamiento
Diferir tratamiento y realizar seguimiento
Posibilidad de INICIAR TRATAMIENTO
Si existe riesgo de hepatocarcinoma (antecedentes familiar HCC, cirrosis o hepatitis fulminante), reactivación de VHB, manifestaciones extrahepáticas o durante el monitoreo reúne criterios de escenarios 1 a 4
Tabla 19. Criterios para el inicio del tratamiento de infección crónica por VHB (escenarios según las directrices de MINSA).
Prevención
Inmunización activa (vacuna)
♦ Vacuna recombinante (extrayendo del DNA viral el gen S que codifica para el HBsAg)
♦ Tres dosis intramusculares en el deltoides (0, 1, 6 meses)
♦ Se evalúa la inmunoprotección con los títulos de Anti-HBs 11 .
♦ Títulos protectores más de 10 mUI/ml de Anti-HBs 12
♦ No es teratogénica, puede ser administrada durante el embarazo.
Inmunización pasiva (gammaglobulina hiperinmune) → reduce la frecuencia de enfermedad clínica, pero no previene la infección.
♦ Perinatal: recién nacido de madre portadora (Ag HBs +) (junto con vacunación)
♦ Posexposición: contacto sexual esporádico, punción percutánea accidental
♦ Pretrasplante hepático de sujetos HBs Ag positivos
Pronóstico
Factores de buen pronóstico
♦ Niveles ↑ TGP previos al tratamiento
♦ Niveles ↓ DNA previos al tratamiento
♦ Infección adquirida en el adulto
♦ Histología de hepatitis activa
♦ Sexo femenino
♦ Anticuerpos VIH y VHD negativos
Por lo general, se resuelve después de algunas semanas, pero puede durar hasta 6 meses.
Si los síntomas persisten durante > 6 meses, la infección por VHB se considera crónica y puede evolucionar a cirrosis y hepatocarcinoma.
Definición
Hepatitis C aguda: infección por VHC que se desarrolla durante los primeros 6 meses después de la exposición
Hepatitis C crónica: infección por VHC que persiste > 6 meses después de la exposición
Epidemiología
Progresión clínica: 75-85 % de los individuos con infección por VHC desarrollan enfermedad crónica → cirrosis → hepatocarcinoma
En recién nacido de madre portadora (Ag HBs +), se administra gammaglobulina y vacuna.
Patógeno
♦ Virus de la hepatitis C (VHC) → virus de ARN del género Hepacivirus y la familia Flaviviridae Transmisión
♦ Parenteral
– Compartimiento de agujas entre los usuarios de Drogas EV
– Exposición en trabajadores de la salud
– Transfusión de sangre (antes del año 1992 en el mundo, antes del año 2000 en el Perú) 1
Causa más frecuente de hepatitis post-transfusional 2
– Hemodiálisis
– Personas que se someten a modificaciones corporales como tatuajes y perforaciones corporales
– Trasplante de órgano
♦ Sexual: raro
♦ Transplacentaria o vertical → transmisión de madre a hijo (perinatal)
Periodo de incubación: 2 semanas a 6 meses



1 (ENARM 2016)
2 (ENARM 2016)
Los pacientes con un historial médico que indica un alto riesgo de infección por VHC deben ser testeados (drogadictos, politransfundidos, hemodiálisis) (ENARM 2016)
Curso agudo
♦ Asintomático en el 80 % de los casos (importante tamizaje > 40 años)
Curso crónico
♦ Especialmente en individuos asintomáticos (hasta el 85 %), ya que la enfermedad puede no estar diagnosticada y el tratamiento puede retrasarse o nunca iniciarse (estado portador).
♦ Hallazgos a menudo no específicos (fatiga)
♦ Cirrosis hepática (evolución crónica)
♦ Características extrahepáticas:
– Hematológico: crioglobulinemia mixta, linfoma no Hedían de células B, PTI, anemia hemolítica autoinmune
– Renal: glomerulonefritis membranoproliferativa (más común)
– Dermatológico: porfiria cutánea, liquen plano
– Endocrino: diabetes mellitus, tiroiditis autoinmune
– Vascular: vasculitis leucocitoclástica
ELISA: pruebas de inmunoensayo estándar para anticuerpos anti-VH
♦ Positivo en casos de infección por VHC aguda, crónica y previa 3
♦ En inmunodeprimidos, puede ser indetectable.
♦ El factor reumatoide puede dar falsos positivos.
Tratamiento
Hepatitis C aguda

Figura 102. Infección crónica por el virus de la hepatitis C. El acúmulo de células inflamatorias en la placa limitante (la primera fila de hepatocitos que rodea el tracto portal) se denomina hepatitis de interfaz.
PCR para el ARN del VHC si los anticuerpos son positivos.
♦ Si PCR positivo: la infección por VHC activa (puede ser aguda o crónica)
♦ Marcador más precoz (+ sensible)
♦ Mejor método para detectar infección activa por el virus de la hepatitis C
♦ Terapia antiviral: los mismos regímenes que para la infección crónica del VHC Hepatitis C crónica
♦ Objetivos de tratamiento → erradicación del ARN de VHC en suero
♦ Regímenes de tratamiento
♦ Combinación de dos antivirales de acción directa (nunca monoterapia)
– Sofosbuvir + Velpatasvir (esquema pangenotípico)
– Sofosbuvir + Daclatasvir
– Sofosbuvir + Ledipasvir (genotipos 1, 4, 5 y 6) Interferón alfa + ribavirina (terapia clásica)
– 6 meses → genotipo 2 – 3 (buen pronóstico)
– 12 meses → genotipo 1 – 4 (peor pronóstico)
– Vacunas para la hepatitis A y B
Cuando ELISA – y PCR + para VHC, puede tratarse de periodo de ventana o en casos de inmunosupresión (VIH).
Elisa (Anti-VHC) PCR (CV)

Esquema
Sofosbuvir/Velpatavir 400/100 mg (en presentación individual DFC)
Sofosbuvir/Daclatasvir 400/60 mg (en presentación individual DFC)
Pronóstico
Factores de buen pronóstico
♦ Genotipo 2/3
♦ Carga viral baja
♦ Ausencia de cirrosis
♦ Menor edad (pacientes jóvenes)
♦ Menor peso corporal
♦ Respuesta virológica precoz
Epidemiología
Dosificación
1 tableta/día por 12 semanas
1 tableta/día por 12 semanas
El interferón y la ribavirina están asociados con efectos adversos severos (por ejemplo, artralgias, trombocitopenia, leucopenia, depresión y anemia) y teratogenicidad.
El 5 % de todos los pacientes con VHB infectados crónicamente son portadores del virus de la hepatitis D.
Etiología
Patógeno
♦ Virus de la hepatitis D (VHD) → partícula viral incompleta → requiere HBsAg de VHB para ingresar a célula huésped
♦ Virus delta de cadena ARN monocatenario (defectuoso)
Transmisión:
♦ Sexual, parenteral, perinatal
Periodo de incubación
♦ Coinfección: 1-6 meses
♦ Superinfección: 2-8 semanas
Por lo general, se resuelve después de algunas semanas, pero puede durar hasta 6 meses.
Sin el tratamiento adecuado, la mayoría de las personas infectadas desarrollarán hepatitis C crónica.
Con el tratamiento adecuado, se cura más del 90 %.
La coinfección con VHB, generalmente, conduce a la hepatitis aguda más grave.
♦ Coinfección → hepatitis B aguda + hepatitis D
♦ Serología → HbsAg + y Anti-HBc IgM + y Anti VHD + La superinfección de un portador de HBsAg crónico aumenta el riesgo de cirrosis hepática y acelera la progresión de la enfermedad.
♦ Superinfección → hepatitis B crónica + hepatitis D
♦ Serología → HbsAg + y Anti-HBc IgM - y Anti -VHD +
Tratamiento
En el caso de los niveles elevados ARN- VHD y ALT=TGP: IFN-a (interferón)
Complicaciones
Idénticas a las de la hepatitis B
Pronóstico
La superinfección se asocia con un mal pronóstico.
Agsup


Ig Mcore

VHB Aguda
VHD

COINFECCIÓN (FHF)

Ig Mcore VHB Crónico
VHD

SUPERINFECCIÓN (90% Cronifica)
Etiología
Patógeno:
♦ Virus de la hepatitis E (VHE) → pertenece a la familia de Hepeviridae y el género Orthohepeviridae
♦ Es un virus pequeño (34 nm de diámetro), sin envoltura, con un ARN monocatenario, de sentido positivo.
♦ Los genotipos 1 y 2 de VHE se encuentran solo en humanos, pero los genotipos 3 y 4 son enfermedades zoonóticas con reservorios tanto en humanos como en animales (cerdos, monos y perros).
Vía de transmisión:
♦ Fecal-oral (sobre todo a través de agua, alimentos contaminados)
Periodo de incubación: 2-8 semanas
Diagnóstico
Puede ser asintomático (especialmente, niños)
Fiebre, malestar
Anorexia, náuseas, vómitos, diarrea
Dolor hipocondrio derecho, leve hepatomegalia, ictericia
Riesgo de cronificación: poco común, solo genotipo 3 o 4 en pacientes inmunodeprimidos (por lo general, en pacientes con trasplantes de órganos sólidos)
Laboratorio:
♦ IgM anti-VHE: infección activa (hepatitis aguda)
♦ IgG anti-VHE: detección pasada (curado)
♦ PCR de ARN de VHE
Cuadro clínico
IgG anti-HEV En Heces
IgM anti-HEV
0 1 2 3 5 4 6 7 8 9 10 11 12 13
Tratamiento
Sintomático (cuidados de apoyo)
Prevención
No hay vacuna disponible.
Complicaciones
Rara vez (anemia aplásica)
Pronóstico
Por lo general, se resuelve en 3 meses por sí solo, sin complicaciones.
Un curso fulminante es relativamente común en mujeres embarazadas con infección por VHE (que ocurre hasta en el 20 % de los casos), y es potencialmente mortal tanto para la madre como para el feto.






Transmisión Fecal - Oral
Sexual, parental, perinatal Parental
Sexual, parental, perinatal Fecal - Oral
periodo de iincubación 2 a 6 semanas 1 a 6 semanas 2 semanas a 6 meses 1 a 6 meses 2 a 8 semanas
Progresión a la cronicidad No Si hasta el 85% si no se trata Si raro (posibilidad en inmunodeprimidos)
Nota Tipicamente se resuelve sin secuelas
Manifestaciones extrahepáticas
Manifestaciones extrahepáticas
Solo si hay coinfección con el VHB
Aumento del riesgo de hepatitis fulminante en el embarazo
Inmunización Si Si No Vacuna VHB No


Definición
La hepatitis autoinmune (HAI) es una forma rara de hepatitis crónica que afecta predominantemente a las mujeres.
Epidemiología
Distribución bimodal: 10 a 20 años y 40 a 60 años
♦ HAI tipo 1: más común en adultos
♦ HAI tipo 2: más común en niños
Sexo: ♀ > ♂
♦ Tipo 1: (4: 1)
♦ Tipo 2: (10: 1)
HAI tipo 1 (80 % de los casos)
HAI tipo 2 (20 % de los casos)
Idiopático → se asocia comúnmente con otras afecciones autoinmunes
HAI tipo 1: tiroiditis de Hashimoto, enfermedad de Graves Basedow, enfermedad celíaca, artritis reumatoide
HAI tipo 2: tiroiditis de Hashimoto, diabetes mellitus tipo 1, vitiligo
Presencia de HLA A1, HLA-B8 y HLA-DR3
Signos de insuficiencia hepática aguda
♦ Ictericia
♦ Dolor hipocondrio derecho
♦ Fiebre
♦ Hepatomegalia
♦ Esplenomegalia
♦ Ascitis
Pruebas de laboratorio
♦ ↑↑↑ALT=TGP 1 y ↑ AST=TGO 2
1 (ENARM 2006) (ENARM 2019)
4 (ENAM 2016) (ENARM 2006, 2005) (ENARM 2023)
Anticuerpos séricos
♦ HAI Tipo 1
– ANA → anticuerpos antinucleares (↑sensibilidad) 3
– ASMA → anticuerpos anti- músculo liso (↑especificidad) 4
♦ HAI Tipo 2
– anti-LKM-1 → anticuerpos microsomales-1 anti-hígado-riñón
– ALC-1 → anticuerpos anti- citosol hepático-1
Biopsia de hígado:
♦ Confirma el diagnóstico en casos de sospecha clínica alta y anticuerpos negativos 5
♦ Histología → hepatitis de interfaz infiltrado linfocitario (plasmocitario) 6
2 (ENARM 2005) 3 (ENARM 2006) (ENARM 2023)
5 (ENARM 2019) (ENARM 2023) 6 (ENARM 2019)

Hepatitis
Tratamiento
Medicamentos inmunosupresores
♦ Primera línea: prednisona + azatioprina
♦ Segunda línea: micofenolato, ciclosporina, tacrolimus
La colangitis biliar primaria (cirrosis biliar primaria) es una enfermedad hepática crónica progresiva de origen autoinmune, que se caracteriza por la destrucción de los conductos biliares intralobulillares.
Etiología
Se considera una enfermedad autoinmune. Asociado con otras afecciones autoinmunes:
♦ Artritis reumatoide
♦ Tiroiditis de Hashimoto
♦ Enfermedad celíaca
El diagnóstico se establece con base en los autoanticuerpos positivos (anticuerpos antimúsculo liso) y hallazgos histológicos sugestivos de hepatitis.
Trasplante de hígado
♦ Indicado en casos de cirrosis hepática descompensada.
Epidemiología
Sexo: ♀ > ♂ (~ 9: 1)
Rango de edad: 30 a 65 años
1 (ESSALUD 2023)
♦ Síndrome CREST (esclerodermia)
♦ Síndrome de Sjögren 1
Los antecedentes familiares positivos son un factor predisponente. Presencia de HLA-DR3 y HLA-DR4
Inicialmente, los pacientes suelen estar asintomáticos.
Fatiga (generalmente, el primer síntoma)
Prurito intenso 1
♦ Palma-plantar al inicio y luego, generalizado 2
♦ Lesiones de rascado (signo de la mariposa)
♦ Síntoma inicial más frecuente
MUJERES DE 35 A 60 AÑOS
ANTICUERPOS ANTIMITOCONDRIALES (AMA-2)
ELEVACIÓN DE LA IGM
MELANOSIS
MALA ABSORCIÓN DE GRASAS

Figura 109. Las 5 M de la colangitis biliar primaria (cirrosis biliar primaria).
3 (ENARM 2007) (ESSALUD 2023) 4 (ENARM 2007)
Pruebas de laboratorio
♦ ↑ Fosfatasa alcalina ↑ GGT 3
♦ Hipercolesterolemia
Anticuerpos antimitocondriales (AMA) (> 95 % casos) 4
Hiperpigmentación (melanosis)
Hepatomegalia
Esplenomegalia
Colestasis → ictericia, coluria, acolia
Malabsorción (deficiencia de vitaminas liposolubles, osteoporosis)
Xantomas y xantelasma

Figura 110. Las placas amarillas bien definidas (xantelasma) son visibles bilateralmente en la cara medial de los párpados superiores → son un hallazgo común en pacientes con hipercolesterolemia.
Electroforesis de proteínas séricas → hipergammaglobulinemia (↑ IgM)
Biopsia hepática
♦ Se realiza en caso de diagnóstico incierto → Si los AMA son negativos pero la sospecha clínica es fuerte

Tratamiento 1 (ENARM 2007) (ESSALUD 2023) 2 (ENARM 2007) (ESSALUD 2023)
Terapia médica
♦ Primera línea: ácido ursodesoxicólico
Tratamiento del prurito → colestiramina, rifampicina, sertralina
Trasplante de hígado
♦ Indicado en casos de cirrosis hepática descompensada.
♦ Tratamiento definitivo
Inflamación crónica progresiva de los conductos biliares intrahepáticos y extrahepáticos.
La causa exacta es desconocida.
Asociaciones autoinmunes:
♦ Colitis ulcerosa
♦ La actividad de la colangitis está inversamente relacionada con la actividad de la colitis.
Presencia de HLA-B8 y HLA-DR3
A menudo, inicialmente asintomático
Colestasis → ictericia, coluria, acolia
Prurito
Fatiga
Pruebas de laboratorio
♦ ↑ Fosfatasa alcalina ↑ GGT
♦ Hipercolesterolemia
Sexo: ♂ > ♀ (2: 1)
Edad: en el momento del diagnóstico, 40 años aproximadamente

Figura 112. Colangiopancreatografía retrógrada endoscópica. Son visibles estenosis multifocales con dilatación → conductos biliares arrosariados.
Los anticuerpos anticitoplasma de neutrófilos perinucleares (ANCA p) (> 80 % casos)
Imagen
♦ Colangiopancreatografía por resonancia magnética → prueba no invasiva de elección
– Hallazgos: estenosis multifocales que se alternan con dilatación (conductos arrosariados)
♦ Colonoscopia → para evaluar la colitis ulcerosa
Biopsia hepática
♦ No es una parte esencial del diagnóstico.
♦ Hallazgo típico: cicatrización concéntrica de “piel de cebolla” y fibrosis de los conductos biliares


obliteración
Terapia médica
♦ Primera línea: ácido ursodesoxicólico
♦ Inmunosupresores → tacrolimus
Mujeres: Hombres
Elevación predominante de pruebas hepáticas
los
Trasplante de hígado
♦ Indicado en casos de cirrosis hepática descompensada.
♦ Tratamiento definitivo y curativo
TGP, TGO F, Alc, -GT F, Alc, -GT
Elevación de las Ig séricas IgG IgM IgG, IgM
Autoanticuerpos ANA-Anti-Músculo liso AMA (Anti Mitocondrial) p-ANCA
Histología
Lesión ductal llorida
Fibrosis y obliteración de los conductos biliares grandes; ductopenia
Terapia de primera elección Inmunopresores (corticoides azatioprinas) Ácido ursodeoxicólico (AUDC) AUDC
HAI: hepatitis autoinmune
CBP: cirrosis biliar primaria
CEP: colangitis esclerosante primaria


Definición
Condición crónica del hígado caracterizada por la fibrosis difusa irreversible más nódulos de regeneración.
Epidemiología
La cirrosis es la causa más frecuente de hipertensión portal en los adultos 1
Sexo: ♂ > ♀ (2:1)
1 (ENARM 2004)
Etiología
Alcoholismo crónico: Es la causa más frecuente (cirrosis micronodular)
Hepatitis viral crónica: La hepatitis B, C y D (cirrosis macronodular) 1
Hepatotoxicidad: Fármacos (amiodarona, metotrexate) aflatoxinas (Aspergillus)
Esteatohepatitis no alcohólica: Asociada con la obesidad y diabetes tipo 2
Enfermedades autoinmunes: Hepatitis autoinmune, cirrosis biliar primaria.
Trastornos metabólicos: Incluyendo hemocromatosis y enfermedad de Wilson.
1 (ENARM 2010)
Las células de Kupffer (macrófagos) destruyen los hepatocitos, activan las células estrelladas hepáticas (células de Ito) y promueven la inflamación.
Las citocinas inflamatorias (TGF-b, PDGF) inducen la apoptosis de los hepatocitos y la activación de las células estrelladas hepáticas que se transforman en miofibrolastos y producen colágeno de forma excesiva (fibrosis difusa)
Exceso de tejido conectivo en la zona periportal y la zona centrolobulillar y la formación de nódulos regenerativos comprimen los sinusoides hepáticos y desencadenan una hipertensión portal intrasinusoidal.

Los pacientes con cirrosis pueden ser asintomáticos (cirrosis compensada).
Por la lesión hepatica:
Insuficiencia hepática: Ictericia, edema, coagulopatía, encefalopatía.
Hiperestrogenismo: Ginecomastia, atrofia testicular, telangiectasias, eritema palmar.
Hipertensión portal:
Esplenomegalia: pancitopenia
Ascitis
Várices gastro esofágicas
Circulación colateral (“cabeza de medusa”)
Peritonitis bacteriana espontánea
Síndrome hepatorrenal
Pruebas de laboratorio: Incluyen pruebas de función hepática alteradas (ALT, AST, bilirrubina elevada, albúmina baja, tiempo de protrombina prolongado).
Índice APRI: modelo bioquímico no invasivo que utiliza los niveles de plaquetas y la enzima aspartato aminotransferasa (AST) para predecir la fibrosis hepática, cuando su valor es superior a 2, indica que podría haber una cirrosis.
Imágenes: La ecografía abdominal con doppler es la mejor prueba inicial, pueden mostrar un hígado nodular y signos de hipertensión portal. TAC de abdomen en pacientes con obesidad. El FibroScan es una técnica de elastografía por ultrasonido que mide la rigidez del hígado (> 25 kPa indica fibrosis), ha demostrado ser superior a otros métodos no invasivos (como APRI y FIB-4) para identificar fibrosis.
Biopsia hepática: gold estándar en casos de duda diagnóstica para determinar etiología específica.

Modelo para la puntuación de la enfermedad hepática terminal (puntuación MELD)
♦ Se utiliza para predecir la tasa de mortalidad a tres meses
♦ Considera 3 parámetros: bilirrubina, INR y creatinina.
Puntuación de Child-Pugh
♦ Se utiliza para predecir la tasa de mortalidad a 1 año
♦ Considera 5 parámetros: bilirrubina y albúmina, el tiempo de protrombina, encefalopatía y ascitis
SCORE CHILD PUGH
Bilirrubina
Albumina
Tiempo de protrombina
Encefalopatía
Ascitis
ESTADIO PUNTOS MORTALIDAD
Índice de MELD Mortalidad
Tratamiento
El tratamiento de la cirrosis hepática depende de la causa subyacente, la gravedad de la enfermedad y la presencia de complicaciones. Incluye:
Tratamiento de la causa subyacente: Abstinencia del alcohol, tratamiento antiviral para hepatitis (VHB, VHC), manejo del hígado graso no alcohólico con pérdida de peso y control metabólico.
Medidas generales: Dieta adecuada, suplementos vitamínicos, evitar ciertos medicamentos (AINES, opiodes, benzodiacepinas)
Profilaxis: betabloqueantes (propranolol) en la hipertensión portal, antibióticos (quinolonas) para la peritonitis bacteriana espontánea, vacunas de rutina: neumocócica, hepatitis A, hepatitis B, influenza, SARS-CoV-2 y tétanos.
Trasplante hepático: Considerado en casos avanzados con insuficiencia hepática (estadio B y C de ChildPugh, score de MELD > 10 puntos)
Ascitis:
Es la complicación que se observa con más frecuencia en la cirrosis.
Acumulación de líquido en la cavidad abdominal (trasudado: gradiente albumina ≥ 1,1 g/dL)
Producida por hiperaldosteronismo secundario (↑presión hidrostática), hipoalbuminemia (↓presión oncótica)
Cursa con distensión abdominal, signo de la oleada, matidez desplazable.
Imagen: Ecografía (> 100 ml) 1
Tratamiento: Dieta hiposódica, diuréticos con espironolactona 100 mg (+importante) junto con furosemida 40 mg y en casos de ascitis a tensión indicamos paracentesis evacuatoria (+ infusión albumina)
la causa más frecuente de muerte en pacientes con cirrosis es la hemorragia varicosa y en segundo lugar infecciones. DATITO
1 (ENARM 2013)
Encefalopatía hepática:
Deterioro neuropsiquiátrico debido a la acumulación de amoniaco (NH3) que produce edeme cerebral (astrocitos)
Factores precipitantes: HDA (más frecuente), infecciones, estreñimiento, fármacos (benzodiacepinas), uremia
Se clasifica en cuatro grados según los criterios de West Haven
♦ Grado 1: euforia, ansiedad, sueño invertido
♦ Grado 2: Letargia, apatía, cofusión parcial, asterixis 2
♦ Grado 3: Somnolencia, estupor, confusión total, asterixis, clonus
♦ Grado 4: Coma, midriasis
Tratamiento: Dieta normoproteica (1 gr/kg), lactulosa (principal recurso terapuetico), antibiótico (rifaximina, metronidazol), flumazenilo.
Peritonitis bacteriana espontánea:
Infección monomicrobiana del líquido ascítico (más frecuente E. coli)
Producida por translocación bacteriana
Cursa con fiebre más dolor abdominal, alteración del sensorio, falla renal 3
Paracentesis diagnóstica 4
♦ Cultivo +
♦ Leucoitos > 500/mm3
♦ Polimorfonucleares (PMN) > 250/mm3
Tratamiento de elección con cefalosporinas de 3 (ceftriaxona, cefotaxima) 5
Profilaxis con quinolonas (ciprofloxacino o norfloxacino), en casos de hemorragia varicosa
Síndrome hepatorrenal (SHR):
Insuficiencia renal funcional en el contexto de cirrosis avanzada.
Cursa con oliguria más insuficiencia de tipo pre renal (Nao < 10mEq/l)
Se clasifica en dos tipos:
♦ SHR tipo 1: rápidamente progresiva (< 2 semanas), mal pronóstico
♦ SHR tipo 2: se presenta con ascitis refractaria a tratamiento diurético
2 (ENAM EXTRA 2022)
3 (ENARM 2006, 2014, 2021) (ENAM EXTRA 2022)
4 (ENARM 2006, 2003, 2012, 2021)
5 (ENARM 2021) (ENARM 2023)
Tratamiento: Expansores de volumen (albumina), terlipresina y trasplante hepático (elección)
Síndrome hepato pulmonar:
Asociado con vasodilatación pulmonar excesiva (mediado ON) e hipoxemia.
Presenta la triada: hipoxia, hepatopatía y derivación intrapulmonar
Cursa con platipnea (disnea en posición erecta), y la ortodesoxia (disminución de oxígeno sanguíneo en posición erecta)
Tratamiento con oxígeno complementario, inhibidores de ON inhalados, el trasplante hepático es el tratamiento de elección.
Hipertensión portopulmonar:
Asociado vasoconstricción y remodelación vascular pulmonar (mediado por endotelina) e hipertensión arterial pulmonar
Cursa con disnea de esfuerzo (más frecuente), dolor torácico y hemoptisis.
Confirmación con una presión media en la arteria pulmonar > 25 mmHg
Tratamiento con inhibidores de la fosfodiesterasa-5, antagonistas de los receptores de endotelina, y análogos de prostaciclina.
Carcinoma hepatocelular:
En pacientes con cirrosis se recomienda el tamizaje con ecografía y dosaje de AFP cada 6 meses.


La hipertensión portal (HTP) se define cuando el gradiente de presión venosa hepática (GPVH) supera los 5 mmHg, cuando es ≥ 10 mm Hg inicia la aparición de complicaciones (formación de várices y ascitis) y > 12 mm Hg se asocia a descompensaciones (hemorragia por várices)
Las causas de hipertensión portal pueden clasificarse en tres categorías principales:
1. PREHEPÁTICAS:
Trombosis de la vena porta (causa de HTP más frecuente en lactantes) 1 Compresión extrínseca de la vena porta (por tumores, linfadenopatías).
2. INTRAHEPÁTICAS:
Presinusoidal
Esquistosomiasis hepática.
Enfermedades hepáticas infiltrativas (sarcoidosis, tuberculosis).
Leptospirosis
Sinusoidal
Cirrosis hepática (la causa más frecuente de HTP en adultos). 2
Hepatitis alcohólica, tóxica, viral.
Postsinusoidal
Enfermedad veno oclusiva (esclerosis hialina)
3. POSTHEPÁTICAS:
Síndrome de Budd-Chiari (trombosis de las venas hepáticas). 3
Pericarditis constrictiva.
1 (ENARM 2007) 2 (ENARM 2004) 3 (ENARM 2012)
Características del aumento del flujo sanguíneo a través de anastomosis portosistémicas:
1. Hemorragia gastrointestinal (várices gastroesofágicas)
2. Hematoquecia (várices hemorroidales o anorrectales)
3. Circulación colateral (“cabeza de medusa”)
4. Esplenomegalia congestiva (trombocitopenia, anemia, leucopenia)
5. Distensión abdominal por ascitis
6. Encefalopatía hepática










El capítulo de INFECTOLOGÍA es considerado un CAPÍTULO INTERMEDIO debido al porcentaje moderado de preguntas que generalmente se incluyen en exámenes oficiales como ESSALUD, ENAM y ENARM. Por lo tanto, es recomendable revisar los temas más relevantes y consolidar los conceptos esenciales. Asigna repasos espaciados y realiza evaluaciones junto con capítulos menores para maximizar la eficiencia de tu tiempo de estudio.






ETIOLOGÍA
S. aureus es una bacteria coco Gram positiva catalasa y coagulasa positivos.
PATOGENIA
Staphylococcus aureus
Enzimas
♦ Catalasa
♦ Coagulasa
♦ Hemolisinas
Toxinas
♦ Hialuronidasa
♦ Lipasa
♦ Penicilinasa
♦ Superantígenos: pueden activar una gran cantidad de células T, lo que resulta en la liberación masiva de citocinas.
♦ Toxina 1 del síndrome de choque tóxico (TSST-1) 1
♦ Enterotoxina B (estable al calor)
♦ Toxina exfoliativa (causa epidermólisis en SPEE)
♦ Leucocidina (causa necrosis de la piel y membranas mucosas)
Proteínas
♦ Factor de aglutinación A: se une al fibrinógeno → activación, agregación y aglutinación de las plaquetas
♦ Proteína A: inhibe la fagocitosis y la fijación del complemento al unirse a la región Fc de IgG
♦ Proteína de unión a penicilina modificada (PBP) en MRSA
♦ Componentes de la superficie microbiana que reconocen las moléculas de la matriz adhesiva (MSCRAMM): facilitan la adherencia de S. aureus a la matriz extracelular del tejido del huésped
♦ Polisacáridos capsulares: promueven la colonización y la persistencia en los tejidos del huésped. 2
Staphylococcus epidermidis
Produce una biopelícula que consta de proteínas y polisacáridos extracelulares.
♦ Protege a S. epidermidis de los mecanismos de defensa del huésped y los antibióticos.
♦ Facilita la colonización de superficies de material protésico y catéteres intravenosos → infecciones asociadas al dispositivo.
Infecciones causadas por S. aureus
Infecciones de piel 3 y tejidos blandos: impétigo, foliculitis, forúnculo, hidrasadenitis, ántrax 4 , celulitis, erisipela, fascitis, piomiositis, mastitis, infección de sitio operatorio. 5
Neumonía estafilocócica 6
Osteomielitis
Osteomielitis crónica
Artritis séptica
Infección de prótesis articular
Bacteriemia y sepsis
Meningitis
Endocarditis
Enfermedades mediadas por toxinas del S. aureus
Intoxicación alimentaria
Síndrome de shock tóxico estafilocócico
Síndrome de piel escaldada o síndrome de Ritter
TRANSMISIÓN
Ingestión de toxinas preformadas en alimentos ricos en carbohidratos como lácteos, productos agrícolas, carnes, huevos y ensaladas.
FISIOPATOLOGÍA
S. aureus produce enterotoxinas termoestables que proliferan en alimentos refrigerados inadecuadamente (carnes enlatadas, mayonesa/ensalada, natillas). 1
Mediado por enterotoxinas A hasta la E del S. aureus. Las toxinas son preformadas en el ambiente.
Período de incubación corto (<6 horas)
CLÍNICA
Resolución de los síntomas después de 24 a 48 horas
♦ GECA leve con una duración que suele ser menor de 12 horas
Predominan los vómitos.
No suele hacer fiebre.
1 (ENARM 2002)

Figura 1. S. aureus con enterotoxinas en alimentos ricos en carbohidratos
El diagnóstico suele ser clínico.
Se pueden detectar las toxinas en la comida y el vómito.
TRATAMIENTO
Evitar la deshidratación con líquidos.
No suele requerir antibióticos.
EPIDEMIOLOGÍA
1 (ESSALUD 2016)
Antiguamente, muy asociado a mujeres con tampones vaginales durante la menstruación. Actualmente, aumento de los casos asociados a taponamiento nasal, infecciones de heridas, infecciones de sitio operatorio y otros.
Los pacientes suelen ser de base sanos.
FISIOPATOLOGÍA
Mediado por la toxina TSST-1 del S. aureus sensibles o resistentes a meticilina 1
CLÍNICA
El TSS suele manifestarse como un pródromo de síntomas inespecíficos, seguidos de hipotensión y progresión rápida (8 a 12 h) hasta la afectación de órganos diana 2
Comienzo
♦ SST estafilocócico
– Etiología menstrual: inicio máximo en los días 3 a 4 de la menstruación
SST posquirúrgico y posparto: generalmente, <48 horas después de la cirugía o el parto
Pródromo
♦ Síntomas similares a los de la gripe: fiebre alta, escalofríos, mialgia, dolor de cabeza, náuseas, vómitos, diarrea
2 (ENARM 2000) (ENARM 2006)
♦ Erupción dérmica: más frecuente en SST menstrual
♦ Erupción máculo-eritematosa transitoria (similar a una quemadura solar)
♦ Comúnmente, involucra las palmas de las manos y las plantas de los pies.
♦ Por lo general, se descama una a dos semanas después del inicio.
♦ Compromiso mucoso
♦ Lengua de fresa
♦ Conjuntivitis no purulenta
♦ Hiperemia orofaríngea
♦ Evidencia de puntos de entrada: cortes superficiales o quemaduras; heridas quirúrgicas


Shock y disfunción de órganos terminales:
♦ Temprano: taquicardia, taquipnea, fiebre alta, estado mental alterado
♦ Tardío 3 :
– Hipotensión
– Relleno capilar retardado
– Empeoramiento del estado mental alterado
– Evidencia de insuficiencia orgánica
– Signos de alteración de la coagulación (púrpura fulminante)
– Ulceración de mucosas

Para sepsis:
♦ Hemograma completo: puede haber leucocitosis con desviación izquierda, anemia, trombocitopenia
♦ Perfil de coagulación: ↑ TP, ↑ TTP, ↓ fibrinógeno, ↑ productos de degradación de fibrina
♦ Perfil hepático: ↑ ALT / AST, ↑ bilirrubina total, ↓ albúmina, ↓ proteína total
♦ Panel metabólico basal
– Suero: ↑ BUN, ↑ creatinina
Hipocalcemia
♦ VBG / ABG: ↑ lactato; AGA puede mostrar signos de insuficiencia respiratoria
La clínica se desarrolla rápidamente dentro de las 48 horas.
Fiebre y escalofríos
Eritrodermia macular difuso
Descamación de 1 a 2 semanas después del exantema
Hipotensión y/o shock
Falla de órganos y/o sistemas
3 (ENAM 2015, 2016, 2018)
Toxinas de S. aureus:
- Toxina A-E: Intoxicación alimentaria
- TSST-1: SSTS
- Toxina exfoliativa A y B: Síndrome de Ritter
♦ Marcadores inflamatorios: ↑ VSG, ↑ PCR
♦ Creatina quinasa: puede estar elevada
♦ Análisis de orina: sedimento urinario, ↑ leucocitos en orina sin ITU (piuria estéril)
Bacteriología
♦ Hemocultivos
♦ SST estafilocócico: típicamente negativo (positivo en <5 % de los casos)
♦ Cultivos específicos
♦ Realice un examen físico completo para identificar cualquier posible sitio primario de infección.
♦ Obtener cultivos de cualquier fuente sospechosa de infección (p. ej., piel, vagina, fosas nasales, heridas).
Reanimación hemodinámica según sea necesario
Identificar y manejar la fuente de infección; obtener cultivos del sitio(s) primario(s) sospechoso(s) de infección.
♦ Examine en busca de lesiones y heridas en la piel.
♦ Retire cualquier cuerpo extraño (tampones, compresas nasales, compresas quirúrgicas).
♦ Drene las acumulaciones de líquido infectadas (abscesos).
♦ Consulta quirúrgica urgente por sospecha de fascitis / miositis necrotizante.
Limitar el efecto de las toxinas y mejorar la eliminación de bacterias.
♦ Inicie la terapia antibiótica empírica para el SST dentro de la primera hora después de la presentación.
♦ Los regímenes de antibióticos deben incluir un antibiótico inhibidor de la síntesis de proteínas que inhiba la producción de toxinas (p. ej., clindamicina y linezolid) y un antibiótico bactericida que se dirija a los organismos causantes (es decir, vancomicina 4 o un antibiótico betalactámico).
♦ Considere la Ig IV como terapia adyuvante en el SST estreptocócico. Consulta urgente de especialistas apropiados.
Considere la posibilidad de ingresar a UCI, ya que los pacientes pueden deteriorarse rápidamente.
Administrar cuidados de apoyo para la disfunción multiorgánica según sea necesario (soporte ventilatorio, hemodiálisis).
Iniciar la terapia antibiótica empírica para el TSS tan pronto como se sospeche el TSS; no espere los resultados de los estudios de laboratorio.
4 (ENAM 2017)
EPIDEMIOLOGÍA
Patología propia de pacientes pediátricos (lactantes)
FISIOPATOLOGÍA
Mediado por las toxinas exfoliativas A y B de Staphylococcus del fago del grupo II, cepas 55 y 71.
Las toxinas se dirigen hacia la desmogleína-1, produciendo separación entre los queratinocitos en la capa granulosa, lo que crea ampollas.

Figura 4. Distribución de las desmogleínas (imagen de la izquierda) y separación de la epidermis superficial por separación de queratinocitos en la capa granulosa en un SPE (imagen de la derecha).
Inicialmente:
♦ Fiebre, malestar e irritabilidad
♦ Sensibilidad de la piel
♦ Eritema difuso o localizado, que a menudo comienza perioralmente
Después de 24 a 48 horas 1
♦ Ampollas flácidas, que se desprenden fácilmente al friccionarlas con una presión leve (es decir, con una apariencia de piel escaldada) → desprendimiento generalizado de la epidermis
♦ El signo de Nikolsky es positivo.
♦ Sin afectación de las mucosas
♦ El agrietamiento y la formación de costras son comunes.

Pruebas de laboratorio: para confirmar el diagnóstico
♦ Leucocitosis
♦ ↑ VSG
♦ Cultivos de sitios potenciales de infección previa (sangre, orina, piel anormal, nasofaringe, ombligo o cualquier otro foco sospechoso)
Biopsia: indicada en casos poco claros, especialmente, cuando se sospecha síndrome de Stevens-Johnson (SSJ) o necrólisis epidérmica tóxica (NET).
♦ Formación de fisuras intraepidérmicas y ampollas en la capa granular
♦ Falta de infiltrado de células inflamatorias
Imágenes: como una radiografía de tórax, para descartar neumonía como fuente original de infección
El síndrome de Stevens-Johnson y la necrólisis epidérmica tóxica se manifiestan con afectación de la mucosa, no así el SPEE.

Admisión hospitalaria
♦ Necesario en la mayoría de los casos
♦ Aislamiento recomendado
♦ Los casos graves (p. ej., grandes áreas de piel desprendida) pueden tratarse en la unidad de quemados o en UCI.
♦ El tratamiento ambulatorio es posible en niños mayores que comen y beben bien con una afectación mínima de la piel Antibiótico IV
♦ Las penicilinas resistentes a la penicilinasa son el fármaco de elección: nafcilina, oxacilina
♦ Vancomicina: en áreas con alta prevalencia de MRSA adquirida en la comunidad (o en pacientes que no responden al tratamiento)
Cuidados de apoyo
♦ Rehidratación de líquidos según corresponda
♦ Cuidado de la piel de apoyo: emolientes que cubren la piel desprendida
♦ AINE, según corresponda para el dolor y la fiebre.
A. En SST
Falla de órgano
Pérdida de extremidades (por hipotensión grave, CID, los vasopresores, entre otros)
SST estafilocócica: tasa de mortalidad 5-10 % (SST estafilocócica menstrual <5 %, SST estafilocócica no menstrual hasta 20 %)
B. Las complicaciones que enfrentan los pacientes con SPEE son similares a las de los pacientes con quemaduras, ya que ambos tienen una barrera cutánea comprometida:
Desequilibrios de líquidos y electrolitos
Desregulación térmica
Infecciones secundarias (p. ej., neumonía, sepsis)
Los estreptococos son bacterias Gram positivas cocos y catalasa negativos.
Se clasifican según la capacidad de hacer hemólisis en alfa (hemólisis parcial), beta (hemólisis total) y gamma (sin hemólisis):
♦ Alfahemolíticos: S. pneumoniae, S. del grupo viridans
♦ Betahemolíticos: S. pyogenes (Grupo A), S. agalactiae (Grupo B)
♦ Gammahemolíticos: S. faecalis, S. bovis
Infecciones por S. Pneumoniae
Reservorio:
♦ Nasofaringe
Factores de virulencia y resistencia:
♦ Polisacáridos capsulares
♦ Proteasa IgA1
Enfermedades:
♦ Otitis media (especialmente, en niños)
♦ Sinusitis
♦ Neumonía
♦ Meningitis
♦ Peritonitis bacteriana espontánea en niños
Antibiótico de elección
♦ Penicilina
♦ Cefalosporina de 3° generación (p. ej., ceftriaxona)
♦ Macrólido (pacientes con alergia a la penicilina)
Los esteroides están contraindicados, ya que la etiología del SPEE es infecciosa.
La oxacilina se usa para S. aureus sensible a meticilina y la vancomicina para S. aureus resistente a meticilina.

Reservorio:
♦ Orofaringe
Cultivo
♦ Disposición en forma de cadena
♦ Anaerobios facultativos
♦ Resistente a la optoquina
♦ Insoluble a la bilis
Factores de virulencia y resistencias
♦ Dextrano: facilita la unión a la fibrina: agregados plaquetarios en las válvulas cardíacas dañadas.
Reservorio:
♦ Nasofaringe
♦ Los humanos son el único anfitrión.
Cultivo:
♦ Disposición en forma de cadena
♦ Lancefield: grupo A
♦ Anaerobios facultativos
♦ Sensible a la bacitracina
♦ Pirrolidonil arilamidasa (PYR) positivo
Factores de virulencia y resistencia
♦ Toxinas
– Exotoxina A eritrogénica
– Estreptolisina O 1
– Estreptolisina S 2
♦ Enzimas
– DNasa: destruye los neutrófilos → potencia la infección y la transmisión
– Estreptoquinasa
– Hialuronidasa
♦ Proteínas
–
Proteína F: proteína de unión a fibronectina que media la adherencia a las células epiteliales
– Proteína M (factor de virulencia): previene la opsonización por C3b
♦ Cápsula de ácido hialurónico: inhibe la fagocitosis
♦ Formación de biopelículas (placa dental) por S. mutans y S. mitis
Enfermedades:
♦ Caries dental (S. mutans y S. mitis)
♦ Endocarditis bacteriana subaguda (S. sanguinis)
♦ Faringitis
Antibiótico de elección
♦ Penicilina
♦ Cefalosporina de 3° generación (p. ej., ceftriaxona)
♦ Macrólido (pacientes con alergia a la penicilina)
Enfermedades
♦ Cabeza y cuello
– Faringitis
– Amigdalitis
– Absceso periamigdalino
– Otitis media
♦ Piel y tejidos blandos (piógenos)
– Erisipela
– Celulitis
– Impétigo (lesiones: costras de color miel o melicéricas) 3
– Fascitis necrotizante
♦ Enfermedad mediada por toxinas
– Escarlatina
– Síndrome similar a un shock tóxico estreptocócico
♦ Complicaciones inmunológicas (después de la infección primaria)
– Fiebre reumática aguda 4
– Glomerulonefritis posestreptocócica
Antibiótico de elección
♦ Penicilina
♦ Cefalosporinas de 1° generación
♦ Cefalosporinas de 2° generación
♦ Macrólido (pacientes con alergia a la penicilina)
(ENARM 2006)
(ESSALUD 2009) 3 (ENAM EXTRA 2021)
(ENARM 2015)
Reservorio
♦ Tracto gastrointestinal y genital
Cultivo:
♦ Disposición en forma de cadena
♦ Lancefield: grupo B
♦ Anaerobios facultativos
♦ Factor CAMP: agranda el área de hemólisis en un cultivo formado por S. aureus
♦ Resistente a la bacitracina
♦ Hipurato positivo
♦ Pirrolidonil arilamidasa (PYR) negativo
Factores de virulencia y resistencia
♦ Cápsula
Enfermedades
♦ Meningitis y neumonía neonatal
♦ Sepsis neonatal, sepsis puerperal (endometritis)
♦ Infección por estreptococos del grupo B de aparición temprana
♦ Infección por estreptococos del grupo B de aparición tardía
Antibiótico de elección
♦ Penicilina G
♦ Ampicilina
♦ Cefalosporinas
♦ Pacientes con alergia a la penicilina:
– Cefalosporinas
– Vancomicina
Reservorio
♦ Tracto gastrointestinal
Cultivo
♦ Diplococos, cadena-como disposición
♦ Lancefield grupo D
♦ Alfa-hemólisis y gamma-hemólisis
♦ Anaerobios facultativos
♦ Pirrolidonil arilamidasa (PYR) positivo
♦ Crecimiento de bilis y NaCl al 6,5% (mayor resiliencia que los estreptococos)
Enfermedades
♦ Puede ser provocado por procedimientos GI / GU
♦ Incluidos los siguientes:
UTI
– Colecistitis
Endocarditis subaguda
♦ Enterococo resistente a la vancomicina (ERV): infección nosocomial
Antibiótico de elección:
♦ Resistencia intrínseca a cefalosporinas y penicilina G
♦ Ampicilina
♦ Vancomicina (pacientes con alergia a la penicilina)
♦ Enterococo resistente a la vancomicina (ERV): linezolid o daptomicina
Infecciones por S. Bovis (actualmente, streptococcus gallolyticus)
Reservorio
♦ Tracto gastrointestinal: aislada hasta en un 10 % de la población (tasas más altas en pacientes con cáncer colorrectal).
Cultivo
♦ Disposición en forma de cadena
♦ Lancefield grupo D
♦ Anaerobios opcionales
♦ Beta-hemólisis o gamma-hemólisis
♦ Crecimiento de bilis, no de NaCl al 6,5%
Factores de virulencia y resistencias
♦ Cápsula
♦ Pil 1: se une al colágeno, permite la unión y colonización de las células huésped
Enfermedades
♦ Bacteriemia
♦ Endocarditis infecciosa en pacientes con carcinoma colorrectal
♦ Carcinoma colorrectal
Antibiótico de elección
♦ Penicilina (p. ej., penicilina G IV)
♦ cefalosporinas de 3° generación (p. ej., ceftriaxona intravenosa) MÁS gentamicina
- ITU que se complica con endocarditis, sospechar en S. faecalis.
- Anciano con cáncer colorrectal que se complica con endocarditis, sospechar en S. bovis.
ETIOLOGÍA
Bacillus anthracis
Bacilo Gram positivo inmóvil y esporulado
Reservorio: tierra y mamíferos
Cultivo
♦ Aerobios
♦ En forma de palo de bambú
♦ Las colonias muestran un halo de proyecciones (cabeza de medusa).
Factores de virulencia y resistencia
♦ Cápsula de polipéptido (contiene d- glutamato), es la única bacteria con una cápsula polipeptídica.
♦ Formador de esporas
♦ Toxina del ántrax, una exotoxina que consiste en lo siguiente:
♦ Toxina del edema
♦ Factor letal
♦ Antígeno protector
EPIDEMIOLOGÍA
Contacto con lana de oveja (carbunco cutáneo)
Inhalación de esporas (carbunco pulmonar)
Ingesta de esporas (carbunco digestivo)
El humano no transmite la enfermedad (es una zoonosis).
FISIOPATOLOGÍA
El Bacillus anthracis libera la toxina del carbunco que necrosa tejidos.
CLÍNICA
Carbunco cutáneo:
♦ Es el tipo más frecuente.
♦ Lesión en zonas de piel expuestas
♦ Pápula (pruriginosa)→ vesícula o ampolla → Úlcera necrótica 1
♦ Edema duro perilesional con linfadenopatía y linfangitis regional
Carbunco respiratorio:
♦ Usado como bioterrorismo.

♦ Síntomas inespecíficos generales y luego respiratorios, de rápida instauración
♦ Cuadro severo de disnea grave e hipoxemia, y se caracteriza por una mediastinitis hemorrágica.
Carbunco digestivo:
♦ Es un cuadro raro.
♦ Hay dos formas: orofaríngea y gastrointestinal.
♦ Cursa con lesión necrótica hemorrágica de la mucosa, por lo que lleva a una hemorragia digestiva.
EXÁMENES
Tinción Gram, cultivo y PCR en muestras de las lesiones
Inmunohistoquímica de tejidos
IgG anti-antígeno protector (anti-AP) por ELISA
Punción lumbar (si hay sospecha de infección sistémica)
Los bacilos Gram positivos esporulados son Bacillus y Clostridium. DATITO
Se ha notificado meningitis en asociación con casos de carbunco cutáneo por inhalación y gastrointestinal. Si te preguntan por un antibiótico para carbunco, debes pensar en ciprofloxacino.
TRATAMIENTO
Antibióticos:
2 (ENAM 2003)
♦ Carbunco cutáneo sin afectación sistémica: ciprofloxacino 2 o doxiciclina o levofloxacino o moxifloxacino, y como alternativas: clindamicina o amoxicilina.
♦ Carbunco sistémico sin meningitis: ciprofloxacino más clindamicina o linezolid
♦ Carbunco con meningitis: ciprofloxacino más meropenem más linozolid.
Antitoxina:
♦ Usado para carbunco sistémico.
♦ Raxibacumab y obitoxaximab
ETIOLOGÍA
Corynebacterium diphtheriae
Es un bacilo Gram positivo inmóvil no esporulado.
Tiene forma de porra y en grupo parecen letras chinas.
Reservorio
♦ Tracto respiratorio
♦ Los humanos son los únicos anfitriones.
Factores de virulencia y resistencia
♦ Toxina diftérica (exotoxina): inhibe la síntesis de proteínas al inactivar EF-2
EPIDEMIOLOGÍA
Persona no vacunada
Contacto con un paciente con difteria o portador
Transmisión por gotitas de saliva o por objetos contaminados
FISIOPATOLOGÍA
Mediado por la toxina diftérica de la bacteria que se une al receptor HB- EGF, bloquea la activación del EF-2 (factor de elongación 2) y produce la muerte celular.
CLÍNICA
Forma respiratoria:
♦ La bacteria llega a la vía respiratoria superior.
♦ Faringitis→ gran inflamación y dolor → pseudomembrana blanquecino grisácea sangrante al tocarla → aumenta la inflamación y adenopatías → “cuello de toro” asociado a estridor, insuficiencia respiratoria y muerte.
♦ Del 20 al 30 % cursa con miocarditis con disfunción Cardiaca.
♦ El 5 % cursa con neuropatías: parálisis del paladar, de paredes faríngeas posteriores, de motor ocular común y del facial.
Forma cutánea:
♦ La bacteria se pone en contacto con lesiones cutáneas.
La “difteria maligna” es una extensa faringitis membranosa más inflamación masiva con aspecto de “cuello de toro”, a la que sobreviene un estridor, insuficiencia respiratoria y muerte.
♦ Úlceras superficiales o llagas crónicas con membranas grisáceas
Hisopado del borde o debajo de la pseudomembrana para solicitar PCR y cultivo Prueba de Elek (detecta cepas toxigénicas)
TRATAMIENTO
Antibiótico
♦ Si tolera la vía oral: eritromicina o penicilina V o azitromicina
♦ Si no tolera la vía oral: penicilina G acuosa o penicilina G procaínica
Antitoxina diftérica
Aislamiento para evitar contagios
Manejo de contactos con antibióticos: eritromicina o penicilina G benzatínica o azitromicina
Prevención con vacuna que se encuentra en la norma técnica


ETIOLOGÍA
Listeria monocytogenes
Es un bacilo Gram positivo móvil no esporulado.


Es una bacteria que normalmente está en la flora digestiva.
Reservorio
♦ Productos de leche no pasteurizada
♦ Carnes frías
Factores de virulencia y resistencia
♦ Motilidad basada en actina
♦ Resistencia al frío: replicación a temperaturas de 4 a 10 ° C
♦ Listeriolisina O

EPIDEMIOLOGÍA
Transmisión por consumo de alimentos contaminados.
También por contacto directo con animales en veterinarios o carniceros. Existe transmisión transplacentaria o en el momento del parto.
FISIOPATOLOGÍA
Es el resultado de la ingestión oral y la subsiguiente penetración de la mucosa intestinal y la infección sistémica. La bacteria tiene predilección por el tejido fetal y placentario; el mecanismo no se comprende bien.
La bacteria se introduce en las células (parásito intracelular facultativo).
A continuación, el organismo utiliza un mecanismo único de propagación de una célula a otra, sin exponerse a un entorno extracelular.
La listeriolisina O, una toxina formadora de poros, es una citolisina dependiente del colesterol y es el principal factor de virulencia.

1 (ENARM 2019)
CLÍNICA
En pacientes sanos, cursan con una gastroenteritis con o sin fiebre, de corta duración y resolución completa. 1
En ancianos e inmunosuprimidos se desarrolla una bacteriemia/ sepsis o MEC
En recién nacidos, se observará la llamada granulomatosis infantiséptica por transmisión transplacentaria o sepsis/MEC por transmisión durante el parto.
La MEC por L. monocytogenes en recién nacidos se hace evidente en la segunda semana de vida.
EXÁMENES
En las gastroenteritis no se suele hacer búsqueda de la bacteria. En la bacteriemia/sepsis se solicita hemocultivo.
En las MEC, se solicita estudio de LCR.
TRATAMIENTO
Las gastroenteritis no suelen requerir antibiótico, pero, si es un paciente es inmunosuprimido o mayor de 65 años, debería recibir amoxicilina o cotrimoxazol por vía oral.
Para bacteriemia/sepsis o MEC, se da ampicilina más gentamicina vía EV o penicilina G más gentamicina EV.
ETIOLOGÍA
Clostridium perfringens
Es una bacteria Gram positiva, bacilo, anaerobio y esporulado
Tienen forma de palillo de tambor.
Muchos son comensales en colon y genitales femeninos.
Reservorio
♦ Tierra
♦ Piel
♦ Tracto gastrointestinal Factores de virulencia y resistencia
♦ Exotoxinas
♦ Toxina alfa de C. perfringens
♦ Enterotoxina (termolábil)
EPIDEMIOLOGÍA
Evento de traumatismo que produce una herida con compromiso vascular (heridas de cuchillo, heridas de bala y lesiones por aplastamiento)
FISIOPATOLOGÍA
La bacteria ingresa gracias al trauma. Al comprometer el suministro de sangre, se forma un ambiente anaeróbico óptimo para el crecimiento bacteriano.
Mediado por toxinas, principalmente toxinas alfa (toxina hemolítica con actividad de fosfolipasa C y esfingomielinasa) y theta (también conocida como perfringolisina O)
La toxina alfa es, en gran parte, responsable de la necrosis y ausencia de respuesta inflamatoria tisular (en los tejidos afectados no hay leucocitos PMN).
El shock se debe a las toxina alfa y theta.

de metileno, gran aumento)
1 (ENAM 2020)
Desarrollo de la clínica muy rápida y grave
Dolor súbito por la isquemia mediada por toxinas
Piel de coloración pálida → bronce → púrpura o roja Desarrolla ampollas claras, rojas, azules o moradas. Crepitación al tacto por la formación de gas 1
Aspecto tóxico → shock, FMO, CID
EXÁMENES
TEM o RMN con presencia de gas en tejidos profundos
Hemocultivos
Histopatología con destrucción tisular, bacterias y ausencia de neutrófilos en tejidos
Desbridamiento quirúrgico
Antibióticos: penicilina G más clindamicina
Cámara de oxigenoterapia hiperbárica


ETIOLOGÍA
Clostridium difficile
Reservorio:
♦ Tracto gastrointestinal Factores de virulencia y resistencia
♦ Toxina A (enterotoxina)
♦ Toxina B (citotoxina)
Asociados habitualmente
Clindamicina
Penicilinas de amplio espectro
Cefalosporinas 2°, 3°, 4° G.
Carbapenémicos
FISIOPATOLOGÍA
1 (ENARM 2022)
La transmisión de la bacteria es vía fecal-oral. Estos cuadros aparecieron poco después del uso generalizado de antibióticos 1
También por antineoplásicos y estasis intestinal poscirugía.
Los cuadros suelen ser en pacientes hospitalizados. La edad avanzada y los supresores gástricos aumentan el riesgo.
Ocasionalmente asociados
Penicilinas de espectro estrecho
Cefalosporinas 1° G.
Cotrimoxazol
Sulfonamidas
Los antibióticos generan una disrupción de la microflora colónica.
Mediado por exotoxinas: toxinas A y B del C. difficile.
La toxina B es 10 veces más potente que la toxina A.
Aumentan la permeabilidad vascular con migración de células inflamatorias.
Alteran las uniones intercelulares y apoptosis.
Hay degradación del tejido conectivo con formación de pseudomembranas.
El nivel de toxinas en heces se correlaciona con la gravedad de la enfermedad.
Existe una cepa “hipervirulenta” de C. difficile conocida como cepa NAP1/BI/027.
Diarrea acuosa de alto volumen y maloliente, con fiebre, dolor abdominal 2
El 5 % cursa con disentería.
Puede progresar a un megacolon tóxico y perforación colónica.
Enfermedad no fulminante:
♦ No grave: leucocitos <15000 cel/ml y creatinina
sérica <1.5mg/dl
♦ Grave: leucocitos >15000 cel/ml y creatinina sérica
>1.5 mg/dl
Enfermedad fulminante: hipotensión o shock, íleo o megacolon
Toxinas en heces
Prueba NAAT
Radiografía de abdomen
Endoscopía digestiva baja: pseudomembranas
Retirar el antibiótico responsable
Precaución de contacto e higiene de manos
Antibióticos
♦ Enfermedad no fulminante: vancomicina VO; alternativa, metronidazol VO
♦ Enfermedad fulminante: vancomicina VO más metronidazol EV



ETIOLOGÍA
N. gonorrhoeae
Es un diplococo Gram negativo 1
Reservorio:
♦ Tracto genital
♦ Los humanos son los únicos anfitriones
Factores de virulencia y resistencia
♦ Proteasa IgA1
♦ Lipooligosacárido (LOS)
2 (ENARM 2015) 1 (ENARM 2014)

♦ Adhesinas: se adhieren a las células epiteliales del huésped (la variación antigénica de los pili permite evitar los anticuerpos neutralizantes que evitarían la reinfección).
EPIDEMIOLOGÍA
La transmisión se da por contacto sexual.
El ser humano es el único huésped.
Es muy contagiosa.
Dos terceras partes son asintomáticos (portadores) y es más frecuente en mujeres.
Factores de riesgo: nueva pareja sexual, múltiples parejas sexuales, no estar casado, ser joven, pertenecer a una población étnica subrepresentada, niveles educativos y socioeconómicos bajos, antecedentes de abuso de sustancias y antecedentes de un episodio previo de gonorrea.
FISIOPATOLOGÍA
La infección por gonococo tiene cuatro etapas:
♦ Adhesión a la superficie de las células mucosas
♦ Penetración o invasión local
♦ Proliferación local
♦ Evasión de la inmunidad del huésped
CLÍNICA
Localizada (Gonorrea)
♦ Incubación de 2 a 10 días
♦ En varones: uretritis con pus, disuria, meato aumentado e irritado. Puede complicarse con epididimitis y prostatitis 2
♦ En mujeres: cervicitis mucopurulenta con disuria, pus, hemorragia del cérvix. Puede complicarse con salpingitis, endometritis, EPI, síndrome de Fitz Hugh Curtis, conjuntivitis neonatal.
Diseminada
♦ Dos terceras partes son mujeres jóvenes y lo más frecuente es que sean asintomáticas.
♦ Si presentan síntomas, hay: fiebre, tenosinovitis, artralgias, petequias, pustulosas, papulosas y lesiones cutáneas.
EXÁMENES
Tinción Gram y cultivo en secreciones
TRATAMIENTO
Localizada: ceftriaxona IM monodosis o cefixima VO monodosis
Diseminada: ceftriaxona EV o cefotaxima EV


El cultivo para N. gonorrhoeae es el cultivo de Thayer- Martin.




ETIOLOGÍA
Neisseria meningitidis
EPIDEMIOLOGÍA
El humano es el único reservorio.
Reservorio:
♦ Nasofaringe
♦ Los seres humanos son los únicos huéspedes (afecta más comúnmente a las personas que viven hacinadas).
PATOGENIA
Factores de virulencia y resistencia
♦ Proteasa IgA1
♦ Polisacáridos capsulares
♦ Lipooligosacárido (LOS): los niveles séricos de LOS se correlacionan con la gravedad de los síntomas
♦ Adhesinas: los pili y las proteínas de opacidad facilitan la colonización nasal → infección sistémica
Transmisión por contacto con secreciones nasofaríngeas
FACTORES DE RIESGO
Contactos domiciliarios, poblaciones cerradas, alcohólicos, esplénicos, y déficit de los últimos factores del complemento y properdina.

Periodo de incubación de 2 a 10 días
Al llegar la bacteria a la orofaringe, desarrolla una infección faríngea con síntomas respiratorios o dolor de garganta, luego migra por vía hematógena.
MEC: en un 55 % de casos, cursa con síndrome meningoencefalítico.
MEC + meningocococemia: en un 30 % de casos, cursa con MEC más afectación cutánea con máculas, petequias o púrpuras.
Meningocococemia fulminante: en un 15 % de casos, curso brusco de shock, CID e insuficiencia suprarrenal.
MEC: estudio de LCR citoquímico, tinción Gram y cultivo
Meningococemia: cultivo o detección de antígenos o ADN en sangre, lesiones cutáneas y LCR
Los cultivos de faringe no tienen valor.
TRATAMIENTO
Cefalosporinas como ceftriaxona EV
Aislamiento
Prevención con vacunas

ETIOLOGÍA
Escherichia coli
Es una bacteria Gram negativa, bacilo entérico
Factores de virulencia comunes
♦ LPS endotoxina → shock séptico
♦ Resistencia a las sales biliares → prolifera en el tracto
gastrointestinal
E. Coli enteropatógena (EPEC)
Reservorio: flora intestinal natural
Características: generalmente, en niños
Factores importantes de virulencia:
♦ Adherencia al epitelio intestinal → destrucción de microvellosidades (inhibe la absorción).
♦ No se produce ninguna toxina.
Enfermedades:
♦ Gastroenteritis
♦ Infecciones nosocomiales, colecistitis, peritonitis
Antibiótico de elección:
♦ Ciprofloxacina o TMP/SMX
E. Coli enterotoxigénica (ETEC)
Reservorio: alimentos y agua contaminados con heces
Características: causa común de diarrea del viajero 2
Factores importantes de virulencia:
♦ Toxina termolábil
♦ Toxina termoestable
Enfermedades:
♦ Gastroenteritis
♦ Infecciones nosocomiales, colecistitis, peritonitis
Antibiótico de elección:
♦ Ciprofloxacina o TMP/SMX
E. Coli invasiva (EIEC)
Reservorio: flora intestinal natural
Características: causa esporádica de diarrea
Factores importantes de virulencia:
♦ Invasión directa del epitelio intestinal y formación de enterotoxinas → diarrea sanguinolenta a (similar a Shigella)
Enfermedades:
♦ Gastroenteritis
♦ Infecciones nosocomiales, colecistitis, peritonitis
Antibiótico de elección
♦ Ciprofloxacina o TMP/SMX
(ENAM 2019)
En diarreas, lo más importante o primero en el manejo es la rehidratación (ENAM 2009, 2016)

E. Coli enteroagregativa (EAEC)
Reservorio: alimentos y agua contaminados con heces
Características: suele provocar diarrea persistente
Factores importantes de virulencia:
♦ La agregación (patrón “apilados-ladrillo”) uno con el otro y la adhesión a intestinal mucosa → inflamación → diarrea acuosa
Enfermedades:
♦ Gastroenteritis
♦ Infecciones nosocomiales, colecistitis, peritonitis
Antibiótico de elección
♦ Ciprofloxacina o TMP/SMX
E. Coli enterohemorrágica (EHEC)
Reservorio: carne poco cocida, vegetales de hojas crudos
Características: serotipo más común: O157: H7
Factores importantes de virulencia:
♦ Toxina similar a Shiga: diarrea sanguinolenta
♦ Mayor liberación de citocinas (principalmente células epiteliales renales) → SHU (sin invasión de células huésped)
Enfermedades:
♦• Gastroenteritis
♦• Infecciones nosocomiales, colecistitis, peritonitis
Antibiótico de elección
♦ Ciprofloxacina o TMP/SMX
Reservorio: flora intestinal natural
Características: causa más común de infecciones urinarias
Factores importantes de virulencia:
♦ P fimbria (pili asociados a pielonefritis): se unen específicamente al epitelio
urogenital cistitis, pielonefritis
Enfermedades:
♦ Cistitis
♦ Pielonefritis
Antibiótico de elección
♦ Ciprofloxacina o TMP/SMX
E. Coli causante de meningitis neonatal
Reservorio: flora intestinal natural Características: segunda causa más frecuente de sepsis y meningitis neonatal
Factores importantes de virulencia:
♦ Polisacárido capsular K1: protege contra la fagocitosis
Enfermedades:
♦ Meningitis neonatal
♦ Neumonía
Antibiótico de elección
♦ Ampicilina o cefalosporinas de 3.ª generación (Ej., cefotaxima)
MÁS gentamicina
ETIOLOGÍA
Klebsiella pneumoniae
Reservorio: flora intestinal natural
Factores importantes de virulencia:
♦ Polisacáridos capsulares → cápsula mucoide grande
♦ Ureasa
♦ Resistencia a múltiples fármacos
EPIDEMIOLOGÍA
Factores de riesgo: alcohólicos, diabetes mellitus, EPOC.

E. coli es la bacteria comensal más frecuente.
La diarrea del viajero puede reducirse mediante el uso profiláctico de rifaximina (ENARM 2010).
CLÍNICA
Neumonía extrahospitalaria
Es una neumonía grave
Cursa con necrosis, abscesos y empiema
Afecta principalmente lóbulo superior derecho
Tos con expectoración purulenta y aspecto en “jalea de grosella”
EXÁMENES
Radiografía de tórax: consolidado con aspecto de “neumonía pesada”
TRATAMIENTO
Carbapenem o fluoroquinolonas o cefalosporinas de IV generación
ECET es la causa más frecuente de diarrea del viajero, la causa más frecuente de diarrea acuosa aguda en niños mayores de 2 años y en adultos (ENARM 2006)
ECEH serotipo O157H7 es la bacteria más relacionada al síndrome hemolítico urémico.
- E. coli enterotoxigénica, E. coli enteropatógena, E. coli enteroagregativa afectan el intestino delgado y producen diarrea acuosa
-E. coli enterohemorrágica, E. coli enteroinvasiva afectan el intestino grueso y producen diarrea disentérica.
ETIOLOGÍA
Salmonella typhimurium y Salmonella entiridis
Factores importantes de virulencia:
♦ Motilidad flagelar
♦ Cápsula Vi: evasión de la quimiotaxis de los neutrófilos
♦
• Endotoxina
Reservorio: Animales.
EPIDEMIOLOGÍA
Transmisión vía oral por consumo de huevo, mayonesa, cremas pasteleras, productos lácteos. 1
Es una zoonosis.
FISIOPATOLOGÍA
Las bacterias llegan al intestino e invaden la mucosa produciendo inflamación y sangrado.
Del intestino, luego pasan a la sangre (bacteriemia).
tifoidea
ETIOLOGÍA
Salmonella typhi y Salmonella paratyphi
EPIDEMIOLOGÍA
Es un tipo de fiebre entérica.
El único reservorio es el humano (no es una zoonosis).
Transmisión fecal-oral
El portador crónico elimina la Salmonella en heces u orina por más de 12 meses.
1 (ENAM EXTRA 2022)
2 (ENAM 2012) (EXTRA 2020)
Periodo de incubación de 6 a 48 horas
GECA disentérica
Se suele presentar en brotes.
Dura 3 a 5 días.
Coprocultivo
Hemocultivo
TRATAMIENTO
Líquidos para evitar la deshidratación (es lo primero)
Antibióticos en casos graves o pacientes con alto riesgo (menores de 3 meses, ancianos, usuarios de prótesis, anemia crónica, enfermedad cardiovascular, trasplantados, linfoma, VIH/SIDA) con ciprofloxacino 2 o cefalosporinas.
FISIOPATOLOGÍA
Ingresan por vía oral y llegan al intestino.
Llegan a las placas de Peyer, de ahí migran a ganglios linfáticos y luego a la sangre (bacteriemia).
Después, llegan al hígado o bazo para seguir haciendo bacteriemias secundarias.
Se infiltran en la médula ósea.
También se quedan en la vesícula (más aún si hay cálculo).

Un dato epidemiológico importante es el consumo de alimentos en ambulantes.
CLÍNICA
Periodo de incubación de 1 a 2 semanas
Clásicamente, se divide en semanas:
♦ Primera semana: fiebre en picos en ascenso
♦ Segunda semana: fiebre mantenida muy elevada. Roséola tífica (máculas rosadas, fugaces que desaparecen con la vitropresión), cefalea y estado estuporoso o tífico. Lengua tostada, bradicardia relativa (signo de Faget), esplenomegalia. Diarrea de color verdoso o estreñimiento pertinaz. 1
♦ Tercera semana: caen síntomas, pero pueden aparecer complicaciones: perforación y hemorragia intestinal, meningismo, colecistitis aguda, glomerulonefritis 2
♦ Cuarta semana: período de defervescencia. Resolución. Pueden aparecer recidivas, con menor repercusión clínica.
Aglutinaciones (usarlo como prueba inicial), se hacen positivo en la segunda semana
Hemograma: leucopenia con desviación izquierda, se hace evidente en la segunda semana 3
Cultivos:
♦ Hemocultivo principalmente positivo en la primera semana, es la prueba gold estándar 4
♦ Mielocultivo, son positivos casi siempre en todas las semanas, por eso es la prueba más sensible y rentable 5
♦ Coprocultivo y urocultivo son principalmente positivos en la segunda o tercera semana
TRATAMIENTO
No complicada: ciprofloxacino o azitromicina
Complicada: ceftriaxona
Portador crónico: cirprofloxacino 6
Prevención con aislamiento entérico e higiene
ETIOLOGÍA
Shigella sp
Reservorio:
♦ Los humanos son el único hospedero 1
♦ Patógeno obligado
Factores importantes de virulencia:
♦ Toxina Shiga
2011)
Cuatro especies divididas según el antígeno O:
♦ S. dysenteriae (el más grave), S. flexneri (el más frecuente), S. bodyii y S. sonnei (el más leve)
EPIDEMIOLOGÍA
Transmisión fecal-oral
No hay portador crónico.
Factores de riesgo: hacinamiento y malos hábitos higiénicos
Más frecuente en niños.
Clásicamente, la complicación más frecuente es la hemorragia y la más grave, la perforación tífica (se presenta en íleon terminal). (ENARM 2010, ENARM 2011) (ENAM 2006, 2015)
1 (ENARM 2007, 2006) (ENAM 2009)
6 (ENAM 2017) 2 (ESSALUD 2001)
(ENAM EXTRA 2021) 3 (ENAM 2008) 4 (ENARM 2011) 3 (ENARM 2000) 5 (ENARM 2004)
Afecta sobre todo el colon distal.
Tiene toxinas citotóxicas.
CLÍNICA
Puede ser asintomático hasta una disentería basilar. Fiebre, pocas heces con moco y sangre, cólico intenso, tenemos, pujo y vómitos 2
Complicaciones neurológicas (rigidez, convulsiones, irritabilidad), bacteriemia, SHU, síndrome de Reiter 3
EXÁMENES
Coprocultivo con MacConkey, Agar SS, Hektoen
TRATAMIENTO
Líquidos para evitar la deshidratación (lo más importante)
Antibióticos como quinolonas o azitromicina
ETIOLOGÍA
Yersenia pestis
Es la especie más importante de Yersenia.
Tiene forma bipolar en imperdible. Factores importantes de virulencia:
♦ Posibilidad de enriquecimiento en frío
Peste bubónica
♦ Representa el 80 a 95 % de los casos.
1 (ENAM 2010) (ENAM 2020)
Su reservorio animal son los roedores (especie Rattus spp.), también los gatos.
Vector: pulga de la rata (Xenopsylla cheopis)
Transmisión por la picadura del vector, pero también puede hacer transmisión por inhalación de humano a humano cuando hay peste neumónica 1
♦ La picadura no deja una lesión evidente, solo es una picadura inaparente.
♦ Cursa con fiebre, escalofríos, debilidad, cefalea y luego desarrolla el bubón. 2
♦ Un bubón es un ganglio agrandado con compromiso de la piel circundante.
♦ Luego pueden evolucionar a la forma septicémica o neumónica.
Peste septicémica
♦ Representa el 10 a 20 % de los casos.
♦ Puede ser primaria (sin hacer la forma bubónica) o secundaria (después de la forma bubónica).
♦ La forma secundaria es la más frecuente.
♦ Cursa con fiebre, síntomas gastrointestinales y síntomas generales.
♦ Luego cursa con shock, CID y falla de órganos.
Peste neumónica 3
♦ Es una presentación rara, pero casi siempre mortal.
♦ Puede ser primaria (sin hacer la forma bubónica) o secundaria (después de la forma bubónica).
♦ La forma secundaria es la más frecuente; la forma primaria es por inhalación.
♦ Cursa con fiebre, disnea, dolor torácico, hemoptisis y luego la muerte (casi el 100 %).

El lugar más frecuente de los bubones es la región inguinal.
2 (ENAM EXTRA 2022)
3 (ENAM 2010)
Cultivo de muestras del bubón, LCR, esputo o sangre
Tinción con Wright-Giemsa (forma de bastones) o tinción de Wayson (forma de imperdible cerrado), también por inmunofluorescencia
Serológicos: anticuerpo contra el Ag F1
Prueba rápida: Ag F1 Radiografía de tórax
Bubónica
♦ Adultos doxiciclina o cloranfenicol
♦ Niños o gestantes: cotrimoxazol Septicémica o neumónica
♦ Adultos o niños: estreptomicina
♦ Gestante: cotrimoxazol Profilaxis
♦ Adultos: doxiciclina
♦ Niños o gestantes: cotrimoxazol

ETIOLOGÍA
Vibrio cholerae
Tiene forma de coma.
Se divide en serogrupos según el antígeno O.
♦ Los O1 (el principal) y el O139 generan la enfermedad.
Serotipos: Inaba, Ogawa, Hikohjima
Biotipos: Clásico y Tor
EPIDEMIOLOGÍA
Transmisión fecal-oral Requiere un gran inóculo.
FISIOPATOLOGÍA
El V. choleare brinda la toxina del cólera. 1
La toxina se une al receptor gangliósido GM1 del enterocito, activa al adenilato ciclasa y aumenta el AMPc 2
Luego aumenta la secreción de cloro, sodio y agua, produciendo una diarrea secretora 3
CLÍNICA
Tiene un periodo de incubación de 1 a 2 días.
Cursa con diarrea acuosa con moco, blanquecina (aspecto de agua de lavado de arroz) y olor a pescado. Rápidamente, en menos de 24 horas, lleva a un shock hipovolémico 4 .
Si hay vómitos, pero no suele haber fiebre, ni dolor ni tenesmo.
EXÁMENES
Coprocultivo con cultivo TCBS (da una coloración amarillenta)
TRATAMIENTO
Brindar abundantes líquidos para evitar la deshidratación (es lo primero) 5
♦ Vía oral: SRO de alta osmolaridad
♦ Vía EV: solución polielectrolítica de preferencia
♦ Usar NaCl 0.9 % o lactato Ringer en shock Antibióticos
♦ Doxiciclina o tetraciclina 6
1 (ENAM 2003)
4 (ENAM 2015) (ENAM 2017)


La diarrea del cólera tiene aspecto de “agua de lavado de arroz”.
2 (ENARM 2006) (ESSALUD 2009)
5 (ENARM 2007, ENARM 2015)
3 (ENARM 2007)
6 (ENAM 2005)
ETIOLOGÍA
La especie más importante: P. aeruginosa.
Produce pigmento azul-verde piocianina y en agar colonias amarillo-verdosas fluorescentes.
Toxina: exotoxina A (la más potente)
Factores importantes de virulencia:
♦ Cápsula de polisacáridos mucoides → formación de biofilm
♦ Endotoxina → fiebre, shock
♦ Exotoxina A: inactiva la EF-2 → inhibición de la síntesis de proteínas → muerte de las células del huésped
♦ Fosfolipasa C: degrada las membranas celulares
♦ Pioverdina y piocianina: sideróforos que ayudan a Pseudomonas a crecer y proliferar en condiciones de deficiencia de hierro → generan especies reactivas de oxígeno
♦ Las resistencias intrínsecas y adquiridas son comunes, algunas cepas son multirresistentes.
EPIDEMIOLOGÍA
Actúa como oportunista.
La mayoría se adquiere en hospitales, produciendo infecciones graves.
Prefiere ambientes húmedos.
Factores de riesgo: inmunodepresión, alteraciones de barrera, alteración de la flora bacteriana normal.
INFECCIONES:
Ectima gangrenoso: lesión dolorosa, ulcerada/ hemorrágica, rodeada de eritema y edema.
Otitis externa maligna: otitis necrosante, otorrea purulenta, otodinia, osteomielitis. En diabéticos, también se produce otitis externa difusa.
Úlceras corneales: por abrasiones o lentes de contacto que usan soluciones de limpieza.
Artritis y osteomielitis: factores de riesgo, los ADVP
ITU: cuando hay sondaje, uropatía obstructiva, nefrolitiasis.
Neumonía: es más frecuente en pacientes con fibrosis quística, también en pacientes con EPOC, SIDA y neutropénicos.
Bacteriemia y sepsis: es de pacientes inmunodeprimidos (típico de neutropénicos).
Combinación de betalactámico más aminoglucósido 1
1 (ESSALUD 2004)
Antibióticos antipseudomónicos: Ticarcilina + Clavulámico
Piperazilina + Tazobactam
Ceftazidima Cefoperazona
Cefipime
Cefpiroma Aztreonam
Carbapenem Aminoglucósidos
Ciprofloxacino (ENAM 2020)
Colistina
Sinónimos: fiebre mediterránea, fiebre ondulante, enfermedad de Bang, fiebre malta, fiebre de Gibraltar. 1
ETIOLOGÍA
Brucella sp es un Gram negativo muy pequeño. La más frecuente es la Brucella melitensis.
No forma esporas, no tiene cápsula, no tiene flagelos.
ANIMALES ENFERMOS CONTACTO (fetos, secundinas y secreciones vaginales)
1 (ENARM 2010) 2 (ENAM 2004)
EPIDEMIOLOGÍA
Es un tipo de zoonosis, la más común en el mundo. Existe vacuna, pero en animales.
Transmisión directa e indirecta:
♦ Directa por contacto con animales: trabajador de camal, veterinario o criador 2
♦ Indirecta por consumo de derivados lácteos no pasteurizados


CLÍNICA
Periodo de incubación de 1 a 4 semanas
En niños es más benigno que en adultos.
En el embarazo puede producir aborto, parto prematuro y muerte fetal.
Es una enfermedad polimórfica y recidivante.
Clásicamente, se divide en agudo (<8 semanas), subagudo (8 semana a 1 año) y crónico (> 1 año).
Agudo-subagudo 3
♦ Inicio insidioso
♦ Fiebre ondulante y vespertina
♦ Sudoración parcelar y nocturno
♦ Escalofríos
♦ Falta de apetito
♦ Cansancio
♦ Hepatoesplenomegalia
♦ Dolores osteoarticulares
♦ Adenopatías
♦ Puede focalizar en un 20 %.
♦ No presentan síntomas generales, como fiebre, sino que focalizan:
♦ Osteoarticular: el más común, con sacroilitis, espondilitis o miembros inferiores. 4
♦ Genitourinario: orquitis-epididimitis
♦ Pulmonar: bronquitis, neumonitis intersticial, neumonía lobar, etc.
♦ Gastrointestinal: hepatitis granulomatosa
♦ Hematológico: todas las penias (por mieloptisis)
♦ Neurológico: meningitis, encefalitis, mielitis, radiculitis y/o neuritis.
♦ Cardiológico: endocarditis (indica Qx), miocarditis, pericarditis, endarteritis.
♦ Oftalmológico: uveítis.
♦ Dermatológico: lesiones maculares, maculopapular, escarlatiniforme, papulonodular y eritema nodoso
INGESTIÓN (leche cruda y productos lacteos) 3 (ENARM 2012) (ENAM 2016, 2018) 4 (ENARM 2009)
Prueba de tamizaje: prueba de Rosa de Bengala 5
♦ Rápida, cualitativa, detecta IgG1
♦ Alta especificidad para aguda, menos para subaguda y crónica
♦ No tiene utilidad para el seguimiento.
♦ Ante una prueba positiva, hacer P. complementarias.
Pruebas complementarias
♦ Prueba de aglutinación en tubo: detecta IgM e IgG2, un incremento de títulos al cuádruple o más en 15 días de diferencia confirma el diagnóstico 6
♦ Prueba de aglutinación con 2-Mercaptoetanol (2-ME): detecta IgG, sirve para seguimiento de pacientes, ya que, si baja los títulos, indica eficacia del tratamiento.
Cultivos
♦ Hemocultivo es el más específico.
♦ Mielocultivo es el más sensible, más rentable y el gold estándar 7
Radiología
♦ Radiografía lateral de columna: signo de Pedro Pons (desprendimiento del borde anterosuperior vertebral)
♦ RMN: espondilodiscitis

TRATAMIENTO
Adultos y mayores de 8 años:
♦ Doxiciclina más rifampicina por 6 semanas 8
♦ Doxiciclina por 6 semanas más gentamicina 2 semanas
Niños menores de 8 años
♦ Cotrimoxazol más rifampicina
♦ Eritromicina más rifampicina
Gestante o en periodo de lactancia
♦ Cotrimoxazol más rifampicina
♦ Eritromicina más rifampicina
Focalización osteoarticular: sacroiliaca unilateral y art de MMII más frecuente en agudas y espondilitis (más grave) más frecuente en crónicas (más frecuente, lumbares).
El cultivo de Brucella es el medio de Ruiz de Castañeda y tiene crecimiento lento.

5 (ENAM 2014)
6 (ENAM 2006)
7 (ESSALUD 2015)
8 (ENARM 2005) (ESSALUD 2014)
ETIOLOGÍA
Bartonella henselae
Factores importantes de virulencia:
♦ Lipopolisacárido (LPS)
EPIDEMIOLOGÍA
Su reservorio animal es el gato.
El vector de la bacteria es la pulga Ctenocephalides felis.
La transmisión se da por contacto con el animal (gato).

CLÍNICA 1
Lesión o herida de gato
Fiebre
Adenopatía regional autolimitada
Pueden incluir compromiso visceral, neurológico y afectación ocular.
EXÁMENES
Serológicos tipo IgG, el IgM suele ser negativo, ya que aparece muy poco y por poco tiempo.
TRATAMIENTO
Azitromicina por 5 días

Presentación clínica de la enfermedad por arañazo de gato, además de la fiebre. Nótese la lesión y la adenopatía regional.
ETIOLOGÍA
Bartonella quintana
Factores importantes de virulencia:
♦ Lipopolisacárido (LPS)
♦ Sistema de secreción de tipo IV (T4SS)
♦ Adhesinas
♦ Proteínas de unión a la hemina
EPIDEMIOLOGÍA
Tiene como vector al piojo.
Se manifiesta en situaciones de hacinamiento y mala higiene.
Se transmite por la picadura del piojo.
1 (ENAM 2005)
La enfermedad por arañazo de gato se da en pacientes inmunocompetentes; si fuera inmunosuprimido, daría angiomatosis bacilar.
CLÍNICA
Fiebre
Cefalea Malestar general Mareos
Dolor óseo, típico en la tibia
EXÁMENES
Serológicos PCR
Cultivo (definitivo pero difícil)
TRATAMIENTO
Doxiciclina por 4 semanas más gentamicina por 2 semanas


esos ambientes.
ETIOLOGÍA
Bartonella baciliformes
Bacteria Gram negativa, pleomórfica, aeróbica e intracelular
Tiene tropismo por eritrocito (fase hemática) y células endoteliales (fase histioide).
EPIDEMIOLOGÍA
El hombre es el único reservorio.
Tiene como vector al mosquito Lutzomyia verrucarum (1000 a 3000 msnm) 1
La transmisión se da por picadura del mosquito.

La fiebre de las trincheras se da en pacientes inmunocompetentes; si fuera inmunosuprimido, daría angiomatosis bacilar.
1 (ENAM 2005)
La enfermedad de Carrión suele presentarse en la Sierra (por ejemplo, Áncash) (ENAM 2004).
Fase hemática o aguda o fiebre de la Oroya 2
♦ Periodo de incubación de 61 días (10-210 días)
♦ Fiebre
♦ Anemia severa
♦ Síntomas generales como cefalea
♦ Tinte ictérico por la hemólisis
♦ Se suele complicar en la segunda semana, con complicaciones no infecciones e infecciosas como Salmonelosis (tífica y no tífica), reactivación de toxoplasmosis, shigelosis, sepsis por enterobacter y S. aureus, histoplasmosis diseminada, neumocistosis, TBC y malaria 3
Fase histioide o crónica o verruga peruana
♦ Verrugas en zonas expuestas
♦ Más frecuente en niños.
2 (ENARM 2006) (ENAM 2003)
3 (ENAM 2008)
1 (ENAM 2004)

Cultivo es el gold estándar.
Frotis puede dar negativo, por eso, ante sospecha, se debe iniciar con antibióticos hasta el resultado del cultivo.
Aguda
♦ Niños menores de 14 años o 45 kilos y gestantes: amoxicilina más ácido clavulámico
♦ Adultos mayores de 14 años o mayores a 45 kilos: ciprofloxacino 4
Crónica
♦ Niños y gestantes: azitromicina o rifampicina
♦ Adolescentes o adultos: azitromicina o rifampicina o ciprofloxacino

como el


ETIOLOGÍA
Borrelia burgdorferi
Es una bacteria espiroqueta.
EPIDEMIOLOGÍA
Se presenta en pacientes que fueron de excursión, fueron a acampar o de cacería.
Tiene como vector a la garrapata.
CLÍNICA
Se presenta en fases:
Fase local aguda:
♦ Aparece días o un mes después de la inoculación.
♦ Cursa característicamente con eritema crónico migrans.
♦ Cursa con o sin síntomas generales Inespecíficos.
Fase diseminada precoz:
♦ Aparece semanas a meses después.
♦ Cursa con lesiones cutáneas secundarias, fiebre y fatiga.
♦ También puede cursar con meningitis, parálisis, bloqueo AV.
Fase diseminada tardía:
♦ Aparece meses o años después.
♦ Su más común presentación es mona u oligoartritis.
♦ También con acrodermatitis crónica atrófica o encefalomielitis.
TRATAMIENTO
Doxiciclina o amoxicilina VO Ceftriaxona o penicilina EV
ETIOLOGÍA
Leptospira interrogans Es una bacteria espiroqueta.
Reservorio:
♦ Orina animal en el agua (p. ej., ratas, bovinos, ovejas y cabras)
♦ El hombre actúa como un reservorio accidental.
EPIDEMIOLOGÍA
La transmisión se da por contacto de la piel con orina del reservorio, principalmente de roedor.



Si en una pregunta mencionan gasfitero o contacto con roedores, deben pensar en Peste y Leptospirosis (ESSALUD 2022)
CLÍNICA
Tiene 3 presentaciones: anictérica, asintomática e ictérica (Enfermedad de Weil). Además, temporalmente se divide en fase leptospirémica (en la primera semana) y leptospiúrica (después de los 7 a 10 días).
La sintomatología incluye: cefalea, mialgia, dolor abdominal, vómitos, inyección conjuntival, meningismo, uveítis, erupción en piel, fiebre y vómitos. En la forma ictérica, se agrega ictericia, hemorragia, falla renal y miocarditis 1
Aislamiento de la bacteria, el lugar donde buscarla depende de la fase:
♦ 1° fase: buscarla en sangre y LCR
♦ 2° fase: buscarla en orina
Los serológicos son útiles en la segunda fase.

Además de la fiebre, la conjuntivitis y el dolor en pantorrillas es muy característico de la leptospirosis (ESSALUD 2022)
La triada de la enfermedad de Weil es ictericia, hemorragia y falla renal.


Cuadro leve:
♦ Adultos: doxiciclina o amoxicilina o eritromicina
♦ Gestantes o niños: amoxicilina o eritromicina
Cuadro moderado a grave:
♦ Adultos: penicilina G sódica 2 o ampicilina o ceftriaxona o ciprofloxacino
♦ Niños menores de 40 kilos: penicilina G sódica o ampicilina o ceftriaxona
♦ Gestante: igual que adulto, pero no ciprofloxacino
ETIOLOGÍA
Rickettsia felis
EPIDEMIOLOGÍA
Se han reportado casos en Tacna.
Tiene como vector a la pulga del gato (Ctenocephalides felis).
Tienen como reservorio animal al gato.
CLÍNICA
Fiebre
Cefalea
EXÁMENES
Aislamiento bacteriano
La principal causa de muerte es la neumonitis hemorrágica. DATITO
1 (ENARM 2013) (ENAM 2013, 2017, 2018) (ESSALUD 2016) (ESSALUD 2023) (ESSALUD 2022) (ENAM EXTRA 2022)
2 (ENAM 2020)
Mialgias
Erupción macular
Prueba de aglutinación de Weil-Felix PCR
TRATAMIENTO
Niños, adultos y gestante: doxiciclina
ETIOLOGÍA
Treponema pallidum
Es una bacteria espiroqueta.
Sífilis primaria:
Su reservorio es el humano.
La principal transmisión en pediatría es vertical. La principal transmisión en adultos es sexual, aunque también por trasplantes o transfusiones.
También conocido como chancro duro o chancro luético 1
Aparece 4 semanas después del contacto.
Su lugar más frecuente en varón es el surco balanoprepucial y en mujeres, el cérvix. 2
Cursa con una pápula que luego se ulcera, con bordes bien delimitados y elevados, limpia, indolora y adenopatía regional indolora. 3
Remite sola en 4 a 6 semanas.
Sífilis secundaria: 4
Aparece 2 a 8 semanas después de la primaria.
Cursa con síntomas generales y, principalmente, lesiones cutáneas con máculas, rash palmo-plantar o condilomas. También cursa con adenopatías generalizadas.
Sífilis latente:
Se puede dividir en precoz (<1 año), la cual puede cursar aún con lesiones cutáneas secundarias, y tardía (>1 año), la cual suele ser asintomática.
Sífilis terciaria
Esta cursa con gomas (en piel, tejido submucoso, hueso), neurosífilis (asintomático, meningitis, sífilis meningovascular, tabes dorsal), afectación cardiovascular (aneurismas e insuficiencia aórtica).


Las pruebas se suelen dividir en treponémicas y no treponémicas:
Treponémicas: FTA-abs 5 , MHA-TP, LIA, TP-PA, EIA, CIA.
No treponémicas: VDRL, RPR, USR 6
TRATAMIENTO
Sífilis 1°, 2° y latente precoz: PGB 2,4 millones IM 1 dosis; si hay alergia a penicilina, dar doxiciclina 7 o tetraciclina por 2 semanas.
Sífilis tardía, ineficacia del tratamiento, VIH: PGB 2,4 millones IM 1 dosis/ semana por 3 semanas; si hay alergia a penicilina, dar doxiciclina o tetraciclina por 4 semanas.
Neurosífilis: PGA 18-24 millones/día EV por 10 a 14 días o PGP 2,4 millones/ día IM + probenecid VO por 10 a 14 días; si hay alergia a penicilina, se debe desensibilizar o dar ceftriaxona.


Definición
Infección que se desarrolla después de 48 horas 1 de hospitalizado hasta 10 días posteriores al alta 2
La infección no debe estar presente ni en incubación al momento del ingreso
Epidemiología
La principal vía de transmisión directa es por las manos.
La transmisión indirecta por fómites, secreciones y la vía aérea son menos importantes.
Factores de riesgo:
♦ Intubación
♦ Catéter venoso central 1
Etiología
Gram negativos como E. coli y Pseudomona
♦ Catéter venoso periférico
♦ Catéter urinario
Gram positivos como S. aureus, S epidermidis y enterococos
Hongos como Cándida sp.
Ante una septicemia, debe solicitarse hemocultivo para aislar al agente. (ENAM 2015)
Petersdorf, Beeson (1961)
1) T>38.3°C en varias ocasiones
2) >3 semanas duración
3) No diagnóstico tras 1 semana de investigación, tanto hospitalario como ambulatorio.
Durack y Street (1991) FOD clásico
♦ Fiebre >38.3°C
♦ Duración mayor a 3 semanas
♦ Evaluación de al menos 3 visitas ambulatorias o 3 días en el hospital FOD nosocomial
♦ Fiebre >38.3°C
♦ Paciente hospitalizado
♦ No fiebre o incubación al ingreso
♦ Evaluación de al menos 3 días con pruebas negativas FOD neutropénica
♦ Fiebre >38.3°C
♦ PMN < 500
♦ Evaluación de al menos 3 días con pruebas negativas
FOD asociado al VIH
♦ Fiebre >38.3°C
♦ Duración de más de 4 semanas para pacientes ambulatorios o más de 3 días en hospitalizados
♦ Evaluación de al menos 3 días con pruebas negativas
♦ Infección por VIH confirmado
Infecciosas:
♦ Tuberculosis
♦ Abscesos intra-abd.
♦ Colecistitis-colangitis
♦ Endocarditis infecciosa
♦ Flebitis por catéter
♦ CMV-VEB
Inflamatorias
♦ LES
♦ Vasculitis
♦ Esclerodermia
Tumores
♦ Linfomas H y no H


Loxosceles laeta
También llamada araña en forma de violín, araña casera o araña del rincón de la casa 1
Es una araña de base inofensiva, pero que muerde al sentir peligro.
Se identifica por su color marrón, patas largas y articuladas y sus 3 pares de ojos.
Ubicación geográfica: América del Sur y del Norte
Buscar el antecedente de mordedura en su domicilio 1

Mediado por la esfingomielinasa-D 1 Cursa con eventos dermonecróticos, hemolítico, procoagulante.
1 (ENARM 2012) (ENARM 2017) (ESSALUD 2023) 1 (ENARM 2014) (ESSALUD 2023) 1 (ENARM 2013)
CARACTERÍSTICAS CLÍNICAS
Forma cutánea 1 :
♦ Mordida inicialmente indolora que se convierte en una placa livedoide, luego una ampolla dolorosa y eritematosa en varias horas.
♦ Decoloración de la piel de color negro azulado, que, generalmente, se observa dentro de las 24 horas.
♦ Formación de una escara de color negro oscuro al final de la primera semana.
Forma visceral:
♦ Anemia hemolítica 2
♦ Falla renal por el daño tubular, debido al pasaje de hemoglobina libre producto de la hemólisis 3
♦ Orina oscura
♦ CID, sangrados y falla multiorgánica 4
TRATAMIENTO
Manejo de la herida: incluye la limpieza de la herida, enfriamiento y analgesia, desbridamiento de tejidos para lesiones necróticas graves, antihistamínicos, corticoides, colchicina, antibióticos (para sobreinfección), vacuna antitetánica.
Diálisis
Dapsona
Antídoto: usarlo lo más pronto posible, antes de las 6 a 12 horas 5

LATRODECTISMO
Lactrodectus mactans
También conocida como araña viuda negra.
Se reconoce por su cuerpo de color negro y su mancha roja en forma de reloj de arena.
1 (ENAM EXTRA 2022)
Ubicación geográfica: se encuentra en muchas regiones del mundo.
Típicamente, el contexto de la mordedura es estar en el campo 1
Veneno: neurotoxina (latrotoxina alfa).
Provoca exocitosis masiva de ACh y norepinefrina.
CARACTERÍSTICAS CLÍNICAS
Local:
♦ Mordida muy dolorosa que se convierte en una mácula roja circular y luego en una lesión en forma de diana con halo central pálido
Sistémico 1 :
♦ Dolor muscular y rigidez de las extremidades, abdomen y espalda.
♦ Pueden ocurrir síntomas neurológicos autónomos.
– Excitabilidad, insomnio, ansiedad, midriasis, alteraciones de la frecuencia cardiaca, vómitos, hiperestesia, hipersecreción, piloerección
1 (ENAM 2009, 2020) (ENAM EXTRA 2022)


La lesión cutánea por loxoscelismo es más agresiva y exagerada con respecto al daño del tejido que la del latrodectismo.
El tratamiento general incluye la limpieza de la herida, enfriamiento y analgesia. Relajante muscular, como las benzodiazepinas tipo diazepam
Antídoto: aplicarlo lo más pronto posible, antes de las 6 a 12 horas 1 .
1 (ENARM 2020)
Las familias venenosas importantes son:
F. Viperidae
G. Bothrops
G. Bothriopsis
G. Posthidium
G. Lachesis
G. Crotalus
F. Elapidae
G. Micrurus
G. Leptomicrurus
F. Viperidae tiene cabeza triangular, ojos elípticos verticales, cuello estrecho y cola corta afinada.
F. elapidae tiene cabeza redonda, ojos ligeramente elípticos diagonales, cuello grueso y cola larga afinada.
CARACTERÍSTICAS CLÍNICAS
Mordeduras secas (mordeduras sin envenenamiento): síntomas locales menores
El envenenamiento conduce a diversos grados de síntomas locales y sistémicos que dependen de la cantidad y toxicidad del veneno.
Hay venenos que tienen actividad proteolítica, coagulante, vasculotóxica, nefrotóxica, vagal, neurotóxica, miotóxica, nefrotóxica.
Se debe vigilar de cerca a los pacientes para detectar signos de inestabilidad cardiovascular y compromiso respiratorio.
No se recomienda la inmovilización por presión ni los torniquetes.
Administración de antiveneno
♦ No se recomienda darlo ante una pobre sospecha de mordedura de serpiente venenosa, solo cuando hay una alta sospecha.
Esto debido a sus grandes efectos adversos: hipersensibilidad, enfermedad del suero.
Por tal motivo, es crucial la aplicación de antihistamínicos y/o adrenalina antes de la aplicación del suero.
El suero es específico para cada una de las mordeduras por serpiente diferente.
Lo ideal es aplicar una dosis y dentro de la primera hora de la mordedura.
En el manejo, es importante vigilar la diuresis. (ENAM 2017)


Los virus del herpes humano (VHH) son miembros de una gran familia de virus ADN (familia Herpesviridae), que infectan a los seres humanos. Los virus del herpes humano se clasifican en tres subfamilias principales:
Subfamilia Alfaherpesvirinae:
♦ Incluye el virus del herpes simple 1 (VHH-1), el virus del herpes simple 2 (VHH-2) y el virus de la varicela zóster (VHH-3).
♦ Tienen un ciclo de replicación rápido y una amplia gama de hospederos.
♦ Persisten en las células ganglionares durante la vida útil del huésped.
Subfamilia Betaherpesvirinae:
♦ Incluye citomegalovirus (VHH-5), VHH-6 y VHH-7.
♦ Tienen un ciclo de replicación lento y un rango de hospederos limitados.
♦ Persiste en granulocitos y linfocitos.
Subfamilia Gammaherpesvirinae:
♦ Incluye el virus de Epstein-Barr (VHH-4) y el virus asociado al sarcoma de Kaposi (VHH-8).
♦ Tienen un potencial oncogénico y un rango de hospedadores muy restringido.
♦ Persiste en los linfocitos B.
Virus del herpes simple 1 (VHS-1 o VHH-1)
EPIDEMIOLOGÍA
Seroprevalencia: ≥ 50 % en adultos
PATOGENIA
Modo de transmisión: saliva, secreciones respiratorias.
Después de la infección primaria, el virus permanece latente en los ganglios nerviosos (por lo general, los ganglios del trigémino)
CLÍNICA
Gingivoestomatitis herpética: típico de niños 1
Herpes orolabial: son episodios de reactivación 2
Otros: eccema herpético, panadizo herpético, encefalitis (más comúnmente causado por el VHH-1 que el VHH-2), queratitis por VHS, conjuntivitis por VHS, esofagitis por VHS, eritema multiforme.

Figura 55. Gingivoestomatitis herpética. Nótese la inflamación de las encías.

Figura 56. Presentación clásica de herpes labial, vesículas múltiples sobre una base eritematosa localizadas en el labio inferior. 1 (ENAM 2004) 2 (ENAM 2009)
DIAGNÓSTICO
Para la gingivoestomatitis herpética y el herpes orolabial, el diagnóstico suele ser clínico. El uso de pruebas depende del lugar de la infección. Pueden usarse: citodiagnóstico de Tzanck, cultivo, antígenos, Elisa y PCR.
TRATAMIENTO
Aciclovir VO 3
Alternativas: famciclovir o valaciclovir
Aciclovir EV: encefalitis
Virus del herpes simple 2 (VHS-2 o VHH-2)
EPIDEMIOLOGÍA
Seroprevalencia: 10-20 % en adultos.
PATOGENIA
Modo de transmisión: relaciones sexuales, perinatal. Después de la infección primaria, el virus permanece latente en los ganglios nerviosos (típicamente ganglios sacros).
CLÍNICA
Herpes genital: es una ITS, cursa con quemazón → parestesias → lesiones eritematosas → vesículas → úlceras → costras. Es muy dolorosa. Cursa con adenopatías dolorosas 4
Otros: eccema herpético, herpes congénito/neonatal simple, meningitis viral (más comúnmente causada por VHS-2 que por VHS-1), paroniquia herpética.
DIAGNÓSTICO
Para el herpes genital, el diagnóstico suele ser clínico.
El uso de pruebas depende del lugar de la infección. Pueden usarse: citodiagnóstico de Tzanck, cultivo, antígenos, Elisa y PCR.
TRATAMIENTO
Aciclovir VO
Alternativas: famciclovir o valaciclovir
En meningitis o herpes neonatal: aciclovir EV

3 (ENARM 2007)
4 (ENARM 2020)
La primoinfección del VHH-1 es la gingivoestomatitis herpética y su reactivación es el herpes orolabial.
El herpes genital en varón es más frecuente en el pene y en mujer, es más frecuente en cérvix y luego en vulva.

PATOGENIA
Modo de transmisión: secreciones respiratorias, líquido vesicular.
Después de la infección primaria, el VVZ puede llegar a ser latente en ganglios de la raíz dorsal, ganglio de Gasser (herpes zóster oftálmico) o ganglio geniculado (herpes zóster ótico).
CLÍNICA
Varicela: es la primoinfección, más frecuente en niños, exantema vesicular de distribución cefalocaudal. Su complicación más frecuente es la sobreinfección bacteriana.
Herpes zóster: es la reactivación, más frecuente en inmunodeprimidos, cursa en un dermatoma con síntomas neurológicos → vesículas → costras. Su complicación más frecuente es la neuralgia posherpética 5
Síndrome de varicela congénita.


Diagnóstico
La primoinfección y reactivación del VHH-2 es el herpes genital, la diferencia es que en el primero va con síntomas generales. El herpes zóster más frecuente es el torácico, hay otros característicos, como oftálmico, ótico.


Para varicela y herpes zóster, el diagnóstico suele ser clínico.
Hay pruebas que se pueden usar, tales como PCR, cultivo y anticuerpos fluorescente directo.
Tratamiento
Síndrome de Ramsay-Hunt: es un herpes zóster ótico más parálisis facial.
DATITO 5 (ESSALUD 2003) (ENAM EXTRA 2022)
La primoinfección del VHH-3 (VVZ) es la varicela y su reactivación es el herpes Zóster.
Varicela: sintomáticos y aciclovir VO.
Herpes zóster: aciclovir VO; si es generalizado o en inmunosuprimidos, se debe dar EV.
Neuralgia posherpética: analgésicos, antidepresivos tricíclicos, carbamacepina, gabapentina o pregabalina.
Tiene inmunización activa y pasiva.
6 (ENAM 2020)
EPIDEMIOLOGÍA
65 % en los niños, adolescentes y adultos jóvenes entre 6 y 19 años.
PATOGENIA
Transmisión por saliva 6 y transfusiones.
Potencial oncogénico: puede inmortalizar y transformar las células B del huésped.
Utiliza el receptor CD21 para causar infección en las células B.
CLÍNICA
Los niños que son pacientes inmunocompetentes suelen ser asintomáticos o subclínicos.
En pacientes inmunocompetentes adolescentes y jóvenes, puede desarrollarse la mononucleosis infecciosa (enfermedad del Beso) 7
♦ Incuba 2 a 6 semanas
♦ Pródromos inespecíficos
♦ Triada clásica: fiebre, faringitis y adenopatías 8
♦ También cursa con visceromegalia y rash cutáneo; tiene resolución espontánea.
♦ Queda con malestar, fatiga y falta de concentración.
♦ Complicaciones como PTI, anemia hemolítica autoinmune, síndrome hemofagocítico.
Los pacientes inmunocompetentes adultos, generalmente, ya son seropositivos.
En pacientes inmunodeprimidos, se puede desarrollar leucoplasia oral vellosa.
♦ Lesiones blanquecinas típicamente en el borde lateral de la lengua.
El VEB también se relaciona con procesos neoplásicos, tales como:
♦ Linfoma de Burkitt 9
♦ Carcinoma nasofaríngeo (especialmente en adultos de ascendencia del sudeste asiático)
♦ Linfoma de Hodgkin (sobre todo, el de celularidad mixta)
♦ Timoma
♦ Carcinoma gástrico
♦ Trastorno linfoproliferativo


7 (ENARM 2009) (ENARM 2015) (ENAM 2018, EXTRA 2020)
8 (ENARM 2018, 2022) (ENAM 2003) (ENAM EXTRA 2023)
La faringitis de la mononucleosis infecciosa es exudativa.
Ante un paciente con herpes zóster o leucoplasia oral vellosa, se debe sospechar en inmunosupresión, como el VIH (ENARM 2020).
La mejor prueba inicial para la mononuclosis infecciosa es la reacción de Paul Bunnel.
9 (ENAM 2003)
DIAGNÓSTICO
Ac heterófilos (reacción de Paul Bunnel): son IgM, están positivos entre 1 semana a 3 meses. Suele ser la primera prueba por solicitar.
Hemograma con linfocitos atípicos más del 10 % y citopenias.
Enzimas hepáticas elevadas 10
Ac Anti-ACV-IgM es un indicador de primoinfección.
Ac Anti-AP-difuso se asocia a carcinoma nasofaríngeo.
Ac. Anti-AP-restringido se asocia a linfoma de Burkitt.
TRATAMIENTO DE MONONUCLEOSIS INFECCIOSA
Reposo, no consumir alcohol.
Corticoides si desarrolla complicaciones autoinmunes.
PATOGENIA:
Modo de transmisión: congénito, relaciones sexuales, transfusiones, trasplantes, saliva, orina
Características: linfocitos grandes atípicos con cuerpos de inclusión intranucleares, que tienen apariencia de ojo de búho
Utiliza integrinas para causar infecciones.
CLÍNICA
En inmunocompetentes: asintomático (queda en latencia) o sintomático, con un síndrome mononucleósido.
Infección congénita o perinatal: congénita (enfermedad por inclusiones citomegálicas) o perinatal (asintomático, faringitis, bronquitis, crup o neumonía intersticial)
En inmunosuprimidos (sobre todo, en VIH/SIDA): retinitis, colitis, esofagitis, neumonía intersticial, adrenalitis, úlceras digestivas, encefalitis, hepatitis.
DIAGNÓSTICO
Muestras de citología o histología: células citomegálicas que contienen una inclusión intranuclear ubicada en la porción excéntrica rodeada por un halo claro con un aspecto de “ojo de búho”.
Otras pruebas: cultivo, PCR y serológicas.
TRATAMIENTO
Primera línea: Ganciclovir, valganciclovir
Segunda línea: Foscarnet, cidofovir

10 (ENARM 2019) (ENARM 2003)
El síndrome mononucleósido del CMV cursa con faringitis, pero sin exudado.
PATOGENIA
Modo de transmisión: saliva
El virus se propaga temprano.
La reactivación del virus latente o la reinfección pueden ocurrir más adelante en la vida (especialmente, si los individuos se vuelven inmunodeprimidos).
CLÍNICA
Roséola infantil
DIAGNÓSTICO
Suele ser clínico.
TRATAMIENTO
Tratamiento sintomático
Virus asociado al sarcoma de KaposI (VHH-8) 11
EPIDEMIOLOGÍA
Mayor en hombres que tienen sexo con hombres (HSH) y pacientes VIH positivos 12
PATOGENIA
Modo de transmisión: relaciones sexuales
Tiene potencial oncogénico 13
Infecta las células endoteliales causando un tumor maligno, multifocal y muy vascularizado.
CLÍNICA
Sarcoma de Kaposi relacionado con el SIDA 14 :
Cutáneo: Forma más frecuente y la presentación inicial habitual. Lesiones cutáneas papulares de diferentes tonos (rosa, rojo, morado, marrón) ubicados con mayor frecuencia en miembros inferiores y cara (nariz).
Visceral: puede afectar casi todos los sitios viscerales. Los más frecuentes son la cavidad bucal, tracto gastrointestinal y sistema respiratorio.
TRATAMIENTO
Tratamiento de la enfermedad subyacente (p. ej., tratamiento antirretroviral en paciente con VIH) con o sin quimioterapia (doxorrubicina liposomal pegilada).

La roséola infantil es más frecuentemente causada por el VHH6 que por el VHH-7.
El sarcoma de Kaposi es la neoplasia maligna más frecuente en adultos con VIH, pero en niños con VIH es el linfoma.
11 (ENARM 2009) (ENARM 2017)
12 (ENAM EXTRA 2023)
13 (ENARM 2014)
14 (ENAM 2005)
La fiebre amarilla es endémica en las regiones tropicales de América del Sur y África subsahariana. Asia, Europa, América del Norte y Australia están libres de fiebre amarilla (excepto en casos ocasionales importados).
Patógeno: virus de la fiebre amarilla
Virus de ARN lineal de sentido positivo, monocatenario
Familia Flaviviridae y género Flavivirus Nucleocápside icosaédrica y con envoltura
Transmisión
Vectores: mosquitos Aedes aegypti y Haemagogus 1 Reservorio principal: humanos y monos 2 Nicho ecológico en el Perú: Rupa-Rupa
Tiene 3 ciclos:
♦ Selvático: mono-mosquito (Haemagogus)-mono
♦ Rural: mono-mosquito-humano
♦ Urbano: humano-mosquito (Aedes aegypti)-humano

1 (ENARM 2009) (ESSALUD 2013) (ESSALUD 2015)
2 (ENARM 2018) (ESSALUD 2012)
Tiempo de incubación: 3 a 6 días.
Características clínicas
♦ La mayoría de las personas infectadas permanecen asintomáticas.
♦ En pacientes sintomáticos: progresión clásica en tres etapas.
1. Período de infección (3 a 4 días)
Inicio repentino de fiebre alta (hasta 41 ° C o 105 ° F)
Dolores de cabeza, escalofríos
Náuseas, vómitos
LABORATORIO:
↑ ALT / AST
Leucopenia
En período de intoxicación
♦ Trombocitopenia, ↑ TTP
♦ Signos de insuficiencia orgánica
PRUEBAS DE CONFIRMACIÓN DIAGNÓSTICA
Según el tiempo de enfermedad:
♦ Antes o igual a 5 días: qRT- PCR, aislamiento viral
♦ Igual o más a 6 días: Ac IgM e IgG
Biopsia hepática
♦ Se utiliza para el diagnóstico definitivo.
2. Período de remisión (hasta 2 días)
Alivio de los síntomas y disminución de la fiebre.
3. Período de intoxicación (solo en aproximadamente el 15 % de los pacientes sintomáticos)
Hemorragia (epistaxis, sangrado de las mucosas, melena, hematuria, vómitos negros) 3
Disfunción multiorgánica (p. ej., insuficiencia renal y hepática aguda) 4
Dolor abdominal, severa ictericia
♦ No debe hacerse mientras el paciente tenga una infección activa por fiebre amarilla.
♦ Puede mostrar cuerpos de Councilman (glóbulos apoptóticos eosinofílicos) o cuerpos de Torres en hígado.
Tratamiento sintomático
No se dispone de un tratamiento antiviral específico.
Evitar los AINEs, que aumentan el riesgo de hemorragia (aspirina, ibuprofeno, naproxeno) en pacientes con infección confirmada o sospecha de fiebre amarilla.
Sobreinfecciones bacterianas (neumonía, sepsis)
Trastornos cardíacos (miocarditis)
3 (ENAM 2017)
4 (ENARM 2000)
El signo de Faget (disminución del número de pulsaciones; mientras que la fiebre permanece elevada) puede encontrarse en la infección por el virus de la fiebre amarrilla (ENARM 2009)
Los principales órganos comprometidos son el hígado y el riñón (ENARM 2000, ENARM 2009)
Distribución: regiones tropicales de todo el mundo
Incidencia
♦ Enfermedad viral más común que afecta a los turistas en las regiones tropicales
♦ ~ 400 millones de infecciones por año en todo el mundo
Patógeno
Virus de ARN cadena simple en sentido positivo
Familia Flaviviridae y género Flavivirus
Nucleocápside icosaédrica y con envoltura
4 serotipos en base a la proteína de envoltura E4: DEN-1, DEN-2, DEN-3 y DEN-4 1
1 (ENARM 2013)
Vector: Aedes aegypti 2
Reservorio: humano
Periodo de incubación: 4-10 días 1
Características clínicas:
2 (ENAM 2012, 2020)
Ciclo: humano-mosquito-humano
Clásicamente, se divide en tres fases: febril, crítica y convaleciente.
♦ Febril: los primeros tres días, por alta viremia, cursa con fiebre y otros síntomas, como malestar general, mioartralgia, dolor retroocular, deshidratación, rash 2
♦ Crítica: entre el cuarto a sexto día 3 , extravasación de líquidos, shock, hemorragias, trombocitopenia 4 y hematocrito elevado, falla de órganos y muerte.
♦ Convaleciente: después del sexto día, reabsorción de líquidos, mejoría del paciente, mejoría de plaquetas y hematocrito.
Clasificación clínica:
♦ Dengue sin signos de alarma: vive o viajo a zona de dengue o infestación del vecto con fiebre menor o igual a 7 días y 2 o más de: cefalea, mialgia, artralgia, dolor ocular o retroocular, náuseas o vómitos, rash o exantema, o leucopenia. 5
♦ Dengue con signos de alarma: dolor abdominal intenso y continuo o dolor a la palpación de abdomen, vómitos persistentes, acumulación de líquidos, sangrado de mucosas y/o piel, estado mental alterado, hipotensión postural, aumento de hematocrito o hepatomegalia. 6 .
♦ Dengue grave: shock hipovolémico o síndrome de dificultad respiratoria por extravasación de plasma, sangrado grave o compromiso grave de órganos. 7
5 (ENARM 2012) (ENARM 2016) (ENAM 2013) (ENAM 2018)
6 (ENARM 2017, 2018, 2021, 2023) (ENAM 2016) (EXTRA 2020, 2021)
DATITO
Los serotipos DEN-2 y DEN-3 se asocian a mayor gravedad. El dolor retroocular es un dato aclínico muy importante para sospechar en dengue.
1 (ENARM 2010)
2 (ESSALUD 2019) (ENAM EXTRA 2023)
3 (ENAM 2017)
4 (ENAM EXTRA 2023)
7 (ENAM 2003)

Laboratorial
Leucopenia
Neutropenia
Trombocitopenia
↑ AST
Elevación de hematocrito
Tratamiento sintomático
Manejo de soporte, no tiene manejo específico 1
Figura 68. Exantema en el dengue. Exantema maculopapular morbiliforme (similar al sarampión). 1 (ENARM 2020) 2 (ENARM 2012) (ENARM 2015)
La infección por otro serotipo durante la convalecencia de otro se asocia a mayor gravedad (ENAM 2004).
Confirmación del diagnóstico
Menor o igual a 5 días de enfermedad: qRT-PCR, aislamiento viral, Ag-NS1 Igual o mayor a 6 días de enfermedad: ELISA IgM e IgG.
♦ Sin signos de alarma y sin factores de riesgo* (Grupo A): manejo en domicilio.
♦ Sin signos de alarma y con factores de riesgo* (Grupo B1): Manejo hospitalario. 2
♦ Con signos de alarma (Grupo B2): Manejo hospitalario.
♦ Grave (Grupo C): Manejo en UCI.
* Factores de riesgo: embarazo, menor de 1 año, mayor de 65 años, obesidad mórbida u otras comorbilidades importantes.
No usar AINEs, AAS, metamizol, corticoides.
En dengue, para el manejo de fiebre, se recomienda paracetamol (ENAM EXTRA 2021)
En la prevención, es importante el control vectorial (ENAM EXTRA 2020)
Infección por VIH: incidencia máxima entre los 20 y los 30 años
Es un virus ARN monocaternario, cadena simple diploide
Familia Retroviridae y género Lentivirus
Tiene envoltura y nucleocápside icosaédrica
Especies:
VIH-1: más común en todo el mundo
♦ Grupo M (el más frecuente), N y O
VIH-2: restringido casi por completo a África Occidental
Función de las proteínas estructurales
El gen pol codifica una poliproteína que consiste en:
♦ Proteasa: escinde las proteínas gag y gag-pol durante la maduración del virión.
♦ Transcriptasa inversa: convierte el ARN viral en dsDNA.
♦ Integrasa: ayuda a insertar los genes virales en el genoma del huésped.
El gen gag para la proteína gag, que consta de:
♦ Nucleocápsidos
♦ Proteínas de la cápside (proteína p24)
El gen env codifica la gp160, que se escinde en glicoproteínas de envoltura:
♦ gp120: se une a las células T CD4+ del huésped.
♦ gp41: ayuda a la fusión y entrada del virus en la célula huésped.
El gen tat (trans-activador de la transcripción) codifica la proteína tat que promueve la transcripción viral.
Sexual: responsable de + 80 % de las infecciones en el mundo
Riesgo por acto sexual
Riesgo para los hombres que tienen sexo con hombres (HSH): 0,5 % para la pareja receptiva
Riesgo para las relaciones sexuales entre hombres y mujeres
♦ 0,1 % para la pareja femenina
♦ 0,05 % para la pareja masculina
Factores modificadores
♦ Carga viral: la transmisión es poco probable si la carga viral es < 400 copias/ml.
♦ Circuncisión: menor riesgo de infección para los hombres circuncidados.
♦ Coinfección: la inflamación genital (coinfección con otros patógenos como el VPH o herpes genital) aumenta la concentración local de virus y, por tanto, el riesgo de transmisión.
♦ Daño en la mucosa genital: aumenta el riesgo de transmisión.
Transmisión parenteral
Compartir agujas
Lesiones por pinchazo de aguja
Sangre infecciosa en mucosas
Transfusiones de sangre
Transmisión vertical: de la madre al niño
Durante el embarazo, más probable en el tercer trimestre.
Durante el parto
A través de la lactancia materna, después del parto
Infección inicial y ciclo de replicación del VIH
1. El VIH entra en el cuerpo, se une al receptor CD4 de las células del huésped con su glicoproteína gp120.
2. La envoltura viral se fusiona con la célula huésped, la cápside entra en la célula.
♦ Para la fusión, deben estar presentes el receptor CD4 y un correceptor (CCR5 en macrófagos, y CCR5 o CXCR4 en células T).
♦ La entrada del virus en los macrófagos a través de CCR5 se produce, principalmente, durante las primeras etapas de la infección, mientras que la entrada a través de CXCR4 se produce en etapas posteriores.
♦ Los individuos sin receptores CCR5 parecen ser resistentes al VIH; estos pacientes tienen una mutación CCR5 homocigota o heterocigota.
3. El ARN de un virión se transcribe en ADN por la transcriptasa inversa viral y luego se integra en el ADN del huésped por la integrasa viral.
4. El ADN viral se replica y los viriones se ensamblan.
5. El virión reutiliza una parte de la membrana de la célula como envoltura y abandona la célula.
Progresión a la inmunodeficiencia crónica
El VIH infecta a los linfocitos CD4+, y luego se reproduce y disemina a otros linfocitos CD4+ cercanos al lugar original de la infección → infección de los linfocitos CD4+ concentrados en el tejido linfoide especializado (los ganglios linfáticos o GALT) → crecimiento explosivo y diseminación → síndrome agudo de VIH con alta carga viral.
Después de la fase aguda, la carga viral disminuye y permanece aproximadamente en ese nivel durante unos 8-10 años (fase de latencia clínica).
Durante la fase de latencia clínica, el virus se replica, principalmente, dentro de los ganglios linfáticos.
La pérdida creciente de linfocitos CD4+ (sobre todo, de células T) deteriora la función inmunitaria y, por tanto, facilita las infecciones oportunistas y el desarrollo de enfermedades malignas (SIDA).
El aumento de la carga viral suele conducir a una disminución del número de linfocitos CD4+ y viceversa.

Adhesión y penetración Descober

Antagonistas CCR5: maraviroc
Inhibidor de la fusión: enfuvir tida
NtRTIs: tenofovir, adefovir
NRTIs: abacavir, didanosina, emtricitabina, lamivudina, estavudina, zidovudina
NNRTIs: efavirenz, nevirapina
Inhibidores de la integrasa: raltegravir, dolutegravir
Inhibidores de la proteasa: lopinavir, ritonavir, indinavir, nel navir
En las primeras etapas de la infección por el VIH, los pacientes suelen ser asintomáticos. Periodo de incubación: 2-4 semanas
Infecciosidad: dos picos (1.º pico: en los primeros meses tras la infección; 2.º pico: durante la fase de SIDA)
Infección aguda por VIH o síndrome retroviral agudo o síndrome similar a la mononucleosis.
Fiebre
Fatiga
Mialgia y artralgia
Cefalea
Linfadenopatía generalizada no sensible
Latencia clínica y SIDA
Erupción cutánea generalizada
Síntomas gastrointestinales (náuseas, diarrea, pérdida de peso)
Síntomas orofaríngeos (dolor de garganta, ulceraciones, dolor al tragar)
Latencia clínica: los individuos infectados pueden seguir siendo asintomáticos.
Condiciones no definitorias de SIDA
♦ Temperaturas subfebriles crónicas
♦ Linfadenopatía generalizada persistente
♦ Diarrea crónica
♦ Infecciones oportunistas localizadas
– Candidiasis oral – Infecciones vaginales
♦ Leucoplasia oral vellosa: lesiones que no se pueden raspar, localizadas principalmente en los bordes laterales de la lengua, desencadenadas por el virus de Epstein- Barr.
♦ Relacionado con el VPH: carcinoma de células escamosas del ano (frecuente en HSH) o del cuello uterino
♦ Manifestaciones cutáneas (p.ej, molusco contagioso, verrugas, exacerbaciones de la psoriasis, herpes zóster)


con
oral. En el lateral izquierdo de la lengua, se observa una placa blanca confluente de 3-5 cm de aspecto velloso, que no desprende al raspado.
Pruebas de tamizaje para VIH
Incluye ELISA, quimioluminiscencia y las pruebas rápidas 1 Los resultados se informan como “reactivo” y “no reactivo”.
Pruebas confirmatorias para VIH 2
Incluye detección de carga viral, la inmunofluorescencia indirecta (IFI) o inmunoblot.
Los resultados se informan como positivas, negativas o indeterminadas para el caso de IFI e inmunoblot, y de manera cuantitativa para la carga viral.
Se considera como paciente con infección VIH a aquellas personas que presenten alguno de los siguientes resultados:
Dos pruebas rápidas de detección de anticuerpos para VIH (tercera generación) de diferentes fabricantes con resultados reactivos.
Una prueba de detección de anticuerpos para VIH (tercera generación) y una prueba rápida de detección de anticuerpos y antígeno para VIH (cuarta generación), con resultados reactivos.
Una prueba rápida para VIH (tercera o cuarta generación) y un ELISA para VIH con resultados reactivos.
Una prueba rápida para VIH (tercera o cuarta generación con resultado reactivo y una prueba confirmatoria (carga viral, IFI o inmunoblot.) positiva.
Una vez definido el caso, se debe iniciar todo el proceso de atención y evaluaciones necesarias para el ingreso temprano al TAR.
Todos los casos identificados deben contar con pruebas de confirmación (carga viral, IFI o inmunoblot.) sin que estos resultados retrasen el inicio temprano del tratamiento cuando se considere pertinente.
1 (ENARM 2016) 2 (ENARM 2011)
La carga viral sirve para determinar el síndrome retroviral agudo (ENAM 2014)
Realizar la prueba del VIH a los pacientes con antecedentes de consumo de drogas intravenosas que presenten una pérdida de peso inexplicable, depresión y/o demencia.
A diferencia de la candidiasis oral, la candidiasis esofágica es una afección definitoria del SIDA.
Prueba de tamizaje

¿Resultado reactivo?

Si No

Reportar como NO REACTIVO

Realizar prueba de tamizaje 2
Si No

Discordancia ver nota de pie

Reportar como REACTIVO

Tomar muestra de CV previo a inicio de TAR
Figura 73 Flujograma de diagnóstico de infección por VIH en adultos, según MINSA-Perú 2020. Ante discordancia con 2 pruebas rápidas, se debe solicitar ELISA o quimioluminiscencia (QL); y ante discordancia con ELISA o QL, se debe solicitar prueba confirmatoria.
El método de ELISA de tercera generación para detectar infección por VIH, frecuentemente, se hace positivo a partir de las 2 a 4 semanas (ENARM 2016)
Prueba Objetivo de detección Tiempo aproximado de positividad (días)
ELISA 1°G IgG 35 a 45 días
ELISA 2°G IgG 25 a 35 días
ELISA 3°G
ELISA 4°G
Western blot
Carga viral
Límite de sensibilidad 50 copias/ml
Carga viral
Corte de ultrasensibilidad 1 a 5 copias/ml
IgM e IgG 20 a 30 días
IgM, IgG y antígeno p24 15 a 20 días
IgM e IgG
35 a 50 días (indeterminado) 45 a 60 días (positivo)
ARN 10 a 15 días
ARN 5 días
Clasificación clínica e inmunológica de la infección por VIH:
Síntomas asociados a la infección por VIH Estadio clínico Valor de CD4 (valor absoluto por mm3)
Asintomático 1 >500
Síntomas leves 2 350 a 499
Síntomas avanzados 3 200 a 349
Síntomas graves 4 (ENAM 2003) <200 (ENAM 2010)
Estadio clínico 1
Asintomático
Linfadenopatía generalizada persistente
Estadio clínico 2
Pérdida moderada de peso idiopática (menos del 10 % del peso corporal presumido o medido)
Infecciones recurrentes de las vías respiratorias (sinusitis, amigdalitis, faringitis, otitis media)
Herpes zóster
Queilitis angular
Úlceras orales recurrentes
Erupciones papulares pruriginosas
Dermatitis seborreica
Estadio clínico 3
Pérdida grave de peso idiopática (más de 10 % del peso corporal presumido o medido)
Diarrea crónica idiopática durante más de un mes
Fiebre persistente idiopática (mayor de 37.5°C, intermitente o constante, durante más de un mes)
Candidiasis oral persistente
Leucoplasia oral vellosa
Tuberculosis pulmonar 3
Infecciones bacterianas graves (como neumonía, empiema, piomiositis, osteomielitis, artritis, meningitis, bacteriemia)
Estomatitis, gingivitis o periodontitis ulcerativa necrotizante aguda
Anemia (<8 g/dl), neutropenia (0.5 x 10 9/L) y/o trombocitopenia crónica (<50 x 10 9/L) idiopática
Estadio clínico 4
Síndrome de consunción por VIH
Neumonía por Pneumocystis 4
Neumonía bacteriana grave recurrente
Infección crónica por herpes simple (orolabial, genital o anorrectal de más de un mes de duración)
Candidiasis esofágica (o candidiasis de la tráquea, los bronquios o los pulmones)
Tuberculosis extrapulmonar
Sarcoma de Kaposi
Infección por citomegalovirus (retinitis o infección de otros órganos)
Toxoplasmosis del SNC 5
Encefalopatía por VIH
Criptococosis extrapulmonar (incluyendo meningitis) 6
Infección diseminada por micobacterias no tuberculosas
Leucoencefalopatía multifocal progresiva
Criptosporidiasis crónica
Isosporiasis crónica
Micosis sistémica (histoplasmosis extrapulmonar, coccidioidomicosis)
Septicemia recurrente (incluyendo por Salmonella no tifoidea)
Linfoma (cerebral o de las células B, no Hodgkin) 7
Carcinoma cervical invasivo
Leishmaniosis atípica diseminada
Nefropatía sintomática asociada al VIH o miocardiopatía asociada al VIH
3 (ESSALUD 2008)
4 (ENARM 2011) (ENARM 2015) (ENAM 2012, 2013, 2018) (EXTRA 2020, EXTRA 2021)
5 (ESSALUD 2016) (ENAM 2016) (ENAM EXTRA 2022)
6 (ENARM 2011) (ENARM 2016) (ENAM 2014, 2018) (EXTRA 2021, EXTRA 2020)
7 (ENARM 2010)
La cifra de linfocitos T CD4 para considerar VIH como estadio de SIDA es menor a 200 (ENARM 2004, ENARM 2009)
El Toxoplasma ingresa al cuerpo por la vía digestiva. (ENAM 2003) DATITO
1 (ESSALUD 2018) (ENAM 2010)
Todas las personas infectadas por el VIH (independientemente del recuento de CD4) deben comenzar la terapia antirretroviral combinada lo antes posible 1
Los fármacos antirretrovirales se combinan para prevenir la resistencia.
Todos los fármacos antirretrovirales son capaces de atacar tanto al VIH-1 como VIH- 2, excepto la enfuvirtida y los inhibidores de la transcriptasa inversa no nucleósidos. Esquemas:
Esquema Fármacos
Elección
Alternativo
Tenofovir 300mg/lamivudina
300mg/dolutegravir 50mg
Tenofovir 300mg/lamivudina
300mg/efavirenz 400mg O
Tenofovir 300mg/emtricitabina
200 mg/efavirenz 600mg
Dosis
1 tableta en DFC cada 24 horas
1 tableta en DFC cada 24 horas
Tabla 05. Esquema de elección y alternativos para infección por VIH, según MINSA-Perú 2020. DFC: Dosis fijada combinada.
Profilaxis para P. jirovecii, diarrea por coccidias y toxoplasma 1
Esquema triple
TDF/FTC (o TDF+3TC) + DRV/rtv (o DRV + rtv)
TDF/FTC (o TDF+3TC) + RAL
TDF/FTC (o TDF+3TC) + ETV
TDF/FTC (o TDF+3TC) + ATV/rtv
TDF/FTC (o TDF+3TC) + LPV/rtv
DRV/r + RAL + ETV
TDF/FTC (o TDF+3TC) + DTG
AZT/3TC + DTG
Esquema dual
LPV/rtv + RAL
Tabla 06. Esquema de segunda línea recomendados, según MINSA-Perú 2020.
Para pacientes en estadio clínico 3 y 4 o con recuentos de CD4 <200 células/microL 2
Cotrimoxazol 160/800 mg 01 tableta VO diaria
♦ Descontinuarla, luego de iniciado el TAR y el recuento de linfocitos CD4 sea mayor a 200 células/microL
Profilaxis con terapia preventiva para tuberculosis (TP TB) 3
Para todos los pacientes, debe iniciarse inmediatamente después de realizado el diagnóstico de infección por VIH y de haber descartado TB activa.
Adicionalmente, se indicará piridoxina 50mg/día VO durante los meses de tratamiento preventivo con isoniacida.
La rifampicina o rifapentina no podrán ser administradas juntamente con un esquema de tratamiento antirretroviral que incluya a un inhibidor de proteasa. En estos casos, se debe considerar el uso de isoniacida sola como TP TB.
2 (ENARM 2014, 2001, 2005)
2 (ENARM 2009)
2 (ENARM 2006, 2009, 2014, 2018) (ENAM 2013)
Esquema de tratamiento
Rifapenina + isoniacida semanal durante 3 meses (12 dosis)
Isoniacida diaria durante 6 meses
Isoniacida + rifampicina diaria durante 3 meses
Rifampicina diaria por 4 meses
Dosis en función del peso corporal
Isoniacida:
Adultos=15 mg/kg
Rifapentina:
>50 kg: 900 mg
32.1-50 kg: 750 mg
25-32 kg: 600 mg
Adultos=5 mg/kg
Isoniacida:
Adultos=5 mg/kg
Rifampicina:
Adultos=10 mg/kg
Dosis máxima diaria
Isoniacida: 300 mg
Rifapentina: 900 mg
300 mg
Isoniacida: 300 mg
Rifampicina: 600 mg
Adultos y niños=10 a 20 mg/kg/ día 600 mg
Los fármacos hepatotóxicos (por ejemplo, nevirapina) están contraindicados en la coinfección con el VHB o el VHC.
La mayoría de los INTR terminan en “-ina”, los inhibidores de la proteasa en “-navir” y los inhibidores de la integrasa en “-gravir”.
Se encuentra en reservorios animales en la mayoría de los países.
Incidencia en todo el mundo: hasta 70 000 personas mueren de rabia cada año.
La rabia está causada por varios miembros diferentes de la familia Rhabdoviridae.
Los rabdovirus tienen forma de bastón o bala.
Género: Lyssavirus
Virus ARN monocatenario
Transmisión
Reservorio animal más común en todo el mundo: perros
Se propaga a través de la saliva del animal rabioso tras la mordedura.
El virus de la rabia se une al receptor ACh de los nervios periféricos en la herida de la mordedura → migra de forma retrógrada a lo largo de los microtúbulos axonales (utilizando la proteína motora dineína) → entra en el SNC → infecta el cerebro
El diencéfalo, el hipocampo y el tronco encefálico son los primeros afectados.

Periodo de incubación: 4-12 semanas (puede durar meses)
SÍNTOMAS PRODRÓMICOS
Síntomas similares a los de la gripe (fiebre, malestar)
Localmente: dolor, parestesia y prurito cerca del lugar de la picadura
RABIA ENCEFÁLICA (80 %)
Hidrofobia: espasmos musculares faríngeos involuntarios y dolorosos al intentar beber; más adelante en la enfermedad, incluso la visión del agua puede provocar náuseas o vómitos.
Síntomas del SNC
♦ Ansiedad, agitación y combatividad, que se alternan con períodos de calma
♦ Confusión y alucinaciones
♦ Fotofobia
♦ Fasciculaciones
♦ Convulsiones
♦ ↑ Tono muscular y reflejos con rigidez nucal
Coma 1 y muerte a los pocos días o semanas del desarrollo de los síntomas neurológicos
RABIA PARALÍTICA (20 %)
Parálisis flácida, que asciende gradualmente y se extiende desde la herida de la mordedura
Paraplejía y pérdida del tono de los esfínteres
Insuficiencia respiratoria y muerte
Diagnóstico Antemortem
Se necesitan cuatro muestras para las pruebas: suero, saliva, LCR y piel.
PRUEBAS DE LABORATORIO
RT-PCR para detectar el ARN de la rabia
Cultivo celular para aislar el virus
El rasgo patognomónico de la rabia es la hidrofobia, producto del espasmo muscular faríngeo.
Esto puede presentarse junto con agitación, comportamiento extraño, cambios en el estado mental y, posiblemente, espuma en la boca.
La rabia paralítica cursa con parálisis ascendente, parecida al síndrome de Guillain Barre.
1 (ENAM 2018)
1 (ENARM 2002) (ESSALUD 2008)
Prueba de anticuerpos fluorescentes (FAT) para detectar el antígeno viral en un frotis o en una sección congelada de una biopsia
Prueba de anticuerpos
♦ Los anticuerpos séricos detectados en individuos no inmunizados y que no recibieron inmunoglobulinas profilácticas postexposición indican el diagnóstico.
♦ El aumento de los niveles de anticuerpos en suero durante varios días en pacientes inmunizados es sugestivo de infección por rabia.
♦ La presencia de anticuerpos en el LCR, independientemente del historial de inmunización, refiere infección por rabia.
PRUEBAS ADICIONALES
Análisis del LCR: hallazgos característicos de la encefalitis.
Diagnóstico
Tinción inmunofluorescente del antígeno viral en el tejido del SNC infectado
Hallazgos histopatológicos: cuerpos de Negri (cuerpos de inclusión citoplasmáticos eosinófilos, que suelen encontrarse en el cerebelo y el hipocampo) 1

Figura 75. Célula ganglionar con cuerpos de Negri.
Profilaxis preexposición
Aunque la presencia de cuerpos de Negri es patognomónica de rabia, su ausencia no descarta infección.
Vacuna VCC en personas con alto riesgo, se dan en 3 dosis (día 0, 7 y 28), por vía IM.
Profilaxis postexposición 1
Manejo de herida con lavado con agua a chorro y jabón 2 ; no suturar la herida
Si se observa al animal, se hará por 10 días.
Determinar si la herida es grave: cara, cabeza, cuello, dedos de la mano y pie, lesión extensa, genitales.
Vacuna VCC, se aplica por vía IM; si se da completo, serían 5 dosis (día 0, 3, 7, 14 y 28).
Suero antirrábico, se aplica por vía IM; si se da, es una sola dosis.
EXPOSICIÓN ANIMAL PASIVO (SUERO) ACTIVO (VACUNA)
Animal NO sospechoso
Lesión no grave
Animal NO sospechoso
Lesión grave
Animal sospechoso
Cualquier lesión
Animal no localizado
Cualquier lesión
Animal silvestre
Control 10 días NO
Control 10 días NO
Control 10 días Solo perro o gato
Cualquier lesión Obtener muestra de encéfalo
Animal confirmado
Cualquier lesión
Animal confirmado
Iniciar, si no hay animal o tiene rabia
Iniciar con 2 dosis y ver al animal
SI, si es L. grave Completo
SI, si es L. grave Completo Suspender si aparece animal sano
SI, si es L. grave Completo
SI Completo
Contacto c/saliva SI Completo
El VCC es una vacuna de cultivos celulares. (ESSALUD 2012)
1 (ESSALUD 2003)
2 (ENAM 2017)
Ante una mordedura humana, también se hace lavado de herida y se da amoxicilina más ácido clavulánico (ENAM 2013, EXTRA 2021). DATITO


ETIOLOGÍA
Giardia lamblia
También llamado G. intestinalis, G. duodenalis
Es un protozoario del grupo de los flagelados.
Formas biológicas: trofozoíto y quiste
Forma infectante: quiste
EPIDEMIOLOGÍA
Distribución mundial
Suele ser frecuente entre los menores de 5 años.
Transmisión vía fecal-oral
El contagio es persona a persona.
Hábitat: intestino delgado (duodeno y yeyuno proximal) 1

Figura 76. Parasitológico en heces de un paciente con giardiasis. Nótese quiste y trofozoíto.
Amebiasis
Etiología
Entamoeba histolytica
Protozoario del tipo de las amebas
Formas biológicas: trofozoíto y quiste
Forma infectante: quiste

Lo más frecuente es que cursen asintomáticos. En sintomáticos:
♦ Forma aguda: diarrea autolimitada, heces fétidas y esteatorreas 2 , dolor cólico, síndrome pseudoulceroso 3
♦ Forma crónica: diarrea intermitente o crónica, flatulencia, heces pastosas, astenia, baja de peso y puede dar malaabsorción (clínica clásica).
Parasitológico en heces para visualizar los trofozoítos 4 o quistes
Antígenos fecales por ELISA (método de elección)
Biopsia duodenal en pacientes con VIH TRATAMIENTO
Metronidazol VO por 5 días 5
El hábitat del G. lamblia es principalmente el duodeno y en su primera porción (bulbo duodenal).
Los protozoarios se dividen en:
• Flagelados
• Amebas
• Esporozoos
• Ciliophora
1 (ENAM 2005)
2 (ENAM EXTRA 2022)
3 (ENARM 2021) (ESSALUD 2016) (ENAM 2015, EXTRA 2020, 2022, 2023)
4 (ENAM EXTRA 2021)
5 (ENAM 2004)
Epidemiología
Única ameba enteropatógena intestinal del hombre
Frecuente en zonas endémicas
Transmisión fecal-oral
Contagio de persona a persona
Hábitat: el colon

Amebiasis intestinal
Lo más frecuente es asintomático.
Lo sintomático es con diarrea disentérica, hepatomegalia dolorosa e hipersensibilidad abdominal. Por tener efecto citotóxico, dan colitis (hábitat), que pueden complicarse a ameboma, hemorragia, perforación, colitis ulcerosa 1
Amebiasis extraintestinal
Lo más frecuente es en hígado y lado derecho. Cursa con hepatitis, ameboma hepático y absceso.
Parasitológico en heces para ver trofozoíto y quiste
Prueba de Ag y Ac séricos (son más sensibles y específicos)
Anatomopatología: úlceras en “botón de camisa”
Asintomático
Antiparasitarios intraluminales: iodoquinol o furoato de diloxanida
Sintomáticos
Metronidazol 2 VO por 7 a 10 días y luego un amebicida intraluminal

ETIOLOGÍA
Naegleria fowleri
Es un protozoario del tipo flagelado.
Formas biológicas: trofozoíto y quiste
Forma infectante: trofozoíto
EPIDEMIOLOGÍA
La transmisión se da por ingreso del parásito a través de mucosa nasal 1
Por contacto de agua dulce o piscinas calentadas
Hábitat: el cerebro
CLÍNICA
Periodo de incubación: 1 a 7 días
Se presenta en niños, adolescentes y jóvenes sanos.
1 (ENARM 2022)
2 (ENAM 2003)
Figura 77.
Muestra de intestino de paciente con amebiasis intestinal. Nótese la colitis (primera imagen) y la úlcera en botón de camisa.
Es un cuadro agudo.
1 (ENAM 2003)
Cursa con síndrome meningoencefalítico, luego hipertensión endocraneana y termina en la muerte.
Mortalidad 95 % a los 10 a 15 días de la clínica.
EXÁMENES
Trofozoíto en LCR
IFI
PCR
TRATAMIENTO

Es incierto, pero se sugiere una combinación entre anfotericina B, rifampicina, fluconazol, miltefosine y azitromicina, más corticoide.
Quiste Trofozoíto ameboide Trofozoíto flagelado

ETIOLOGÍAS

EPIDEMIOLOGÍA
Transmisión CLÍNICA

Curso insidioso, en semanas o meses. Cursa con síndrome meningoencefalítico, luego hipertensión endocraneana hasta la muerte.
Cuando ingresan por piel, puede hacer clínica ojos, genera queratitis amebiana.
LCR
Es incierto, pero se sugiere una combinación entre miltefosine, fluconazol y pentamidina para Acantamoeba; miltefosine, fluconazol y albendazol para Balamuthia.

ETIOLOGÍA
Balantidium coli
Es un protozoario flagelado.
Es el único protozoario flagelado que ataca al hombre.
Formas biológicas: trofozoíto y quiste
Forma infectante: quiste
EPIDEMIOLOGÍA
La MEC amebiana primaria se da en pacientes sanos, pero la encefalitis amebiana granulomatosa subagudacrónica se presenta en inmunosuprimidos.
Transmisión por vía oral Relacionado al contacto con cerdos (heces)
Hábitat: el colon

DATITO
Es el protozoario más grande.
1 (ENAM 2009)
CLÍNICA
Lo más frecuente es que sean asintomáticos.
Los sintomáticos cursan con diarrea disentérica 1
Puede cronificarse con episodios intermitentes de dolor abdominal y disentería.
EXÁMENES
Parasitológico en heces para ver el quiste y el trofozoíto
TRATAMIENTO
Adultos y niños mayores de 8 años: tetraciclina
Niños menores de 8 años: metronidazol, iodoquinol o nitazoxanida
ETIOLOGÍA
Isospora belli (Cystoisospora belli)
Es un protozoario dentro del grupo de los esporozoos.
Formas biológicas: esporozoíto, merozoíto, ooquiste
Forma infectante: ooquiste
EPIDEMIOLOGÍA
Transmisión por vía oral
Por consumo de alimentos o aguda contaminados
Hábitat: el intestino delgado


Se presenta típicamente en pacientes con VIH. Cursa con diarrea acuosa severa y crónica.
EXÁMENES
Parasitológico en heces para ver los ooquistes Coloración de Ziehl-Neelsen modificado o Kinyoun
TRATAMIENTO
Cotrimoxazol
Alternativas: pirimetamina más leucovorina, o ciprofloxacino

La Isospora belli es menos común comparado con la Cyclospora cayetanensis y la Cryptosporidium parvum.
ETIOLOGÍA
Cyclospora cayetanensis
Es un protozoario del grupo de los esporozoos.
Forma infectante: ooquiste esporulado (necesita de días o semanas para esporularse desde un ooquiste no esporulado, es decir, transmisión indirecta)
Hábitat: el intestino delgado
EPIDEMIOLOGÍA
Transmisión por vía oral
Por consumo de alimentos o aguas contaminadas
CLÍNICA
Diarrea acuosa severa y crónica, y pérdida de peso, fiebre y síntomas generales en pacientes con infección por VIH.
EXÁMENES
Parasitológico en heces para ver el ooquiste no esporulado
Coloración de Ziehl-Neelsen modificado o Kinyoun
TRATAMIENTO
Cotrimoxazol
Alternativas: no está bien reportado, pero se sugiere ciprofloxacino.
Criptosporidiasis
ETIOLOGÍA
Cryptosporidium parvum
Es un protozoario del grupo de los esporozoos.
Forma infectante: ooquiste esporulado (no necesita de un tiempo para que se convierta en esporulado, ya que sale así en las heces, por eso puede tener transmisión directa).
CLÍNICA
Se presenta típicamente en paciente con VIH. Cursa con diarrea acuosa severa y crónica.
EXÁMENES

82. Parasitológico en heces con ooquiste no esporulado de C. cayetanensis.
EPIDEMIOLOGÍA
Transmisión por vía oral
Generalmente, por contacto de agua contaminada, potable o de piscina
Hábitat: el intestino delgado

Parasitológico en heces para ver los ooquistes esporulados
Coloración de Ziehl-Neelsen modificada o Kinyoun
TRATAMIENTO
Nitazoxanida

83. Parasitológico en heces con ooquistes de C. parvum.
ETIOLOGÍA
Leishmania sp. 1
Es un protozoario del grupo de los flagelados
Tiene varias especies como: L. peruviana, L. tansoni, L. amazonensis, L. guyanensis, pero la más frecuente es la L. brasiliensis
La L. amazonensis, L. guyanensis y L. brasiliensis son las que pueden hacer forma mucocutánea
Tiene dos formas biológicas: promastigote y amastigote
La forma infectante es la promastigote
Se han sugerido reservorios animales

EPIDEMIOLOGÍA
La transmisión es por inoculación del mosquito Phlebotomo Lutzomyia, también conocido como “titira” o “manta blanca”
Los mosquitos son más activos desde el atardecer hasta el amanecer

Leishmania cutánea o cutánea andina o Uta 2
Después de la picadura e inoculación del parásito, se produce una mácula.
La mácula evoluciona a pápula o nódulo.
Luego, se ulcera con una costra que posteriormente se cae.
Deja una úlcera indolora, de bordes elevados, con adenopatía regional, limpia (sin secreciones), autolimitada, pero que puede reactivarse por traumas.

86. Úlcera cutánea de Leishmania cutánea. Nótense los bordes, lo “limpio” y lo bien delimitado.
Leishmania mucocutánea o espundia
Aparece meses o años después de una forma cutánea.
2 (ENAM 2004, 2019)
La úlcera de leishmania cutánea tiene similares características a la de una sífilis primaria.
Cursa con inflamación de la vía aérea superior, dando aspecto de nariz de tapir.
Luego, cursa con ulceración en vía aérea superior y avanza por toda esa zona destruyendo tejidos. Primero, sin muchas molestias, pero luego sí se presentan.
Se llamará severa cuando compromete, por ejemplo, la laringe, impidiendo la alimentación y respiración.
Puede conllevar a muerte.


Leishmania visceral
Esta es causada por L. donovani, inexistente en Perú.
Muestra una picadura desapercibida.
Luego, hay afectación sistémica, fiebre, visceromegalia, linfadenopatía generalizada, hemorragia gingival, edema y ascitis. Algunos casos, ictericia leve.
Cursa con citopenias, hipoalbuminemia e hipertransaminemia. Deterioro clínico con falla de órganos y muerte.
EXÁMENES
Demostración del parásito
Cutánea: biopsia o raspado del borde externo de la lesión para ver los amastigotes dentro de las células 3
Visceral: en sangre, médula ósea (más rentable) y ganglios
Cultivo
Agar Novy-Nicolle-McNeal
Serología
Se detectan anticuerpos en todos los casos.
Prueba de cutirreacción

Intradermorreacción de Montenegro, que demuestra hiperreactividad retardada celular en formas cutánea y mucocutánea.
TRATAMIENTO
CLINICA
LEISHMANIOSIS CUTÁNEA
LEISHMANIOSIS MUCOCUTÁNEO
LEISHMANIOSIS MUCOCUTÁNEO GRAVE
LEISHMANIOSIS VISCERAL
Antimonial pentavalente 20 mg/kg/día
Por 20 días (ENAM EXTRA 2022)
Antimonial pentavalente 20 mg/kg/día
Por 30 días
3 (ENAM 2003)
Anphoterecin-B 0.5 a 1.0 mg/Kg /día hasta acumular 1.5 a 2.0 gramos.
Anphoterecin-B 0.5 a 1.0 mg/Kg /día hasta acumular 1.5 a 2.0 gramos.
Anfotericina-B 0.7 a 1 mg/Kg hasta acumular 1.5 a 2.0 gramos en total. Pentamidina, Ketaconozol
Antimonial pentavalente 20 mg/kg/día
Por 30 días
Anphoterecin-B 0.5 a 1 mg/Kg hasta completar 30 mg/Kg
ETIOLOGÍA
Plasmodium sp
Es un protozoario intracelular que pertenece al grupo de los esporozoos 1
Tiene varias especies: P. vivax, P. Falciparum, P. ovale, P. Malariae 2 .
Presenta varias formas biológicas: esporozoíto, esquizonte hepático, hipnozoíto, merozoito, trofozoíto en anillo, trofozoíto maduro, esquizonte eritrocitario, gametocito.
Forma infectante: esporozoíto

EPIDEMIOLOGÍA
Transmisión por inoculación del esporozoíto por un mosquito hembra del género Anopheles.
También existe transmisión vertical (madre a feto) y por transfusiones.
El hombre se comporta como un hospedero intermediario y el mosquito como un hospedero definitivo.
El mono también puede ser un hospedero intermediario 3
El IPA (índice parasitario anual) se calcula con el número de casos entre el total, y multiplicado por 1000.
El vector se lleva al gametocito (ESSALUD 2023) (ESSALUD 2022).
1 (ENARM 2007)
2 (ENARM 2013)
3 (ENARM 2009)

Hay que sospecharlo en un paciente que acude de zona endémica, por ejemplo, la selva 1 Cursa con fiebre, cefalea, anemia hemolítica, visceromegalia e ictericia 2
La fiebre se presenta con episodios de 48 horas sin fiebre (P. vivax y P. Falciparum) y a eso se le llama terciana; o fiebre con episodios de 72 horas sin fiebre (P. Malariae) y a eso se llama cuartanas 3
Forma grave, cuando tiene alguno de los siguientes:
♦ Trastorno del sensorio y convulsiones 4
♦ Anemia severa 5
♦ Compromiso de órganos: renal, hemático, hepático, pulmonar
♦ Parasitemia elevada
♦ Generalmente, hay que sospechar en P. Falciparum 6
EXÁMENES
Se solicita gota gruesa (gold estándar) para evidenciar los eritrocitos parasitados con Plasmodium sp. 7
Ciclo evolutivo del Anopheles: huevo, larva, pupa, adulto (ENARM 2002)
A las tercianas por P. vivax, se les llama “terciana benigna”; a las tercianas por P. Falciparum, se les llama “tercianas malignas” (ENARM 2020).

1 (ENARM 2022)
2 (ENARM 2022) (ENAM 2008, 2009) (EXTRA 2020) (EXTRA 2021)
3 (ENARM 2014, ENARM 2017, ENARM 2022) (ENAM 2003)
4 (ENARM 2011) (ENAM 2003)
5 (ENAM EXTRA 2022)
6 (ENAM EXTRA 2022)
7 (ENARM 2022) (ENAM 2004)
Malaria por P. vivax
♦ Cloroquina x3d+Primaquina x7d, ante falla terapéutica: A+M+P 1 Malaria por P. malariae
♦ Cloroquina x3d+Primaquina x1d, ante falla terapéutica: A+M+P
Malaria por P. Falciparum no complicada
♦ (A+M+P): Artesunato x3d+Mefloquina x2d+Primaquina x1d Malaria por P. Falciparum resistente
♦ Quinina x7d+Clindamicina x7d+Primaquina 1d 2
Malaria grave por P. vivax
♦ Derivado de arthemisinina+Clindamicina+Primaquina
Falla terapéutica precoz 3
Clínica de malaria severa día1-3 + parasitemia
Parasitemia en día 2 > que en día 0
Parasitemia en día 3 >25 % del día 0
Parasitemia sintomática en día 3
Falla terapéutica tardía
Clínica de malaria severa >día 3 + parasitemia
Parasitemia sintomática >día 3
Parasitemia >día 7
Respuesta clínica y parasitaria adecuada
Sin parasitemia en el día 28.
Profilaxis
No evita la infección, pero previene la aparición de formas graves.
Se debe dar antes, durante y después (hasta 4 semanas después) de acudir a la zona endémica.
Esta se indica en:
♦ Gestantes
♦ Niños menores de 5 años
♦ Personal de salud
♦ Turistas nacionales y/o extranjeros
♦ Otros que la demanden cuando se desplacen hacia zonas de alta endemicidad o epidemia.
Se puede usar:
♦ Cloroquina 2 tab (300mg) c/semana, empezar 1 semana antes de viajar
♦ Mefloquina 1 tab (250mg) c/semana, empezar 1-2 semanas antes de viajar
♦ Doxiciclina 1 tab (100mg) c/día, empezar 1-2 días antes de viajar
El P. vivax es el más frecuente; el P. Falciparum es el más grave.
La primaquina elimina al esquizonte hepático, al hipnozoíto (por lo tanto, previene recaídas) y gametocitos, mientras que la cloroquina elimina al esquizonte eritrocitario (ENARM 2010, ENARM 2016) (ESSALUD 2008) (ENAM 2013, 2014). La primaquina no se da en gestantes.
(ENARM 2009)
(ENARM 2009) 2 (ENARM 2002)
ETIOLOGÍA
Trypanosoma cruzi 1
Es un protozoario del grupo de los flagelados.
Formas biológicas: tripomastigote, amastigote (intracelular), epimastigote
El epimastigote es la forma que se encuentra en el intestino del vector.
Forma infectante: tripomastigote
EPIDEMIOLOGÍA
Más riesgo en zona rural. Es endémico en la región suroccidental del Perú. Transmisión por la autoinoculación (rascado de piel o tocarse las conjuntivas del ojo) del tripomastigote dejado en las heces del vector.
El vector es el Triatoma infectans, también llamado Chirimacha o Bananón (Perú), Vinchuca (Ecuador, Bolivia, Chile y Argentina), Chipo (Venezuela), Pito (Colombia), Chinches (Honduras y El Salvador), Chicha (Paraguay) o Barbeiro (Brasil). También hay transmisión vertical (madre a feto) y por transfusiones.

1 (ESSALUD 2011)
El T. cruzi produce la enfermedad de Chagas; el T. brucei, la enfermedad del sueño. DATITO

Aguda
Periodo de incubación: aproximadamente 1 semana
Duración de 2 semanas a meses
Puede ser asintomático o sintomático.
Los sintomáticos cursan con fiebre, signos en el sitio de la autoinoculación como signo de Romaña (ojos) 1 o Chagoma (piel), adenopatías y edemas.
Es raro que se presente en formas graves, como miocarditis aguda o MEC, esta última es la peor.
El parásito circula por la sangre.
Crónica indeterminada
Es una fase asintomática.
No se encuentra el parásito en la sangre.
Enfermedad crónica
Se presenta en un 20 a 30 % de los casos.
1 (ENAM 2006, 2017, 2020)
Por el histiotropismo, en:
♦ Miocardio, dará cardiomiopatía dilatada, viene con clínica de insuficiencia cardiaca por disfunción sistólica
♦ Esófago, dará megaesófago, viene con clínica de disfagia 2
♦ Colon, dará megacolon, viene con clínica de estreñimiento 3
Si hay inmunosupresión, se pueden desarrollar abscesos cerebrales.
Fase aguda: gota gruesa con Giemsa para identificar al tripomastigote (forma diagnóstica) en la sangre
Fase crónica: se pueden evidenciar los anticuerpos por ELISA.
TRATAMIENTO
Benznidazol Nifurtimox
2 (ENAM 2018) (ENAM EXTRA 2023)


3 (ENAM EXTRA 2023)


El tripomastigote es tanto la forma infectante como diagnóstica.


ETIOLOGÍA
Trichuris trichiura
Tamaño: 4 cm, de color rojizo
Formas biológicas: gusano y huevo
Forma infectante: huevos embrionados
EPIDEMIOLOGÍA
Transmisión vía oral

FISIOPATOLOGÍA
Llegan a su hábitat que es el colon, preferentemente el ciego 1
Mediante lesión mecánica, generan inflamación local, edema y hemorragia.
La gravedad es proporcional al número de parásitos.

CLÍNICA
Infestación leve: asintomáticos
Infestación moderada: dolor tipo cólico y diarrea ocasional
Infestación severa: en niños desnutridos, diarrea disentérica, cólico, distensión, anorexia, prolapso rectal 1 , anemia ferropénica, apendicitis 2

1 (ENARM 2013)
Parasitológico en heces: huevos
TRATAMIENTO
Mebendazol o albendazol

1 (ESSALUD 2014)
2 (ENARM 2009, ENARM 2022)
ETIOLOGÍA
Enterobius vermicularis
Tamaño: macho 4 mm y hembra 10-12 mm de color blanco
Formas biológicas: gusano y huevo
Forma infectante: huevos embrionados
EPIDEMIOLOGÍA
Transmisión vía oral
Muy contagioso
Más frecuente en niños que en adultos.
El hombre es el único que sufre esta enfermedad.
Los huevos embrionados de oxiuros ingresan por vía oral.
Los huevos liberan una larva en el intestino delgado.
Llega al colon, preferentemente al ciego, (hábitat), para madurar a su forma adulta.
Las hembras reptan en la noche hacia la zona perianal, lo que genera las molestias.
Algunas incluso migran hacia la zona anterior, afectando el área genital en niñas 1

CLÍNICA
Prurito y eritema perianal y vulvar nocturno 2
Bruxismo (rechinar de los dientes)
Insomnio e intranquilidad 3
Dolor abdominal en FID, diarrea ocasional
Apendicitis
Vaginitis, leucorrea e ITU en niñas 4

1 (ENARM 2020) (ENAM EXTRA 2023)
2 (ENAM 2006) (ENAM EXTRA 2023)
3 (ENAM 2005)
4 (ENAM EXTRA 2023)
Test de Graham (elección) 5
Eosinofilia en sangre
TRATAMIENTO
Albendazol o mebendazol
Pamoato de pirantel

5 (ENAM 2004, 2013) (ESSALUD 2023)

ETIOLOGÍA
Ascaris lumbricoides
Tamaño: muy grande, 20 a 40 cm, de color blanco o rosado
Formas biológicas: gusano y huevo (bordes mamelonados)
Forma infectante: huevo infectivo
EPIDEMIOLOGÍA
Transmisión vía oral
Primera infección por helmintos, más frecuente en el mundo
1 (ENAM 2003)
Los huevos caen con las heces: huevo fertilizado y no fértil.
Los huevos fertilizados se convierten en huevos infectivos.
Ciclo de Loos: los huevos infectivos son ingeridos, llegan al intestino sin adherirse y pasan al torrente sanguíneo, llegan al pulmón, pasan a los alveolos (hacen un síndrome de Loeffler), maduran, reptan hacia la faringe y son deglutidos; en el intestino delgado (yeyuno) alcanzan la fase de adulto 1

CLÍNICA
Respiratoria:
Fiebre, tos, sibilancias y hemoptisis 2
Síndrome de Loeffler 3
Intestinal:
Más frecuente asintomáticos.
Si hay gran parasitosis, dan síntomas inespecíficos.


Ascaris lumbricoides es el helminto nemátode intestinal más grande. DATITO
2 (ENAM EXTRA 2023) 3 (ENAM 2006)
En niños de zonas endémicas con gran parasitosis, se apelotan en el intestino delgado y producen obstrucción. Además, pueden migrar y obstruir vías: biliar, pancreática.
Parasitología en heces: huevos en gran cantidad La radiografía de tórax en síndrome de Loeffler evidencia un infiltrado bilateral cambiante.

El síndrome de Loeffler es una neumonitis eosinofílica aguda autolimitada que “viene y que va” (ENARM 2016) El huevo de Ascaris lumbricoides tiene forma de “granada” por sus bordes mamelonados.
4 (ENARM 2002, ENARM 2009) (ENAM EXTRA 2021)
TRATAMIENTO
Albendazol o mebendazol 4
Si hay síndrome de Loeffler, dar corticoides.
Cirugía en casos de obstrucción
ETIOLOGÍA
Strongyloides stercolaris
Tamaño: 2 mm
Formas biológicas: gusanos (larva rabditiforme y filariforme) y huevo
Forma infectante: larva filariforme 3
EPIDEMIOLOGÍA
Transmisión por piel 2


Figura 109. Muestra de paciente con ascaridiasis que generó obstrucción intestinal.
1 (ENARM 2004) 2 (ENARM 2006)
FISIOPATOLOGÍA
Tiene 3 ciclos: indirecto, directo y autoinfestante — Indirecto: en suelo, hembra y macho producen huevos, y estos maduran a larva rabditiforme y luego, filariforme, e ingresan por piel
Directo: larvas rabditiformes que cayeron al suelo maduran a filariformes e ingresan por piel
Autoinfestante: larvas rabditiformes en el colon maduran a filariformes e ingresan por la mucosa o piel perianal, esto en pacientes inmunosuprimidos. Llevan bacterias a la sangre → sepsis.
De la piel, pasan a la sangre y hacen ciclo de Loos (pueden hacer síndrome de Loeffler), y llegan a su hábitat que es el intestino delgado

Figura 110. Formas biológicas de S. stercolaris: huevo, larva filariforme y larva rabditiforme.
CLÍNICA
Dérmica:
♦ Larva currens
Respiratorio e intestinal:
♦ Similar a ascaridiasis, pero con cuadros de malabsorción y no obstrucción.
Síndrome de hiperinfestación
♦ En pacientes inmunosuprimidos
♦ Cuadro diarreico con esteatorrea muy intensa; si afecta al colon, causa colitis disentérica grave con shock.
Strongyloides stercolaris es el helminto nemátode intestinal más pequeño.
Parasitológico en heces con visión de larvas rabditiformes 3
TRATAMIENTO
Ivermectina (elección) o tiobendazol o albendazol 4
3 (ENAM 2020)
4 (ENARM 2009, 2012) (ENAM 2006)


ETIOLOGÍA
Ancylostoma duodenale y Necator americanus Tamaño: 10 mm, blanquecinos o herrumbrosos
Formas biológicas: gusano (larvas rabditiforme y filariforme) y huevo
Forma infectante: larva filariforme
Tienen cápsula bucal con dos pares de dientes (Ancylostoma) o dos láminas semicirculares (Necator).
1 (ENAM 2012, EXTRA 2021)
Transmisión por piel 1 Es la segunda infección helmíntica más frecuente. Necator americanus hay en América y Australia. Ancylostoma duodenalis hay en África y Europa.

FISIOPATOLOGÍA
Los huevos embrionados en las heces caen al suelo.
Los huevos brindan larvas rabditiforme y estas maduran a filariforme.
La larva filariforme ingresa por piel, típicamente en los pies.

De la piel, pasan a la sangre y hacen ciclo de Loos (pueden hacer síndrome de Loeffler), y llegan a su hábitat que es el intestino delgado.
Son hematófagos (0.1 ml/día/parásito), ya que se nutren de los capilares.
CLÍNICA
Pápula pruriginosa en piel que no recuerda el paciente 2
El pasaje larvario pulmonar da poca sintomatología 3 .
El cuadro duodenoyeyunal causa dolor epigástrico con diarrea.
Anemia ferropénica de lenta instauración y tolerada 4

ETIOLOGÍA
Trichinella spiralis
Tamaño: 1-4 mm
Parasitológico en heces para evidenciar huevos
TRATAMIENTO
Albendazol o mebendazol

2 (ENAM 2011)
3 (ENAM 2016)
4 (ENAM EXTRA 2022)
1 (ENARM 2013)
Formas biológicas: gusano y larva enquistada
Forma infectante: larva enquistada en tejidos
Hospedero intermediario: hombre
FISIOPATOLOGÍA
Ingesta de larvas enquistadas

EPIDEMIOLOGÍA
Transmisión vía oral
Antecedente de ingesta de carne de cerdo mal cocida
Hospedero definitivo: hombre en tejidos (carne de cerdo) y liberadas en intestino delgado
Maduran a formas adultas en intestino delgado y estas brindan larvas pequeñas 1
Las larvas pequeñas pasan a la sangre y llegan al tejido muscular (hábitat) estriado o cardiaco.

Si en una pregunta de parásitos mencionan “cerdos”, deben pensar en:
- Balantidium coli: por contacto con heces de cerdo (criador) (ENARM 2009)
- Trichinella spiralis: por consumo de carne de cerdo mal cocida
- Tenia solium: por consumo de carne de cerdo mal cocida
Puede presentar gastroenteritis con náuseas, vómitos, cólico y diarreas.
Miositis con mialgias espontáneas a la palpación y a la movilización.
Formas graves: miocarditis.
Clásico que vengan con eosinofilia + edema periorbitario + miositis + fiebre
ETIOLOGÍA
Toxocara canis o cati
Tamaño 5-10 cm
Formas biológicas. gusano y huevo
Leucocitosis con eosinofilia en sangre
Aumento de enzimas musculares
Excepcional ver parásitos en heces
TRATAMIENTO
Albendazol o mebendazol
Corticoide: prednisona (por la inflamación en el músculo)
Forma infectante: huevos embrionados (bordes muy mamelonados)
EPIDEMIOLOGÍA
Transmisión por vía oral
Hospedero definitivo: animal perro o gato
Hospedero intermediario: hombre
Es una zoonosis por ingestión de huevos infectantes, eliminado más por cachorros.
Es más frecuente en niños y adolescentes <20 años.

CLÍNICA
La mayoría, asintomáticos.
Los sintomáticos pueden hacer:
♦ Toxocariasis visceral (larva migrans visceral): puede atacar hígado, pulmón, SNC, pero llegan a calcificarse.
♦ Toxocariasis ocular (larva migrans ocular): cuando ataca al ojo, se da inflamación de retina, llevando a ceguera; ataca un solo ojo.
Serológicos
Biopsia
TRATAMIENTO
Albendazol o mebendazol (para la toxocariasis visceral y ocular)
Corticoides para la forma ocular (el objetivo es reducir los daños, no ayuda la cirugía)
FISIOPATOLOGÍA
El animal elimina al suelo huevos en sus heces; los huevos se vuelven huevos embrionados.
El humano ingiere los huevos embrionados y eclosionan en el tubo digestivo.
Las larvas liberadas pasan a la sangre y llegan a los tejidos, pero ya no se desarrollan más, sino que se calcifican

Toxocara canis o cati es conocida como el Ascaris del animal.

ETIOLOGÍA
Taenia saginata y Tenia solium
Formas biológicas: gusano (larva y adulto) y huevo
Forma infectante de teniasis: larvas enquistadas
Forma infectante de cisticercosis: huevos
Características T. saginata T. solium
Tamaño 5 a 8 metros
Aspecto globular
1.5 a 2 mm
Escólex
Estróbilo
Huevo
4 ventosas acetabulares
No corona de ganchos
1000 a 2000 proglótides c/u 1.5 a 2 cm x 1 cm
3 a 5 metros
Aspecto piriforme
0.5 a 1 mm
4 ventosas
Si tiene doble corona de ganchos en el rostelo
800 a 900 proglótides c/u 0.6 a 0.8 cm x 0.5 cm
30 a 45 um esféricos ovoides Ídem
Características de T. saginata y T. solium.


EPIDEMIOLOGÍA
La teniasis se transmite por vía oral, consumo de carne mal cocida de vacuno (T. saginata) o de cerdo (T. solium) por ingesta de larvas enquistadas. La cisticercosis se trasmite por vía oral, secuencia ano-manoboca por ingesta de huevos.
FISIOPATOLOGÍA
Teniasis
♦ Es causado por T. saginata o T. solium.
Hospederos T. saginata T. solium
H. definitivo Humano→Teniasis Humano→Teniasis
H. intermediario natural Vacuno→Cisticercosis Cerdo→Cisticercosis
H. intermediario accidental No tiene
Humano→Cisticercosis (ENAM 2003)
Hospederos de T. saginata y T. solium.
♦ El animal tiene en sus tejidos larvas enquistadas, que son consumidas por el humano.
♦ En tubo digestivo, los quistes eclosionan y liberan a la larva.
♦ La larva madura hasta su forma adulta, ubicada en el intestino delgado (hábitat).
♦ También pueden generar obstrucción en intestino, vía biliar, apéndice.
Cisticercosis
♦ Es causado solo por T. solium.
♦ En el humano con teniasis, las T. solium liberan huevos embrionados en las heces.
♦ Por mala higiene, la mano en contacto con las heces lleva los huevos a la boca y lo deglute.
♦ Los huevos en el intestino liberan larvas pequeñas que pasan a la circulación y de ahí a diferentes tejidos (hábitat), como cerebro, corazón, músculo estriado, ojo, etc., produciendo inflamación en ellos.

CLÍNICA
Teniasis
Lo más frecuente, asintomático. 1
Síntomas gastrointestinales inespecíficos
Obstrucciones de intestino, vía biliar, apéndice.
Neurocisticercosis
Convulsiones 2 , síndrome de hipertensión endocraneana, trastorno del sensorio, alucinaciones 3
EXÁMENES
Teniasis:
Detección de coproantígenos
Parasitológico en heces
Test de Graham
Diagnóstico de certeza: proglótides gravídicas y huevos en heces
Diagnóstico de especie: por # ramificaciones
Neurocisticercosis
Serológicos
Neuroimágenes
TRATAMIENTO
Teniasis: praziquantel o niclosamida
Neurocisticercosis: hospitalización, corticoide (dexametasona) y albendazol

y número de ramificaciones (T. saginata con más ramificaciones).
ETIOLOGÍA
Diphyllobothrium latum
Tamaño: más de 10 metros
Formas biológicas: gusano (larvas y adulto) y huevo
Forma infectante: larva plerocercoide
1 (ENARM 2012)
2 (ENAM EXTRA 2022)
3 (ENARM 2020)
EPIDEMIOLOGÍA
Transmisión vía oral
Consumo de pescado crudo o mal cocido, de agua dulce
Hospedero definitivo: humano
Hospedero intermediario: crustáceos y peces

El Diphyllobothrium latum es el tipo de tenia más grande del
FISIOPATOLOGÍA
El humano consume pescado crudo o mal cocido que contiene larva plerocercoide. La larva plerocercoide madura a su forma adulta, ubicándose en el intestino delgado (hábitat), y se fija por sus botrias.
Típicamente, se localizan en el íleon terminal para consumir vitamina B12. Evitan la absorción de vitamina B12 y generan anemia megaloblástica.

CLÍNICA
La mayoría son asintomáticos. Pueden dar clínica inespecífica, como las tenias.
Anemia megaloblástica
Cuadros obstructivos intestinales y biliares
EXÁMENES
Parasitológico en heces para visualizar los huevos Deficiencia de la vitamina B12
TRATAMIENTO
Praziquantel o niclosamida

Etiología
Echinococcus granulosus
Tamaño: 2 a 7 mm de longitud
Formas biológicas: gusano (larvas y adultos) y huevo
Forma infectante: huevo embrionado
EPIDEMIOLOGÍA
El modo más común de transmisión a los humanos es el consumo accidental de tierra, agua o alimentos que han sido contaminados por la materia fecal de un perro infectado.
La enfermedad se encuentra más comúnmente en personas involucradas en la crianza de ovejas, como resultado del papel de la oveja como huésped intermediario del parásito y la presencia de perros de trabajo a los que se les permite comer los despojos de las ovejas infectadas.
Hospedero definitivo: perros y lobos → teniasis
Hospedero intermediario natural: oveja → quiste hidatídico 1
Hospedero intermediario accidental: humano→quiste hidatídico
FISIOPATOLOGÍA
El humano ingiere los huevos embrionados, llegan

al tubo digestivo y eclosionan brindando una larva pequeña.
El humano ingiere los huevos embrionados, llegan al tubo digestivo y eclosionan brindando una larva pequeña.
La larva pequeña pasa a la sangre y de ahí a diferentes tejidos del cuerpo, en primer lugar, al hígado (más frecuente lado derecho) (ESSALUD 2009), y, en segundo lugar, al pulmón (más frecuente lado derecho) (ENARM 2007, ENARM 2011)
La larva pequeña pasa a la sangre y de ahí a diferentes tejidos del cuerpo, en primer lugar, al hígado (más frecuente lado derecho) 2 , y, en segundo lugar, al pulmón (más frecuente lado derecho) 3
El humano se comportará como oveja, es decir, desarrollará quiste hidatídico en los tejidos.
El quiste suele ser unilocular con crecimiento lento (1 cm/ año).
El humano se comportará como oveja, es decir, desarrollará quiste hidatídico en los tejidos. El quiste suele ser unilocular con crecimiento lento (1 cm/ año).
En anatomopatología se observan capas (de afuera hacia dentro): adventicia, capa cuticular y capa germinativa (vesículas con escólex → liberadas formarán la “arenilla hidatídica).
En anatomopatología se observan capas (de afuera hacia dentro): adventicia, capa cuticular y capa germinativa (vesículas con escólex → liberadas formarán la “arenilla hidatídica).
— El quiste ejerce un efecto de masa, pero también puede complicarse rompiéndose, liberando su contenido o infectándose.
El quiste ejerce un efecto de masa, pero también puede complicarse rompiéndose, liberando su contenido o infectándose.

1 (ESSALUD 2007) 2 (ESSALUD 2009)
3 (ENARM 2007, ENARM 2011)
La mayoría son asintomáticos.
Hepático: dolor abdominal, masa palpable e ictericia 4
Pulmonar: al romperse, resulta en la famosa vómica hidatídica 5
EXÁMENES
Radiografía de tórax: quiste simple, signo del menisco aéreo, signo de doble arco, signo del camalote 6
TEM tórax o TEM abdomen
TRATAMIENTO
Quirúrgico (quistectomía) 7 , con método PAIR (Punción Aspiración Inyección con alcohol o suero hipertónico y Reaspiración)
Antiparasitario (mebendazol) pre y posquirúrgico
(ENARM 2009)
(ENAM 2004)
(ENAM 2018)
(ENAM 2004)

ETIOLOGÍA
Fasciola hepática (duela del hígado)
Tamaño: 30 mm por 15 mm
Formas biológicas: gusano (larvas y adulto) y huevo
Forma infectante: larva metacercaria
EPIDEMIOLOGÍA
Transmisión por vía oral
Consumo de berros o agua contaminada
Paciente que viene de la sierra central o sur Hospedero definitivo natural: ganado vacuno, ovino, caprino
Hospedero definitivo accidental: hombre
Hospedero intermediario: caracol de la familia
Lymnaeidae

F. hepática es la parasitosis que genera gran eosinofilia (<20 %).

FISIOPATOLOGÍA
El humano ingiere la larva metacercaria enquistada y se desenquista en el tubo digestivo.
En el intestino delgado, la larva libre pasa por la pared del intestino hacia el peritoneo.
En el peritoneo, se queda por meses hasta que encuentra el hígado y lo penetra.
En el hígado, se ubicará en las vías biliares intrahepáticas (hábitat), donde maduran a su forma adulta.
CLÍNICA
Fase aguda: migración del parásito al hígado, dura 3 a 5 meses, cursa con fiebre, hepatomegalia dolorosa e hipereosinofilia 1
ETIOLOGÍA
Paragonimus peruvianus (P. mexicanus)
Tamaño: adulto 7.5 a 12 mm por 4 a 6 mm
Formas biológicas: gusano (larvas y adulto) y huevo
Forma infectante: larva metacercaria
EPIDEMIOLOGÍA
Transmisión vía oral por consumo de cangrejos de río 1
Importante en Cajamarca y La Libertad
Hospedero definitivo: humano
Hospedero intermediario: caracol de río y cangrejo de río
Fase crónica o de estado: el parásito se ubica en vía biliar, lesiona hígado y vía biliar, obstruye vía biliar.
Fase aguda: Arco II, Western blot, Fas2- ELISA. Fase crónica: métodos directos, técnicas de concentración.
Triclabendazol 2 o bitionol 1 (ENAM 2004, 2008) 2 (ENAM 2009)
FISIOPATOLOGÍA
El humano consume cangrejos de río contaminados con larva metacercaria enquistada.
La larva enquistada eclosiona en el tubo digestivo, atraviesa la pared intestinal para llegar al peritoneo.
Del peritoneo, atraviesan el diafragma para llegar al pulmón (hábitat), pasando por la cangrejos de río 2
Importante en Cajamarca y La Libertad Hospedero definitivo: humano Hospedero intermediario: caracol de río y cangrejo de río pleura.
En el pulmón, generan lesiones y hasta derrame pleural
(ENAM 2006)

(ENAM 2006)

CLÍNICA
La mayoría, asintomático.
Los sintomáticos hacen cuadro parecido a bronquitis crónica o tuberculosis: tos, hemoptisis, dolor y disnea. Un 25 % llegan al SNC.
EXÁMENES
Examen de esputo Radiografía de tórax con infiltrados lobulares, las lesiones de la moneda, cavidades, nódulos calcificados, la ampliación hiliar, engrosamiento pleural y derrames. Opacidades en forma de anillo de cavidades contiguas, dando la apariencia característica de un racimo de uvas.
TRATAMIENTO
Praziquantel o triclabendazol
Agregar corticoide si hay afectación del SNC.



ETIOLOGÍA
Histoplasma capsulatum
Tiene una fase saprobia y otra parasitaria.
EPIDEMIOLOGÍA
La forma saprobia se observa en suelo rico, en guano de ave y murciélago.
Se transmite por inhalación de conidios.
La presentación “diseminada” es típico de Inmunosuprimidos, como el VIH.
FISIOPATOLOGÍA
Los conidios al ser inhalados se convierten en levaduras.
Las levaduras son ingeridas por los macrófagos.
Sobreviven y proliferan en el interior de la fagolisosoma.
Algunas se mantienen latentes dentro del macrófago.
Otras proliferan, destruyen al macrófago y lesionan tejidos.
Forma asintomática
(ENAM 2003)
La mayoría de los casos, por poco inóculo, y es de pacientes inmunocompetentes.
Cuadro autolimitado, solo deja un nódulo con calcificaciones concéntricas.
Forma de histoplasmosis pulmonar aguda
Por un gran inóculo y es de pacientes inmunocompetentes.
Cuadro parecido a un cuadro pseudogripal.
Se podría observar linfadenopatía hiliar e infiltrados, y hasta nódulos pulmonares.
Forma de histoplasmosis diseminada 1
Mínimo porcentaje de los casos; puede ser de forma aguda, subaguda o crónica.
La forma aguda es típico de pacientes lactantes y adultos inmunosuprimidos, shock séptico con fiebre, infiltrados pulmonares y disnea aguda. También úlceras y hemorragias bucales y gastrointestinales, insuficiencia suprarrenal, meningitis o endocarditis. Sin tratamiento, mueren en días o semanas.
La forma subaguda cursa con fiebre, pérdida de peso y malestar, úlceras orofaríngeas, visceromegalia, citopenias. Puede afectar glándulas suprarrenales, válvulas cardiacas y el SNC. Sin tratamiento, fallecen en 2 a 24 meses.
La forma crónica cursa con pérdida de peso, fatiga, acompañada o no de fiebre, úlceras bucales y visceromegalia.


EXÁMENES
Radiografía de tórax
Anatomopatología de cortes tisulares
2 (ENARM 2003, ENARM 2009)
Cultivo de sangre, médula ósea u otro material clínico
Pruebas serológicas, como la detección de antígenos en sangre y orina
TRATAMIENTO
Formas leves con itraconazol
Formas graves, como la diseminada con anfotericina B lipídica 2
Paracoccidioidomicosis
ETIOLOGÍA
Paracoccidioides brasiliensis
Tiene forma saprobia y parasitaria.
EPIDEMIOLOGÍA
La forma saprobia se observa en suelo y vegetación.
La transmisión es por inhalación de conidios; otras formas son por inoculación, deglución o por piel lesionada.
FISIOPATOLOGÍA
Los conidios al ser inhalados se transforman en grandes levaduras multipolares de gemación.
Son ingeridas, pero no destruidas por los macrófagos.
Pueden estar en estado latente durante incluso 40 años.
Se pueden diseminar a la mucosa oral y nasofaríngea.

CLÍNICA

Figura 137. Radiografía de tórax de paciente con histoplasmosis diseminada aguda.
Forma aguda-subaguda (forma juvenil)
10 % de casos
Se presenta en menores de 30 años.
Cursa con fiebre, pérdida de peso, adenopatías, visceromegalia y aplasia medular 1
No suelen afectar al pulmón.
Forma crónica (forma de adulto) 2
90 % de casos
Se presenta en mayores de 30 años.
Sí afecta al pulmón, con infiltrados 3
Cursa también con úlceras en mucosas.
EXÁMENES
Visión directa con KOH (forma de timón de barco)
TRATAMIENTO
Casos no graves: itraconazol
Casos graves: anfotericina B lipídica

1 (ENAM EXTRA 2022)
2 (ENAM 2017, EXTRA 2021)
3 (ENAM EXTRA 2022)
ETIOLOGÍA
Sporothrix schenkii 1
EPIDEMIOLOGÍA
El hongo se ubica en suelo y vegetación. La transmisión es por inoculación traumática de tierra, vegetales o materia orgánica 2
FISIOPATOLOGÍA
Una vez inoculado, desarrolla una infección crónica. Se caracteriza por afectar el recorrido de los vasos linfáticos que drenan el punto primario de inoculación.
CLÍNICA
El lugar de inoculación desarrolla un nódulo que puede ulcerarse.
Luego, aparecen nódulos linfáticos secundarios en sentido proximal a lo largo del trayecto del drenaje linfático de la lesión primaria 3
Después, los nódulos se ulceran y secretan pus.
EXÁMENES
Cultivo de pus o tejido infectado
Anatomopatología con aspecto de material de Splendore-Hoeppli
TRATAMIENTO
Actualmente, se recomienda itraconazol 4 . Antes se usaba con mayor frecuencia yoduro de potasio.

Esporotricosis. Nótese el lugar de la inoculación en círculo; las otras lesiones son los nódulos secundarios.
ETIOLOGÍA
Aspergillus fumigatus
EPIDEMIOLOGÍA
Transmisión por inhalación
FISIOPATOLOGÍA
Reacción de hipersensibilidad I y III
Cursa con broncoconstricción e inflamación persistente.
Termina causando bronquiectasias centrales llenas de moco.
CLÍNICA
Clínica de asma bronquial crónico
Imágenes como TEM de tórax para ver bronquiectasias e infiltrados pulmonares
IgE en sangre
Eosinofilia en sangre
Precipitinas frente a Aspergillus
Aspergillus en esputo
Reactividad cutánea inmediata y semirretardada
TRATAMIENTO
Corticoides, ya que la posibilidad de erradicación es pobre.
1 (ESSALUD 2016)
2 (ENAM EXTRA 2023)
3 (ENAM EXTRA 2023)
4 (ENAM 2005)
DATITO
Aspergillus fumigatus es la especie más frecuente de Aspergillus.
Se sospechará en paciente con antecedentes de cavidad dejada por tuberculosis.
Cursa con tos, hemoptisis y pérdida de peso.
Radiografía con radiopacidad redonda que se mueve con menisco aéreo 1
Tratamiento: cirugía 2 con voriconazol antes y después de la cirugía; otra opción es anfotericina B.
1 (ENARM 2017) (ENAM 2017)
2 (ENAM 2010)
Se sospechará en los siguientes pacientes:
♦ Que presenten neumonía aguda cavitada
♦ Que no responden a antibióticos
♦ Neutropénicos
Radiografía con condensación cavitada, con base pleural
Tratamiento: voriconazol o anfotericina B
ETIOLOGÍA
Hongos de los géneros Rhizopus, Mucor, Rhizomucor, etc.
EPIDEMIOLOGÍA
Se encuentran en suelo y vegetación.
Factor de riesgo importante: diabetes con cetoacidosis.
El hongo se pone en contacto con la vía aérea superior.
FISIOPATOLOGÍA
Infección necrótica aguda de la cavidad nasal, de los senos paranasales y la órbita
Se disemina al SNC con afectación de las meninges y cerebro.
CLÍNICA
Se observa una ulceración necrótica que empieza en el paladar y progresa a estructuras contiguas, como senos paranasales, ojos y SNC 1
EXÁMENES
Examen microscópico directo
Estudio anatomopatológico
Cultivo
TRATAMIENTO
Anfotericina B



Mucormicosis rinocerebral.
la úlcera necrótica en paladar.
(ENAM EXTRA 2021)
ETIOLOGÍA
Cándida albicans y no albicans
Las especies de Cándida no albicans representan aproximadamente la mitad de todas las infecciones por candidiasis invasiva y del torrente sanguíneo. Los más destacados han sido C. glabrata y C. parapsilosis, seguidos de C. tropicalis y C. krusei.
EPIDEMIOLOGÍA
La candidiasis es una infección nosocomial cada vez más importante tanto en adultos como en niños, especialmente en aquellos que son atendidos en unidades de cuidados intensivos.
Todas las C. krusei son resistentes al fluconazol.
Una proporción cada vez mayor de C. glabrata son resistentes al fluconazol.
Además, la resistencia a las equinocandinas entre los aislados de C. glabrata se informa cada vez con mayor frecuencia en ciertos centros médicos.
Tienen mayor riesgo de candidemia: los pacientes en la UCI y los inmunodeprimidos (pacientes con neoplasias hematológicas, receptores de trasplantes de órganos sólidos y células madre hematopoyéticas).
Hay tres vías principales por las que la cándida accede al torrente sanguíneo:
♦ A través de la barrera mucosa del tracto gastrointestinal
♦ A través de un catéter intravascular
♦ Desde un foco de infección localizado, como la pielonefritis.
CLÍNICA
Fiebre mínima hasta un síndrome de sepsis, indistinguible de una infección bacteriana grave.
La candidiasis invasiva se define como la diseminación hematógena a múltiples vísceras (ojo, riñón, válvulas cardiacas, cerebro).
Lesiones oculares características (coriorretinitis con o sin vitreítis), lesiones cutáneas y, con mucha menos frecuencia, abscesos musculares.
El estándar de oro para el diagnóstico de candidemia es un hemocultivo positivo, pueden ser negativos y el diagnóstico se basará en la sospecha clínica.
En pacientes con hallazgos focales (lesiones cutáneas o compromiso parenquimatoso), se debe realizar una biopsia para tinción, cultivo y evaluación histopatológica.
Prueba de beta-D-glucano como complemento de los hemocultivos y la biopsia.
TRATAMIENTO
Opciones:
♦ Equinocandinas (caspofungina, micafungina, anidulafungina) 1
♦ Azol (fluconazol)
♦ Anfotericina B
Pacientes no neutropénicos: 1. ° equinocandinas, 2.° fluconazol, 3. ° anfotericina B
La cándida en un hemocultivo nunca debe considerarse un contaminante y siempre debe dar lugar a una búsqueda de la fuente de la fungemia.
Pacientes neutropénicos: 1. ° equinocandinas, 2. ° anfotericina B 1 (ENARM 2019)